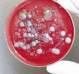

УДК 355.233(075.3)
З-38
З-380
Захист України : підручник для 10 класу закладів загальної середньої освіти. Рівень стандарту. / М. М. Фука, К. О. Пашко, І. М. Гарасимів, А. А. Гудима, С. І. Чуткий, Р. М. Мельник, Б. І. Білах. — Тернопіль : Астон, 2023. — 380 с
ISBN 978-966-308-856-3
Підручник містить навчальний матеріал, передбачений чинною програмою МОН України з предмета «Захист України» для 10 класу закладів загальної середньої освіти. Відомості, подані в підручнику, сприятимуть підготовці молоді до служби в ЗСУ, а також — захисту життя та здоров’я як власного, так й інших людей під час надзвичайних ситуацій. Видання
ISBN 978-966-308-856-3
§ 2. Система
§ 6. Нормативно-правова
§ 7. Військова
§ 8. Українське
§ 12. Поняття про військові статути. Військові звання та знаки розрізнення. Військова дисципліна, її суть і значення ................ 95
§ 13. Розподіл часу і повсякденний порядок. Розпорядок дня та його значення для виконання основних заходів повсякденної діяльності, навчання й побуту особового складу підрозділів ...... 103
РОЗДІЛ 3. СТРОЙОВА ПІДГОТОВКА ТА ПРИКЛАДНА ФІЗИЧНА ПІДГОТОВКА.................................................................
Тема 1. Стройові прийоми і рух без зброї ............................................................110
§ 14. Строї та їх елементи. Обов’язки військовослужбовця перед шикуванням і в строю. Підготовча та виконавча команди ......... 110
§ 15. Стройове положення. Повороти на місці. Рух стройовим і похідним кроком. Повороти під час руху .............................. 113
Тема 2. Строї, відділення ..............................................................................................116
§ 16. Шикування відділення в розгорнутий і похідний строї. Розмикання і змикання відділення. Рух відділення стройовим
і похідним кроком ............................................................... 116
§ 17. Вправи на мобільність поперекового відділу. Вправи для
відновлення після перевантаження, реабілітаційні вправи для
§ 19. Сучасна
§ 20. Прийоми та правила стрільби
§ 21.
та будова автоматичної зброї. Підготовка до стрільби ........................................................ 168 §
23. Порядок неповного розбирання і складання та обслуговування автомата. Тренування в неповному розбиранні та складанні
§ 24. Малокаліберна, пневматична гвинтівки та гладкоствольна рушниця: загальна будова та характеристика ......................... 177
§ 25. Основи стрільби з пневматичної гвинтівки. Помилки під час стрільби з гвинтівки та їх усунення ....................................... 183
§ 26. Загальна будова та види боєприпасів до стрілецької зброї. Маркування боєприпасів. Спорядження магазина патронами і порядок зарядження автомата. Вимоги правил
§ 27. Орієнтування на місцевості.
§ 28. Складання опису місцевості.
§ 29. Способи визначення відстаней на
§ 30. Спосіб горизонталей. Визначення
висот за топографічною картою. Визначення зон видимості. Правила користування навігатором
§ 31. Географічна система координат. Система прямокутних координат...........................................................................
РОЗДІЛ 6. ОСНОВИ ЦИВІЛЬНОГО ЗАХИСТУ
Тема 1. Нормативно-правова база цивільного захисту ..............................231
§ 32. Єдина державна система цивільного захисту та її складові. Законодавче та нормативно-правове забезпечення її функціонування ...............................................................
Тема 2. Надзвичайні ситуації мирного та воєнного часу, загрози їх виникнення
§ 33. Причини виникнення та
§ 38. Виживальницький запас. Вміст та складання тривожної валізи 260
§ 39. Види, місцезнаходження, обладнання укриттів, сховищ, бомбосховищ ......................................................................
§ 40. Повідомлення про
§ 41. Засоби індивідуального та колективного захисту. Застосування засобів індивідуального захисту ......................... 274
§ 42. Медичний, радіаційний і хімічний захист, евакуація
населення з небезпечних районів ........................................... 280
§ 43. Дії в умовах особливого періоду, під час артилерійського
обстрілу, у натовпі, у разі виявленні підозрілого предмету, виходу із зони бойових дій ...................................................
288
§ 44. Види терористичних проявів та способи дій терористів.
Захист від терористичних проявів та дії населення в умовах
надзвичайних ситуацій, пов’язаних з терористичними проявами............................................................................ 297 Тема 4. Попередження ризиків від вибухово-небезпечних предметів .... 306 § 45. Психологічна стійкість та саморегуляція під час надзвичайних ситуацій. Само- та взаємодопомога при панічному нападі, тривозі, істериці, ступорі, апатії, проявах гніву, злості, агресії ............. 306
§ 46. Протимінна діяльність та її складові. Міжнародні стандарти та нормативно-правова база протимінної діяльності в Україні. Ознаки небезпечних територій (районів) та їх системи позначення (маркування) .................................................... 314
РОЗДІЛ 7. ДОМЕДИЧНА ДОПОМОГА................................................... 322 Тема 1. Базова підтримка життя .........................................................................322
§ 47. Рятувальний ланцюжок у разі раптової зупинки серця.
Алгоритм дій проведення серцево-легеневої реанімації............. 322
§ 48. Основні правила та порядок проведення реанімації ..................
§ 49. Техніка забезпечення прохідності верхніх дихальних шляхів ... 329
§ 50. Штучне дихання. Методика та техніка проведення штучної вентиляції легень ................................................................ 331
§ 51. Непрямий масаж серця як спосіб відновлення діяльності серцево-судинної системи, методика його
§ 52. Застосування автоматичного зовнішнього дефібрилятора .........
§ 53. Техніка проведення реанімаційних
рятівниками .......................................................................
§ 54. Види
до захисту свого життя, життя рідних,
співгромадян... Прийде розуміння, що, за великим рахунком, — це і є захист України. Бо Україна — це власне ви, ваші рідні й друзі!
Попереду доросле життя, у якому — що на довгій ниві: практичні вміння й навички, здобуті під час вивчення курсу «Захист України», колись можуть стати в пригоді.
У таблиці, поданій перед змістом (див. с. 3), наведено перелік розділів, які ви вивчатимете протягом двох років. Під час навчально-польових зборів теоретичні знання набудуть практичного втілення: ви вправлятиметеся в тактичній, вогневій, стройовій підготовці. Структура підручника чітка й зрозуміла. Запитання на початку параграфа (вони надруковані кольоровим шрифтом) налаштують
теріалу. У тексті підручника нові терміни виділено півжирним шрифтом. Слова або речення, які мають важливе значення, подано курсивом. Чимало знань відомі вам з курсів, які ви вивчали в минулі роки («Біологія», «Основи здоров’я», «Правознавство», «Історія України» тощо).У підручнику багато піктограм — умовних позначень, зміст яких подаємо нижче.









Рубрика «Пригадаймо!» містить запитання, які спонукають відновити в пам’яті вже відоме.
Рубрика «Запам’ятаймо!» позначає, що інформація, подана в ній, має
особливе значення, її потрібно пам’ятати.
Рубрика «Це потрібно вміти робити!» містить відомості, спрямовані на вироблення та закріплення практичних навичок. Такі вміння допоможуть впоратися зі складними ситуаціями, зберегти здоров’я й життя як ваше, так й інших людей.
Рубрика Nota Bene (N. B.) (з лат. Notа Bene — зверни увагу звертає вашу увагу на особливо важливі твердження.
Рубрика «Ерудит–ONLINE» містить інформацію, що ознайомлює з цікавими відомостями. Ваша здатність до сприйняття будь-якої інформації має бути «ввімкнена» повсякчас, тобто працювати «в режимі онлайн». Рубрика «Маю честь» розповідає про конкретні випадки

Пригадайте з курсів «Історія України», «Українська література», «Правознав-ство», яку роль виконували Збройні сили України (ЗСУ) на різних етапах розвитку України як держави. Наведіть приклади.
Військово-патріотичне виховання — складова патріотичного виховання молоді Частиною системи національного виховання є військово-патріотичне, що передбачає формування високого ідеалу служіння народові, готовності до трудового
ської держави. Воно покликане формувати громадянина-патріота, готовність у будь-який час стати на
військово-технічними знаннями, спонукати
лення, а також
простору країни. Найвищу юридичну силу в нашій країні
військового законодавства. Згідно зі статтею 17 Конституції України, «захист суверенітету і територіальної цілісності України, забезпечення її економічної та інформаційної безпеки є найважливішими функціями держави, справою всього Українського народу». У статті 65 зазначено, що «захист Вітчизни, незалежності й територіальної цілісності України, шанування її державних символів є обов’язком громадян / громадянок України»

стану. Зміст навчального матеріалу предмета охоплює нормативи, які рекомендовані для відпрацювання під час проведення занять. Закріплення рівня знань, умінь і навичок відбудеться під час навчально-польових занять. Розділ «Основи національної безпеки України» дає поняття про систему світової колективної безпеки та національної безпеки держави. У ньому розглянемо структуру воєнної організації держави, воєнне та міжнародне військове співробітництво. Також отримаєте поняття про національні інтереси держави, загрози її національній безпеці, воєнну доктрину та основні засади забезпечення кібербезпеки України. Зміст розділу «ЗСУ на захисті України» розкриває основи законодавства про призначення, структуру
службу, висвітлює історію українського війська; сприяє формуванню людини-патріота, захисника України. У розділі також формуються уявлення
про закони військової
кож навчання основам самозахисту.
вами теорії стрільби, оволодіння
ручних гранат.
вих занять (зборів). Заняття з предмета «Захист України» в усіх закладах загальної середньої освіти рекомендується починати з ви-конання гімну України. Рекомендована форма одягу для учнів/учениць під час проведення занять з предмета «Захист України» - військова (форма збройних формувань України).
Обов’язки та правила поведінки учнів / учениць на уроках Ваша дисципліна, організованість і відповідальність є запорукою успішності занять із «Захисту України». Стосунки на заняттях між вами та вчителем, а також між собою наближені до статутних стосунків між військовослужбовцями Збройних сил України.

1. У чому полягає призначення ЗСУ та інших військових формувань?
2. Що передбачає обов’язок громадян / громадянок України перед державою

3. Поясніть, що ви очікуєте від
4. Чому, на вашу думку, ЗСУ є гарантом національної безпеки держави?
5. Чому важливо володіти основами цивільного захисту?

покликані дбати про єдність

безпеки , як сукупність спільних заходів держав
підтримання миру, запобігання війні, припинення актів агресії та надання колективної допомоги. Колективна безпека є системою спільних дій держав, установленою Статутом ООН для підтримки міжнародного миру й безпеки, запобігання (придушення) агресії. Наріжним каменем колективної безпеки є розуміння, що світ є неподільним, і кожний член системи має прийти на допомогу іншим дипломатичними засобами, економічними акціями і в екстремальних випадках — військовими засобами. Створення системи колективної безпеки передбачає застосування комплексу заходів
загрози. Загальна зацікавленість держав у справі збереження міжнародного правопорядку сприяла створенню системи колективної безпеки.
Колективна безпека як система спільних дій держав містить такі елементи: а) загальновизнані принципи сучасного міжнародного права, найважливішими з яких є принцип незастосування сили, непорушності кордонів, територіальної цілісності, невтручання у внутрішні справи; б) колективні заходи для запобігання й усунення загрози миру; в) колективні заходи з обмеження та скорочення озброєнь, аж до повного роззброєння.

Колективні заходи для запобігання й усунення
актів агресії як елемент колективної безпеки — це дії збройного або неозброєного характеру, що здійснюють групи
ональні та універсальні організації,
пеки України
розвитку країни та її інтеграції
співтовариство.

У Законі України «Про національну безпеку України» зазначено, що національна безпека — це захищеність державного суверенітету, територіальної цілісності, демократичного конституційного ладу та інших національних інтересів України від реальних та потенційних загроз.
Відповідно

ситуацій. Основними принципами, що
ної політики у сферах національної
і
є: верховенство права, підзвітність, законність, прозорість та дотримання засад демократичного цивільного контролю за функціонуванням сектору безпеки і оборони та застосуванням сили; дотримання норм міжнародного права, участь в інтересах України у міжнародних зусиллях з підтримання миру і безпеки, міждержавних системах та механізмах міжнародної колективної безпеки; розвиток сектору безпеки і оборони як основного інструменту реалізації державної політики у сферах національної безпеки і оборони.
Державна політика у сферах національної безпеки і оборони спрямовується на забезпечення воєнної, зовнішньополітичної, державної, економічної, інформаційної, екологічної безпеки, кібербезпеки України тощо. Стратегія національної безпеки України визначає:
1) пріоритети національних інтересів України та забезпечення національної безпеки, цілі, основні напрями державної
нальної безпеки;
2) поточні та
3) основні напрями зовнішньополітичної діяльності держави для
4) напрями та завдання реформування й розвитку сектору
ни;
5) ресурси, необхідні для її реалізації. Гібридна
є створення державою-агресором

конфлікті
інформаційну, кібер-
2.1 ).
Іншим прикладом гібридної війни, у якій
жава-агресор домовляється із недержавними виконавцями — групами місцевого населення та бойовиками, зв’язок із якими вона формально заперечує, є російська диверсійна діяльність в Україні навесні 2014 р. ( іл. 2.2 ).
Під час конфлікту групи російських військовослужбовців організовували та координували
озброєні загони сепаратистів


організація держави (ВОД)
сукупність органів державного управління
ним будівництвом, оборонно-промислового і наукового комплексів держави, військових формувань, призначених для виконання завдань безпеки воєнними методами, а також нормативно-правова база, що визначає функції, права, обов’язки всіх елементів ВОД. Воєнну організацію створює держава для захисту особи, суспільства й державного ладу, забезпечення зовнішньої та внутрішньої безпеки передусім для відбиття зовнішньої агресії, що зазіхає на суверенітет, територіальну цілісність і соціально-політичний устрій держави, а також для придушення внутрішніх протиправних виступів, що загрожують суспільному ладу та політичному режиму. Структура ВОД залежить від рівня розвитку суспільства, характеру політичного устрою, соціально-економічної бази, а також від розвитку засобів збройної боротьби, умов внутрішньої і зовнішньополітичної обстановки. Зокрема, у воєнний час в рамках ВОД можуть додатково створюватися партизанські формування, народні ополчення, поліцейські (жандармські) та інші частини. В Україні Воєнну організацію розуміємо як

державної влади, військових формувань, утворених відповідно до законів України, діяльність яких
демократичним цивільним контролем з боку суспільства і безпосередньо спрямована на захист національних інтересів
зовнішніх загроз. Закон України «Про демократичний цивільний контроль над Воєнною організацією і правоохоронними
конкретне тлумачення терміну Воєнна організація. Згідно з ним, це охоплена єдиним керівництвом сукупність органів державної влади, військових формувань, утворених відповідно до Конституції і за-конів України, діяльність яких
вий компонент системи охоплює Державну прикордонну службу України, Національну гвардію України , яка є в структурі Міністерства внутрішніх справ, військові підрозділи Управління державної охорони України, Служби безпеки України, Державна служба надзвичайних ситуацій (ДСНС) та інші державні військові формування. Нормативно-правову базу ВОД як інструмента національної безпеки формують Закони України «Про національну безпеку України», «Про оборону України», «Про Раду національної безпеки і оборони України», «Про Збройні сили України», а також Стратегія національної безпеки і Стратегія воєнної безпеки України, які розмежовують права та функції державних органів України як складових воєнної організації.

1. Що ви розумієте під поняттям «світова колективна безпека»?
2. На яких основних принципах ґрунтується колективна безпека різних держав?
3. Що є об’єктом і суб’єктом національної безпеки держави?
4. Які методи є типовими компонентами гібридної війни?

5. Охарактеризуйте Воєнну організацію держави Україна.
6. У чому, на вашу думку, різниця між


сталий розвиток національної економіки, громадянського суспільства і держави для забезпечення зростання рівня та якості життя населення; інтеграція України в європейський політичний, економічний, безпековий, правовий простір, набуття членства в Європейському Союзі та в Організації Північноатлантичного договору, розвиток рівноправних взаємовигідних відносин з іншими державами.

Явища, тенденції та чинники, що унеможливлюють чи ускладнюють або можуть унеможливити чи ускладнити реалізацію національних інтересів та збереження національних цінностей України, є загрозою національній безпеці країни . Загрози національній

їни і затверджують укази Президента України. За спрямованістю загрози національній безпеці, управління, якими може здійснювати недержавна
безпеки, поділяють на такі види: загрози конституційним правам
і громадянина, індивідуальній, груповій та суспільній
духовному відродженню України; загрози недержавному забезпеченню державної політики нацбезпеки України; загрози розвитку
ціональної
продукції на світовий ринок, а також забезпеченню накопичення, збереження та ефективного використання вітчизняних ресурсів; загрози безпеці систем і засобів безпеки як уже розгорнутих, так і таких, що створюють на території України. Також до загроз віднесено
та воєнно-економічні аспекти, була ухвалена Указом Президента України від 15 червня 2004 року.
Третя редакція Воєнної доктрини України ухвалена РНБО України 2 вересня 2015 року в умовах російської
2014–2015 рр. і введена в дію 24
редакцію
доктрини України». Указом президента України Володимира Зеленського
2021 року «Про рішення ради національної безпеки і оборони України від 25 березня 2021 року «Про стратегію воєнної безпеки України» Воєнна доктрина України як концепція національної безпеки була скасована та замінена відповідно Стратегією воєнної безпеки. У Стратегії воєнної безпеки України сказано, що
самовизначення, збереження
розвитку
громадян усіх національностей. Захист суверенітету
на суші, на морі та в повітряному просторі України, протидії
та нав’язуванні своєї волі в інформаційному просторі; використанні для відсічі агресії
держави та суспільства (воєнного, політичного, економічного, міжнародно-правового (дипломатичного), духовного, культурного тощо); застосуванні всіх форм і способів

17
сфері, сфері оборони і військового будівництва. Соціально-політичні, економічні та інші умови реалізації державної політики у воєнній сфері, сфері оборони і військового будівництва, воєнно-політичні та воєнно-стратегічні обмеження.
Шляхи досягнення цілей державної політики у воєнній сфері, сфері оборони і військового будівництва.
Ресурсне задоволення потреб оборони України.
Перспективна модель організації оборони України,
їни та інших складових

воєнної безпеки держави та забезпеченні її національних інтересів у сфері оборони; створенні й поширенні у світі образу України та ЗСУ як надійного партнера з прогнозованою політикою; зміцненні воєнно-політичної і воєнної безпеки, стабільності в Європейському регіоні та у світі в цілому, сприянні реалізації стратегії держави щодо входження до Євроатлантичних та Європейських структур безпеки;
досягненні відповідності ЗСУ сучасним вимогам, забезпеченні їх спроможності виконувати спільно з підрозділами збройних сил інших держав завдання, що відповідають інтересам національної безпеки та міжнародним зобов’язанням України; підвищенні науково-технічного й оборонно-промислового потенціалу України та ЗСУ. МО України здійснює міжнародне співробітництво на двосторонній, багатосторонній
основі (іл. 3.2), а також у рамках міжнарод-
них організацій. Основними напрямами міжнародного співробітництва українського військового відомства є воєнно-політичний, військовий і військово-технічний. Крім того, ЗСУ співпрацюють з іншими країнами у воєнно-науковій, воєнно-економічній, інформаційній, екологічній галузях тощо. Варто зазначити, що курс на європейську інтеграцію надає можливість залучитися до розбудови Іл. 3.2. Обговорення в кулуарах

. Українське військове відомство здійснює співробітництво
90 країнами світу. Зокрема, на основі міжнародно-договірної бази — приблизно з 60 країнами.
Миротворчість як комплексне воєнно-політичне явище набуває дедалі більшого поширення в зовнішньополітичній діяльності багатьох держав. Україна за обсягом завдань — як минулими, так і актуальними — увійшла до першої двадцятки найактивніших держав-миротворців.

Іл. 3.3. Українські миротворці
Військовослужбовці ЗСУ виконували завдання щодо підтримання миру в операціях під егідою ООН, НАТО. Починаючи з 1992 року, у міжнародних операціях з підтримання миру і безпеки взяло участь понад 42 000 українських
бовців, з яких 54
і понад 100 зазнали поранень. Військовослужбовці нашої держави
участь у операціях з підтримання миру в африканських країнах, колишній Югославії, Лівані, Таджикистані, Грузії, Афганістані, Молдові, Іраку тощо ( іл. 3.3 ).
Багатьох миротворців ЗСУ за зразкове виконання завдань було нагороджено урядовими нагородами іноземних держав, ООН і НАТО (медалями «За службу миру», «За участь у миротворчій операції в регіоні конфлікту», «За службу в Боснії та Герцеговині», «За службу в Косово»).
Послідовно нарощуючи свій внесок у превентивну миротворчу діяльність, Україна сприяє
тривалим і сягає корінням у 1990-ті роки. Є два основні елементи партнерства з Україною: політичний діалог і практична співпраця. З 1997 року відбуваються політичні консультації через комісію Україна — НАТО. Були регулярні дискусії з питань, що стосуються прикордонної безпеки, відбувалися політичні візити на високому рівні. Триває процес політичної взаємодії між НАТО як Альянсом. Україна також брала участь у місіях і операціях НАТО від Косова до Афганістану. Іл. 3.4. Зустріч міністрів оборони країн НАТО у штаб-квартирі Альянсу

Важливо підкреслити, що практична співпраця зросла з 2014 року. Відтоді, а саме з 2014 року по лютий 2022 року, було проведено багато заходів із самооборони, протидії гібридним загрозам, стійкості, цивільної готовності, протидії саморобним вибуховим пристроям. Євроатлантичне партнерство сприяє зміцненню національної безпеки нашої держави. Тому основні зусилля співробітництва України з НАТО в питаннях безпеки й оборони зосереджено на створенні ефективної системи оборонного планування та підвищення обороноздатності; спрямовано на досягнення взаємодії з військовими формуваннями Альянсу в рамках програми «Партнерство
планування та
ну підготовку особового складу, соціальні аспекти воєнної реформи. Статус великої регіональної держави
співробітництва цілком відповідає національним інтересам нашої
з важливих механізмів включення країн Південно-Східної Європи до процесів загальноєвропейської інтеграції.
Триває розвиток співпраці з країнами Вишеградської четвірки (Польща, Чехія, Словаччина, Угорщина). Зокрема, Україна зацікавлена в євроінтеграційному досвіді, у розвитку прикордонного співробітництва в контексті розширення Євросоюзу.
Перспективи вступу України в НАТО. Україна подала заявку на вступ до НАТО за пришвидшеною процедурою
лося стати ним де-юре.
У червні 2022 року на саміті НАТО в Мадриді було затверджено нову Стратегічну концепцію Альянсу . Там було позначено основні напрями майбутнього розвитку організації.
Позиція Альянсу полягає в тому, що кожна демократична
країна в Європі має право подати заявку на членство в НАТО.

Союзники по Альянсу дуже поважають це право. У Стратегічній концепції чітко написано, що двері НАТО залишаються відкритими. У довгостроковій перспективі, звичайно, двері НАТО залишаються відкритими, але рішення про членство ухвалюється консенсусом усіх 30 членів Альянсу.

1. Який Закон України визначає поняття «національні інтереси держави»?
2. Що є пріоритетами національних інтересів України?
3. Яка головна мета Стратегії воєнної безпеки України.

4. Складіть колективний коментар поданої праворуч графічної інтерпре-

5. Яка основна мета міжнародного співробітництва Збройних
6.
Національні інтереси Забезпечення воєннополітичного університету країни Досягнення населенням
України в НАТО?


із прийняттям Закону України «Про основи національного спротиву» . З метою створення та забезпечення функціонування окремого роду сил — Сил територіальної оборони Збройних сил України, створення якого передбачено Законом «Про основи національного спротиву», а також розвитку Сил спеціальних операцій Збройних сил України в інтересах формування руху опору Законом збільшено чисельність Збройних сил України на 11 000 військовослужбовців, тобто загальна чисельність Збройних сил України повинна становити 261 000 осіб, у тому числі 215 000 військовослужбовців .
Документ був введений в дію з дня введення в дію Закону «Про основи національного спротиву».

Згідно Закону України
ються
ний
Правову основу національного спротиву становлять Конституція України, Закони України «Про оборону України», «Про основи національного спротиву» тощо, «Стратегія воєнної безпеки України» (2021), міжнародні договори, згоду на обов’язковість яких надала Верховна Рада України, інші нормативно-правові акти.
Закон України «Про основи національного спротиву» належить до законів, покликаних максимально швидко підвищити обороноздатність держави. Документ було розроблено і схвалено в умовах наростання загрози переходу російсько-української війни в гостру фазу і повномасштабної військової агресії російської
Метою національного спротиву є підвищення обороноздатності держави, надання обороні України всеохоплюючого характеру, сприяння забезпеченню готовності громадян України до національного спротиву.
Складниками національного спротиву є:
територіальна оборона;
рух опору;
підготовка громадян України до національного спротиву.
Загальне керівництво національним спротивом здійснює Президент України як Верховний головнокомандувач Збройних сил
Міністерство оборони України.
Фінансування та матеріально-технічне забезпечення
України, місцевих бюджетів, а також
законодавством України джерел.

чальності, централізації управління
і контрольованої автономності
оборони, активності, рішучості та безперервності ведення територіальної оборони, наполегливості у досягненні мети територіальної оборони, узгодженого, спільного застосування сил і засобів, залучених до ведення територіальної оборони, безперервності взаємодії сил і засобів територіальної оборони, всебічного врахування і повного використання моральних та психологічних факторів.
Територіальну оборону ведуть на всій території України поза межами бойових дій. Сили територіальної оборони визначено як окремий (п’ятий) рід сил ЗСУ (після Сухопутних, Повітряних, Військово-Морських та Сил спеціальних операцій). Територіальна оборона заснована на тісній взаємодії військових підрозділів (військові бригади в кожній області та батальйони в кожному районі) і добровольчих формувань територіальних

2)
3) участь
дій;
4) участь у підготовці громадян України до національного спротиву;
5) участь у забезпеченні умов для безпечного функціонування органів державної влади, інших державних органів, органів місцевого самоврядування та органів військового управління;
6) участь в охороні та обороні важливих об’єктів і комунікацій, інших критично важливих об’єктів інфраструктури, визначених Кабінетом Міністрів України, та об’єктів обласного, районного, сільського, селищного, міського значення, районного у містах рад, сільських, селищних, порушення функціонування та виведення з ладу яких становлять загрозу для життєдіяльності населення;
7) забезпечення умов для стратегічного (оперативного) розгортання військ (сил) або їх перегрупування;
8) участь у здійсненні заходів щодо тимчасової заборони або обмеження руху транспортних засобів і пішоходів поблизу та в межах зон/районів надзвичайних ситуацій та/або ведення воєнних (бойових) дій;
9) участь у забезпеченні заходів громадської безпеки і порядку в населених пунктах;
10) участь
правового режиму воєнного стану в разі його введення
її місцевостях;
11) участь у боротьбі з диверсійно-розвідувальними силами, іншими збройними формуваннями агресора (противника) та не передбаченими законами України воєнізованими або збройними формуваннями;
12) участь в інформаційних заходах, спрямованих на підвищення рівня обороноздатності держави та на протидію інформаційним операціям агресора (противника);
13) участь у наданні населенню правових послуг у порядку, передбаченому Законом України «Про безоплатну правову допомогу».
Вона складається з військової, цивільної та військово-цивільної складових.
Військова складова територіальної оборони включає органи військового управління, військові частини Сил територіальної оборони Збройних сил України, інші сили і засоби сил
до виконання
Військово-цивільна складова територіальної
зон (районів) територіальної оборони та добровольчі формування територіальних громад, які залучаються до територіальної оборони.

3 травня 2022 року Верховна Рада України прийняла зміни до Закону України «Про основи національного спротиву», згідно яких дозволяється застосування Територіальна оборона ЗС України в районах ведення бойових дій. Рух опору , який розгортають на тимчасово окупованих територіях або території України, захопленої противником під час збройної агресії проти України, — система воєнних, інформаційних і спеціальних заходів, організацію, планування, підготовку й підтримку яких здійснюють з метою відновлення державного суверенітету
тери-торіальної цілісності під
України. Учасниками, крім громадян
земці та особи без громадянства.
Завданнями руху опору є:
1) формування осередків руху опору та набуття ними відповідних спроможностей;
2) перешкоджання діям військ (сил) агресора (противника);
3) участь у проведенні спеціальних (розвідувальних, інформаційно-психологічних тощо) операцій;
4) участь у підготовці громадян України до руху опору. Заходи з організації, планування і підготовки
в мирний час та особливий

у встановленому
Військовослужбовці, працівники правоохоронних
та інші особи, які залучаються до заходів з організації, підготовки, підтримання та виконання завдань руху опору, на час проведення таких заходів підпорядковуються Командувачу Сил спеціальних операцій
сил України, рішення якого є обов’язковими до виконання.

Підготовка громадян України до національного спротиву (загальновійськова підготовка громадян) — сукупність заходів із метою формування патріотичної свідомості та стійкої мотивації громадян, набуття ними знань і практичних умінь, необхідних для захисту України.
Серед завдань такої підготовки: а) сприяння набуттю громадянами України готовності та здатності виконувати конституційний обов’язок щодо захисту Вітчизни, незалежності та територіальної цілісності України; б) військово-патріотичне виховання громадян України; в) підготовка населення до умов життєдіяльності в районах ведення (воєнних) бойових дій.
Загальновійськова підготовка організовується за територіально-зональним принципом, ґрунтується на засадах високої мотиваційної привабливості та узгоджується з процесом трансформації системи комплектування за призовом відповідно до
підготовки
України до національного спротиву . Загальновійськова підготовка громадян здійснюється в мирний час та особливий
від політичних
інших вподобань, статі, етнічного та соціального
стану, місця проживання з
стійкого
агресору, зокрема в інформаційному просторі, патріотичної свідомості та стійкої мотивації, набуття та
для захисту України. Загальновійськову підготовку проходять громадяни допризовного, призовного віку, військовозобов’язані, резервісти та інші категорії, які виявили бажання долучитися до національного спротиву.
Загальновійськова підготовка громадян України полягає

занять, курсів ( іл. 4.3 ).
Повноваження сил безпеки та сил оборони з питань
їни» до сил безпеки належать правоохоронні та розвідувальні органи, державні органи спеціального призначення з правоохоронними функціями, сили цивільного захисту та інші органи, на які Конституцією та законами України покладено функції із забезпечення національної безпеки України, а до сил оборони — Збройні сили України, також інші утворені відповідно до законів України військові формування, правоохоронні та розвідувальні органи, органи спеціального призначення з правоо-хоронними функціями, на які Конституцією та законами України покладено функції із забезпечення оборони держави. Закон України «Про основи національного спротиву» надає силам безпеки та оборони України певні повноваження, а саме: 1. Генеральний штаб Збройних сил України:
1) забезпечує реалізацію Головнокомандувачем Збройних сил України повноважень щодо керівництва територіальною обороною та рухом опору;
2) організовує планування територіальної оборони в рамках стратегічного планування застосування Збройних сил України, інших складових сил оборони;
3) здійснює в межах, визначених законодавством України, контроль за підготовкою та станом готовності сил і засобів, які сплановані до виконання завдань територіальної оборони.
2. Командування Сил територіальної оборони Збройних сил України (іл. 4.4):
1) організовує територіальну оборону в межах сухопутної території України;
2) розробляє проект Зведеного плану територіальної оборони України та бере участь у розробці проекту Стратегічного плану застосування Збройних сил України та інших складових сил оборони;
3) готує пропозиції щодо концептуальних засад функціонування територіальної оборони, напрямів її розвитку;
4)

6) організовує створення і забезпечення функціонування системи
7) організовує і координує інформаційно-аналітичну діяльність, необхідну для підготовки та ведення територіальної оборони;
8) вивчає, аналізує та оцінює обстановку, яка впливає на підготовку і ведення територіальної оборони, розробляє прогнози її можливого розвитку;
9) розробляє та доводить до органів управління, сили і засоби яких залучаються до виконання завдань територіальної оборони, а в особливий період також до центральних і місцевих органів виконавчої влади, накази і директиви з питань територіальної оборони Верховного Головнокомандувача Збройних сил України, Головнокомандувача Збройних сил України, Командувача Сил територіальної оборони Збройних сил України, організовує їх виконання і здійснює контроль за їх реалізацією;
10) визначає перелік військових частин Сил територіальної оборони Збройних сил України та добровольчих формувань територіальних громад, які залучаються до посилення охорони та захисту сухопутних ділянок державного кордону України; 11) узагальнює потребу в особовому складі, військовій, спеціальній та іншій техніці, озброєнні, боєприпасах, паливно-мастильних, інших матеріально-технічних, енергетичних, фінансових, інформаційних ресурсах, продовольстві, земельних ділянках, комунікаціях, фондах та майні, необхідних для розгортання (формування та доукомплектування) військових частин Сил територіальної оборони Збройних сил України та сил і засобів, які сплановані
12)
завдань територіальної
нету Міністрів України
ших центральних органів виконавчої
територіальної оборони;
13) організовує проведення навчань (тренувань), оперативно-польових поїздок з територіальної оборони та
ціонального спротиву;
14) організовує та підтримує взаємодію з органами військового управління Збройних сил України, органами управління інших складових сил безпеки та сил оборони, сили і
завдань територіальної оборони;
15) розробляє проекти Доктрини
1)
2)
3)
реалізацію керівником регіонального органу військового управління Сил територіальної оборони Збройних сил України повноважень щодо організації та керівництва територіальною обороною у військово-сухопутній зоні відповідальності;
4) організовує створення та забезпечення функціонування системи управління територіальною обороною у військово-сухопутній зоні відповідальності, здійснює контроль за її станом;
5) організовує і координує інформаційно-аналітичну діяльність, необхідну для ведення територіальної оборони у військово-сухопутній зоні відповідальності;
6) вивчає, аналізує та оцінює обстановку, яка впливає на підготовку та ведення територіальної оборони, розробляє прогнози її можливого розвитку у військово-сухопутній зоні відповідальності;
7) організовує планування територіальної
8) розробляє та доводить до регіональних
нів виконавчої
зоні; 9) готує пропозиції щодо переліку військових частин
залучаються до посилення охорони та захисту сухопутних
що сплановані до виконання завдань територіальної оборони у військово-сухопутній зоні відповідальності; 11) визначає потребу в особовому складі, військовій, спеціальній та іншій техніці, озброєнні, боєприпасах, паливно-мастильних, інших матеріально-технічних, енергетичних, фінансових, інформаційних ресурсах, продовольстві, земельних ділянках, комунікаціях, фондах
1)
реалізацію Командувачем Сил спеціальних операцій Збройних сил України повноважень щодо управління діями руху опору;
2) організовує та здійснює заходи з підготовки, ведення та підтримки руху опору, а також забезпечує контроль за їх виконанням;
3) розробляє проект Положення про рух опору;
4) бере участь в розробці проектів законів України та інших нормативно-правових актів з питань руху опору;
5) подає необхідні розрахунки та пропозиції, аналітичні матеріали для прийняття Командувачем Сил спеціальних операцій Збройних сил України рішень з питань руху опору;
6) вивчає, аналізує та оцінює обстановку, яка впливає на здійснення заходів щодо підготовки та ведення руху опору, розробляє
зміну обстановки;
7) готує
8) організовує виконання наказів та директив з питань руху опору;
9) здійснює відбір осіб, які
стати учасниками руху опору;
10) визначає потреби
ведення руху опору;
11) створює і використовує інформаційні,
та забезпечення виконання завдань руху опору;
12) готує та надає пропозиції Головнокомандувачу Збройних сил України щодо залучення сил і засобів сил безпеки
підготовки, підтримання
13) спрямовує та координує
сил України до здійснення заходів з організації, підготовки та виконання завдань руху опору сил і засобів
рони;
14) організовує документування
4)
5)
(тренуваннях), оперативно-польових поїздках з територіальної оборони, забезпечують участь у них підпорядкованих сил і засобів;
6) забезпечують використання навчальної матеріально-технічної бази військових частин, центрів підготовки, полігонів для підготовки військових частин Сил територіальної оборони Збройних сил України та громадян України до національного спротиву.
Національна поліція України, Національна гвардія України, Служба безпеки України, Державна прикордонна служба України, Державна служба спеціального зв’язку та захисту інформації України, Державна спеціальна служба транспорту, Управління державної охорони України, центральний орган виконавчої влади, що реалізує державну політику у сфері цивільного захисту:
1) беруть участь у проведенні аналізу
обстановки, яка впливає на виконання завдань територіальної оборони та руху опору;
2) беруть участь у плануванні територіальної оборони;
3) беруть участь у створенні системи управління територіальною обороною;
4) здійснюють підготовку підпорядкованих сил і засобів, що залучаються до територіальної оборони, та управління ними під час виконання завдань територіальної оборони;
5) підтримують взаємодію під час підготовки та виконання завдань територіальної оборони;
6) беруть участь у навчаннях (тренуваннях), оперативно-польових поїздках з територіальної оборони, забезпечують участь
ваних органів та підрозділів. Національна поліція України та Служба безпеки України також проводять у визначеному законодавством України порядку
спеціальну перевірку кандидатів на посаду командира добровольчого формування територіальної громади.

1. Що таке «національний спротив»?
2. Що визначає Закон України «про основи національного спротиву»?
3. Що становить правову основу національного спротиву?
4. Які складники національного спротиву вам відомі?
5. Назвіть завданнями територіальної оборони України.
6.
7.


них думок, вичерпну
користь організатора інформаційної пропаганди. Як наслідок, відбувається усвідомлення окремих фактів чи подій у потрібному для маніпулятора світлі, формування потрібного світогляду чи життєвої позиції стосовно питань, у яких раніше були протиріччя чи нерозуміння.
Мета інформаційної війни — послабити моральні і матеріальні сили супротивника або конкурента та посилити власні. Вона передбачає заходи пропагандистського впливу на свідомість людини в ідеологічній та емоційній галузях. Очевидно, що інформаційна війна — складова
ідеологічної боротьби. Вони не призводять безпосередньо до кровопролиття, руйнувань, при їх веденні
логії, психології
а часом і перевищують наслідки збройних воєн.
1) створення в
негативного ставлення до культурної спадщини;
2) маніпулювання суспільною свідомістю і
орієнтацією груп населення держави з метою створення політичної напруги і хаосу;
3) дестабілізація політичних відношень між партіями, об’єднаннями та рухами з метою провокації конфліктів, розпалення недовіри, підозрілості, загострення політичної боротьби, провокування репресій проти опозиції і навіть громадянської війни;
4) зниження рівня інформаційного забезпечення органів влади й управління, ініціація помилкових управлінських рішень;
5) дезінформування населення про роботу державних органів, підрив їх авторитета, дискредитація органів управління;
6) провокування соціальних, політичних, національних і релігійних
нень;
7) ініціювання страйків,
8)

Інформаційна війна , як найвищий ступінь інформаційного протиборства, спрямована на розв’язання суспільно-політичних, ідеологічних, а також національних, територіальних та інших конфліктів між державами, народами, націями, класами й соціальними групами шляхом широкомасштабної реалізації засобів і методів інформаційного насильства (інформаційної зброї).
Основні методи інформаційної війни — блокування
спотворення інформаційних потоків та процесів прийняття рішень супротивника. Інститут національно-стратегічних досліджень США та деякі західні експерти і вчені виокремлюють сім складників інформаційних воєн:
1. Стратегія й тактика нейтралізації органів управління противника (командна війна).
2. Розвідувальна війна.
3. Електронна війна.
4. Психологічна війна.
5. Комп’ютерна війна.
6. ІВ у економічній сфері.
7. Інформаційний тероризм. Основними компонентами інформаційної війни у військовій сфері прийнято вважати: розвідку; контррозвідку (насамперед, протидію розвідці противника, включаючи маскування та дезінформацію); радіоелектронну боротьбу; автоматизоване управління військами і зброєю; з’ясування державної належності військових об’єктів, їх ідентифікацію; навігаційне забезпечення своїх військ (сил) і засобів; морально-психологічне забезпечення дій власних військ (сил), психологічну
тивника.
Інформаційні війни ведуться в двох площинах: гуманітарній (інформаційно-психологічна війна); технічній (інформаційно-технічна війна).
Гуманітарна площина: деструктивний вплив на населення (цивільних та військових) семантично визначеної інформації. Таку інформаційну війну називають інформаційно-психологічною ( фейк «Розіп’ятий хлопчик ). В інформаційних війнах такого типу мова йде про нав’язування моделі світу (картини світ, світогляду) для прогнозування бажаного типу поведінки. Класичним прикладом є війна


Україні». Автор статті — Том Парфітт повідомляв про таємний план «Троя», який у листопаді 2014 надіслав до Кремля колишній
заворушень, а шпигуни вже діяли на місці подій. Йшлося про стратегію підготовки населення Запорізької області до проросійського заколоту у регіоні, або як подавав це Муратов — «визволення від фашистських окупантів». Цей план, як наголошував автор, був частиною ширшого плану Кремля з дестабілізації України. Все це увійшло до доповіді, з якою ознайомився кореспондент британського часопису. Доповідь ґрунтувався на витоках інформації з листів електронної
Владислава Суркова.
Технічна площина: цілеспрямована
реваги шляхом нанесення шкоди інформації, інформаційним процесам, інформаційним системам супротивника при одночасному захисті власної інформації, інформаційним процесам та інформаційним системам. Щодо цілей атак в інформаційній війні, то чим залежніший супротивник від інформаційних систем при ухваленні рішення, тим більше він уразливий до ворожого маніпулювання цими системами. Програмні віруси впливають тільки на ті системи, у яких є програми. Чим сучасніше суспільство, тим більше воно покладається на інформацію та засоби її доставки. Сюди відноситься також Інтернет — але це лише вершина цієї інформаційної конструкції. Будь-яка розвинена країна має телефонну, банківську та безліч інших мереж, що керуються комп’ютерами, отже мають властиві для них слабкі місця. У найбільш широкому сенсі інформаційна війна включає засоби пропаганди.
Генеральна мета інформаційної війни , таким чином, — порушити обмін інформацією в таборі конкурента. Неважко зрозуміти, що цей вид зброї, як правило, взагалі
і, найчастіше, невидимі війни, та що об’єктами впливу є, насамперед, громадські інститути суспільства і держави — економічні, політичні, соціальні, тощо. Крім того, військова стратегія використання інформаційної
сектором
лежати.
від реальності. Також російська пропаганда стрімка, безперервна, повторювана, але їй бракує внутрішній узгодженості. Дослідження з експериментальної психології свідчать, що такий підхід може бути досить ефективним. Крім того, саме ті чинники, які роблять подібну
збройних сил до АР Крим супроводжувалось
2.
но-східних регіонів.
5. Психологічна підтримка українських прихильників радикального
зближення регіонів Сходу й Півдня України з РФ. Зазначені завдання реалізувались через майже повний спектр
комунікацій, до яких передусім слід
1. Традиційні ЗМІ.
2. Електронні ЗМІ (телебачення).
3. Інтернет ЗМІ.
4. Соціальні мережі. При цьому використовувалися усі методи інформаційно-психологічної боротьби — від розміщення тенденційної інформації та напівправди до неприхованої неправди («фейку»).

3 серпня 2016 року було опубліковано архів поштової скриньки співробітниці так званого МДБ «ДНР» Тетяни Єгорової, яка відповідала за роботу з журналістами. Архів містив листування між МДБ «ДНР» та представниками українських та закордонних ЗМІ (телеканал «Інтер», телеканал «Україна», ICTV, Gazeta Wyborcza і багатьох інших) в яких останні узгоджували зміст своїх телесюжетів та публікацій з побажаннями спецслужб «ДНР» та росії. Окрім того, архів
агентурної роботи
факт співпраці деяких журналістів зі спецслужбами терористів, який був опублікований центром «Миротворець» раніше.
Кібербезпека Кібербезпека — це комплекс процесів, практичних порад і технологічних рішень, які допомагають захищати важливі системи та мережу від кібератак.
В Україні функціонує Національний координаційний центр кібербезпеки ( іл. 5.1 ), який є робочим органом Ради національної безпеки і оборони України. Центр за-
безпечує координацію діяльності суб’єктів національної безпеки і оборони України


України «Про національну безпеку України» та «Про основні засади забезпечення кібербезпеки України», Конвенції про захист прав людини і основоположних свобод, Конвенції про кіберзлочинність, Стратегії національної безпеки України, Концепції боротьби з тероризмом в Україні, інших нормативно-правових актів.
Викликами для України у сфері кібербезпеки є: активне використання кіберзасобів у міжнародній конкуренції; змагальний характер розвитку засобів кібербезпеки в умовах швидких прогресуючих змін інформаційно-комунікаційних технологій, зокрема хмарних та квантових обчислень, 5G-мереж, великих даних, Інтернету речей, штучного інтелекту тощо; мілітаризація кіберпростору та розвиток кіберзброї, що дає можливість приховано проводити кібератаки для підтримки бойових дій і розвідувально-підривної діяльності у кіберпросторі; вплив пандемії COVID-19 на економічну діяльність та соціальну поведінку, що спричинив стрімку трансформацію і організацію значного сегмента суспільних відносин у дистанційному режимі
користанням електронних
невпинно нарощує
призначення, застосування якої
самперед,
системи державних органів України та об’єкти критичної інформаційної інфраструктури з метою виведення їх з ладу (кібердиверсія), отримання прихованого доступу і контролю, здійснення розвідувальної та розвідувально-підривної діяльності. Кібератаки також
речовин, які загрожують життю та здоров’ю людей тощо; організовані та спонсоровані урядами інших держав кібератаки, що пов’язані з викраденням у політичних, економічних або військових цілях чутливої інформації (кібершпигунство) та здійсненням розвідувально-підривної діяльності. Особливостями таких кібератак є їх тривалість, складність та прихований характер, що ускладнює їх попередження, виявлення та нейтралізацію; використання терористичними організаціями кіберпростору для вчинення актів кібертероризму, фінансової та іншої підтримки терористичної діяльності. Україна прагне створити максимально відкритий, вільний, стабільний і безпечний кіберпростір в інтересах забезпечення прав і свобод людини, соціального, політичного і економічного розвитку держави. Для подальшої розбудови

садах стримування, кіберстійкості, взаємодії необхідним є: посилення спроможності національної системи кібербезпеки
унеможливлення
ності, мінімізації
загроз у кіберпросторі, підтримувати
критичної інформаційної
і
забезпечення розвитку комунікації, координації та партнерства між суб’єктами забезпечення
стратегічних відносин у сфері кібербезпеки із ключовими
Союзом, Сполученими Штатами Америки та іншими державами — членами НАТО, співробітництво у цій сфері з
далеко до появи перших
мат і мінометів на кордоні між Україною та Росією. Така війна передбачає поєднання інструментів впливу й засобів підривної діяльності, які синхронно поєднуються для використання слабкостей іншої країни. Звісно, слабкості ці на-перед визначаються, аналізуються та збираються в окрему теку, умовно «слабкості країни Х».

Мовний чинник — найбільш вигідна пропозиція з усього «меню» слабкостей. Приклад продукування смислів гібридної війни в цьому аспекті ми всі добре знаємо: «відбувається насильницьке витіснення російської мови та переслідування російськомовних».
Гібридна війна має дві особливі ознаки:
1. Розмитість меж між війною і миром, коли не можна виділити якийсь поріг війни.
2. Невизначеність, коли складно взагалі ідентифікувати цю війну. У контексті гібридних технологій ведення сучасних військових протистоянь особливе значення мають так звані Сили спеціальних операцій (ССО) та специфіка їх комунікаційного забезпечення,

печних, інколи політично чутливих операцій, що проводить
різновид військової діяльності, який здійснюють спеціально створені сили, організовані, треновані та оснащені для цієї мети, які використовують оперативну техніку й методи, відмінні від традиційних військових. Характерними ознаками ССО є: прихованість дій; здатність виконувати операції, котрі приводять до тактичної або стратегічної переваги; спеціальна навченість та оснащеність; високий рівень спеціалізації; підвищений рівень адаптованості; мобільність та здатність проводити операції автономно; відносно невелика кількість особового складу; спроможність працювати у трьох середовищах (повітря, земля, море). До типових завдань ССО відносяться: рейди та сучасні бойові дії;
медична допомога; здобуття розвідувальної інформації
фронту; виявлення, ідентифікація та визначення цілей для власних засобів ураження;
антитерористичні операції. В Україні у 2015 році було розпочато процес створення власних ССО за стандартами НАТО. Каталізатором цього рішення, зрозуміло, стала російська агресія та війна на сході країни.
Серед завдань українських ССО: спеціальна розвідка; спеціальні заходи; контртерористичні заходи; прямі військові дії; аналіз і обробка інформації для випрацювання правильної стратегії та залучення необхідних ресурсів; нетрадиційні методи ведення війни — психологічні та інформаційні операції.

Аналізуючи типові функції окремих підрозділів та командування ССО, слід зробити висновок: один із провідних компонентів у їхній діяльності — робота із соціальними онлайн-мережами, які є фактично специфічним
вальної інформації.
Відповідно до технічних та комунікаційних можливостей віртуальних соціальних мереж, ССО можуть використовувати їх для: здійснення
спецоперацій (чутки, офіційні звернення, попередження);
дезінформації противника щодо
та завдань;
збирання розвідувальної
керівний склад;
координації
важко
За аналогією, технології web 2.0 в цьому контексті можна визначити як високоточну зброю, що може вражати не просто певні цільові групи, але й конкретних їх представників, чітко визначених персоналій. Така адресність та, за потреби, вибірковість, дає можливість досягати максимального ефекту із оптимізацією витрат у плані часу, інтелектуальних та матеріально-технічних ресурсів.

При аналізі результатів найвідоміших міжнародних військових, політичних та економічних конфліктів
ХХІ ст. стає зрозумілим, що інформаційно-психологічна зброя сьогодні має
ючи фізично, психотехнології стають причиною групових,
У форматі використання усього спектру інформаційно-психологічних операцій соціальні онлайн-мережі мають можливість забезпечувати: координацію протестних та терористичних рухів; поширення контенту, що відноситься до категорії інформаційної зброї; збирання важливої інформації про персон або організації, що представляють інтерес для атакуючої сторони; збирання розвідувальної інформації про офлайн-дії противника; відстеження суспільних настроїв; локалізацію джерел інформації, що представляє небезпеку. Однією з головних функцій соціальних онлайн-мереж є можливість координації інформаційних потоків, що розгортаються навколо реальних військових дій. В умовах сучасних, як гібридних,
реалізації цього завдання роботу із соціальними
кращий засіб контролю за інформаційним процесом — координування інформаційних потоків та формування правильних меседжів із відповідним
контентним супроводом. Також ефективним засобом посилення власних можливостей щодо
координації інформаційних потоків може стати залучення до активної співпраці волонтерів / волонтерок . Волонтерський рух в середовищі
онлайн-мереж як інструмент протидії інформаційній агресії або для здійс-
нення аналогічних атак на інформаційне поле супротивника став одним із засобів протидії російській агресії проти України.

Серед українських волонтерських проєктів, які діють як допоміжні віртуальні ресурси в інформаційно-психологічній війні з російськими агресорами та сепаратистськими рухами, можна назвати такі: Inform Napalm та «Інформаційний спротив», центр «Миротворець». Ці мережеві проекти демонструють яскравий приклад того, як за допомогою належним чином розбудованої інформаційної мережі та системи роботи можна ефективно забезпечувати та результативно супроводжувати офлайн-процеси. Практично всі згадані вище
OSINT (Open Source Intelligence)
передбачає пошук, вибір та збирання інформації, отриманої з відкритих джерел. Важливою складовою такої роботи є системний аналіз наявної інформації з відповідною оцінкою та висновками, що дозволяють зрозуміти логіку та передбачити дії противника. Одним із базових золотих правил такої практики є те, що близько 90% необхідної для аналізу та прийняття відповідних рішень інформації перебуває у відкритих джерелах. До таких джерел відносять: традиційні ЗМІ (газети, журнали, радіо, телебачення); інтернет-видання, що відносяться до ЗМІ (новинні сайти та портали, інтернет-ресурси профільних структур); акаунти та віртуальні майданчики у соціальних онлайн-мережах; офіційні звіти державних структур; публічні заяви політиків та держс-лужбовців; спостереження — радіомоніторинг, використання загальнодоступних даних, аерофотозйомок (наприклад, Google Earth); професійні та академічні звіти, конференції, доповіді, статті; звіти та виступи в
окремих незалежних
рішення, залежить, наскільки якісно ці інструменти можуть працювати. Правила поводження в умовах інформаційної блокади Понад 8 років війна, що точилася в нашій державі, була локалізована лише двома областями нашої Батьківщини. Та 24 лютого 2022 року все змінилося. Вся Україна стала ареною бойових дій. Тому військовим, бійцям тероборони, волонтерам / волонтеркам, працівникам критичної інфраструктури та звичайним цивільним людям потрібно знати, що робити під час війни, аби захистити себе у інформаційному просторі.
1. Військові та бійці тероборони: ніколи нікому не казати, де саме знаходитеся. Це інформація тільки для побратимів та командування; тримати смартфони в режимі «В Літаку». Засоби радіоелектронної розвідки ворога можуть засікти телефон, та й не забувати — у багатьох телефонах є автоматична підтримка навігаційної системи Глонасс (російський аналог GPS), у тому числі айфонах та багатьох смартфонах; не фотографувати місцевість, де знаходиться та не надсилати фото друзям. Так само неприпустимо фотографувати будь-які військові документи та карти; двофакторна автентифікація має бути увімкнута скрізь, в усіх сервісах; оновити паролі та зробити їх безпечними — мінімум 8 символів, літери великого та малого регістру, цифри та спецсимволи; не повторювати паролі у різних сервісах;
не відповідати на дзвінки з незнайомих номерів; також для дзвінків найкраще користуватися захищеними месенджерами, такими як Signal. Дзвінки по мобільній мережі перехопити набагато простіше;
видалити по-максимуму усі додатки зі смартфону, які регулярно не використовуються. Найліпше йти на бойову позицію з кнопковим телефоном, а не зі смартфоном.
2. Волонтери / волонтерки. Правила для волонтерів / волонтерок у цілому відрізняються від військових не сильно, але є декілька важливих моментів: якщо волонтер / волонтерка допомагає військовим на лінії фронту
засоби інформування
новажених органів; двофакторна автентифікація має бути увімкнута скрізь, в усіх сервісах; оновити паролі та зробити їх безпечними — мінімум 8 символів, літери великого та малого регістру, цифри та спецсимволи; не повторювати паролі у різних сервісах; не відповідати на дзвінки з незнайомих номерів; також для дзвінків найкраще користуватися захищеними месенджерами, такими як Signal. Дзвінки по мобільній мережі перехопити набагато простіше.
3. Працівники об‘єктів критичної інфраструктури: нікому не розповідати про свою роботу. Який стан у енергетиці, медицині та таке інше. Це також фронт війни й не треба навіть гіпотетично давати розвідці супротивника додаткової інформації; не під’єднувати будь-які свої девайси до мережі установи. Навіть смартфон не варто заряджати від свого робочого комп‘ютера. Чим менше контактів внутрішньої мережі з зовнішнім світом — тим менше шансів на успішну кібератаку зі сторони ворога; сходити до відповідального за інформаційну безпеку в установі, та попросити його ознайомити з
або смартфон приходять повідомлення з невідомих адрес на пошту чи в месенджери — одразу звернутися до відповідального за інформаційну безпеку; ні в якому випадку не завантажувати
та
відкривати підозрілі файли, що прийшли.
4. Цивільне населення: двофакторна автентифікація має бути увімкнута скрізь, в усіх сервісах; оновити паролі та зробити їх безпечними — мінімум 8 символів, літери великого та малого регістру, цифри та спецсимволи; не повторювати паролі у різних сервісах; не відповідати на дзвінки з незнайомих номерів; для дзвінків найкраще користуватися захищеними
якщо
свій телефон від світлин, переписок та підписок у соцмережах. Пам’ятайте: це — тимчасово; якщо можете — допомагайте одне одному та нашим захисникам
ранений у свідомості
інформації.
онлайн. Однак, коли у 1948 році
людини
сали навіть у науково-фантастичних романах.
ся ГО «Платформа прав людини»
підтримки Counterpart International, свідчать про наявність таких порушень цифрових прав українців :
1) Одним із способів обмеження цифрових
їй непотрібних цифрових послуг, наприклад спаму.
2) Заблокування веб-сайтів в Україні,
чів Інтернету.
3) Поширення користувачами соціальної мережі
теня із результатами голосування.
4) Збір та поширення конфіденційної інформації
ром мобільного зв’язку,
5) Надання

тому уявити своє життя без ґаджетів просто неможливо. Завдяки ним можна навчатися, спілкуватися, робити покупки, грати в ігри, читати книги, слухати музику, дивитися відео, обробляти фото тощо.
Але, на жаль, не кожен може ефективно та безпечно використовувати сучасні цифрові технології в роботі, навчанні, професійному чи особистісному розвитку.
Вміння шукати, аналізувати та споживати інформацію безпечно для свого здоров’я, опановувати ризики цифрового
успіху в ньому у наш час – це необхідність.
Цифровізація
несе
професійному та
розвитку — ось що таке цифрова грамотність.

Цифрова грамотність — це
знань, умінь та навичок, які необхідні для безпечного та ефективного використання цифрових технологій та ресурсів інтернету.
Цифрова грамотність необхідна кожному через
1. «Держава в смартфоні» та комфортне проживання в країні. Означає велику кількість сервісів онлайн. Більше не треба витрачати свій час на стояння в черзі. Онлайн-послуги — це комфорт, зручність, економія часу.
ефективно використовувати всі можливості, які надає держава.
2. Особистий розвиток та вирішення особистих потреб. Завдяки знанням цифрової грамотності дідусі та бабусі отримають можливість частіше спілкуватися з онуками
3.
на ринку праці. Володіючи цифровою грамотністю, у
4.
5.
на свій пристрій.
Міністерство цифрової трансформації запустило національну онлайн-платформу з цифрової грамотності «Дія. Цифрова освіта», яка доступна в мережі Інтернет за QR-кодом.
На онлайн-платформі кожен громадянин може безкоштовно опанувати цифрові навички за новим сучасним форматом — освітні серіали. Наразі, доступний онлайн-курс «Тренінги для тренерів» в мережі Інтернет за QR-кодом.
Безпека онлайн-спілкування Онлайн-спілкування — те, до чого ми звикли, те, що об’єднує людей зі схожими інтересами з різних міст та країн, а в час війни — це можливість підтримувати соціальні зв’язки з близькими, а також будувати нові стосунки з однолітками.



Онлайн-спілкування — це особлива форма комунікації, в процесі якої відбувається взаємодія
з одним в мережі Інтернет, та здійснюється шляхом обміну знаковими, та/або мультимедійними повідомленнями.
Програми обміну миттєвими повідомленнями дозволяють спілкуватися в режимі реального часу, але різниця полягає в тому, що ви маєте вибрати особу, з якою бажаєте спілкуватися. Програма показує, хто з ваших друзів також знаходиться в онлайні, і ви можете запросити одного або декілька друзів для приватного спілкування. Ви також можете обмінюватися файлами (світлинами, аудіо- та відеокліпами), разом грати в ігри, робити голосові або відеоголосові дзвінки.
Технологія обміну миттєвими повідомленнями несе ті самі ризики, що й електронна пошта та чат. Користувач може відкрити вкладений файл або посилання, що містить віруси, шпигунську програму або матеріал, який вам не підходить. Якщо ви знаєте особу у «реальному житті», тоді спілкування з нею є більш безпечним. Спілкування за допомогою обміну миттєвими повідомленнями завжди приватне, і ви можете контролювати з ким розмовляєте та скільки часу хочете присвятити розмові.
Ви можете зробити спілкування більш безпечним, скоригувавши настройки програми обміну миттєвими повідомленнями. Вибір людей для спілкування. Найбезпечнішим є спілкування з людьми, яких ви вже знаєте в реальному житті. Потенційно відправити повідомлення вам може будь-хто.
1. Не діліться геолокацією — ані
військ чи складами зберігання боєприпасів ЗСУ. Усе, що може прочитати в листах ваш знайомий, може побачити й ворог!
2. Не надсилайте в месенджерах чи соцмережах паролі від банківських карток, ґаджетів тощо. Або ж використовуйте спеціальні програми для зашифрованих миттєвих повідомлень.
3. Задля безпеки не надсилайте в месенджери інформацію про рух ворога— ліпше повідомте про це ЗСУ через чатбот «єВорог» @evorog_bot, після чого видаліть листування.
4. Зараз ворог намагається заволодіти даними
лише в кіберпросторі, а й фізично: можуть викрасти смартфон.
надійні паролі, дотримуйтеся цих правил і бережіть себе та близьких. Telegram

та поширення новин під час війни. У Національній
налаштувати цей месенджер так, щоб
активності — Ніхто.
Фотографії профілю
мого профілю — Мої контакти.
Дзвінки → Хто може мені телефонувати — Мої контакти (або Ніхто, якщо хочете).
Дзвінки
Peer-to-peer
3.
4.
порація Meta, якій належать сервіси
Instagram і WhatsApp, заявила про підтримку блокування підроблених
шахрайських акаунтів, а також обмеження поширення дезінформації ». З огляду на проблеми з безпекою особистих даних, цей месенджер не можна було назвати найбезпечнішим і до війни. З іншого боку, тут є наскрізне шифрування та двофакторна аутентифікація. Але, що погано, немає секретних чатів, інформація зберігається на пристроях у відкритому вигляді.
Viber пропонує наскрізне шифрування, секретні чати з можливостями автоматичного видалення повідомлень, заборони або відстеження скриншотів, а також захисту від копіювання та пересилань повідомлень.
На відміну від Telegram , у Viber повне шифрування за замовчуванням увімкнено для всіх чатів, але, як і Telegram, всі резервні копії чатів тут зберігаються у відкритому вигляді.
Крім цього, кілька років тому повідомляли: деякі сервери компанії розміщуються на території Росії. Немає гарантії, що спецслужби цієї країни не мають доступу до
шифровані за замовчуванням. Передбачено, що навіть творці програми не можуть отримати доступ до даних користувача. Мобільна та десктоп-версії доступні для безплатного завантаження. Утім порівняно з переліченими вище месенджерами у Signal менше функцій.
Серед інших месенджерів — Threema, Confide, Wickr, Briar, Zello тощо. Підходять не для всіх пристроїв
Правила дорадчого характеру, які стануть у пригоді під час користування електронною поштою: не нехтуйте загальною безпекою вашого гаджета, ПК.
користуйтеся надійними актуальними програмами антивірусного захисту.
будьте уважними під час перегляду отриманої кореспонденції. Не розпаковуйте

злочинцем. Отже, пам’ятайте про те, що спілкування
може приховувати і суттєву небезпеку для вас. Тому, щоб уберегти себе
неприємностей ви повинні постійно пам’ятати нескладні правила
або новими
якими ви познайомилися саме в Інтернеті, а не в реальному житті.
Спілкуючись в Інтернеті ви, заради своєї безпеки, не повинні ніколи: повідомляти своєму віртуальному
адресу, номер свого
та місцезнаходження своєї школи та інші дані; відправляти комусь свої фото
або звичайною поштою; повідомляти пароль до своєї Інтернет-сторінки. Ваш пароль як ключ від вашої квартири, тому нікому його не віддавайте!; казати, що ви вдома знаходишся одні; обговорювати теми, які вам неприємні або яких ви соромитесь; відповідати на питання, які стосуються вашого особистого жит-

тя; розповідати багато про своїх друзів, знайомих та родину, особливо, видавати їхні таємниці; відправляти поштою або передавати через когось свої особисті
речі співрозмовнику по Інтернету.
Крім того:
при реєстрації у чаті ніколи не заповнюйте поля, де від вас вимагають прізвище, номер мобільного та домашнього телефону, домашню адресу. Якщо ці поля обов’язкові, то краще вигадай для себе прізвище, адресу та номер телефону. Це потрібно для вашої безпеки. Взагалі, для реєстрації на різних сайтах створіть для себе
чі повинно бути таким, де постійно знаходиться багато людей, наприклад, парк розваг, каток.

Запам’ятайте! Не можна розкривати і ділитися в соціальних мережах (та і загалом, зустрічаючи незнайомців) особистими даними: місцем прогулянок; номером телефону; часом коли вдома відсутні батьки; адресою; номерами банківських карток; повним ім’ям та іменами членів своєї родини
римати
технікою (смартфон, планшет, ноутбук) і точкою роздачі Wi-Fi йде сигнал. І для шахраїв перехопити його — задача проста. Тож зловмисники можуть отримати дані, які передають Wi-Fi, через зокрема: пошту, повідомлення в соціальних мережах, файли, паролі та логіни. Щоб у хакерів не було можливості отримати особисту інформацію і здійснювати атаки, варто дотримуватись певних правил безпеки з використання Wi-Fi у громадських місцях:
1. VPN. Приватна віртуальна мережа — це один із найбезпечніших способів збереження конфідейційності даних.
2. Двоетапна аутентифікація. Це захист, який передбачає встановлення додаткового паролю на певні сайти. Таким чином у шахраїв не буде змоги провести операцію під твоїм акаунтом. Наприклад, Google, щоб перевірити чи дійсно саме ти входиш у акаунт,
3.
4.
режні.
Наприклад, не проводьте
коли підключені до бездротової мережі в закладі чи магазині. Це може
небезпечно, адже вводите особисті дані, які хакери можуть
і потім ними скористатись. Створення та використання паролів. Кожен користувач комп’ютера неодмінно використовує безліч паролів у своїй повсякденній роботі. Від їх надійності залежить безпека конфіденційних даних, таких як повідомлення електронної пошти, профілі в соціальних мережах або навіть банківський рахунок. У той час недбале ставлення до вибору паролів може призвести не лише до доступу сторонніх осіб до власних даних, але й до фінансових втрат. При створенні акаунту в соціальних мережах, реєстрації в інтернет-магазинах або додатках у смартфонах, необхідно вказувати пароль — так працює будь-яка система авторизації. Конфіденційність приватних даних не надійно захищена, якщо пароль є нестійким до зламу. Наприклад, такі комбінації, як «123456», «11111», «qwerty», «рassword», «abc123», хакер може зламати за лічені секунди. Довший пароль забезпечує більший рівень безпеки. Надійний пароль має містити не менше 8 символів і складатися
паролю слід додавати цифри та спеціальні символи (@, #, ! та інші)
заміни деяких букв у паролі. Під час заміни букв на символи не допускайте поширених помилок, таких, як заміна «а» на «@» або «і» на «1» чи «!». Рекомендується не використовувати як пароль ім’я, прізвище, номер телефону, дату народження тощо. Крім того, краще утриматися від фраз зі щоденного вжитку: назв книг, відомих цитат, текстів пісень. Не варто зберігати пароль


тільки вам. Таким чином, знаючи алгоритм, ви завжди легко запам’ятаєте та введете свій пароль. Для людей, які не знають цього алгоритму, пароль повинен здаватися випадковим набором символів. Пароль повинен легко вводитися із клавіатури. Врахуйте можливість введення паролю із мобільного телефону.

1. Що таке «інформаційна війна»? Вирішення яких завдань вона передбачає?
2. Які складники має інформаційна війна?
3. Що таке «кібербезпека»?
4. Назвіть виклики для України у сфері кібербезпеки.
5. Які загрози кібербезпеці є в Україні?

6. Чому ССО мають особливе значення для ведення
вих протистоянь у контексті гібридних технологій?
7. Чому інформаційно-психологічну зброю
зброї масового знищення?
8. Чому волонтерський рух має велике значення для протидії інформаційній агресії?
9. Як необхідно поводитися в умовах інформаційної блокади?
10. Чому цифрова грамотність необхідна кожному?

11. Складіть правила безпечного листування в соціальних мережах.
12. Чого ніколи не можна робити, спілкуючись в Інтернеті?
13. Яких правил онлайн-безпеки необхідно дотримуватися в громадських місцях?
14. Які основні характеристики надійного паролю?
15. Придумайте пароль, який би відповідав усім параметрам безпеки.

Коли відзначають День Збройних сил України?
Законодавство України про військову службу Нормативно-правова база з військових питань спрямована на ознайомлення громадян із системою законів, які забезпечують обороноздатність держави. Вони, зокрема, регулюють питання проходження військової служби та мобілізації. Ця нормативно-правова база містить Закони України, Укази Президента України, постанови та розпорядження Кабінету Міністрів України (КМУ), накази МО України, інші нормативні акти.
Передусім це: Закони України: Конституція України, «Про Збройні сили України», «Про оборону України», «Про альтернативну (невійськову) службу», «Про військовий обов’язок і військову службу», «Про мобілізаційну
підготовку та мобілізацію», «Про основи національної безпеки України», «Про основи національного спротиву», «Про порядок направлення підрозділів Збройних сил України до інших держав», «Про правовий режим воєнного стану», «Про правовий режим надзвичайного стану», «Про Раду національної
України», «Про участь України в міжнародних миротворчих
та
Укази Президента України: від 25 березня 2021 року «Про рішення Ради національної безпеки і оборони України від 25 березня 2021 року «Про Стратегію воєнної безпеки України», «Про Положення про Міністерство оборони України та Положення про Генеральний штаб
«Про затвердження військово-адміністративного
Структура і завдання ЗСУ Збройні сили України (ЗСУ) — це військове формування,
ральний штаб Збройних сил
Збройними силами України.
Міністр оборони
Командування об’єднаних сил
Десантноштурмові війська
Сили логістики
Сухопутні війська
Сили спеціальних операцій
Війська зв’язку та кібербезпеки
Повітряні сили
Сили територіальної оборони
Медичні сили
військовоморські сили
Сили підтримки
Органи управління, військові частини, ВВНЗ,
військ (сил), висадки повітряних десантів, прикриття важливих об’єктів держави, угруповань своїх військ від ударів засобів повітряного нападу, ведення повітряної розвідки та повітряного перевезення військ і матеріальних засобів. Військово-Морські сили — призначені для стримування, локалізації і нейтралізації збройного конфлікту, а при необхідності – відсічі збройної
агресії з моря як самостійно, так і у взаємодії з іншими видами Збройних сил України, військовими формуваннями, сприяння Сухопутним військам України на приморському напрямку.
Десантно-штурмові війська — окремий рід військ Збройних сил України, який призначений для вертикального охоплення противника та дій в його тилу.
Сили спеціальних операцій — окремий рід сил, який може залучатися до здійснення заходів правового режиму воєнного і надзвичайного стану, організації та підтримання дій руху опору, проведення військових інформаційно-психологічних операцій, боротьби з тероризмом і піратством, заходів щодо здійснення захисту життя, здоров’я громадян та об’єктів (майна) державної власності за межами України, забезпечення їх безпеки та евакуації (повернення), посилення охорони державного кордону, захисту суверенних прав України в її виключній (морській) економічній зоні і континентального шельфу України та їх правового оформлення, забезпечення безпеки національного морського судноплавства України у відкритому морі чи у будь-якому місці, що знаходиться поза межами юрисдикції будьякої держави, заходів щодо запобігання розповсю-дженню зброї масового ураження, протидії незаконним перевезенням зброї і наркотичних засобів, психотропних речовин, їх аналогів або прекурсорів у відкритому морі, ліквідації надзвичайних ситуацій
надання військової допомоги іншим державам, а також брати участь у міжнародному військовому співробітництві, міжнародних антитерористичних, антипіратських та інших міжнародних операціях з підтримання миру і безпеки, на підставі міжнародних договорів України та в порядку і на умовах, визначених законодавством України. Сили територіальної
під час відмобілізування і стратегічного (оперативного) розгортання, підготовки та ведення операцій (бойових дій), відновлення боєздатності військ (сил), отримання, накопичення, обліку, зберігання, постачання та поповнення запасів матеріальних засобів. Сили підтримки призначені для оперативного забезпечення військ. Зокрема інженерної підтримки, радіоелектронної боротьби (РЕБ), радіаційного, хімічного та біологічного захисту (РХБЗ), топографічного та гідрометеорологічного забезпечення.
Медичні сили призначені для медичного забезпечення Збройних сил України. Медичні підрозділи Сухопутних військ, Повітряних сил, ВМС, ДШВ, ССпО, СТрО, Сил підтримки, Сил логістики, Військ зв’язку та кібербезпеки.
У складі Збройних сил України діє Військова служба правопорядку — спеціальне правоохоронне формування, призначене для забезпечення правопорядку і військової дисципліни серед військовослужбовців Збройних сил України у місцях дислокації військових частин, у військових навчальних закладах, установах та організаціях, військових містечках, на вулицях і в громадських місцях; для запобігання злочинам, іншим правопорушенням у Збройних силах України, їх припинення; для захисту життя, здоров’я, прав і законних інтересів військовослужбовців, військовозобов’язаних
організацію та проведення військово-професійної
молоді та прийому до вищих військових
закладів та


му кандидату на навчання
у виборі військової спеціальності, що найбільш відповідає його здібностям, психологічним та особистісним якостям, які оцінюються в процесі військово-професійного відбору.
Військово-професійна орієнтація молоді включає:
військово-професійне інформування; військово-професійні консультації; військово-професійний добір; військово-професійний відбір.
військово-професійне інформування. Військово-професійне інформування — це система заходів щодо збору (розробки), узагальнення та розповсюдження відомостей про: військову професію, ВВНЗ та ВНП ЗВО, де можна її здобути, зміст і перспективи військової служби; вимоги, що висуваються до особи, яка бажає отримати ту чи іншу військову спеціальність; форми навчання і умови оволодіння різними військовими спеціальностями; можливість професійно-кваліфікаційного росту, реалізації професійних інтересів, намірів та мотивацій особи. Військово-професійне інформування проводиться протягом декількох
етапів:
підготовчого, який починається у сім’ї, дошкільному закладі та продовжується в школі до 4–5 класу (до 11–12 років); шкільного, який охоплює 5–9 класи (до 12–16 років);
завершального, який продовжується в 10–11 класах (до 17–18 років).
На підготовчому етапі основними виконавцями заходів щодо професійної орієнтації та військово-професійної орієнтації є батьки або інші законні представники.
На шкільному етапі основним джерелом інформації є вчителі закладів загальної середньої освіти, представники громадських об’єднань та військово-патріотичних організацій. Територіальні центри комплектування та соціальної підтримки і військові навчальні заклади надають методичну допомогу в проведенні військово-професійного
му господарстві (15-18 років) і вимагає участі
цьому процесі військових фахівців: офіцерів територіальних центрів комплектування та соціальної підтримки, офіцерів ВВНЗ та ВНП ЗВО, офіцерів-вихователів ліцеїв та коледжів, соціологів, психологів відповідного державного (комунального) закладу, вчителів та викладачів предмета «Захист України».
Військово-професійний відбір (система професійно-діагностичного обстеження особи, спрямована на визначення ступеня її придатності до конкретних видів військово-професійної діяльності) та добір (система професійно-діагностичного обстеження особи, яка спрямована на визначення конкретних військових спеціальностей, найбільш придатних для їх оволодіння зазначеною особою) проводяться командирами та фахівцями військових частин, територіальних центрів комплектування та соціальної підтримки, військових навчальних закладів, військових ліцеїв та коледжів під час вивчення моральних та ділових якостей осіб, які виявили бажання навчатися у ВВНЗ (ВНП ЗВО), проведення зборів або підготовчих курсів у закладах загальної середньої освіти, військових ліцеях, коледжах тощо. На цьому етапі проводиться уточнення
відності особистих якостей кожного кандидата вимогам, які висуває військова служба до особи, визначається придатність кандидата
у ВВНЗ (ВНП ЗВО) та
реднього
бовців військової служби за контрактом
та закладів Збройних сил України, з числа ліцеїстів
начальників ліцеїв, з числа цивільної молоді - на начальників територіальних центрів комплектування
інформаційне
військово-професійної орієнтації відповідають начальники (керівники) ВВНЗ та ВНП ЗВО, які здійснюють роботу з відбору та
та сержантського складу; вищі військові навчальні заклади та військові навчальні підрозділи закладів вищої освіти, що здійснюють підготовку студентів за програмами підготовки офіцерів запасу;
військові коледжі сержантського складу;
військові коледжі з посиленою військовою та фізичною підготовкою;
військову та хорунжу школи;
військові ліцеї.

Військові навчальні заклади України — система підготовки військових фахів, що створена в Україні, є складником державної системи освіти. Освітню діяльність провадять 2 університети, 4 академії, 6 військових інститутів, 3 військові коледжі сержантського складу, 1 відділення військової підготовки, 32 кафедри військової підготовки, 10 кафедр медицини катастроф та військової медицини, 3 військові ліцеї. Курсанти / курсантки та слухачі / слухачки здобувають вищу освіту у 25-й галузі знань «Воєнні науки, національна безпека, безпека державного кордону», а також у двадцять
сукупно за 40-ка ліцензованими спеціальностями та 148-ми спеціалізаціями. ВВНЗ та ВНП ЗВО здійснюють підготовку за державним замовленням, забезпечуючи
тактичного, оперативного та стратегічного рівнів.
онує в межах трьох вертикалей,
кваліфікації є важливим чинником формування міцного підґрунтя набуття взаємосумісності
силами держав-членів НАТО та структурами Альянсу, професіоналізації сил оборони та трансформації системи кадрового менеджменту. В основу формування структури та

ських стандартів та євроатлантичних
освіти.
Протягом навчання
та навчатися у провідних військових навчальних закладах НАТО та держав – членів Організації Північноатлантичного договору.
Після завершення навчання кожен випускник, отримавши офіцерське (сержантське) військове звання, гарантовано працевлаштовується – призначається на посаду для проходження військової служби за контрактом.
До освітнього процесу у ВВНЗ, ВНП ЗВО, ЗФПВО та військових
активно залучається офіцерський склад з бойовим досвідом. Переважна більшість викладацького складу є
У системі підвищення кваліфікації функціонує близько 500
військовослужбовців, працівників
державних службовців Міноборони та ЗС України з метою отримання необхідних знань, умінь та практичних навичок для виконання обов’язків за посадою з терміном навчання від 2 тижнів до 6
Детальну інформацію щодо найменування навчальних закладів, переліку спеціальностей та
для вступу можна переглянути у Довіднику вступнику до вищих
військових навчальних закладів та
підрозділів закладів вищої освіти .

1. Які нормативні акти складають нормативно-правову
ськових питань України?


2. Охарактеризуйте організаційну структуру Збройний сил України.
3. Що таке «військово-професійна орієнтація
4. Які типи закладів
5. Чому Сухопутні війська є


Прапори були однакової форми
жаку. Відрізняли їх за забарвленням, зображеннями (зорі, місяць),
Коли прапор піднімали над військом — це був
волосся).
до початку бою. Навколо прапора йшла завзята боротьба,
перемога.
що
не перемогли. Трубами та бубнами подавали сигнал до бою, до походу.
Відзнаки козацького війська називали клейнодами . За клейноди війська вважали гетьманську булаву й бунчук, печать, хоругви ( іл. 7.1. ), бубни і труби, деколи й козацьку гармату.
Клейноди (від нім. Kleinod, польськ. klejnot — коштовність) — регалії в Запорозькому козацькому війську (прапори, бунчуки, труби, литаври, барабани) і символи

булаву, бунчук, хоругву, печать. Несли з великою пошаною «на подушках, тафтою червоною укритих». Нижча старшина також мала відзнаки: полковник — пірнач, хоругву і значок, сотник — хоругву.
Розрізняли три види хоругв: усього війська або гетьманська; полкові; сотенні.
У козацькому війську довго не було одного типу козацьких хоругов, а панувала повна довільність і щодо барв прапорів, і щодо знаків, що на них були. Бувало, козацьке військо використовувало прапори тих держав, що брали його на службу.
Свою печать із написом «Печать Славного Войска Запорозького Низового» мав кожний полк, а деколи й сотня. Різні запорозькі паланки мали свої печаті, з різними знаками (олені, леви, птахи, шаблі, списи, стріли). Мали свої військові символи й Січові стрільці: прапори, відзнаки роду військ, номери частин, військових посад тощо.
У березні 1918 р. Мала Рада УНР затвердила герб УНР — знак Київської держави часів Володимира (тризуб, оточений вінком із листя), великий та малий герби, печатки. Тоді ж затвердили
із зображенням тризуба. Зміст Військової присяги.

клятву народові України. Текст Військової присяги Я, (прізвище, ім’я, по батькові), вступаю на військову службу і урочисто присягаю Українському народові завжди бути йому вірним і відданим, обороняти Україну, захищати її суверенітет, територіальну цілісність і недоторканність, сумлінно і чесно виконувати військовий обов’язок, накази командирів, неухильно дотримуватися Конституції України та законів України, зберігати державну
сумлінно виконувати обов’язки військової служби. Бойовий прапор військової частини ЗСУ Кожна військова частина під час формування отримує Бойовий Прапор. Бойовий Прапор військової частини в Збройних Силах України, як і в багатьох інших країнах світу, є символом честі, доблесті, бойової слави і продовження бойових традицій. За визначенням типу прапора — бойовий прапор.

Бойовий Прапор військової частини Збройних Сил України є символом: честі, доблесті, слави і зобов’язує кожного військовослужбовця Збройних Сил України віддано служити Українському народові, мужньо, вміло і непохитно боронити Українську державу, не шкодуючи свого життя.
Бойовий Прапор військової частини є почесним знаком, що визначає особливості її бойового призначення, історії та заслуг і свідчить про належність військової частини до Збройних Сил України.
Бойовий Прапор після сформування
частини вручається їй від імені Президента України представником, призначеним Міністром оборони України.
Бойовий Прапор закріплюється за військовою частиною на весь час незалежно від
найменування військової частини вносяться до Грамоти Президента України, що видається під час вручення Бойового Прапора. Бойовий Прапор завжди знаходиться
вослужбовці, що є безпосередніми винуватцями цього, несуть
ність згідно із за-коном. Для охорони Бойового Прапора у військовій частині виставляють пост № 1 — найвідповідальніший і найважливіший, який довірено найкращим воїнам. Під Бойовим прапором військовослужбовці приймають присягу, беруть участь у парадах, походах, маневрах.
Бойовий Прапор військової частини (з’єднання) Збройних сил України (далі — Бойовий Прапор);— квадратне полотнище малинового кольору розміром 130 130 см із

На зворотній стороні Бойового Прапора у центрі міститься напис назви військової частини (з’єднання), якій вручається Бойовий Прапор.
Полотнище зворотної сторони Бойового Прапора прикрашено по периметру лиштвою з орнаментом у вигляді зображення листя і кетягів калини. У кутах розміщено емблему роду військ, до якого належить військова частина (з’єднання).
Усі зображення та написи на полотнищі Бойового Прапора виконані золотим шитвом.
Вільні сторони Бойового Прапора прикрашено золотою бахромою.
Висота емблеми Збройних сил України становить 5/7 висоти полотнища, ширина лиштви разом із кантом — 1/10 ширини полотнища.
Ратище Бойового Прапора дерев’яне, коричневого кольору. Верхівка ратища стрілоподібна з жовтого металу, в ній вміщено рельєфне
ження емблеми Збройних Сил
ним орнаментом та зображенням медальйону — підвіски із Знаком Президента України.
Стрічка зав’язується бантом
30 см з двома горизонтальними променями та скріплюється розеткою діаметром 10 см.
Стрічка є невід’ємною частиною Бойового Прапора.
Порядок вручення Бойового прапора, його
визначається
та
внутрішньої служби « Положення про порядок вручення бойових
Збройних Сил України, Сухопутних військ Збройних Сил України, Повітряних Сил Збройних Сил України, Десантно-штурмових військ Збройних Сил України ( іл. 7.3 ), Сил спеціальних операцій Збройних Сил України ( іл. 7.4 ), емблему Військово-Морських Сил Збройних Сил України і Військово-Морський Прапор Збройних Сил України, штандарти Міністра оборони України, начальника Генерального штабу Збройних Сил України, командувачів Сухопутних військ
Збройних Сил України, Повітряних Сил Зброй-
них Сил України, Військово-Морських Сил
Збройних Сил України, Десантно-штурмових
військ Збройних Сил України, Сил спеціальних
операцій Збройних Сил України ( іл. 7.5 ), емблему Головного управління розвідки Міністерства
оборони України.

Іл. 7,3. Прапор Десантно-штурмових військ Збройних сил України

Іл. 7.4. Емблема Сил спеціальних операцій Збройних сил

Іл. 7.5. Штандарти Міністра оборони України, начальника Генерального штабу Збройних сил України, командувачів Сухопутних військ Збройних сил України, Повітряних сил Збройних сил України, Військово-Морських сил Збройних сил України, Десантно-штурмових військ Збройних сил України, Сил спеціальних операцій Збройних сил України



1. Охарактеризуйте історичні витоки Військової присяги, Бойового Прапора, військових відзнак та символіки України.
2. Поясніть зміст, значення та порядок складання Військової присяги на вірність українському народові.
3. Вивчіть напам’ять текст присяги.
4. Наведіть історичні приклади, у яких би йшлося про Бойовий прапор, Військову присягу, військові відзнаки.
5. Розгляньте зображення всіх прапорів
6.

1. Слов’янське військо (ІІІ–ІХ ст. н.е.).
2. Українське військо періоду княжої
(Х–ХІV ст.).
3. Українське військо періоду козацтва (ХV–ХVІІІ ст.).
4. Українські військові формування під час Першої світової війни (1914–1918 рр.).
5. Збройні сили Української Народної Республіки (1917–1922 рр.).
6. Збройні сили Другої світової війни (1939–1945 рр.).
7. Збройні сили незалежної України до 1914 р.
8. Нова українська армія — від 2014 р. Слов’янське
на віче. Певного бойового порядку давні слов’яни
застосовували засідки, обходи, захоплення та інші військові хитрощі.
Військо мало вдосконалене
підрозділами, «лавою» ( сх. 8.1 ).
8.1
держави військо складалося
ополчення . Дружина будувалась за зразком варягів, але до неї входили вищі верства громадянства та бояри, які усвідомлювали потребу в захисті своєї Батьківщини. Дружина князя складалася з полків (по 100–200 осіб), їх називали за іменем князя і, рідше, — земель. Народне ополчення спочатку не мало постійної військової організації, а збиралося для самооборони. Його організовували й поділяли на тисячі за назвами міст. Княжа дружина поділялася на старшу і молодшу . Старша дружина складалася з представників феодальної аристократії й була найближена до князя, брала участь в обговоренні державних та господарських справ (боярська рада), очолювала молодшу дружину та воїв. Молодша дружина , або гридь , була ядром збройних сил і складалася з професійних воїнів, охороняла князя, його двір і майно, виконувала адміністративно-судові доручення. Молодша дружина становила постійне населення сторожових градів-фортець, збудованих на кордонах Русі. Тут вона несла військову службу, а у вільний час обробляла землю та виконувала різні господарські роботи для своїх потреб. Зброя в ті часи була двох видів: охоронна (захисна) і зачіпна (наступальна). Захисну зброю (броня — кольчуга, шолом і щит) використовували для захисту тіла в бою. Наступальну (спис, меч, шабля, сокира та лук зі стрілами) — для враження супротивника. За княжої доби були два роди війська: оружники й стрільці . Оружники мали панцир, шолом, щит, меч, спис, сокиру. Стрільці — лук і стріли. До
кінця XI ст. українське військо було пішим. Кіннота, за своїм озброєнням поділялася на важку (воїни в панцирах, шоломах, зі списами і щитами) та
легку (стрільці з луками).
У княжу добу розвивався й український військовий флот. Воєнні човни називалися лодіями . Річкові та морські лодії мали різні розміри і вміщували 40–100 воїв.
Збиралося військо за наказом князя. Спеціальні військові тренування, маневри у війську не проводили. Дорослі вдосконалювали свою майстерність у бою. Підлітки мали
уміти боротися, кидати спис, стріляти з лука, володіти мечем, шаблею, їздити верхи. Після такої підготовки їх брали у бойові походи. Київські князі Аскольд, Олег, Ігор,
ців),
були ненадійні союзники, які часто грабували княжі землі. Отож галицький князь Данило Романович провів реформу, під час якої створив незалежне від боярської дружини
стих людей» і безземельного боярства. Військо складалося з важкоозброєних « оружників » і легкоозброєних « стрільців ». Оружники, у кольчугах і шоломах, зі списами, мечами та щитами воювали на конях або пішки. Стрільці були озброєні луками й захищали
бій, вражаючи ворога стрілами. Українське військо періоду
, яка утворилася в XVI ст., була військово-політичним об’єднанням з єдиним центром, власними законами, виборчою системою, козацькою радою. Розташована на річкових островах, Січ була укріпленням, оточеним глибоким ровом і десятиметровим валом
частоколом, кількома високими вежами з бійницями для гармат. Козаки гарнізону Січі
вальні роз’їзди. Для спостереження використовували підвищені
вогняно-димові споруди, які називали « маяками », « фігурами ». Коли помічали ворога,
ги й захисту, а також легких рухливих фальконетів (легких гармат). Деякі з них мали вертлюги, які прикріплювали до бортів човна або судна.
Козаки були озброєні шаблями й списами, а також вогнепальною зброєю — мушкетами, пістолями, самопалами, рушницями ( іл. 8.1 ).
Запорожців називали « рушничним військом ». Крім того, у козаків були також келепи (бойові молоти), якірці та рогульки — їх застосовува-
ли проти ворожої кінноти. У XVI ст. та в першій

половині XVII ст. козацтво ще використовувало луки. Цей, на перший погляд, анахронізм мав практичне значення. Адже лук стріляв швидше Іл. 8.1. Козаки в атаці
за рушницю, тож один лучник міг доволі ефективно прикрити десяток козацьких стрільців під час заряджання зброї. Окрім зброї та належної амуніції, кожен вояк мав сокиру, косу, лопату, шнури тощо, щоб насипати вали й будувати укріплення, а також зв’язувати вози в табір. На кожні 5–10 козаків був один віз, що перевозив зброю, боєприпаси, продукти, фураж для коней, лопати, сокири, пилки тощо. На возах перевозили і гармати.
Найпоширенішим видом бойового порядку в козаків став так званий табір з возів — найважливіший елемент
тактики в умовах рівнинної степової місцевості, який застосовувався для просування військ,
вози. Між рядами
не замикались, їх прикривала кіннота. Для замкнення цих сторін прямокутник мав «крила», тобто один ряд возів був довший за інші, що дозволяло перекрити табір спереду і ззаду. Для тривалої оборони табору колеса возів зв’язували ланцюгами, закопували в землю, насипали її на вози. Навколо
возів робили бруствери, окопи, з’єднані ходами. Розміри табору залежали
від кількості війська. Похідний порядок козацького війська будували за правилами військового мистецтва. Попереду (на відстані до 6 км) йшли козаки-розвідники. За розвідувальними загонами на відстані
екіпажі, кожен з яких будував човен — « чайку » для екіпажу з 50–70
мат. У похід вирушало близько 60–100 «чайок», на яких було в середньому по 100 гармат на тисячу козаків.
Поступово змінювалися масштаби й умови битв. Якщо в XV–XVI ст. козаки билися з турками в дніпровських плавнях, то вже в XVII ст. доводилося воювати у відкритому морі. У плавнях козаки нападали із засідки, ховаючись в очереті, у морі — намагалися наблизитися до ворога непомітно вночі або проти сонця. Якщо такої можливості не було, атакували подібно до кінної лави. Частина вояків веслувала, а частина стріляла. Наблизившись до
ли для походів, а потім знищували.

Іл. 8.2. Козацький човен Уміло використовували запорожці й якості своїх човнів
вецького були настільки ефективними, що за його ліквідацію взявся сам султан Османської імперії. Гетьман Богдан Хмельницький очолив
стання, метою якого була
успішне


3.
4.

5.
зацької) доби були переможними; б) складіть
(кожна група — на вибір). Використайте додаткову інформацію з Інтернету, історичних документів тощо.

ви вважаєте, чи
р.
стояння Антанти (Англія, Франція, Росія) та Троїстого союзу (Німеччина, Австро-Угорщина, Італія). У планах супротивників чільне місце належало завоюванню українських земель, які були театром жорстоких боїв. Українці змушені були воювати на боці російської (3,5 млн) та австрійської (250 тис.) армій за чужі інтереси і вести братовбивчу війну. У 1914 р. на добровільних засадах був сформований легіон Українських січових стрільців (УСС) ( іл. 9.1 ). Він складався з піхотного полку (2–3 курені). Кожен курінь (батальйон) мав 4 піхотні сотні (роти). Сотні складалися з 4-х чот (взводів), чоти — з 4–х роїв (відділень) по 10–15 осіб.
Легіон УСС здебільшого складався з вихованців воєнізованих організацій: спортивно-громадської (« Сокіл »), пожежної (« Січ »), учнівсько-

Іл. 9.1. Січові стрільці
шкільної (« Пласт »). До міста Стрий (Львівщина), де формувався легіон, прибуло понад 10 000 добровольців. Проте дозвіл надали лише 2500 особам, адже австрійське командування хотіло, щоб українці служили в імперській армії, де б вони «розчинилися» в масі солдатів інших національностей. Військову присягу усуси


— старовинної столиці Галичини, піднявши тут на знак
де новосформований полк УСС, потрапивши в оточення, був практично

(УГА), основу якої склали формування Українських Січових
Революційна повстанська армія
ра Махна зуміла нав’язати збройну
відразу кільком титанам — білогвардійцям, військам Директорії, німецько-австрійським формуванням, а також більшовикам. З останніми Махно укладав епізодичні союзи, проте щораз опинявся їхньою жертвою — аж до розгрому його сил Червоною армією, після чого він залишив Батьківщину. У 1918 р. Центральна Рада проголошує створення військового флоту УНР ( іл. 9.4 ). ВМФ України складався з лінійних кораблів, серед яких були кораблі-велетні — дредноути — «Цариця Катерина Іл. 9.1. Січові стрільці

Велика» та «Воля», крейсерів, гідрокрейсерів, міноносців, підводних човнів і сторожових катерів і морської піхоти. У 1920 р. армія УНР після тяжких боїв з Червоною армією перейшла р. Збруч і була інтернована польською владою. 1924 р. вона припинила існування як організована збройна сила. Інтерновані вояки перейшли на становище політичних емігрантів. Згодом вони ввійшли до складу українських національно-патріотичних організацій. Військова техніка, що використовувалась в українсько-більшовицькій війні, була «спадком» від російської армії. На жаль, в умовах зруйнованого війною господарства виробництво «української» зброї і військової техніки майже припинилося. Тому використовували все, що мало бодай якусь цінність.
та німецької армій. Завдяки технічним частинам
війни Коли 17.09.1939 р. радянські війська перейшли польсько-радянський кордон, для українського народу розпочалася Друга світова війна. Західна Україна відповідно до радянсько-німецького пакту про ненапад від 23.08.1939 р. і, зокрема, «Таємничого додаткового протоколу» перейшла під контроль СРСР. Після нападу 22.06.1941 р. Німеччини на СРСР Україна перетворилася на важливий театр воєнних
ськами. На території
кількістю
мілітаристської Японії.
Військовий подвиг багатьох українців відзначений
жавними нагородами СРСР. Серед них 2072 особи удостоєні
Радянського Союзу, із них 32 особи — двічі, а льотчик-винищувач Іван Кожедуб здобув це звання тричі. Із 7 млн орденів і медалей, вручених солдатам і офіцерам, 2,5 млн здобули жителі України. Після проголошення в 1991 р. незалежності Україна мала майже 800-тисячну армію, понад 6100 танків, 8000 бойових машин, 1100 літаків, за кількістю та якістю яких українська армія поступалась лише американській, російській та китайській. В Україні дислокувалися ракетна армія, 3 загальновійськові та 2 танкові армії, армійський корпус, 4 повітряні армії, окрема армія Протиповітряної оборони, Чорноморський флот. Хто ж тоді міг уявити, що у 2014 р. нам доведеться захищатися, розраховуючи лише на 6000 солдат та офіцерів.
24 серпня 1991 р. Верховна Рада України прийняла постанову
військові формування в Україні », якою визначила: «Підпорядкувати всі військові формування, дислоковані
України; утворити Міністерство оборони
приступити до створення Збройних сил України». Фактично цією
сил України як важливого інституту держави і невід’ємного
історію
(1997–2000);
збройних формувань
районах Донецької та Луганської областей, які призвели до припинення діяльності місцевих органів влади, керівництво держави прийняло рішення щодо проведення на цих територіях антитерористичної операції та виконання завдань територіальної оборони. Для безпосереднього управління силами і засобами, які залучалися до участі у проведенні антитерористичної операції, був створений оперативний штаб на чолі з керівником Антитерористичного центру при Службі безпеки України. На початок проведення антитерористичної операції на сході України підрозділи Збройних сил не мали достатньої кількості озброєння і техніки, особовий склад був слабо підготовлений. Наявне модернізоване та нове озброєння, що отримували підрозділи Збройних сил в одиничних екземплярах, не впливало на боєздатність частин і підрозділів. Завдання по захисту України виконувалися завдяки самопожертві та героїзму воїнів. У перший період АТО велику допомогу підрозділам Збройних сил надали добровольчі батальйони . Одночасно із збільшенням угруповання
районах Донецької та Луганської областей здійснювався перехід системи
ально-технічного забезпечення Збройних сил,
за територіальним принципом, на функціонування
антитерористичної операції. На етапі розгортання системи матеріально-технічного забезпечення вирішення
державної політики. Тому було відмінено позаблоковий
оборони, які згодом були переформовані в окремі мотопіхотні батальйони. Загалом, 2014 рік став для Збройних сил України перевіркою на мужність, витривалість, вірність Військовій присязі та відданість державі, увійшов в історію як рік відродження української армії. За результатами комплексного огляду сектору безпеки

2020 року.
Затверджено військово-адміністративний
ративний штаб. Доведено до логічного завершення створення
ловним завданням Міністерства
реформування Збройних сил для створення боєздатних, добре оснащених, підготовлених до виконання завдань за призначенням військ (сил).
Протягом 2015 року Збройні сили України відновили
набули бойового досвіду,
спроможності, необхідного рівня технічної оснащеності та матеріальної забезпеченості для захисту суверенітету і територіальної цілісності держави, завдяки чому
силах сформовано 15 бойових
5 батальйонів (дивізіонів), а також бригаду, 6 полків та 11 батальйонів оперативного (бойового), тилового і технічного забезпечення. Збільшено авіаційний парк та бойовий склад зенітних ракетних військ, сформовано підрозділи для охорони аеродромів і стартових позицій зенітних ракетних військ. Відновлено діяльність 138 районних та міських військових комісаріатів, завдяки чому проведено шість черг часткової мобілізації та призвано понад 200 тис. військовозобов’язаних.
Навесні 2016 року відновлено призов на строкову службу в Україні. Усього до Збройних сил було призвано 19 тис. осіб, що дало змогу не допустити зниження укомплектованості до критичного рівня та замінити військовослужбовців, переміщених до частин, задіяних у антитерористичній операції.
У вересні 2018 р. Верховна Рада зрівняла жінок і чоловіків у правах для прохо-дження військової служби. Це відкрило шлях у професію тисячам українок, які прагнули служити своєму народу зі зброєю у руках. Одночасно розгорнулася масштабна робота зі знищення будь-якого нагадування про реальне минуле: було введено нову форму одягу й військове вітання, яке використовували в армії УНР і в ОУН в 40-ві роки минулого століття, виведено на новий рівень ідеологічну роботу. Величезна маса людей отримала бойовий досвід. Змінилася й загальна структура — до трьох видів Збройних
війська. Сформовано майже
чення. Після
ЗСУ збільшилася до
року включно.Чисельність
майже втричі.

1. Опишіть військову діяльність українського народу під
2. Яке значення мала діяльність

3.
4.
ТЕМА 3.
§ 10.


Міжнародне гуманітарне право (МГП), або право збройних конфліктів — це система


Необхідність регулювання воєнних дій
зумовлена статистикою Міжнародного Комітету Червоного Хреста (МКЧХ),
понад 14 000 війн. У них загинуло приблизно 5 млрд людей,
тривалішими. Так, з 2011 р. вони уже відбулися або тривають у таких країнах: громадянська війна в Лівії (2011), громадянська війна в Сирії (з 2011), конфлікти у Північному Малі (2012–2013), Судані (з 2012), Лівії, Ємені,
(з 2015), Колумбії (1964–2016), ізраїльсько-палестинський конфлікт тощо.
необхідності обмеження насилля воюючих сторін шляхом узгодженої розробки й укладення договорів, які регулюють відносини між державами під час збройних конфліктів. Це зумовило створення системи міжнародного гуманітарного права («право збройних конфліктів», «право війни»).

МГП діє під час усіх збройних конфліктів в будь-якому регіоні земної кулі — як міжнародних, так і неміжнародних. Норми МГП вступають у дію з початком збройного конфлікту або операції з підтримання
застосування
ють із загальним закінченням
закінченням окупації.
тих, які припинили
до складу збройних сил воюючих сторін та безпосередньо ведуть бойові дії проти ворога зі зброєю в руках, дотримуючи у своїх діях законів та звичаїв війни ( іл. 10.2 ). Згідно з Женевськими конвенціями (1949) та Додаткового протоколу до Женевських конвенцій 1949 р. (8.06.1977 р.) про захист жертв війни, статус
комбатанта мають: а) особовий склад регулярних ЗС; б) поліцейські сили; ополчення, добровольчі

Іл. 10.2. Уніфікована військова форма одягу військовослужбовців (комбатантів) ЗСУ й інших військових формувань
загони; в) бійці національно-визвольних рухів опору та партизани; г) особи, що допомагають ЗС, але не беруть участі в бойових діях; ´ ) члени екіпажів торгових суден і цивільних літаків, що надають допомогу ЗС; д) населення, яке за наближення супротивника взялося до зброї, за умови, що воно відкрито її носить і дотримує законів та звичаїв війни. За комбатантами визнають право застосовувати військове насильство, відповідно й до них застосовують вищу форму військового насильства — фізичне знищення. Потрапивши в полон, комбатанти набувають статусу військовополонених. Некомбатанти — це інтендантський, медичний, юридичний
ний персонал, який
сторони і допомагає в досягненні
не за матеріальну вигоду!) можуть бути зарахованими до особового складу збройних сил однієї з воюючих сторін. До учасників бойових дій належать: а) особи, що захищали незалежність, суверенітет та територіальну цілісність України і брали безпосередню участь в операції об’єднаних сил (ООС), забезпеченні її проведення й перебували в районах проведення такої операції; б) осіб військового та цивільного персоналу підрозділів ЗСУ, інших військових формувань, правоохоронних органів, що брали участь у міжнародній миротворчій операції або в розмінуванні місцевості від інженерних боєприпасів і вибухових пристроїв на території нашої та інших держав.

Наказом Міністра оборони України від 23.03.2017 № 164 затверджена Інструкція про порядок виконання норм МГП у Збройних силах України.
Відповідно до Інструкції, норми МГП застосовують як у міжнародних, так і у внутрішніх збройних конфліктах. Крім цього, норми МГП застосовують і в разі порушень
внутрішнього порядку, які не розглядають як збройний конфлікт. Інструкція у поєднанні зі Статутом
Військовослужбовці ЗСУ мають дотримувати принципів і норм МГП та міжнародних договорів
ципів МГП: законності, обмеження, розрізнення, сумірності, гуманності та військової необхідності.
Кожен військовослужбовець має знати і дотримувати норм МГП: виконуючи завдання, застосовувати зброю лише проти супротивника та
його об’єктів;
не нападати на осіб і об’єкти, які захищає МГП, якщо особи не чинять ворожих дій, а об’єкти не використовують у воєнних цілях; не заподіювати зайвих страждань, не завдавати більшого збитку, ніж необхідно для виконання бойового завдання; якщо обстановка сприяє, забирати поранених, хворих

ядерної, біологічної, хімічної та лазерної зброї; мін тощо.
щодо методів — це наказ нікого не залишати живим і
цим супротивнику, військові хитрощі, віроломство, неналежне використання розпізнавальних емблем, зазначених у Женевських конвенціях тощо. МГП обмежує законні засоби і методи ведення війни. Цей принцип підтверджений у Додатковому протоколі. Засоби ведення війни
це зброя й інші засоби, які використовують збройні сили у війні для перемоги над супротивником. Методи ведення війни — це способи застосування засобів війни. МГП цілком забороняє такі засоби ведення війни: розривні й запальні кулі, а також кулі, які
ються в тілі людини (кулі з твердою оболонкою, яка не повністю покриває осердя або має надрізи); снаряди масою до 400 г, розривні, або з вибуховою (запалювальною) речовиною; хімічна зброя — отруйні, задушливі та інші гази, рідини й процеси
10.3 );
бактеріологічна (біологічна)
лазерна зброя, спеціально


зброя

нітарного права.

Застосування російськими
пасів і запалювальних
види звичайної зброї. Фосфорні боєприпаси — це снаряди начинені самозапальним білим
(від 800°C). 24 березня 2022 року повідомлялося, що російські війська скинули кілька фосфорних бомб в Луганській області. Є підозри про застосування проти захисників Маріуполя та Ізюму хімічної зброї, що є грубим порушенням правил ведення війни, зокрема Конвенції про хімічну зброю. Росія, попри свої публічні обіцянки, так і не ліквідувала свої запаси хімічної зброї, більш того — продовжує синтезувати нові бойові речовини. Використання Росією касетних, термобаричних «вакуумних» бомб, протипіхотних мін в українських містах є порушенням Гаазьких конвенцій і звичаєвого міжнародного гуманітарного права. Заборонено або обмежено застосування запалювальних засобів проти цивільного населення й об’єктів, а також для знищення лісів та іншого рослинного покриву ( іл. 10.5 ). Заборонено за будь-яких обставин використовувати міни, міни-пастки, якщо наслідками можуть бути поранення або загибель цивільних осіб. Міна-пастка — пристрої або матеріали, які відрізняються від протипіхотних мін. Вони призначені, сконструйовані чи пристосовані для того, щоб вбивати або заподіювати ушкодження людині зненацька, коли вона торкається або наближається до безпечного зовні предмета, який містить вибухову речовину.

Для збереження життя в умовах терористичної загрози не можна ніколи й нічого цінного підіймати землі, це може бути замінованою
пасткою (зброя, гроші, апаратура, а також трупи товаришів). Не треба бути занадто цікавим і жадним, наївно вважати, що ця знахідка є везінням. Усе цінне вже вкрадено раніше.
Терористи, які відступали з населених пунктів Донбасу, залишали
за собою чимало мін-пасток у вигляді звичайних ручок або телефонів та інших предметів ( іл. 10.6 ). Людина, яка брала таку річ у руки, у кращому випадку залишалася


сюрпризів. Для більшої Іл. 10.6. Міни-пастки у вигляді: а) ручки; б) мобільних телефонів
наочності українські військові сапери навіть організовували своєрідну виставку «мін-сюрпризів».
напад на осіб, які покидають на парашуті
апарат, що зазнав аварії (або тих, які рятуються від наслідків корабельної аварії), і не чинять ворожих дій; застереження тих, хто обороняється, що в разі продовження опору нікому з них не буде пощади, та віддача наказу нікого не залишати в живих; убивство парламентера й супроводжуючих його осіб — сурмача, барабанщика; незаконне використання парламентерського прапора, прапора нейтральної держави, прапора або розпізнавальних знаків Червоного Хреста, білого прапора парламентера, форменого одягу супротивника, емблеми ООН, окрім як з дозволу цієї організації; примушення громадян ворожої сторони воювати проти своєї держави та взяття заручників, терор стосовно цивільного населення, використання голоду серед цивільного населення для досягнення військових цілей тощо.
Додатковий протокол І (1977) вважає, що: «Заборонено вбивати, наносити поранення або брати в полон супротивника за допомогою віроломства». Приклади віроломства: а) симулювання наміру
під прапором перемир’я або симулювання капітуляції; б) симулювання поранення або хвороби
хитрість, якщо вона не суперечить міжнародному гуманітарному праву. До неї належать дії, що дезорієнтують супротивника, щодо стану, положення і характеру дій
діями є, наприклад: маскування (з використанням умов місцевості, камуфляжних фарб, маскувальних сіток, димів); використання
осіб та об’єктів МГП захищає осіб, які не беруть участі у воєнних діях, а також тих, які перестали брати в них участь у результаті хвороби, поранення або будьякої іншої причини, незалежно від їх раси, кольору шкіри, політичних, релігійних та інших переконань, статі, етнічного та соціального походження, майнового стану, місця проживання, мови або інших ознак. Особи, які перебувають під захистом МГП:

та воєнні злочини під час війни в Україні. Російські загарбники неодноразово вчиняли тяжкі злочини проти українських полонених, що є порушенням правил і звичаїв війни. Наприклад, на фото звільнених українських бранок видно ( іл. 10.7 ), що їм поголили голови, ще, за словами міністерки Верещук
реінтеграції, росіяни змушували їх роздягатися, не дозволяли сідати та принижували; їй відомі випадки зґвалтувань Цивільні особи мають захист, за винятком окремих випадків і періоду,
діях. У разі сумнівів щодо того, чи є особа цивільною, її
МГП також встановлює захист об’єктів, які не мають військового значення, обмежує у
і методів ведення війни. Командири зобов’язані знати, які об’єкти в зоні дій підпорядкованих їм підрозділів перебувають під захистом МГП, а які є військовими об’єктами, і відповідно проводити бойові дії.

Іл. 10.7. Українські бранки після звільнення з полону
Будь-який об’єкт вважають законною ціллю для нападу, якщо він через характер, місцезнаходження чи використання може бути застосований у воєнних діях, а його руйнування, захоплення чи нейтралізація надає військову перевагу.

1. Дайте визначення поняття «міжнародне гуманітарне право».
2. Які дві категорії учасників бойових дій розрізняє МГП? Хто до них належить?
3. Хто належить до найманців? Чим вони відрізняються від добровольців (волонтерів / волонтерок)?

4. Яких принципів МГП слід дотримувати під час воєнних дій?
5. Які особи перебувають під захистом МГП?
6. Що відрізняє: а) віроломство від воєнної хитрості; б) розвідника від шпигуна?

(1949 р.) про захист жертв війни: «Про поліпшення становища поранених і хворих у діючих арміях» (Конвенція I), «Про поліпшення становища поранених, хворих і осіб, які зазнали корабельної аварії, зі складу озброєних сил на морі» (Конвенція II), «Про поводження з військовополоненими» (Конвенція III), «Про захист цивільного населення під час війни» (Конвенція IV) і Додаткові Протоколи до них. Протокол I стосувався захисту жертв міжнародних озброєних конфліктів, Протокол II — захисту жертв збройних конфліктів неміжнародного характеру. У 2005 р.
кової розпізнавальної емблеми», який

Іл. 11.1. Розпізнавальні емблеми міжнародного гуманітарного Руху Червоного
Хреста і Червоного Півмісяця: а — червоний хрест; б — червоний півмісяць; в — червоний кристал
емблему Міжнародного руху Червоного
му тлі, що стоїть на одній зі своїх вершин, — «червоний кристал». Цю емблему визнають поряд із розпізнавальними емблемами Женевських конвенцій та з тими самими цілями. Отже, усі ці розпізнавальні емблеми набули однакового статусу ( іл. 11.1 ).

До жертв будь-якого збройного конфлікту (війни) належать: військовополонені чи інші особи, воля яких обмежена через збройний конфлікт; поранені та хворі; особи, які зазнали корабельної аварії (аварії
нені» і «хворі» стосуються як
так і некомбатантів. Крім того, до військовополонених належать захоплені супротивником: а) особовий склад ополчення і добровольчих загонів, що входять до складу
збройних сил; б) особовий склад збройних сил, що підпорядковується уряду, не визнаному державою, яка тримає в полоні; в) воєнні кореспонденти, постачальники, інші особи, які супроводжують
збройні сили; г) члени екіпажу торгового флоту та цивільної авіації; партизани; ґ) населення неокупованої території, що взялося за зброю і ще не долучилося до регулярних військ, якщо воно відкрито носить зброю і дотримує законів і звичаїв війни.

Стосовно осіб, зазначених вище, МГП забороняє: зазіхати на життя і фізичну недоторканність; брати в заручники; зазіхати на людську гідність; без судового рішення засуджувати і застосовувати покарання.
Усім пораненим, хворим і особам, що зазнали ї аварії корабля (літального апарата), незалежно від того, до якої сторони вони належать, у максимально можливій формі та в найкоротші терміни надають медичну допомогу й догляд.

Поранених (хворих) армійців, які потрапили під владу ворога, вважають військовополоненими; до них мають застосовувати режим військового полону.
Військовополонені перебувають у владі ворожої держави, а не окремих осіб або військових частин.
Військовий полон — не покарання і не помста, це — тимчасове
обмеження можливості брати участь у бойових діях.
Держава, що тримає в полоні, відповідає за поводження з військовополоненими. Військовополонені не можуть бути піддані каліченню, науковим і медичним дослідам. До них не можна застосовувати репресії. Військовополонені мають
й захисту та мають право на гуманне поводження. Їм мають надати медичну допомогу в максимально можливому обсязі й щонайшвидше.
Особа, безвісно відсутня, — людина, що зникла під час ведення воєнних дій і місцезнаходження якої невідоме.
Загиблі (померлі) — особи, які загинули з причин, пов’язаних із веденням воєнних дій. Останки таких осіб, у тому числі й тих, хто не є громадянами держави, у якій вони загинули, потрібно поважати. Місця поховань таких осіб утримують й позначають так, щоб їх завжди можна було розшукати. Організація своєчасного виносу
померлих військовослужбовців

чинити
уживати примусових
чи морального порядку, зокрема для одержання відомостей;
в) застосовувати катування, тілесні покарання, проводити медичні досліди тощо;
г) застосовувати колективні покарання; ґ) захоплювати заручників;
д) депортувати цивільне населення з окупованої території.
Найважливішим правилом четвертої Женевської
міжнародного гуманітарного
зокрема під час окупації.
Цим правилом нехтують
чи примушуючи українських громадян до служби в російській армії. Російські окупанти свавільно вбивають і катують цивільних, ґвалтують жінок і дітей, розстрілюють лікарів, священнослужителів і журналістів. В оточених або захоплених Росією містах немає
на військові об’єкти, а медичний персонал має бути забезпечений розпізнавальними емблемами та знаками. Розпізнавання об’єктів і персоналу медичного, духовного, цивільної оборони, особливо небезпечних об’єктів та культурних цінностей здійснюють, використовуючи розпізнавальні емблеми (знаки), а для медичних формувань та санітарно-транспортних засобів ще й чинні розпізнавальні сигнали.
Усі медичні формування та персонал, які мають емблеми Червоного Хреста, Півмісяця та Кристала як захисний знак, зобов’язані наносити ці емблеми на прапори, будівлі, установи і майно рухомих медичних формувань, на нарукавні пов’язки, одяг і головні убори медичного персоналу. Емблему Червоного Хреста використовує медична служба ЗСУ під час збройних конфліктів для позначення власного медичного персоналу, медичних формувань і санітарно-транспортних засобів на суші, морі та в повітрі.
Медичний персонал зобов’язаний, крім нарукавних пов’язок з емблемою Червоного Хреста, мати посвідчення з емблеми Червоного Хреста і з фото, що зроблені відповідно до вимог, які наведені в Д одатковому протоколі І до Женевських Конвенцій . Ці пов’язки та посвідчення видає у встановленому порядку МО України.
Персонал духовний, цивільної оборони та той, що призначений для охорони культурних цінностей, повинен мати посвідчення особи, що підтверджує їхній статус.
Світловий сигнал подають у вигляді спалахів блакитного кольору (частота від
60 до 100 спалахів / хв) і використовують для розпізнавання санітарних літальних
апаратів, наземних санітарно-транспортних засобів і санітарних суден.
Радіосигнал — це радіотелефонне або радіотелеграфне повідомлення. Використання сигналу пріоритету (терміновості) дозволено винятково медичним формуванням і санітарно-транспортним засобам.
Електронне розпізнавання санітарного літального апарата і спостереження за його курсом забезпечене застосуванням системи повторного радіолокаційного


Рівненська, Південноукраїнська та Хмельницька були відключені
ракетної атаки, яку 23 листопада 2022 року здійснила Російська Федерація про об’єктах енергетичної інфраструктури по всій країні. Від 4 березня 2022 року найбільша в
станція та місто-супутник ЗАЕС – Енергодар — перебувала під окупацією російських військ. Вони створили реальну загрозу виникнення ядерної катастрофи. Наша країна пам’ятає страшні наслідки аварії на ЧАЕС 1986 року, а Росія дозволяла собі шантажувати весь світ загрозою використання ядерних об’єктів та технологій. Атака й захоплення Чорнобильської та Запорізької атомних електростанцій є грубим порушенням Договору про нерозповсюдження ядерної зброї та Міжнародної Конвенції про боротьбу з актами ядерного тероризму та звичаєвого міжнародного гуманітарного права. Об’єкти цивільної оборони — це сховища, які призначено для захисту населення (бомбосховища, протирадіаційні укриття, пункти управління тощо). Цивільними об’єктами вважають усі об’єкти, що не є військовими. У разі сумнівів щодо використання цивільного об’єкта у
його вважають цивільним.
Санітарні зони (місцевості) створюють для захисту хворих і поранених, а також персоналу, на який покладена організація таких зон, управління ними і догляд за особами, що там перебуватимуть.
Демілітаризовані зони — це зони, з яких за згодою обох сторін, що перебувають у збройному конфлікті, виведені всі комбатанти та мобільні бойові засоби.

основних напрями міжнародно-правового захисту жінок в умовах війни: а) як частини цивільного населення; б) як жінок-учасниць військових дій.
Перший напрям залежно від періоду початку й вирішення збройного конфлікту можливо диференціювати на: а) захист жінок від поганого поводження з ними стороною в конфлікті, у владі якої вони опинилися; б) захист жінок від наслідків військових дій.
У
другому напрямі виокремлюють: а) дотримання статусу жінок-комбатантів; б) поводження з жінками-комбатантами як з військовополоненими.
Захист дітей МГП передбачає особливу повагу.
У дітей має бути право на: отримання освіти; возз’єднання сімей, які були розлучені під час збройного конфлікту; неучасть у воєнних діях до вісімнадцяти років; особливий захист до вісімнадцяти років навіть у разі, коли вони брали участь в бойових діях і потрапили в полон; евакуацію з району воєнних дій (за необхідності й за узгодженням з батьками чи з особами, які їх заміняють). Сторони, що перебувають у конфлікті, уживають усіх практично можливих заходів для того, щоб діти, які не досягли 15-річного віку, не брали безпосередньої участі у військових діях. Зокрема, сторони утримуються від вербування їх у збройні сили. Якщо ж такі діти попри все беруть участь у військових
ють особливий захист, незалежно є вони

418 дітей, іще понад 789 поранили від початку повномасштабного вторгнення. Ці цифри не остаточні, оскільки триває робота з їх встановлення в місцях ведення активних
дій, на тимчасово окупованих територіях та територіях, які звільняють ЗСУ.
Існує безліч свідчень того, що російські окупаційні війська вчиняють систематичні військові злочини у кожному регіоні України, який перебуває під їхнім контролем. Про це заявила посолка із особливих доручень у справах глобального кримінального правосуддя
електрики та тепла. Це дія, яка прирівнюється до військового злочину. Посол запевнила, що США підтримують Міжнародний кримінальний суд, українську Генеральну прокуратуру, яка
інцидентів, які можуть мати статус військових злочинів, а також Слідчу комісію ООН та європейську спільну слідчу групу. Дані про злочини Росії в Україні до Міжнародного

1.
3.
4.
5.
6.

Яку роль відіграє дисципліна та самодисципліна в житті будьякої людини? Чи можна без неї досягнуть успіху в житті?
Поняття про військові статути

Статути ЗСУ — це зведення законів військової служби, які лежать в основі повсякденного життя, виховання, навчання та бойової діяльності військ. Вони роз’ясняють, як воїн має нести військову службу і навчатися військової справи, якими морально-бойовими якостями він повинен володіти, щоб бути надійним та умілим захисником Батьківщини.
Статути зобов’язують військовослужбовців сумлінно виконувати військовий обов’язок, вивчати військову справу, бойову техніку і зброю, запам’ятовувати все, чого навчають командири, зразково виконувати показані їм військові прийоми. Положення і вимоги статутів є обов’язковими для всіх військовослужбовців Збройних сил України. Правила поведінки і діяльності, урегульовані ними, мають правовий, обов’язковий для виконання всіма військовослужбовцями характер. Реформування ЗСУ передбачає зміни статутів. Статути будуть демократичнішими, а елементи підготовки адаптують до практики західних країн. ЗСУ мають перейти на стандарти НАТО до 2020 р. Це не тільки сприйняття технічних стандартів; це й інша культура воєнного планування, діяльності та військово-громадянських відносин. Статути ЗСУ поділяють на загальновійськові та статути родів військ . До загальновійськових статутів належать: а) Статут внутрішньої служби ЗСУ; б) Дисциплінарний статут ЗСУ; в) Статут гарнізонної та вартової служб ЗСУ; г) Стройовий статут ЗСУ.
Статут внутрішньої служби ЗСУ визначає
та
військовослужбовців і взаємовідносини, правила внутрішнього порядку у військовій частині та її підрозділах. Дисциплінарний статут ЗСУ висвітлює сутність військової дисципліни, обов’язки військовослужбовців, а також військовозобов’язаних та резервістів під час проходження

Військове
фахової підготовки та терміну служби.
одних військовослужбовців стосовно до інших.
ЗСУ мають два типи рангів — армійські, які використовують у Сухопутних військах, Повітряних силах, Силах спеціальних операцій, Десантно-штурмових військах, і морські — для Військово-Морських сил ( табл. 12.1 ). Таблиця 12.1
корабельний старшина
Штаб-сержант
Майстер-сержант Майстер-старшина
Старший майстер-сержант Старший майстерстаршина
Головний майстерсержант
Головний майстерстаршина
OR8 старшина роти
головний сержант бригади
головний сержант роду військ
головний сержант роду військ, головний сержант ЗСУ
Знаки розрізнення до форменого одягу
1. Нарукавний знак «Державний Прапор України» (праве та ліве передпліччя в місці, передбаченому конструкцією).
2. Нарукавний знак військової частини, навчального закладу (в місці, передбаченому конструкцією).
3. Нарукавний знак або знак за курсами навчання (в місці, передбаченому конструкцією).
4. Знаки розрізнення військових звань ( іл. 12.2 ).
5. Нагрудний знак з прізвищем військовослужбовця (в місці, передбаченому конструкцією).

Іл. 12.1. Знаки розрізнення до форменого одягу
6. Нагрудний знак «Збройні Сили України».

розміщені
ськової символіки.
знак може мати форму таблички із зазначенням прізвища, групи крові, належності
тощо та містити затверджені державні символи.
Нарукавний знак означає належність до держави, військового формування тощо.
Кокарда — знак установленого зразка на головному уборі. Кокарду, як правило, прикріплюють у центрі кашкета, кепі, шапки або іншого
ного убору.
Беретний знак прикріплюють ліворуч від центру берета.
Емблема означає належність військовослужбовців до держави, відповідного військового формування тощо. Емблеми розміщують на лацканах кітеля з обох боків.
На ґудзиках зображено затверджені елементи державної або відомчої символіки.
Позумент — плетений золотавими або сріблястими нитками шнур. Позумент використовують для обладнання
кетів) або погонів.
Кант
Використовується




Іл. 12.4.
зірка


Іл. 12.5. Зірки та знак у вигляді «плетінки» вирізняє cтарших офіцерів Іл. 12.6. Знак категорії вищих офіцерів у вигляді т. зв. «зубчатки»
Знаки розрізнення
(V-подібна нашивка з галуна) ( іл. 12.7 ).
силах УНР (1917–1919). Ще одним елементом сержантських
( іл. 12.8 ). Комбінування



інших військовослужбовців.
Начальник
Підлеглий
Начальники, яким
службою, у тому числі і тимчасово, є
бовців. Найближчий
Дотримання військовослужбовцями статутних взаємовідносин. Порядок звернення до начальників, віддавання і виконання
й старші за військовим званням військовослужбовці у питаннях служби до підлеглих і молодших звертаються за військовим званням і прізвищем або тільки за званням, додаючи в останньому випадку перед званням слово «пане (пані)». Наприклад: «Солдат Черняк», «Пане (пані) солдат»; «Сержанте Мішин», «Пане (пані) сержанте»; «Лейтенанте Малишенко», «Пане (пані) лейтенанте». Військовослужбовці під час звертання до них командира (начальника) або старшого за військовим званням повинні стати у стройове положення. Підлеглі й молодші за військовим званням звертаються у службових справах до командирів (начальників) і
додаючи перед званням слово «Пане (пані)». Наприклад: «Пане (пані) лейтенанте». За необхідності звернутися до іншого військовослужбовця в присутності командира (начальника) або старшого за військовим званням, слід попросити на це дозволу командира (начальника) або старшого за військовим званням. Наприклад: «Пане (пані) полковнику, дозвольте звернутися до майора Іващенка».
Під час звертання один до одного поза строєм, а також у разі віддавання чи отримання наказу військовослужбовці повинні стати у стройове положення, а ті, що знаходяться у головному уборі, прикладають руку до нього. Доповідаючи чи вислуховуючи рапорт, військовослужбовець прикладає руку до головного убору і опускає її після закінчення доповіді. Якщо перед доповіддю
Військовослужбовці повинні постійно
ром (начальником) або старшим за
ший
би обігнати командира (начальника) або старшого
слід попросити у нього на це дозволу.
Військовослужбовцям забороняється тримати руки
одягу, а також сидіти у присутності командира (начальника) або старшого за військовим званням без його дозволу.
Курити дозволяється тільки у спеціально відведених для цього місцях. Військовослужбовці повинні бути ввічливими у спілкуванні з іншими особами, виявляти особливу увагу до осіб похилого віку, жінок і дітей, поступатися їм місцем у громадському транспорті, сприяти захистові честі й гідності громадян, додержанню громадського порядку, а також подавати допомогу при нещасних випадках, виникненні пожежі чи стихійного лиха. Військова дисципліна, її суть і значення.

сті за захист Вітчизни, незалежності
Військова дисципліна зобов’язує кожного військовослужбовця: додержувати Конституції та законів України, Військової присяги, неухильно виконувати вимоги військових статутів, накази командирів; бути пильним, зберігати державну та військову таємницю;
додержувати визначених військовими статутами правил взаємовідносин між військовослужбовцями, зміцнювати військове товариство; виявляти повагу до командирів і товаришів, додержувати військового
етикету;
поводитися з гідністю, не допускати самому
гідних вчинків; не
визначеного Законом України «Про оборону України».
Діяльність командира щодо підтримання військової дисципліни оцінюють не кількістю накладених ним дисциплінарних стягнень, а виконанням обов’язків з додержанням вимог законів і статутів ЗСУ, повним використанням дисциплінарної влади для дотримання порядку і запобігання порушенням військової дисципліни. Тому кожний військовослужбовець зобов’язаний сприяти командирові в постійному підтриманні порядку й дисципліни. Командир, який не
та
цього обов’язку.
Заохочення та стягнення, що
військовослужбовців за старанність, розумну ініціативу та сумлінне
нання службових обов’язків.
До військовослужбовців застосовуються такі заохочення:
а) схвалення; б) подяка; б-1) дострокове зняття раніше накладеного дисциплінарного стягнення; в) додаткове звільнення з розташування військової частини або корабля на берег поза чергою (для військовослужбовців строкової військової
закладів, військових навчальних підрозділів закладів
(вступу) на військову службу про зразкове виконання ним військового обов’язку та отримані заохочення; ґ) додаткова відпустка строком до 5 діб (для військовослужбовців строкової військової служби); д) грамота; е) цінний подарунок; є) грошова премія; ж) анесення прізвища військовослужбовця до Книги пошани військової частини (корабля); з) дострокове присвоєння чергового військового звання; и) почесні нагрудні знаки; і) відомчі заохочувальні відзнаки.

За невиконання (неналежне виконання) військовослужбовцем своїх службових обов’язків
е) пониження у військовому званні на один ступінь (стосовно осіб сержантського (старшинського) та офіцерського складу); є) пониження у військовому званні з переведенням на нижчу посаду (стосовно військовослужбовців сержантського (старшинського) складу); ж) звільнення з військової служби через службову невідповідність (крім осіб, які проходять строкову військову службу, військову службу за призовом під час мобілізації на особливий період, військову службу за призовом осіб офіцерського складу, а також військовозобов’язаних під час проходження навчальних (перевірочних) і спеціальних зборів та резервістів під час проходження підготовки та зборів).

1. Які є загальновійськові статути ЗСУ? Яке їх призначення ?
2. Які військові звання встановлені в ЗСУ? Відповідно до якого документу України зроблено це? Яке призначення військових звань?
3. Які знаки розрізнення є на форменому одязі та формених головних уборах військовослужбовців ЗСУ?
4. Що таке військова дисципліна? Яка її суть і значення?
5. Які обов’язки військовослужбовців з дотримання військової дисципліни?
6. Чим визначають стан військової дисципліни у військовій частині, закладі, установі та організації?
7. Які заохочення накладають на солдат (матросів), сержантів (старшин).
8. Які стягнення накладають на солдат (матросів), сержантів (старшин).



побутового обслуговування, відпочинку та харчування.
Для військовослужбовців строкової служби й курсантів військових навчальних закладів, навчальних центрів, військових частин встановлюють шестиденний робочий тиждень з одним вихідним днем. Тривалість робочого тижня визначає закон.
Військові навчання, походи
виконання. У розпорядку дня має бути передбачений час для: проведення ранкових процедур (зарядки, огляду), ранкового й вечірнього туалету; навчальних занять і підготовки до них; для інструктажу та розводу добового наряду;
зміни спеціального (робочого) одягу, чищення одягу, взуття, миття рук перед їжею, харчування, обслуговування озброєння, бойової та іншої техніки; гуманітарної, культурно-освітньої та спортивно-масової роботи, слухання радіо й перегляду телепередач, інших медіа-ресурсів; огляд хворих у медичному пункті, приймання військовослужбовців командуванням з особистих питань, відвідування військовослужбовців; особистих потреб, вечірньої прогулянки, вечірньої перевірки
головному сержантові роти або особі, яка його заміщує, про готовність роти до огляду. За командою головного сержанта роти головні сержанти (заступники командирів) взводів і командири
вий огляд. На ранкових оглядах перевіряється наявність особового складу, зовнішній вигляд і додержання правил особистої гігієни.
Черговий роти вносить до книги запису хворих прізвища військовослужбовців, які хочуть звернутися за медичною допомогою до медичного пункту частини.
У дні відпочинку ранкову фізичну гімнастику не проводять.
У передбачений розпорядком дня час під керівництвом головного сер-
жанта роти або одного з головних сержантів (заступників командирів) взводів проводиться вечірня прогулянка. Під час вечірньої прогулянки особовий склад строкової військової служби виконує стройові пісні у складі підрозділів. Після прогулянки за командою чергового роти « Рота, на вечірню повірку — СТАВАЙ » головні сержанти (заступники командирів) взводів та командири відділень шикують свої підрозділи для перевірки особового складу. Черговий роти доповідає
особі, яка його заміщує, про готовність роти до вечірньої
віддавши команду « Струнко », розпочинає вечірню повірку,
ща військовослужбовців, зарахованих наказом Міністра оборони України
прізвище військовослужбовця, доповідає: « Військове
Після цього головний
роти перевіряє особовий склад із числа військовослужбовців строкової військової служби за іменним списком. Почувши своє прізвище, кожен відповідає: « Я ». За відсутніх відповідає командир відділення (екіпажу, обслуги). Наприклад: « У відпустці », « У наряді ».
Після перевірки особового складу головний сержант роти уточнює бойовий, пожежний розрахунки на випадок приведення військової частини в бойову готовність (переведення на функціонування
суден і для льотного складу). Приготування їжі має бути закінчено за 30 хвилин до встановленого розпорядком дня терміну її приймання.
Військовослужбовці строкової служби приходять до їдальні в чистому взутті та одязі строєм під командою старшини роти або заступника командира взводу. У їдальні заборонено споживати їжу в головному уборі, польовій утепленій куртці, спеціальному (робочому) одязі.
Військовослужбовці, що в добовому наряді, їдять у визначений командиром військової частини час.
Проміжок між харчуванням не може перевищувати 7 годин. Після обіду протягом не менше ніж 30 хвилин заняття не проводяться
виконуються.
діяльності військовослужбовців
мандир, який їх затвердив ( іл. 13.1 ).


Іл. 13.1. Навчальні заняття з бойової підготовки На навчаннях має бути присутнім весь особовий склад військової частини (підрозділу). Від навчань звільняють осіб, що перебувають у добовому наряді. Заняття розпочинаються і закінчуються за сигналом у час, визначений розпорядком. Перед виходом на заняття командири відділень і головні сержанти (заступники командирів) взводів перевіряють наявність підлеглих і переконуються, чи додержано правил носіння одягу, чи правильно припасовано спорядження, чи розряджена зброя. Після закінчення занять і навчань командири підрозділів перевіряють, чи розряджена зброя, наявність і комплектність озброєння, бойової техніки, навчально-тренувальних засобів, а також наявність стрілецької зброї та боєприпасів. Результати перевірки доповідаються за підпорядкованістю. Невикористані боєприпаси та гільзи здаються в установленому порядку. Зброя чиститься, здійснюється технічне
відпочинку

частини, а під час звільнення — і в межах гарнізону.
Виїзд військовослужбовців строкової військової служби за
гарнізону (за винятком випадків
або відрядження) забороняється.
Військовослужбовці строкової військової служби, які не мають дисциплінарного стягнення у вигляді позбавлення права на чергове звільнення, користуються правом на звільнення з розташування військової частини. При цьому звільнення військовослужбовців здійснюється в такій черговості, щоб це не призводило до зниження рівня бойової готовності військової частини та якості бойового чергування. Військовослужбовців строкової
вання військової частини командир роти в установленому
військової частини порядку. Військовослужбовці одержують право на звільнення з розташування військової частини після складання ними Військової присяги.
Дозвіл на звільнення дається почергово. Черговість звільнень контролюють головні сержанти (заступники командирів) взводів.

Відвідувати військовослужбовців як строкової (контрактної) служби дозволяють у час, визначений розпорядком дня, у відведеній для цього кімнаті військової частини.
Повсякденна діяльність у будь-якій обстановці має здійснюватися з
створення здорових умов їхньої служби і побуту.
Розміщення військовослужбовців в польових умовах
них таборах. Межі
заборонено,
ливості, повинно
розбивається на прямокутні квартали повздовжніми та поперечними лініями, які є водночас і шляхами сполучення ( іл. 13.2 ).
У глибину табір розділяється на смуги трьома паралельними до фронту табору лініями — передньою, середньою
глибину визначається системою розміщення наметів, необхідних споруд та обладнання. Ширина передньої лінії має бути не менше ніж 10 м, середньої та задньої ліній — не менше, ніж 5 м. Між рядами наметів у глибину табору обладнуються доріжки завширшки до 3 м. Для руху техніки вздовж розташування табору в його тилу обладнуються дороги окремо для колісних і для гусеничних машин.
Перпендикулярно до фронту табір розділяють поперечними лініями, які прокладають між батальйонами та окремими підрозділами військової частини. За ділянкою табору між поперечними лініями

приміщення (намети) для зберігання зброї, поблизу яких обладнуються місця для чищення зброї, а за ними — погрібці для води та умивальники.
У другій смузі (між середньою і задньою лініями) розміщують штаб військової частини, медичний пункт і їдальня, погрібці для води та умивальники.
У третій смузі (між задньою лінією та дорогою для техніки) розміщують туалети, склади, майстерні та інші господарські споруди.

Склади боєприпасів та
розміщують за межами табору.
Гімнастичні містечка та майданчики
ються, як правило, неподалік
15 м від наметів та дерев.
Навколо стоянки техніки повинна
Похідні кухні встановлюють на
спортивних ігор
хвойних дерев, 25 м — від наметів. Майданчики для кухонь у радіусі 5 м очищаються від моху, чагарнику та іншого рослинного покриву.
заливають водою і засипають піском.

1. Дайте визначення поняття «внутрішній порядок».
2. Яка мета розподілу часу у військовій частині? Хто його встановлює?
3. Що можна здійснювати в будь-які дні тижня без обмеження загальної тривалості службового часу?
4. Що має бути передбачено в розпорядку дня
5.
6.
7.

строї підрозділів та військових частин у пішому порядку і на машинах; порядок виконання військового вітання, проведення стройового огляду; місце Бойового Прапора військової частини у строю, порядок його внесення і винесення; обов’язки військовослужбовців перед шикуванням і в строю та вимоги до їх стройового навчання. Статут обов’язковий для всіх військових частин, управлінь, штабів, організацій, установ і військових навчальних закладів.

одній лінії одна біля одної.
Фланг — правий (лівий) край строю. Під час поворотів назви флангів не змінюються.
Фронт — бік строю, до якого
повернені обличчям, а машини — лобовою частиною.
Інтервал — відстань по фронту між військовослужбовцями (машинами), підрозділами та частинами.
Дистанція — відстань у глибину між військовослужбовцями (машинами), підрозділами та частинами.
Ширина строю — відстань між флангами.
Глибина
шеренги, такий ряд називають неповним; останній ряд завжди має бути повним. Після повороту двошеренгового строю кругом військовослужбовець неповного ряду самостійно стає в першу шеренгу.
Одношеренговий (шеренга) і двошеренговий строї можуть бути зімкнутими або розімкнутими. У зімкнутому строю військовослужбовці в шеренгах розміщені по фронту один від одного з інтервалами на ширину долоні між ліктями. У розімкнутому строю військовослужбовці в шеренгах розміщені по фронту один від одного з інтервалами на один крок або з інтервалами, які визначає командир.
Колона — стрій, у якому військовослужбовці або підрозділи (машини) розміщені один (одна) за одним (одною) на дистанціях, установлених Статутом або командиром. Колони можуть бути вишикувані по одному, по два, по три, по чотири та більше військовослужбовців. Колони застосовують для шикування військовослужбовців, підрозділів і частин у розгорнутий або похідний стрій. Розгорнутий стрій — стрій, у якому військовослужбовці, підрозділи (машини) вишикувані на одній лінії
фронту в одношеренговому чи двошеренговому строю (в лінію машин) або в лінію колон з інтервалами, установленими Статутом або командиром. Розгорнутий стрій застосовують для проведення перевірок, розподілу, оглядів, парадів, а також в інших необхідних випадках. Похідний стрій — стрій, у якому підрозділ вишикуваний у
підрозділи в колонах вишикувані один
дистанціях, установлених Статутом або командиром. Похідний стрій застосовують для пересування підрозділів, проходження урочистим
ших необхідних випадках.
Напрямний — військовослужбовець (підрозділ, машина), що рухається на чолі строю у визначеному напрямку. За напрямним має переміщуватися решта військовослужбовців (підрозділів, машин).
Замикаючий — військовослужбовець (підрозділ), який рухається останнім у колоні.
Лінійний — військовослужбовець, призначений для позначення лінії шикування підрозділів і частин, а також
маршем.
Підготовча та

повертаються вбік начальника та приймають стройове положення.
здійснюють негайно й точно. З метою привернути увагу підрозділу або окремого військовослужбовця в підготовчій команді, у разі потреби, називають підрозділ
військове звання військовослужбовця. Наприклад: « Взвод (3-й взвод) — СТІЙ »; « Солдат Левченко, кру-ГОМ ».
Під час виконання прийомів
команді можуть
значати назву зброї, наприклад: « Автомати на — ГРУДИ »; « Кулемети на ре-МІНЬ » тощо.
Гучність
час
ГА », а якщо
сигналом
сигнал, який стосується цього підрозділу. Відповідні сигнали, що позначають підрозділи, встановлює командир частини.
Щоб припинити виконання прийому, подають команду « ВІДСТАВИТИ ». За цією командою приймають положення, яке було до виконання прийому.
Під час навчання дозволено виконання зазначених у Статуті стройових прийомів і рухів за розподілом, а також з допомогою підготовчих вправ, наприклад: « Автомат на груди, за розподілом: роби — РАЗ, роби — ДВА, роби — ТРИ»; «Праворуч, за розподілом: роби — РАЗ, роби — ДВА ». Виконання команд «СТАВАЙ», «РІВНЯЙСЬ», «СТРУНКО», «ВІЛЬНО» Шикування військовослужбовців здійснюють за командою « СТАВАЙ ». За цією командою треба швидко стати в стрій
і дистанцію, підбори
Після закінчення рівняння подають команду « СТРУНКО », за якою всі військовослужбовці приймають стройове положення — швидко повертають голову прямо, а карабіни (кулемети) приводять у попереднє положення. За командою « ВІЛЬНО » слід відставити ліву ногу в сторону на ширину плечей, а руки завести за спину, треба бути уважним і не розмовляти (іл. 14.1). Після команди « ВІЛЬНО » може бути подана команда « ЗАПРАВИТИСЬ », за якою, не залишаючи сво-
го місця в строю, потрібно поправити зброю, обмун-
дирування та спорядження у разі потреби вийти із

Іл.14.1. Виконання команди «ВІЛЬНО» строю — звернутися за дозволом до безпосереднього командира (начальника); можна розмовляти тільки з дозволу старшого командира.

1. Що визначає Стройовий статут ЗСУ?
2. Що таке стрій військовослужбовців, підрозділів і частин? Назвіть його елементи.
3. Які розрізняють дві команди? Як їх подають?
4. Як виконують команду « СТАВАЙ »?
5. Для чого подають команду « РІВНЯЙСЬ »? Як її виконують?

6. Як військовослужбовець має виконувати

триматися прямо, без напруження, підбори поставити разом, а носки розвести по лінії фронту на ширину стопи; ноги в

ліво – РУЧ », « Кру – ГОМ ».
Повороти виконуються на два рахунки ( іл. 15.2, 15.3 ):
на рахунок «раз» військовослужбовці повертаються у визначений
бік, зберігаючи правильне поло-
ження корпусу та не згинаючи
ніг у колінах, переносять вагу
тіла на ногу, що попереду;
на рахунок «два» — найкорот-
шим шляхом приставляють другу ногу.


на кроку — 70–80 см. Нормальна швидкість
(малими літерами — підготовча команда, великими — виконавча). За підготовчою командою треба подати
ред, перенести вагу тіла більше


команду подають одночасно з поставленням правої ноги на землю. За цією командою слід зробити ще два
кроком.
Позначення кроку (бігу)
цією командою крок слід позначати підніманням та
піднімати на 15–20 см від землі

припинити рух, подають команду, наприклад: « Солдат Петренко — СТІЙ ». За виконавчою командою, яку подають одночасно з поставленням правої
на землю, слід зробити ще один крок і, приставивши ногу, прийняти стройове положення. Щоб змінити швидкість руху, подають команди: « ДОВШИЙ
КРОК », « КОРОТШИЙ КРОК », « ЧАСТІШИЙ КРОК », « РІДШИЙ КРОК », « ПІВКРОКУ », « ПОВНИЙ КРОК ».
Щоб перемістити поодиноких військовослужбовців на кілька кроків убік, подають команду, наприклад: « Солдат Гнатюк. Два кроки праворуч (ліворуч), кроком — РУШ ». За цією командою військовослужбовець робить два кроки праворуч (ліворуч), приставляючи ногу після кожного кроку. Для переміщення вперед або назад на кілька кроків подають команду, наприклад: « Два кроки вперед (назад),
ногу на півкроку вперед, трохи ліворуч і, різко
ніг (на рахунок «два»), рухатися далі з лівої ноги в новому напрямку (на рахунок «три»).
Під час поворотів рух руками здійснюють у такт кроку.

Повороти та півоберти праворуч і ліворуч під час руху бігом виконують за тими самими командами,

1. За якої умови стройове положення
2.
кожен із
руху?
3. Яку команду подають для переміщення поодиноких військовос-
4. Які команди
конувати?

5. За якою командою приймають стройове положення


обслуга) складається із чотирьох і менше осіб, то завжди шикується в одну шеренгу. Щоб вирівняти відділення на місці, подають команда « РІВНЯЙСЬ » або « Ліворуч — РІВНЯЙСЬ ». За командою «Рівняйсь» усі, крім правофлангового, повертають голову праворуч (праве вухо вище від лівого, підборіддя трохи підняте) і вирівнюються так, щоб кожен бачив груди четвертої особи, вважаючи себе першим.
За командою « Ліворуч — рівняйсь » усі, крім лівофлангового, повертають голову ліворуч (ліве вухо вище від правого, підборіддя трохи підняте).
Під час рівняння військовослужбовці можуть трохи пересуватися вперед, назад або в той чи інший бік. Після закінчення рівняння подають команду « СТРУНКО ».
Під час рівняння відділення після повороту його кругом у наступній команді вказують бік рівняння, наприклад: « Праворуч (ліворуч) — РІВНЯЙСЬ ».
За командою « Відділення — РОЗІЙДИСЬ » військовослужбовці виходять зі строю. Для збору відділення подають команду « Відділення — ДО МЕНЕ », за якою військовослужбовці бігом
його додатковою командою шикуються. Повороти відділення виконують усі військовослужбовці з додержанням рівняння. Після повороту відділення у двошеренговому строю праворуч/ ліворуч командир відділення робить півкроку праворуч/ліворуч, під час повороту кругом — крок уперед.
Розмикання та змикання відділення Для розмикання відділення на місці подають команду « Відділення — праворуч (ліворуч, від середини) розім-КНИСЬ» або «Відділення — праворуч (ліворуч, від середини) на стільки-то кроків розім-КНИСЬ (бігом, розім-КНИСЬ) ». За виконавчою командою всі військовослужбовці, за винятком того, від якого здійснюють розмикання, повертаються у вказаний бік, одночасно приставляючи ногу, повертають голову в напрямку фронту строю і рухаються прискореним півкроком (бігом), дивлячись через плече на того, хто іде позаду, і не відриваючись від нього; після зупинки того, хто іде позаду, кожен робить ще стільки кроків, скільки їх визначено командою, та повертається ліворуч (праворуч).
Якщо інтервал не був визначений, розмикання проводять на один крок. Під час розмикання

повертаючи голову до військовослужбовця, який стоїть ліворуч від нього, називає свій номер і відразу повертає голову прямо; лівофланговий голову не повертає.
У такому
ДІЛИСЬ ».
У двошеренговому строю лівофланговий
ня розподілу
РУШ ». За потреби, у команді визначають напрямок
та
кроком
рівняння, наприклад: « Відділення — на такий-то предмет рівняння праворуч/ліворуч стройовим кроком — РУШ ». За командою « РУШ » усі одночасно п чинають рух із лівої ноги, додержуючи рівняння й зберігаючи інтервали та дистанції. Якщо бік рівняння
Під час повороту
робить півкроку праворуч.
Перешикування відділення з колони
дять за командою « Відділення — у колону по два, кроком — РУШ ». За виконавчою командою командир відділення (напрямний) іде півкроком, другі номери, вийшовши праворуч, у такт кроку займають свої місця в колоні; відділення рухається півкроком до команди « ПРЯМО » або « Відділення — СТІЙ ».
Перешикування відділення з колони по два в колону по одному проводять за командою « Відділення — в колону по одному, кроком — РУШ » (під час руху — « РУШ »). За виконавчою командою командир відділення (напрямний) іде повним кроком, усі інші — півкроком; із звільненням місця другі номери в такт кроку заходять за перші, рухаються далі повним кроком. Для зміни напрямку руху колони подають команди: « Відділення — правим (лівим) плечем вперед — РУШ » — напрямний (напрямні) заходить (заходять) ліворуч (праворуч) до команди « ПРЯМО », інші йдуть за ним (ними); « Відділення — за мною
(бігом
» — відділення йде за командиром; « Відділення
відділення одночасно повертається кругом.

1. За якими командами військовослужбовці виходять
гаються до командира?
2. У якому строю здійснюють рух відділення похідним кроком? Яким він може бути?
3. За якою командою та як відділення перешиковується з колони по два в колону по одному?
4. За якою командою шикується відділення в одношеренговий (двошеренговий) стрій і як це відбувається?

5. За якими командами відділення розмикається і змикається і як це відбувається?
6. Повправляйтеся з товаришами, віддаючи та виконуючи команди, згадані у тексті параграфа.


в польових умовах. Навантаження, зазвичай, підбираються відповідно до рівня свого фізичного розвитку та не є сталими. Таких вправ є досить багато, проте ми наведено ті,
Вправа
вправа дозволяє покращити кровотік в поперековому відділі хребта, задіяти інші типи м’язів, що в свою чергу значно розвантажить м’язи, які були задіяні під час виконання завдань. Вихідне положення — стоячи, ноги на ширині плечей. Нахилившись вправо, правою рукою охопити гомілку правої ноги. Ліву руку спочатку покласти долонею на праву руку, потім відвести її вверх вліво, одночасно повернувши голову вверх вліво вслід за лівою рукою. Потям
руки та позу. Виконати від 3 підходів по 8-12 повторень (відведень) на одну сторону. Вправи для відновлення після перевантаження
1. Стречінг плечових м’язів.
Вправа дозволяє розтягнути групи плечових м’язів, які тривалий час знаходились в статичному навантаженні.
Вихідне положення — сидячи зі схрещеними ногами. Випрямити руку, притиснути її трохи вище грудної клітини (паралельно підлозі). Долонею другої руки спертися на ліктьовий суглоб і як важелем намагатися максимально направити в протилежну сторону. Зафіксувати положення мінімум на 10 секунд, потім поміняти руку.
Виконується від 3 підходів по 30-40 секунд на одну сторону (помірне навантаження).

Важливо при цьому не повертати корпус.
2. Стречінг стегнових (сідничних) м’язів.
Вправа дозволяє розтягнути групи стегнових
які тривалий час знаходились під навантаженням, в тому числі статичному навантаженні.
Виконувати
навантаження).
4. Стречінг корсету спинних м’язів.
Вправа призначена для розтягування групи спинних м’язів які знаходились під навантаженням в тому числі статичному навантаженні, поліпшення кровотоку до спинного мозку та відтоку шкідливих речовин, які утворилися під час застою крові.
Вихідне положення — положення лежачи на спині. Підняти зігнуту праву ногу і, створюючи невеликий прогин в спині, перемістити її вліво, щоб коліно торкнулося підлоги. Можна допомогти собі рукою. При цьому стежити, щоб голова, лопатки і спина не відривалися від підлоги. Завмерти в такому положенні на 15 секунд і потім змінити ногу ногу.
Виконувати від 3 підходів від 60 секунд на дію (помірне навантаження).
5. Динамічні перекати з крижового до шийного відділу.
Вправа дозволяє повернути хребці в анатомічне положення, виконується на рівній та твердій поверхні.
Вихідне положення — лежачи на спині, руками охопити зігнуті колінах ноги. Повільно перекочуватись з крижового до шийного відділу, не відриваючи руки від ніг.
Виконати від 3 підходів від 12 повторень (перекатів).
6. Скручування тазостегнового суглобу.
Вправа дозволяє розтягнути групи м’язів, які знаходились під навантаженням в тому числі статичному навантаженні, поліпшити кровотік до спинного мозку та суглобових сумок тазу.
Вихідне положення — лежачи на спині, руки розведені в сторони долонями до верху, ноги зігнуті в колінах на ширині плечей. Поперемінно повертати таз та ноги вліво-вправо, не відриваючи руки та спину від підлоги.
Виконувати від 3 підходів від 60 секунд (помірне навантаження).
7. Відведення рук в упорі сидячи. Вправа для розслаблення м’язів верхнього плечового поясу, поліпшення кровотоку та самопочуття.
Вихідне положення — сидячи на в упорі на колінах. Руки долонями на підлозі
спинних м’язів які безпосередньо відіграють ключову роль в підтримці хребта.
Вихідне положення — лежачи на животі з зігнути в ліктях руками під лобом долонями до підлоги. Ноги тримати разом.
Вдихнути, одночасно піднявши голову з притиснутими до лоба руками та ноги якомога вище. В процесі стегна повинні
бути щільно притиснуті до підлоги. На видиху повернутись у
вихідне положення.
Виконується на напівм’якій рівній
3
підходів по 8 повторень.
2. Планка на ліктях.
Призначена для розвитку стійкості спинних
вого статичного навантаження.
Вихідне положення — упор лежачи, спираючись на лікті рук та на носки прямих і зведених разом ніг, руки паралельно, кисті вперед, тіло пряме, дивитись вниз на руки, не прогинатись. Утримувати таке положення протягом 20 секунд.
Здійснюється від 3 підходів для досягнення позитивного результату.
3. Бокова планка на ліктях.
вого статичного навантаження.
Вихідне положення
тою долонею, тіло пряме, ноги
разом, дивитись на долонь лівої руки, не прогинатись. Утримувати таке
положення протягом 20 секунд на
Здійснюється
результату. 4. Висока планка на прямих руках .
Вихідне положення —
Вихідне
20 секунд зі зміною ніг. 7. Висока планка зі згинанням руки.
Вихідне положення — упор лежачи, спираючись на праву руку та на носки розведених ніг, ліва руку зігнути в лікті і покласти пальцями долоні до правої сторони груді, тіло пряме, дивитись вниз на руки, не прогинатись. Утримувати таке положення протягом 20 секунд зі зміною рук. 8. Опускання на лікті та підйом на прямі руки.
Вихідне положення — упор лежачи, спираючись на пряму праву руку і
на лікоть лівої руки та на носки розведених ніг, тіло пряме, дивитись вниз
на руки, не прогинатись. Утримувати таке положення протягом 20 секунд
зі зміною положень рук.
9. Низька планка на ліктях з поворотом стегон.
Вихідне положення — упор лежачи, спираючись на лікті рук та на носки ніг, повернувши стегна вправо, руки паралельно, кисті вперед, спина пряма, дивитись вниз на руки, не прогинатись. Утримувати таке положення протягом 20 секунд з поворотом стегон. 10. Висока розтягнута планка.
Вихідне положення — стійка для віджимання з упором на носки та прямих і розведених в сторони ніг, руки впираються в підлогу, корпус тіла прямий. Прес напружений, дивитись вниз, не прогинатись. Утримувати таке положення протягом 20 секунд.
11. Низька бокова планка з прогином Вихідне
ню сторону стопи правої ноги, прийняти упор
ліву руку підняти догори з розкритою долонею, прогнутись, ноги прямі та зведені
положення протягом 20 секунд на кожній руці.
12. Вправа «Пловець».
Вправа призначена для укріплення (приведення в тонус) спинних м’язів, які безпосередньо відіграють роль в підтримці хребта.
Виконується на напів м’якій рівній поверхні. Вихідне положення — лежачи на спині з витягнутими вперед ріками.
Ноги тримати разом. Поперемінно одночасно підняти праву ногу — ліву руку, і навпаки,
Виконати від 3

Дозволяється згинання, розведення ніг, відхилення тіла від нерухомого положення, ривкові та махові рухи.
2. Підтягування на низькій перекладині. Вихідне положення — вис хватом зверху на низькій перекладині (не вище 1 м) на прямих руках, руки на ширині плечей, тіло випрямлене, ноги прямі, ступні ніг разом, торкаються підлоги. Згинаючи руки, підтяти тіло одним рухом до торкання підборіддям перекладини. Повністю розгинаючи руки, опуститися у вихідне положення. Виконати від 3 підходів по 10 повторень.

Дозволяється відпочивати у вихідному положенні.
Забороняється згинати тіло або ноги, торкатися землі будь-якою частиною тіла крім ступні ніг.
3. Згинання і розгинання рук в упорі лежачи.
Вправа забезпечує розвиток та укріплення м’язів верхнього плечового поясу. Має три варіанти виконання (легкий, середній, класичний), що дозволяє виконання людям з різним фізичним розвитком.
Вихідне положення — упор лежачи, руки паралельно, кисті вперед, тіло пряме, ноги разом, спираючись на носки.
Класичний варіант: згинаючи руки, опустити пряме тіло до положення проходження грудьми площини Вихідне положення — стоячи на підлозі, ноги на ширині плечей, руки опущені вниз, тримаючи бронежилет за лямки, спина пряма, дивитись прямо. Піднімати бронежилет плечима
згинаючи руки в ліктях.
Виконати від 3 підходів по 10–15
Дозволяється робити
женні.

Забороняється
будь-якою частиною тіла, розводити та підтягувати ноги.
пиняється.
4. Віджимання від підлоги з опорою ногами
лавку (стілець). Вихідне положення — упор лежачи, ноги (гомілки) на лавці (стільці) на висоті не

5.
Вихідне положення — сидячи на стільці, взятися руками за передній край сидіння, руки прямі, ноги трохи зігнуті в колінах. Винести корпус вперед так, щоб вся вага тіла припала на руки. З цього положення повільно згинаючи руки в ліктях, опустити корпус, так щоб передпліччя були паралельні
до підлоги, потім віджатися у верхнє положення. Виконати від 3 підходів
по 10–15 повторень.

Дозволяється робити зупинку для відпочинку у верхньому положенні в упорі на руках.
Забороняється торкатися підлоги, стільця (лавки) ще будь-якою частиною тіла.
6. Відведення рук в сторони.
Вправа призначена для розвитку
верхнього плечового поясу. Відведення здійснюються одночасно, вага підбирається відповідно до фізичного розвитку організму.
Вихідне положення — стоячи на підлозі, ноги на ширині
плечей, руки опущені вниз притиснуті вздовж тіла, тримаючи гантелі хватом з низу, спина пряма, дивитись прямо. Зігнути руки в ліктях, одночасно піднімаючи
підборіддя дві руки з гантелями, спина та ноги прямі, дивитись прямо, повільно розгинаючи руки прийняти вихідне положення. Виконати від 3 підходів по 15 повторень.
7. Підйом бронежилету трапецієподібними м’язами.
Вихідне положення — стоячи на підлозі, ноги на ширині
плечей, руки опущені вниз, тримаючи бронежилет за лямки, спина пряма, дивитись прямо. Піднімати бронежилет плечима не згинаючи руки в ліктях.
Виконати від 3 підходів по 12 повторень.
8. Підйом бронежилету на біцепс.
Вправа призначена для розвитку та укріплення трапецієподібних м’язів, м’язів грудей та спини. Не рекомендується до виконання
упродовж 1 – 2 секунд.
Виконати від 3 підходів по 15 повторень.
2. Класичні присідання
Вправа призначена для розвитку силових якостей стегнових м’язів. Звернути увагу на техніку виконання дій.
Вихідне положення — стоячи на підлозі, ступні ніг розташовані на ширині плечей, руки зігнуті в кулаках на грудях або витягнуті вперед паралельно землі, долонями донизу.
Присісти до відказу, при цьому п’ятки ніг від землі не відриваються, спину тримати прямо, руки постійно знаходяться в положенні на грудях або витягнутими вперед долонями донизу, піднятися у вихідне положення.
Виконати від 3 підходів по 15 повторень.

Відпочивати забороняється.
3. Закрокування на підвищення.
Вправа призначена для розвитку силових якостей литковоножних
фізіологічних можливостей організму.
підбирається відповідно
Вихідне положення — стоячи на підлозі, ступні
Поперемінно закрокувати на стілець.
Виконати від 3 підходів по 6–10 повторень.

1. Чому потрібна
собів захисту?
2. Які групи м’язів найбільше потребують відновлення
лого виконання бойових завдань
ням особистих засобів захисту?
3. Які вправи виконують для відновлення після перевантаження?
4.


Пригадайте з уроків історії, коли у світі почали використовувати стрілецьку зброю. У яких країнах? Історія розвитку стрілецької
прагнула відшукати засіб, за допомогою
вражати ціль — на полюванні або
нової ери у військовій справі: з’явилася галузь в системі озброєння
ручна вогнепальна зброя.

Вогнепальна зброя — зброя, у якій для викидання снаряда (міни, кулі) із каналу ствола використовується сила тиску газів, що утворюються під час згоряння метальної вибухової речовини (пороху) або спеціальних горючих сумішей.
Поєднує в собі засоби безпосереднього ураження (снаряд, міна, куля) і засоби метання їх до цілі (гармата, міномет, кулемет, автомат, гвинтівка, пістолет тощо).
Першу зброю зі застосуванням пороху вигадали китайці ще в VI ст., вона називалась хо-пао . Хо-пао мало вигляд куль (схожий на сучасну гранату). Щоб використати давньокитайську зброю, треба
чи з рук. Хо-пао робилося так: сірку, селітру, дерев’яні волокна, олію і миш’як
шарів грубого паперу і обмазували смолою. Хо-пао летів, фонтануючи вогнем і з гуркотом розривався, димучі обломки, виділяли отруйний дим миш’яку. У цій зброї використовувались тільки вибухові властивості пороху. Крім «хопао» існували «вогняні яструби», «вогняні колючки», «чорні дракони». Про китайські кулі дізнались у Візантії, грек Каллінік помістив

снаряд
грім арабів», який складався з глиняного горщика, наповненого порохом. «Залізний грім арабів» навів страх на європейців під час Хрестових походів. Але найдивовижніше те, що найбільше європейці боялись не вибухів, а запаху сірки, яку виділяв «Залізний грім арабів». Запах сірки за розповідями священиків XI ст. — присутність диявола.
У Європі виявились сміливці, які відкрили склад пороху. Багатьом вченим приписують звання відкривача пороху: англієць Роджер Бекон 1214—1292 р., німецький філософ Альберт Великий 1193—1280 р., монах Бертольд Шварц. Бертольда Шварца вважали першовинахідником пороху до

промисловості. З 1345—1346 років германські князівства починають виробництво бомбард (від лат. Bomba — «грім», adere — «горіти»). Розміри бомбард просто колосальні (наприклад, нідерландська «Скажена Грета» мала в довжину 5 метрів, її вага була 5 тонн. Вага ядра 325 кг, діаметр ядра 64 см). Бомбарди вражали ціль не тільки ядрами, а й звуком. За словами очевидців, від пострілу бомбарди падали коні. У битві при Кресі

, яке використовувалось до
( іл. 18.2 ),
посилені кільця біля ствола, посередині та
задній частині. Така зброя дістала назву бомбарделла («бомбардочка»). В 1364 році правителі італійського міста Перуджі наказали змайструвати 50 бомбарделл, які пробивають будь-який обладунок. Маленькі бомбарделли і пищалі були легкими і більш-менш зручними, але постріл доносив вбивчу силу кулі всього на 25-30 метрів. Вирішенням проблеми стали « аркебузи » — мушкети зі стволом 80-10 см ( іл. 18.3 ). Для стрільби з аркебузи потрібні два солдати, один клав аркебузу на плече і наводив на ціль, а другий підпалював ґнотом заряд. Наприкінці XV ст. найкращою піхотою була іспанська. Іспанія перша країна яка перейшла від простих пищалей до сучасних на той час мушкетів ( іл 18.4 ). Мушкет мав ствол 110—120 см, калібром 20-23 мм, ложу з коротким прикладом, що дозволив зручно прицілюватись і ґнотовий замок. Важив іспанський мушкет 6 кг. Мушкети стали першою масовою зброєю, а стрільці з мушкетами стали називатись мушкетерами. Мушкетер мав нести на собі важке приладдя. НайІл. 18.4. Мушкети

головніше мушкет, він був довжиною 180 см і важив 6–7 кг, крім того до нього входила підставка «фуршет» (без підставки важкий мушкет не втримати). Мушкет заряджався довго, постріли лунали рідко (мушкетер доживав до 5–6 пострілів). Також для мушкетерів вигадали спеціальне шикування — «равлик». Вперше цей стрій застосувався в 1515 році. Запальнички для рушниці існували вже 1520-х. Виглядали вони примітивно, хоча працювали сучасно, рукою крутили колесо, воно терлось об кремінь і з’являлися іскри. На сьогодні
хто перший змайстрував рушницю з механізмом запальнички. Новим знаряддям для запалення заряду в стволі (після ґнотового замка) став колісцевий замок . Майже вся операція перезарядки залишилась стара: в ствол клали порох, кулю, пиж, вминали все шомполом. Залишилась і поличка для пороху-натруски під запалювальним отвором. Тільки тепер у полички з’явилась кришка, щоб порох не здуло вітром. У колісцевому замку, як і ґнотовому, був гачок, але на ньому запалення

Іл. 18.5. Колісцевий пістоль кінця XVI ст.
дорогий.
ханізмом став в XVI ст. кременевий замок. Замок працював таким чином: рушниця чи пістолет заряджали з дула, на підставку сипали порох, гачок з кременем відводили назад (при цьому стискалася підгачкова пружина), і готово — можна робити постріл. При натиску на гачок кремінь бив по пороху і лунав постріл. Була тільки одна незручність: від натиску на гачок до пострілу проходило 1–2 секунди. Кременевий замок став одразу відомим. Більше ста років його ставили тільки на мисливські рушниці . Кожна країна мала свій власний кременевий замок, найвідоміші були: шотландські, англійські, голландські, шведські, карельські, іспанські, італійські, португальські, турецькі і російські кременеві замки. В 1605 році французький зброяр Марен Ле Буржа винайшов найнадійнішу конструкцію, названу французьким замком, який став основою вогнепальної зброї. З 1650-х років кременеві рушниці стали основною зброєю піхоти. Скорострільність залишилася старою
була гримуча ртуть. Ствол рушниці, куди помістив
рознесло на шматочки. Це було найбільшим відкриттям зброї кінця XVIII ст. Шотландський пастор А. Форсайт винайшов в 1807 році новий запалювальний механізм для рушниці, назву новий замок отримав
в народі — флаконний (через форму пристрою).
тичної
Вона з’явилась наприкінці XIX ст. Бурхливий розвиток автоматичної зброї відбувся в роки Другої світової війни; були створені пістолети-кулемети ( іл. 18.6 ) й автомати ( іл. 18.7 ).

Іл. 18.6. Пістолет-кулемет Шпагіна 1941 (ППШ-41)
Історія розвитку стрілецької

Іл. 18.6. Пістолет-кулемет Шпагіна 1941 (ППШ-41)
що принципові зміни конструкції вогнепальної зброї визначалися зміною
капсуля-детонатора.
Узявши до уваги те, що перші зразки стрілецької зброї з’явилися у XIV ст., основними етапами розвитку її можна вважати: розробку та розповсюдження ґнотового (XV ст.) замка; розробку кременевого (кінець XV ст.) замка;
винахід паперового набою (середина XVI ст.), багнета (XVII ст.);
винахід ударної сполуки та капсульного замка (початок XIX ст.);
винахід нарізної зброї (середина XIX ст.), унітарного набою з металевою
гільзою;
розробка газозаряджувальної зброї (друга пол. XIX ст.);
винахід магазинної зброї (кінець
зброя відома з кінця XIV ст. На озброєнні у козаків

18.8. Автомат «Вепр»
у 2003 році. Тоді Науково-технічний центр точного машинобудування представив скомпонований за схемою «булпап» автомат «Вепр» ( іл. 18.8 ). Його було адресовано насамперед бійцям спецназу й українським миротворцям. Через деякий час одне з українських підприємств розробило новий автомат «Малюк». Він у цілому повторює загальну концепцію «Вепра», але з деякими поліпшеннями в частині ергономіки. Автомат обладнано планкою Пікатінні, і його може бути укомплектовано різними прицільними пристосуваннями.
Однак справжня революція у виготовленні стрілецької зброї в Україні відбулася тоді, коли підприємство «Форт» придбало в Ізраїлі ліцензію на виробництво штурмової гвинтівки «Тавор», що дістала нову назву «Форт221» калібру 5,56 мм. Зброю виготовлено за схемою «булпап», і з практичного погляду вона демонструє високу купчастість і точність стрільби, відмінну функціональну надійність у надзвичайних умовах, комфорт використання та скритність. Порівняно з АК-74 «Форт-221» більш компактний, ергономічний і придатний
бойових характеристик.
Одночасно підприємство «Маяк-Зброяр»
штурмову гвинтівку MZ-15 ( іл. 18.9 ), що являє собою ліцензійну та модернізовану версію американської AR-15/M-16. Гвинтівку виконано за класичною схемою, і вона має цілий ряд переваг, серед яких — невелика маса завдяки використаним


зброї дає змогу її використовувати як із сошок, так і
рук
також
змогу здійснювати монтаж на різних транспортних засобах від мотоцикла до гвинтокрила та з допомогою планки Пікатіні використовувати будь-які тактичні засоби. На озброєні Збройних сил України з’явилися й снайперські гвинтівки українського виробництва VPR-308 та VPR-338, які не є клоном моделі снайперської зброї світових виробників, та в яких реалізовано низку нових для України конструктивних рішень. Для прикладу, у них використано планку Пікатіні двох типів (коротку й довгу), яка рухається вперед-назад. Вона дає змогу встановити широку номенклатуру обладнання, яке зазвичай використовують разом із гвинтівкою. Для зручності передбачено установлювати коліматор під 45° разом зі снайперським прицілом. Також в українських гвинтівках відповідно до сучасних вимог ергономіки встановлено пристрій
Найменування, належність
Прицільна дальність, м/ скорострільність, постр./хв.
Місткість магазина, шт.
SIG Sauer P320 (США) 0,833 9 - 17
Glock 17 (австрія) 0,62 9 50 17
Beretta M9 / Beretta 92FS (Італія) 0,95 9 50 15
QSZ-92 (CF-989) (китай) 0,76 5,8 / 9 50 20 / 15




SIG Sauer P226 (швейцарія)
Heckler & Koch USP (P8) (ФРН)
Steyr AUG A3













3. Охарактеризуйте поетапно еволюцію
4. Складіть розповідь про історичний розвиток
Україні.
5. Охарактеризуйте за таблицею та
джерелами (Інтернет, література) стрілецьке

Пригадайте, що таке
Сучасна вогнепальна зброя розподіляється на артилерійську, стрілецьку зброю та гранатомети.

Стрілецька зброя — ствольна зброя для стрільби кулями та іншими видами патронів; наймасовіша з усіх видів сучасної зброї.
Стрілецьку зброю розрізняють:
за калібром : малого (до 6,5 мм), нормального (6,5 мм – 9 мм) та великого (9 мм – 14,5 мм) калібрів;
за призначенням : бойова, пристрілювальна, учбова, спортивна, мисливська;
за компоновкою та боєприпасом : револьвери, пістолети, пістолети-кулемети, автомати, гвинтівки, карабіни, кулемети та ін.; за типом енергії для виштовхування вражаючого елемента : вогнепальна, пневматична, механічна та електрична; за шляхом використання : ручна (стрілець сам утримує зброю при стрільбі), станкова (потребує спеціального станку або установки);
за шляхом обслуговування : індивідуальна, групова;
за ступенем автоматизації : неавтоматична (у тому числі однозарядна, магазинна, барабанна), самозарядна та автоматична;
за кількістю стволів : одноствольна, двоствольна та багатоствольна; за конструкційними особливостями стволу : нарізна та гладкоствольна.
Розглянемо автоматичну стрілецькі зброю, яка на даний час





дальність, м:
стрільби, пострілів/хв: ~600
Бойова швидкострільність, пострілів/хв: – одиночними пострілами
стрільбі чергами
Початкова швидкість
Відстань, на якій зберігається убійна
Максимальна дальність польоту кулі, м
Висота лінії вогню, мм
Вага автомата (кулемета), кг – без спорядженого пластмасового магазина
зі спорядженим пластмасовим магазином
Місткість магазину, патронів
У 2012 році на озброєння ЗСУ прийнята швейцарська 7,62 мм снайперська гвинтівка BT APR308, яка є індивідуальною зброєю снайперів, та призначена для ураження живої сили противника ( іл. 19.2 ).
19. Сучасна стрілецька

Гвинтівки сімейства APR мають модульну конструкцію. Основним елементом конструкції є нижня частина ствольної коробки (з інтегроваІл. 19.2. 7,62 мм снайперська гвинтівка BT APR308
ним амбідекстерним запобіжником), до якої кріпиться решта елементів. У верхній частині ствольної коробки розташована затворна група, удар-
но-спусковий механізм, складний приклад, інше приладдя та консольно підвішений ствол.
У верхній частині ствольної коробки знаходиться ступорне кільце та рейка Пікатіні (англ. Picatinny rail) для кріплення оптичного прицілу. В рейку вбудований резервний відкритий приціл. Гвинтівки APR мають традиційний поворотний затвор з трьома радіальними бойовими упорами. Затвор потребує повороту на 60°, що має спростити швидку стрільбу. Приклад виготовлений з полімерів та прикріплений до нижньої частини ствольної коробки. Має отвори для встановлення регульованих по висоті сошок. Система живлення використовує знімний коробчатий магазин на 10 набоїв. Затвор блокується коли магазин
ється крізь нижню частину
мується скобою, що інтегрована
Таблиця 19.2. Тактико-технічні характеристики ВТ APR308
Калібр, мм: 7,62Ч51
Принцип дії: ковзний затвор, ручне перезаряджання
Вага гвинтівки без прицілу та патронів, кг: 7,01
Вага прицілу (у повному комплекті), кг: 1,235
Вага супресора, кг: 0,897
Довжина гвинтівки, мм:
приклад розкладений 1139
приклад складений 906
приклад розкладений з встановл. супресором 1330
Ширина гвинтівки, мм: 86
Довжина ствола, мм: 610
Прицільна дальність ураження, м: 1000
Збільшення штатного прицілу ВТ TRS, крат: 3..12 Ємність магазина, патронів: 10 У 2014 році озброєння ЗСУ поповнилось 9-мм пістолетами «Форт-14 ТП» і «Форт-17» та 5,45-мм штурмовою гвинтівкою «Форт-221» ( іл. 19.3 ) і її субкомпактною версією 5,45-мм пістолетом-кулеметом «Форт-224» ( іл. 19.4 ).

Іл. 19.3. 5,45-мм штурмова гвинтівка «Форт-221»

Іл. 19.4. 5,45-мм пістолет-кулемет «Форт-224»
Штурмова гвинтівка «Форт-221» калібру 5,56Ч45 та 5,45Ч39 мм – особиста автоматична зброя, призначена для ураження противника на відстані до 500 метрів виготовлена НВО «Форт» (Казенне науково-виробниче об’єднання «Форт» МВС України).
Скомпонована по схемі bullpup, що дозволило істотно зменшити габарити зброї, не зменшуючи довжину ствола.

1. Компенсатор. 2. Ствол. 3. Рукоятка зведення. 4. Мушка. 5. Передня антабка. 6. Коліматорний приціл Форт М5. 7. Цілик. 8. Планка Пікатіні. 9. Кришка вікна викидання гільз. 10. Фіксуючий штифт кришки прикладу. 11. Кришка прикладу. 12. Важіль затворної затримки. 13. Стопорні штифти ударно-спускового механізму. 14. Магазин. 15. Важіль фіксації магазина. 16. Перемикач режимів стрільби. 17. Пістолетна рукоятка з запобіжною скобою. 18. Спусковий гачок. 19. Цівка. Іл. 19.5. Будова гвинтівки «Форт-221»
Основа автоматики — відведення порохових газів з каналу ствола через прихований корпусом зброї газовідвідний вузол, що знаходиться
лом. Жорстко зафіксований на рамі
цілим із корпусом. На верхній частині корпусу розміщено уніфіковане кріплення «рейка Пікатіні».
Неповне розбирання може бути здійснено в польових умовах без використання будь-яких інструментів.
Може бути укомплектована тактичним ліхтарем, лазерним цілевказівником, оптичним прицілом з 3-х або 4-х кратним збільшенням, прибором нічного бачення.
У 2017 році пройшовши комплекс державних випробувань та дослідну експлуатацію у військах (зокрема у частинах Сил спеціальних операцій), в тому числі в умовах антитерористичній операції, на озброєння Збройних Сил України 5,45/7,62мм штурмова гвинтівка (автомат) «Малюк» була
прийнята, як спеціальний автомат «Вулкан» ( іл. 19.6 ).

Автомат «Вулкан» — це глибока модернізація автомату Калашникова за схемою булпап, що Іл. 19.6. Спеціальний автомат «Вулкан»
дозволяє значно скоротити довжину зброї, зробивши її компактнішою, та змістити центр ваги у більш зручну точку, що покращує точність вогню ( табл. 19.3 ).
Таблиця 19.3. Тактико-технічні характеристики автомат «Вулкан»
Калібр, мм: 5,45Ч38 / 7,62Ч39
Принцип дії: відведення порохових газів, поворотний затвор
Вага з порожнім магазином, кг: 3,2 / 3,3
Довжина, мм: 712
Довжина ствола, мм: 415
Місткість магазину, патронів: 30
Прицільна дальність, м: 1000 / до 1000
Початкова швидкість польоту кулі, м/с: 900 / 715
Відстань прямого пострілу по грудній мішені, м: 460 / 340
Нарізи: 4
Конструкція автомата така, що при здійсненні процедури його розбирання (складання) зі зняттям прицілу зберігається точка прицілювання. Зброю оснащено трьома рейками
У порівнянні з автоматом Калашникова у «Вулкана» значно
віддача. Ним можна керувати
з запобіжника, вести вогонь, міняти магазин і перезаряджати.

Іл. 19.7. самозарядна (напівавтоматична) гвинтівка UAR-10
На озброєння ЗСУ прийнято 7,62-мм самозарядну напівавтоматичну снайперську гвинтівку UAR-10 (іл. 19.7).
Вітчизняна снайперська гвинтівка має зручну конструкцію: може бути розібрана на дві складові частини, що дозволяє
Самозарядну напівавтоматичну
конструкції української UAR-10 є постійне з’єднання рукоятки взведения
Snipex T-REX (іл. 19.8) та 14,5-мм багатозарядна
антиматеріальна гвинтівка ручного заряджання Snipex ALLIGATOR (іл. 19.9) з унікальними тактико-технічними даними (табл. 19.4).
Гвинтівки призначені для враження рухомих і нерухомих цілей, у тому
числі легко броньованих, та сконструйовані з урахуванням усіх вимог до зброї для високоточної стрільби.

Іл. 19.8. 14,5-мм однозарядна великокаліберна антиматеріальна гвинтівка ручного заряджання Snipex T-REX

Іл. 19.9. 14,5-мм багатозарядна великокаліберна антиматеріальна гвинтівка ручного заряджання Snipex ALLIGATOR
Таблиця 19.4.
Тактико-технічні характеристики Snipex T-RЕХ та Snipex ALLIGATOR
Калібр, мм:
Принцип дії:
Вага гвинтівки з сошками, без
Snipex T-RЕХ Snipex ALLIGATOR
поздовжньо-ковзний поворотний, ручне перезаряджання
Поздовжньо-ковзний затвор із вбудованим внутрішнім запобіжником
прицілу, кг: 22,5 25
Довжина гвинтівки з ДГК, мм: 1800 2000
Довжина ствола, мм: 1200 1200
Початкова швидкість кулі, м/с: 980 980
Ефективна дальність ураження, м: до 2000 До 2000
Максимальна дальність, м: 7000
Кількість нарізів: 8 8
Твіст: 17"
Ємність магазина, патронів: 1 5 У 2016 році на
калібру
а патрони подаються зліва направо.

Іл. 19.10. Кулемет КМ-7,62 калібру 7,62Ч54 мм на тринозі Степанова

Іл. 19.11. Кулемет КТ-7,62 калібру 7,62Ч54 мм
К улемет КТ-7,62 калібру 7,62Ч54 мм — кулемет танковий, призначений встановлення на бронеоб’єкти, в якості допоміжного озброєння танків, на авіаційну та іншу військову техніку ( іл. 19.11 ). Аналог радянського ПКТ, але конструктори встановили на ствольній коробці
м’яка коробка для патронів, яка
відпрацювання цю
ки знову використовувати. Замість спускового гачка в КТ-7,62 є
спускова установка — електроспуск, яка активізується
наведення знаряддя, що знаходиться на танку або БМП. Також блок наведення може розташовуватися на рукоятці повороту
мобіля. Сам електроспуск з’єднаний
за допомогою спеціального кабелю (довжина — 50 см). На випадок поломки електроспуску, була передбачена і ручна система відкриття вогню. Для цього використовується механічний спуск, який розташований на задній частині коробки. Таблиця 19.5 Тактико-технічні характеристики КМ-7,62 і КТ-7,62
Модифікаці: КМ КТ Калібр, мм: 7,62Ч54 Rimmed Принцип дії: Відвід
Живлення: стрічка на 100, 200, 250 набоїв Початкова швидкість польоту кулі, м/с: 825 855
Прицільна дальність, м: 1500 2000 Кут прицілу: –10°/+20°
Скорострільність, пострілів/хв.: 650 800 Нарізи: 4
Корок нарізів, мм: 240 У ЗСУ також застосовують стрілецьке озброєння іноземного виробництва. Наведемо деякі з них.
1. Гвинтівка M16 (іл. 19.12) / карабін M4 (іл. 19.13) — це зброя калібру 5,56 мм з газовідвідною автоматикою та повітряним охолодженням ствола, яка може вести вогонь в автоматичному (чергами) та в напівавтоматичному (одиночними пострілами) режимах, що визначається положенням перемикача режиму вогню. Основною відмінністю карабіну М4 від гвинтівки М16 є менша довжина ствола та наявність телескопічного прикладу. З часом вносились зміни у гвинтівку М16 і в неї з’являвся додатковий індекс А1, А2, А3, А4 (М16A1, М16А2 ...) івідповідно карабін М4, який виготовлявся на базі зміненої гвинтівки М16 мав аналогічний індекс (М4А1, М4А2 ...) при збереженні принципових відмінностей
кою і карабіном. Інші відмінності


що застосовується М-193 М-193 М-855 М-193, М-855
Маса з магазином без
ствола, мм
143 § 19. Сучасна стрілецька
мм (приклад розсунутий); 757 мм (приклад складений)
Розділ 4. Вогнева підготовка
Одиночними пострілами 30-40 30-40 35-45 35-45
Чергами 50-70 50-70 60-80 70-90
Ємність магазину, патронів 18, 28, 40 18, 28, 40 18, 28,40, 45 8, 28, 40, 45
Основні частини, з яких складаються гвинтівки М16А1 та М16А2, наведені на іл. 19.14 .


Іл. 19.14. Основні частини гвинтівок М16А1 та М16А2: 1. Ствол зі ствольною коробкою. 2. Спускова коробка з прикладом та рукояткою. 3. Затвор у зборі. 4. Буфер противовідскоку зі зворотною пружиною. 5. Планка перезаряджання. 6. Накладки цівки (у М16А1 — ліва та права, у М16А2 обидві накладки однакові). 7. Магазин.
Автоматика зброї працює за рахунок відведення
налу ствола. Замикання ствола
перезаряджання зброї. При русі затворної рами назад зводиться курок. Нове натискання на спусковий гачок призводить до пострілу. Режим автоматичної стрільби досягається за рахунок того, що після замикання затвора рама затвора
2. Стандартний (базовий) карабін 5,56 мм у версії А2 є модульною автоматичною індивідуальною зброєю, призначеною для
144
одночасною
її положення. Завдяки цьому користувач може налаштувати ергономіку карабіна відповідно до поточних вимог, що випливають з персонального спорядження та характеру виконуваного завдання, наприклад, при використанні протигаза. Модульна конструкція також дозволяє легко та швидко змінювати напрямок викидання гільз. Іл. 19.15. Загальний вигляд карабіна А2

Карабін використовує патрони 5,56Ч45 мм НАТО та їх національні аналоги. Заряджання карабіна здійснюється патронами з секторних і коробчастих магазинів. Крім того, карабін коректно працює з більшістю магазинів, призначених для гвинтівок системи M16 (AR-15). Стрільба ведеться одиночним вогнем, короткими чергами (2-3 постріли) і безперервним вогнем.
Ефективна дальність стрільби карабіна по одиночним цілям — 500 м. Дальність прицілювання залежить від використовуваних прицілів, а
відстань дійсного пострілу по грудній фігури становить близько 400 м.
Початкова швидкість кулі близько 890 м/с.
Теоретична скорострільність гвинтівки становить приблизно 700-900
постр/хв, а практична скорострільність:
безперервний вогонь — до 100 постр/хв; одиночний вогонь — до 40 постр/хв.
Особливістю конструкції карабіна є повна адаптація зброї до використання стрільцями-правшами та лівшами. Усі маніпулятори (важіль вимикача — запобіжника, фіксатор затвора, засувка магазина та рукоятка натягувача) розміщені з обох боків.
Карабін складається з таких основних модулів (іл. 19.16):
1. Телескопічний приклад.
2. Механічний прицільний пристрій.
3. Ствольна коробка.
4. Ствол.
5. Гальмівно-зворотний механізм.
6. Коробка спускового механізму.
7. Магазин.
8. Затворна рама із затвором.
9. Видовжене ців’я з накладкою.
3. Пістолет-кулемет UZI — це легка зброя з повітряним охолодженням ствола, яка може стріляти

Іл. 19.17. Основні частини пістолета-кулемета UZI. Іл. 19.16. Основні модулі карабіна А2.

Характеристика Значення характеристики
Пістолет-кулемет з металевим прикладом 3,5 кг
з дерев'яним прикладом 3,6 кг
Магазин, 25 патронів, порожній 200 г
Магазин, 25 патронів, заряджений
Магазин, 32 патрона, порожній
Магазин, 32 патрона, заряджений
Габаритний, металевий або дерев'яний приклад
З металевим прикладом у складеному вигляді
500 г
220 г
600 г
650 мм
470 мм
Ствол 260 мм
Спосіб роботи Віддача вільного затвору
Тип затворного механізму Блок затвору
Спосіб подачі Магазин
Охолодження Повітря
Калібр 9Ч19 мм Парабелум
Початкова швидкість, прибл. 410 м/сек
Швидкість стрільби 600 пост/хв
Радіус лінії прицілу 309 мм 4. Легка автоматична гвинтівка FN, калібр 7,62 мм НАТО ( табл. 19.8 )
зазвичай відома як «FAL» або «LAR», стала результатом тривалих досліджень і конкурсних випробувань, проведених
в будьяких кліматичних умовах.
Ця гвинтівка була прийнята на озброєння багатьма
дині, так

§ 20. Прийоми та правила стрільби
Магазин на 20 патронів Прицільне пристосування регульований, приціл з градуюванням від 200-600 м, масштабування на 100 м Скорострільність 650–700 п/хв Бойова скорострільність, напівавтоматична до 60 п/хв
5. Українські Збройні сили використовують на фронті канадські гвинтівки « Diemaco C7A1 », яка конструктивно та функціонально аналогічна американській штурмовій гвинтівці «Colt М16А1Е1».
Гвинтівка у версії «С7А1» має на верхній поверхні ствольної коробки замість класичної ручки для перенесення універсальні напрямні типу Пікатіні (нової розробки) для
кріплення прицільних пристроїв, аналогічно американській гвинтівці М16А3. У війська «С7А1» поставляється з оптичним прицілом Elcan. Оптичний приціл було розроблено для легкого кулемета C9 та має горизонтальні й вертикальні міліметрові риски, які використовують для визначення відстані та відхилення, а також мав тритієву прицільну стійку з підсвіткою замість звичайного перехрестя.

1. Як класифікують стрілецьку зброю?

Іл. 19.18. Гвинтівки C7, C7A1 та C7A2
2. Яка автоматична стрілецька зброю на даний час перебуває
3. Яку стрілецьку зброю іноземного виробництва використовують


змінюються під впливом
умов стрільби. Саме це забезпечує високу ефективність вогню, особливо зосередженого. На відстані до 400 м для автоматів і до 800 м для кулеметів забезпечується для таких цілей, як кулемет, ростова фігура, надійність стрільби, близька до 90%, за витрат — 15–25 патронів. Така дієвість вогню сучасної
з одного боку, і короткочасність
вимагають

часу (0,001–0,06 с). Під час пострілу виокремлюють
перший, або основний;
другий;
третій, або період післядії газів. Р0 — тиск газів унаслідок згорання порохового (бойого) заряду; Рм — максимальний тиск газів в закульовому просторі на початку першого періоду; Рк — тиск газів на початку другого періоду; Рд — тиск газів у закульовому просторі на дуловому зрізі; Ратм

нагрівається ствол
кулею, взаємодіючи
утворюють полум’я й ударну хвилю, які спричиняють звук пострілу.
Під час пострілу з автоматичної зброї, який використовує енергію віддачі, тиск газів через дно гільзи передається на деталі затвора і спричиняє його рух зі стріляною гільзою назад. Тиск газів на дно гільзи пересилює інерцію затвора та пружність зворотно-бойової пружини. Куля вже до цього часу вилітає з каналу ствола. Відходячи назад, затвор стискає зворотно-бойову пружину. Потім, завдяки енергії пружини, затвор рухається вперед і досилає наступний набій магазина в набійник.

Початковою швидкістю кулі називають швидкість, із якою куля залишає канал ствола, тобто швидкість руху кулі поблизу точки вильоту.
Початкова швидкість — це умовна
при однакових
рів: а) маса кулі;



звернувши особливу увагу на низини, канави, борозни та інші укриття, що їх супротивник може використати для непомітного наближення. У населеному пункті місце для стрільби може бути обране у вікні будівлі, на горищі, біля фундаменту споруди тощо ( іл. 20.2 ). Стрільба з автомата складається з виконання таких прийомів: а) прийняття положення для стрільби, заряджання зброї; б) виконання пострілу (прицілювання й виконання спуску); в) припинення стрільби (припинення натискування на хвіст спускового гачка, установлення перевідника в запобіжне положення, розряджання автомата). Для заряджання автомата потрібно: а)
г) енергійно відвести
магазин.
Виконання стрільби передбачає встановлення
відника на необхідний вид вогню,



Якщо припустити, що стрільбу з автомата, зазвичай, ведуть на невеликих відстанях у межах дальності прямого пострілу, то кожен стрілець має вміти ставити приціл 3 (4) або «П». Приціл на поділку 3 (4) встановлюється за звуками клацання, а на «П» — відтягуванням хомутика назад до упору. Для установки зброї на необхідний вид вогню, потрібно, натискаючи великим пальцем правої руки на виступ перевідника, повернути перемикач униз: до першого клацання — для ведення автоматичного вогню (АВ), до другого клацання — для ведення одиночного вогню (ОД) ( іл. 20.5. а, б ). Розглянемо найбільш зручний порядок прийняття положення для стрільби лежачи з автоматом модифікацій АК по елементам:
1) якщо автомат в положенні «на ремінь», подати праву руку по ременю дещо вгору та, знімаючи автомат з плеча, підхопити його лівію рукою за ствольну накладку і цівку (у автомата із складаним прикладом відкинути приклад);
2) якщо автомат у положенні «на грудях» дульною частиною догори, взяти лівою рукою автомат знизу за цівку та ствольну накладку і, піднімаючи його дещо вперед і вгору, вивести
перекинути ремінь
та ствольну накладку і, піднімаючи його дещо вперед
накладку і, піднімаючи його дещо вперед і вгору, взяти правою

місці або після пересування (якщо противник попереду) — вибрати будь-яке укриття (ямка, вибоїна, пень, камінь, кущ, дерево), зробити неширокий крок в вперед сторону «недомінантною» ногою (ліворуч — для правши, праворуч — для шульги) для прийняття більш стійкого положення та присісти на обидві ноги, поставити «недомінантну» руку на землю попереду себе, кистю «домінантної» руки
спостерігаючи за полем бою; розкинути злегка
утримувати «недомінантною» рукою за магазин чи за передню рукоятку). Положення лежачи можливо приймати на животі,
животі ( іл. 20.6

положення для стрільби
переміщення в сторону (відповзти в бік), що унеможливить
прицільного вогню противником. Крім того, при прийнятті положення для стрільби зі зброєю з оптичними (тепловізійними, коліматорними тощо) прицілами з них за наявності чохол та з об’єктивів резинові ковпачки (заглушки). Для прийняття положення лежачи на лівому боці (варіант для правши), той, кого навчають, впирає зброю прикладом у плече ( іл. 20.7. а ). Ліва рука
від плеча до ліктя спирається на поверхню землі, кисть тримає цівку (передню рукоятку або за магазин; магазин і ствольну коробку автомата). В такому положенні прицільні пристрої повернуті на 90° по відношенню до класичного положення – на животі. Стрільба з такого положення на великі відстані неефективна через необхідність врахування спеціальної поправки, яку в умовах ближнього бою доцільно не враховувати.
Ноги стрільця залишаються так, як і в положенні лежачи на животі, але розгортаються у відповідну сторону та торкаються поверхні землі: верхня нога — внутрішнім ребром стопи, а нижня нога — зовнішнім.
Таке положення забезпечує швидке та ефективне перенесення вогню. Для перенесення вогню на незначні кути досить зміни положення передпліччя руки, що утримує цівку автомату. Якщо потрібно перенесення вогню під великим кутом, стрілок переміщує всю руку, міняючи кут поверхні опори руки.
Для прийняття положення лежачи на правому боці (варіант для правши), той, кого навчають, «недомінантною» рукою тримає зброю за цівку (передню рукоятку або за магазин; магазин і ствольну коробку автомату), регулюючи положенням руки і вигином ліктя напрямок зброї на ціль. Права рука тримає пістолетну рукоятку
При такому положенні
і
на спину, одночасно розвівши ноги в сторони.

Іл. 20.7. Варіанти положення для стрільби лежачи на правому (лівому) боці та спині: а) положення для стрільби лежачи на лівому боці; б) положення для стрільби лежачи направому боці; в) положення для стрільби лежачи на спині. Плечі мають бути підняті, голова нахиляється до правого (лівого) плеча «домінантної» руки так, щоб око, прицільні пристрої та ціль опинилися на одній лінії. Кисть «домінантної» руки тримає
рукоятку. «Недомінантна» рука від плеча до ліктя служить додатковою опорою, опираючись на бронежилет. Кисть «недомінантної» руки продовжує підтримувати автомат за цівку (передню рукоятку або за магазин; магазин і ствольну коробку автомату).
(траєкторії польоту кулі). П’яти ніг (або зовнішніми боками стопи чи одна з ніг зовнішньою, а інша внутрішньою боками) торкаються поверхні землі. Перенесення вогню в даному положенні можливе лише на незначні кути. При стрільбі з

правильною постановкою ніг і розташуванням рук. Іл.

назад, наприклад у будівлі, положення для стрільби з коліна може прийматися одночасним присіданням на обох ногах, зброя при цьому тримається як при стрільбі стоячи (без опори на коліно) ( іл. 20.8.б ). За таких умов лікоть «недомінантної» руки не впирається в м’язи коліна опорної ноги. За наявності укриття стрілець може обходитися без упору сідничних м’язів на п’яту ноги, випрямляючи задню ногу на рівні тазу. З такого положення значно збільшується можливість маневру вогнем, зміни положень для стрільби та зміни вогневої позиції (переходу за інше укриття). Не менш ефективним способом прийняття положення для стрільби з
коліна є одночасне присідання на правій нозі для правші (лівій нозі для шульги) з виносом лівої ноги (правої для шульги) вперед, причому лікоть
лівої руки для правші (правої для шульги) має впиратися у м’язи стегна трохи вище колінного суглобу для забезпечення рівноваги та стабільності під час прицілювання і стрільби ( іл. 20.8.в ). Лікоть «домінантної» руки не повинен підніматися на рівні плеча. Для забезпечення стабільності та рівноваги під час стрільби, сідничні м’язи мають впиратися на п’яту ноги. Однак, в разі прийняття такого
твердому покритті (асфальті тощо) без наколінників,
колінного суглобу.
Якщо виникає необхідність зміни
певної
приклад
положення для стрільби з коліна ( іл. 20.8. д ). При необхідності впсти стрільбу стоячи, стрілець
приймає фронтальну стійку («недомінантна» нога при цьому для зручності може злегка подаватися вперед і в бік) до напрямку стрільби. При цьому ледь згинає ноги в колінах, жорстко фіксуючи м’язами тазостегнових суглобів для забезпечення стійкого положення (іл. 20.9), тулуб при цьому трохи подається вперед. «Недомінантною» рукою зброя підтримується за цівку (передню рукоятку або за магазин; магазин і ствольну коробку автомату), а

незвичним, але досить зручним, забезпечуючи
вагою всього тіла. В будь-якому випадку, стрілець,
бисті антропометричні дані (зріст, довжину рук), можливість регулювання довжини прикладу зброї, має сам визначити для себе ту індивідуальну прикладку, яка буде для нього зручна
русі не зволікати з моментом відкриття
збігається з ціллю. Стрільбу ведуть постійно, уточнюючи приціл. Точку прицілювання вибирають на рівні нижнього обрізу цілі: це дає змогу використовувати для ураження цілі рикошет. Лінія прицілювання Прицілювання — це надання каналу ствола напрямку, необхідного

прорізу прицілу (цілика), мушки та точки прицілювання
(тир, стрільбище,
вість, поле бою).
У процесі прицілювання, як правило, бере участь одне
відне око — праве. Початкове
і менш чітке, розмите бачення мішені та місця (точки) прицілювання.
Основне завдання під час прицілювання — контроль за чіткістю бачення мушки і прорізу цілика. Відсутність контролю за чіткістю бачення прицільних пристроїв — одна з основних помилок під час прицілювання. Навичка втримання потрібної чіткості прицільних пристроїв має таке ж важливе значення, як і навичка втримання рівної мушки.
Прицілюючись, потрібно стежити за тим, щоб гривка прицільної планки займала горизонтальне положення. Утримання мушки рівною, чіткою в точці прицілювання повинне мати активний характер. Стрілець не має чекати настання моменту найкращої стійкості зброї, він зобов’язаний активно шукати способи поєднання прицільних пристосувань зброї, а також їх поєднання з точкою прицілювання. На влучність стрільби істотно впливає дихання стрільця. Якщо не затримати дихання під час спуску курка, зброя матиме значне коливання за вертикаллю та горизонталлю, бо приклад під час видиху опускається, а ствол піднімається, а під час вдиху — навпаки. Щоб цього не відбувалося, необхідно в момент прицілювання і спуску курка затримати дихання. Перед спуском курка треба зробити вдих, а потім неповний видих і затримати дихання на 7–10 с. Цього часу цілком достатньо, щоб правильно прицілитися і зробити плавний спуск



прицілювання, збільшує точність, що важливо для стрільби на довгі дистанції. Встановлюються на гвинтівку
пильну площину «Ластівчин хвіст» або планку Пікатіні (Вівера).
Оптичний приціл представляє собою оптичну трубу, в якій у металевому корпусі знаходяться три системи лінз – об’єктив, окуляр та обертаюча система. У фокальній площині розміщена прицільна сітка (марка) ( іл. 20.12 ).
Зазвичай такі приціли мають кратність

Іл. 20.12. Оптичний пристрій в
розрізі: 1 — окуляр; 2 — обертаюча система; 3 — сітка (фокальна площина); 4 — об’єктив

розвитком зброї українського виробництва, на озброєння МВС України в 2009 році прийнято снайперську гвинтівку калібру 7,62Ч51 мм «Форт301» з відкритим прицілом та штатним оптичним прицілом «Nimrod». Оптичний приціл Nimrod — прицільний
спрощує дефекти зору; зручність і швидкість наведення;можливість ведення
вогню в умовах обмеженої видимості; проста і надійна конструкція; можливість зробити постріл за допомогою відкритого прицілу; можливість ремонту в польових умовах; можливість використовувати при будь-яких погодних умовах та температурах
вкрай важко вести вогонь на ближні відстані, особливо по рухомим цілям через невеликий кут огляду; збільшення ваги і габаритів зброї; нестійкий до ударів та механічних пошкоджень збільшення кратності провокує напрацювання помилок стрільця.
Оскільки цілик, мушка та ціль знаходяться на різних відстанях, при стрільбі потрібно постійно
джувати увагу на правильному фокусуванні зору. Прицілювання через відкритий

Замість прицільної планки та мушки
лінза з яскравою світловою точкою,
система в ньому використовується. Прихований всередині корпусу
випромінює світло в сторону лінзи, на внутрішню поверхню якої нанесене напівпрозоре рефлекторне покриття. Промені світла, відбиваючись від поверхні лінзи в сторону спостерігача, утворюють паралельний потік світла. Саме завдяки паралельності променів зміщення зіниці щодо оптичної осі прицілу не призводить до зміщення
точки прицілювання ( іл. 20.15 ).
Прицілювання може здійснюватися як одним, так і двома

ближньому бою.

Іл. 20.16. Поєднання коліматора (ліворуч та магніфікатора (праворуч) на одній Пікатіні
що важливо
Для стрільби на більші відстані до коліматора можна встановити магніфікатор – це зручний оптичний приціл невеликої кратності, який встановлюється перед коліматором (іл. 20.16).
Звісно, така конструкція не зрівняється з повноцінним оптичним прицілом, проте дозволить вести прицільну стрільбу
дистанції. На відміну від інших оптичний пристроїв, коліматори не оснащені механізмом
коліматори не схильні до цього оптичного явища,
вимоги, а саме: збільшена міцність конструкції,
універсальність елементів живлення, що пов’язано з неможливістю
батарейок; спеціальна сітка прицілювання, що оснащується
швидкість вітру і специфічними мітками;
захист від вологи;
балістичні налаштування


1.
2.

3.
4. Створіть варіант алгоритму одноманітного прицілювання зброї.
5. До яких наслідків зі станом здоров’я призведе посилений розгляд дрібних деталей (мушки й прорізу прицілу)?

6. Обміркуйте, з якою метою після доповіді стрільця: «Такий-то / така-то (звання, прізвище) до


бути нульові установки. Поміркуйте,
приладів нічного бачення ( іл. 21.1. а, б, в ), інших технічних засобів освітлення місцевості або підслуховуванням.






Вбивання кілків (стук молотка)
Крик людини, падіння дерев
Стукіт весел об борт човна, рух
з автомата
Гудок автомобіля, стрільба з великокаліберного кулемета
Стрільба гармати

м
м
м
м Спостерігачам на замітку: демаскувальні
середньої дії ( іл. 21.5 ). БПЛА визначають координати цілі, їх супроводжують та передають дані в режимі он-лайн по захищеному каналі управління, здійснюючи зліт та посадку на непідготовлену поверхню.

Іл. 21.4. БПЛА ближньої дії

21.5. БПЛА середньої дії Вибір цілі для обстрілу на полі бою Автоматник у бою має вибирати найважливіші цілі. Характерними для стрілецької зброї є живі цілі — обслуги вогневих засобів, групи стрільців супротивника чи окремі фігури, що ведуть вогонь із різних положень. Усі цілі в бою рідко залишаються нерухомими, тому стрільбу по живих цілях доводиться частіше вважати стрільбою по цілях, що з’являються, причому такими, що з’являються, як правило, на дуже нетривалий час — декілька десятків секунд і менше. Вони з’являються в різних місцях, здійснюють перебігання, переповзання, переходи. Окрім живих цілей, рухомими цілями для стрілецької зброї є автомобілі, мотоцикли, бронетранспортери та інші рухомі засоби.
Ціллю, вважають фігуру людини завширшки 0,5 м; заввишки — 1,5 м («ростова»), 0,5 м (така, що залягла), 0,3 м (така, що в окопі) тощо.
Загальноприйняті середні швидкості руху цілей: швидкість піхоти, що біжить — 3 м/с, швидкість автомобіля — 8–10 м/с.
Передусім необхідно вражати найнебезпечніші, важливі цілі, наприклад, обслугу кулеметів і гармат, командирів і спостерігачів супротивника. Із двох однаково важливих цілей
й найбільш уразливу.
Розділ 4. Вогнева підготовка із центром кола за допомогою радіусів, одержимо 6000 рівних центральних кутів ( іл. 21.6 ).

Іл. 21.6. Утворення поділок кутоміра (тисячної)

Іл. 21.7. Тисяча
З геометрії відомо, що довжина кола дорівнює 2 П R або 6,28 R (R — радіус кола). Оскільки ми коло поділили на 6000 рівних частин, тоді дугу АС ( іл. 21.7 ) можна виразити так: АВ або 0-01 — ( одна тисячна ) = 6,8 R/1000.
Спростимо цю формулу, поділивши на 6,28. Дістанемо
R/955 для зручності розрахунків, оскільки дальність стрільби у стрілецької зброї невелика, заокруглюємо до R/1000, де R приймається як відстань до предмета, за яким спостерігають.
Отже, поділкою кутоміра (АВ), або тисячною називається центральний кут, дуга якого дорівнює 1/6000 кола, або 1/1000 радіуса (дальності).
Поділка кутоміра (тисячна) дозволяє легко переходити від кутових величин до лінійних розмірів і навпаки, бо довжина дуги відповідає поділці кутоміра на всіх дальностях і складає R/1000 (дальності).

Іл. 21.8. Частина кола
Отож куту в 0-01 (одна тисячна) на дальності 1000 м відповідає дуга — 1 м (1000 : 1000), на дальності 500 м — 0,5 м (500 : 1000), на дальності 2000 м — 2 м (2000 : 1000) ( іл. 21.8 ).
При читанні величин кутів у поділках кутоміра сотні ділень промовляють
164
Отримані формули звуться формулами
застосування в стрілецькій практиці. У цих формулах: Д — (R — радіус кола) — відстань до предмета в метрах; У — кут, під яким видно предмет у тисячних, чи кутова величина між точками в поділках кутоміра.
Наприклад, 0-17, у формулу підставляється 17; 1-25 — ця формула записується 125; В — висота (ширина, довжина) предмета, тобто довжина хорди (дуги) АС.
Для запам’ятовування формул можна користуватися таким способом, записаним у два рядки: (д Ч у)/(В × 1000).

За умови завчасної підготовки можна і треба застосовувати найточніший спосіб — промірювання відстаней кроками або за спідометром автомобіля.
Розгляньмо спосіб за допомогою прицільних
розділів.
значення
ни мушки, можна
ширини (грудної фігури) людини (0,5 м), тоді мушка перекриває 1 м по фронту ( іл. 21.9 ). У цьому разі відстань до цілі становить
У такому випадку стрільбу на відстань до 400 м
потрібно вести, як правило, з прицілом «4» або «П», цілячись у нижній край цілі або в центр її, якщо ціль висока (рухома фігура). Під час

Криюча величина мушки
стрільби на відстані, які більші ніж 400 м, приціл встановлюють, беручи до уваги відстань до цілі, заокруглену до цілих сотень метрів. За точку прицілювання, як правило, вибирають центр цілі.
Спостереження за результатами
трасами куль і за поводженням супротивника.
Корегування вогню здійснюють, змінюючи положення точки прицілювання по висоті й бічному напрямку або змінюючи
на величину відхилення рикошетів або трас, у протилежний бік відхиленню їх
цілі. Якщо відхилення куль від цілі за дальністю перевищує 100 м, то необхідно змінити установку прицілу на одну поділку. Корегуючи вогонь за трасами, стрільбу ведуть патронами зі звичайними й трасуючими кулями у такому співвідношенні: на три патрони зі звичайними кулями один патрон із трасуючою кулею, першим має бути патрон із трасуючою кулею. Ознаками, які вказують на ефективність вогню, можуть бути:
супротивника;
переповзань; розчленовування й розгортання колони; ослаблення
ка; відхід його або
на верхньому краю цілі. Для ураження супротивника
для стрільби є такі величини поправок: а) для середніх умов стрільби за помірного вітру швидкістю 4 м/с, що дме під кутом 90° до площини стрільби; б) для швидкості цілі 3 м/с по біжучих механізованих мішенях. Запам’ятати значення табличних поправок на всі дальності
на полі бою швидкість і напрямок вітру, як і швидкість
Стріляючи по цілі, що рухається на стрільця, — фронтальний рух ( іл. 21.10 ), на відстані, яка не перевищує дальність прямого пострілу, вогонь ведуть без випередження, з прицілом, що відповідає відстані до цілі, на максимальній відстані — з прицілом, який відповідає тій відстані.

Іл. 21.10. Стрільба по фронтально-рухомій цілі

Іл. 21.11. Стрільба по рухомій цілі за умови флангового руху

Іл. 21.12. Стрільба по рухомій цілі за умови, що ціль рухається під кутом
Стріляючи по рухомих цілях під час флангового руху ( іл. 21.11 ), (швидкість 3 м/с) на всі дальності «випередження дорівнює прицілу», тобто: (Випр.
відповідно дальності до цілі. Потрібно пам’ятати, що подвійна
вертикальна лінія
зору прицілу при визначенні випередження має виноситися
Вогонь по цілях, які
стрільби ( іл. 21.12 ), ведеться способом супроводу цілі
Ведучи вогонь способом
супроводу зброєю цілі, солдат, переміщаючи зброю убік руху цілі, у момент найточнішого наведення зброї з урахуванням поправки відкриває вогонь по цілі ( іл. 21.13 ). Величина випередження залежить від швидкостей руху мішені та польоту кулі. Під час
стрільби із супроводом зброєю цілі та винесенням точки прицілювання попереду мішені
способом вичікування цілі.

Іл. 21.13. Ведення вогню способом


1.
2.
3.

4. Охарактеризуйте методику стрільби на ураження по цілях, які рухаються.
5.
томета / снайпер. Яку з названих цілей

6.


є основним видом вогню; він ведеться короткими (до 5 пострілів)
і безперервно. Подавання набоїв при стрільбі здійснюється
Будова автомата та його чищення Автомат
наступних основних частин і механізмів: ствола із ствольною коробкою, прицільним пристроєм, прикладом і пістолетною рукояткою; кришки ствольної коробки; затворної рами з газовим поршнем;
затвору;
зворотнього механізму;
газової трубки із ствольною накладкою; ударно-спускового механізму; цівки;
магазину.
Крім того, у автомату є дульне гальмо-компенсатор і багнет.
Основні частини і механізми, з яких складається автомат АК-74, зображено на іл. 22.2 .

і пістолетною рукояткою; 2 — ствол; 3 — дульне гальмо-ком-

чи немає на зовнішніх частинах іржі, бруду, а також вм’ятин, подряпин, забоїн та інших пошкоджень, які можуть викликати порушення нормальної роботи механізмів; чи немає на дерев’яних (пластмасових) частинах тріщин, відколів і побитостей; чи надійне кріплення шомпола; стан змащення на видимих без розбирання автомату частинах, наявність ременя, а у автомату зі складним прикладом і наявність чохла. При огляді автомату перед заступанням в наряд, перед виходом на заняття і в бойовій обстановці перевіряється те ж, що і при щоденному огляді; крім того, а також справність прицілу і мушки, відсутність у каналі ствола сторонніх предметів, правильність роботи частин і механізмів. При перевірці справності прицілу і мушки переконатися, що: проріз на прицільній планці (на цілику) не має забоїн; хомутик плавно переміщається по прицільній планці й надійно закріплений у встановленому положенні засувкою; пружина надійно утримує прицільну планку; мушка не погнута; риска на полозку
утримується
мушки; цілик вільно переміщається
(АВ), відвести затворну раму за рукоятку назад до упору
рама повинна енергійно
притримуючи
чутне клацання — удар курка по ударнику; поставити перемикач на одиночний вогонь (ОД), натиснути на спусковий гачок, відтягнути затворну раму назад до упору й, не відпускаючи спускового гачка, відпустити затворну раму; відпустити спусковий гачок, при цьому повиннне бути чутне клацання — курок, що вийшов із зачеплення з шепталом
не виступає капсуль вище
дна гільзи, чи немає серед бойових патронів учбових або холостих; спорядити магазин набоями. Набої, у яких виявлено випадання кулі або її ворушіння в гільзі; є вм’ятини, забоїни на кулі та гільзі, уражені корозією фланець гільзи, капсуль або кільцева канавка під викидач, до застосування не придатні. Не можна також використовувати і набої з тріщинами на дульці, корпусі або фланці гільз, так як при заряджанні не виключений випадковий постріл.
Після огляду зброї і набоїв можна приступити до заряджання.

При огляді автомату під час чищення перевірити кожну частину й механізм окремо та перевірити прицільні частини, наявність забоїн, пошкодженостей, іржі та бруду, а на дерев’яних (пластмасових) частинах — тріщин і побитостей. Особливу увагу слід звертати на стан каналу ствола, газової камери та газового поршню.
При огляді приналежності перевірити наявність та справність
метів приладдя.
Для перевірки шомпола, протирки
тирок та
бічний отвір пеналу не повинна проходити головка шомпола. У маслянці не повинно бути тріщин і сколів. Кришка маслянки повинна мати прокладку й щільно навертатися на горловину маслянки. З маслянки не повинне протікати мастило. У викрутки не повинно бути скрошеностей та забоїн на лезі й на стінках вирізів. Виколотка не повинна бути погнута. У планці і перехіднику не повинно бути тріщин, побитостей і вм’ятин. Автомат має бути чистим, справним

Для чищення і змащення зброї використовуються:
рідке рушничне мастило — для чищення зброї і змащення його частин та механізмів за температури повітря
в межах від +5°С до –50°С;
рушничне мастило — для змащення каналу ствола, частин та механізмів

після їх чищення за температури повітря вище +5°С; Іл. 22.3. Приладдя для чищення автомата АК-74
розчин для чищення стволів (РЧС) — для чищення каналів столів та
інших частин зброї, на які діяли порохові гази. Можливі
резарядженням, для чого
Затвор у передньому
положенні, але постріл не здійснено — у патроннику немає патрона
Патрон кулею уткнувся в казенний зріз ствола, рухомі
1. Забруднення чи несправність магазина. 2. Несправність защіпки магазина.
Перезарядити автомат і продовжувати стрільбу. При повторенні затримки замінити магазин. При несправній защіпці магазина відправити автомат до ремонтної майстерні Утикання патрона
частини зупинилися у середньому положенні Несправність магазина. Утримуючи ручку затворної рами, вийняти патрон, що уткнувся, і продовжити стрільбу. При повторній затримці замінити магазин
Затвор у передньому положенні, патрон у
патроннику, курок спущений — постріл не відбувся
Осічка
1. Несправність патрона.
2. Несправність ударника або ударно-спускового механізму; забруднення чи застигання мастила (відсутній або малий накол бойка на капсулі).
3. Заклинювання ударника у затворі
Перезарядити зброю і продовжити стрільбу
При повторенні затримки оглянути і почистити ударник і ударно-спусковий механізм; при поломці чи зносі ударно-спускового механізму автомат відправити до ремонтної майстерні. Від’єднати ударник від затвора і прочистити отвір у затворі під ударником
Гільзу не викинуто із ствольної коробки, вона залишилась в ній попереду затвора або дослана затвором назад у патронник
1. Забруднення частин, що труться, газових шляхів або патронника 2. Забруднення чи несправність викидача
Відвести ручку затворної рами назад, викинути гільзу і продовжити стрільбу. При повторенні затримки почистити газові шляхи, частини, що труться, і патронник; частини, що труться, змастити.
За несправністю викидача автомат відправити до ремонтної майстерні
Недохід затворної рами у переднє положення
Затворна рама зупинилася в одному із середніх положень

Зламана зворотна пружина Замінити пружину (у бойовій обстановці передню частину пружини повернути заправленим кінцем назад і продовжувати стрільбу)
Правила безпечного поводження зі зброєю
1. Отримавши зброю, перевірте, чи не заряджена вона.
2. Не спрямовуйте ствол убік людей, не цільтеся в інших і не допускайте, щоб цілилися у вас.
3. Зброю вважайте зарядженою, доки самі не перевірите і не розрядите її.
4. Розрядивши зброю, поводьтеся з нею як із зарядженою.
5. Звівши курок, ствол зброї спрямовуйте лише в напрямку цілі чи вгору під кутом 45–60° у безпечному напрямку (не спрямовуйте ствол на поверхні, які можуть спричинити рикошет, наприклад бетонна підлога, стеля, стіни тощо).
6. У всіх випадках не кладіть палець на спусковий гачок, доки не буде потреби у відкритті вогню.
7. Перед навчальною стрільбою насухо протріть канал ствола; перевірте, чи немає в стволі сторонніх предметів; переконайтеся в справності зброї та спорядження до неї.

1. У чому полягає підготовка автомата та патронів до стрільби?
2. У чому полягає порядок обслуговування автомата після стрільби?
3. Які можуть виникнути затримки і несправності під час стрільби з автомата АК-74? Назвіть їх причини та способи усунення.
4. Дайте характеристику паливно-мастильним матеріалам,
5.
6.

7.


повне — для чищення у разі сильного забруднення
мата, після застосування його під дощем (снігом) і під час ремонту.
то часте розбирання автомата шкідливе, тому що прискорює зношування частин і механізмів. Розбирання і складання
столі або чистій підкладці; частини й механізм слід розміщувати
хідно перевірити відповідність номерів ствольної
2.
відник вогню вниз, поставивши
ба) або ОД (одиночна стрільба) ( іл. 23.2 ), відвести за рукоятку затворну раму назад ( іл. 23.3 ), оглянути патронник, відпустити рукоятку затворної рами й спустити курок з бойового взводу. Під час розбирання автомата



правої (лівої) руки відокремити кінець шомпола від ствола так, щоб його головка вийшла з-під упору на основі мушки, і витягнути шомпол ( іл. 23.4 ). У разі ускладненого відокремлення шомпола можна використати вибивач, який слід Іл. 23.4. Відокремлення шомпола


вставити в отвір головки шомпола, відвести від ствола кінець шомпола й витягнути його.
4. Відокремити дульне гальмо-компенсатор. «Утопити» пальцем руки
або викруткою фіксатор гальма-компенсатора й викрутити гальмо-компенсатор із різьбового виступу колодки мушки (зі ствола), обертаючи його проти ходу годинникової стрілки ( іл. 23.5 ).
У випадку надмірно тугого обертання корпусу гальма-ком-
пенсатора припускається викручування його за допомогою


23.5. Відокремлення дульного гальма-компенсатора
шомпола, уставленого в отвори гальма-компенсатора. 5. Відокремити кришку ствольної
Правою рукою обхопити шийку (передню частину) приклада, великим пальцем руки натиснути



за ствольну накладку, правою рукою подати вперед спрямовуючий стер-жень зворотного механізму до виходу йогоп’яти з поздовжнього стержня ствольної коробки; підняти задній кінець спрямовуючого стержня

Іл. 23.7. Відокремлення зворотного





руку, а затвор — у праву й вставити
творної рами, повернути
рами, невеликим зусиллям притиснути її
ствольної коробки і подати вперед до упору.
4. Приєднати зворотний механізм. Утримуючи автомат лівою рукою, правою рукою ввести зворотний механізм у канал затворної рами, стискаючи зворотну пружину, подати спрямовуючий стержень уперед
7. Приєднати дульне гальмо-компенсатор. Закрутити
мо-компенсатор на різьбовий
дульного гальма-компенсатора не
ти корпус дульного гальма-компенсатора
сполучення паза з фіксатором.
8. Приєднати шомпол. Вставити різьбовий кінець шомпола в
у кільці цівки й закріпити його. «Утопити» шомпол. Головку шомпола вставити в паз на колодці мушки.
9. Приєднати магазин до автомата. Виконання розбирання (складання) автомата: учень підходить до місця, де розкладено зброю. Час відлічують з моменту подачі команди: «До неповного розбирання (складання) зброї приступити!» — до доповіді учня: «Готово!».

1. Як і у якій послідовності проводять неповне розбирання АК-74?
2. Як і у якій послідовності проводять неповне збирання АК-74?
3. Обґрунтуйте необхідність тренування в розбиранні та складанні автомата.

Яке, на вашу думку, призначення малокаліберних і пневматичних гвинтівок?


Калібр ствола, мм
Довжина гвинтівки, мм
Довжина ствола, мм
Довжина прицільної лінії, мм
Прицільна дальність, м
Найбільша дальність польоту кулі, м
Убивча сила, м
Початкова швидкість польоту кулі, м/с
Швидкострільність, пострілів/хв 10 Кількість нарізів
Маса, кг
Гвинтівка ТОЗ-12 з діоптрійним прицілом призначена для початкового навчання зі

закривати канал ствола, здійснювати постріл, викидати стріляну гільзу. Спусковим механізмом здійснюють
Прицільний пристрій слугує
кута прицілювання.
Тильна кришка захищає очі стрільця
час стрільби. Ложе з’єднує всі частини гвинтівки, слугує
має приклад, шийку, цівку.
Заряджання малокаліберної гвинтівки проводять так: відкривши і відвівши затвор, узяти патрон за
неться на торець

§ 24. Малокаліберна, пневматична
що приводиться в рух енергією стиснутих газів або повітрям. Пневматична гвинтівка пружинно-компресійного типу належить до наймасовіших моделей. Вирізняється простотою й високою надійністю.

Іл. 24.3. Пневматична гвинтівка ІЖ-38. Загальний вигляд

Іл. 24.4. Складові частини і механізми рушниці ІЖ-38: 1 — ствол; 2 — приціл; 3 — вісь ствола; 4 — прокладка ствола; 5 — коробка ствола; 6 — поршень; 7 — пружина бойова; 8 — колодка механізму спускового; 9 — штифт колодки; 10 — ложа; 11 — гвинт ложі задній; 12 — гачок спусковий; 13 — шептало; 14 — важіль блокування; 15 — важіль зведення; 17 — манжета; 18 — шарнір; 19 — клин; 20 — ригель; 21 — пружина ригеля; 22 — вісь шарніра
Таблиця 24.2
Характеристики ІЖ-38
Калібр ствола, мм 4,5
Довжина нарізного ствола, мм
Початкова швидкість польоту кулі, м/с 150–180 Зусилля спуску, кг 2–3 Загальна довжина рушниці, мм 1050 Маса, кг 2,8 Однозарядна пружинно-поршнева гвинтівка моделі
нарізним сталевим стволом.


комплект входять насадки: циліндр (для стріляння кулею); півчок (для стріляння картеччю); чок (для стріляння дробом), а також насадки для використання несмертельних боєприпасів, спеціальних набоїв і гранат зі сльозогінним газом.

Надійне замикання каналу цівки здійснюється поздовжньо-ковзаючим Іл.
замком. Механізм стріляння куркового типу.
Рушниця конструктивно призначена для стрільби тільки
лібру 12 мм з довжиною гільзи 70 мм та калібру 12 мм «магнум» з довжиною гільзи не більше 76 мм, за загальної
більше 65 мм.
технічні дані та характеристики ФОРТ-500 Калібр, мм 12/70,12/76(23/4",3")
Довжина набійника, мм
Маса рушниці без стрілецького паска, кг 3,85 (3,6) Запобіжник від випадкового
Будова рушниці. Рушниця складається
замка, ударно-спускового механізму, трубчастого магазина, підцівника, ручки та розкладного приклада. Цівкова скринька з’єднує основні деталі рушниці: цівку, магазин, ручку і розкладний
стінках цівкової скриньки
сковий механізм розміщено
з рушниці. Для переведення приклада зі
повернути його у вертикальній площині
спрацювання фіксатора розгорнутого стану приклада. Заряджання . Перемістіть
вернувши рушницю так, щоб спускова клямра була зверху. Просувайте передній край набою в магазин до тих пір, доки ободок набою не зайде за правий відсікач.

Ніколи не намагайтесь перебільшити місткість магазина!
Стрільба . Коли дуло рушниці спрямоване на ціль, а рушниця заряджена, установіть запобіжник в позицію «вогонь», прицільтесь, натисніть спусковий гачок на довжину ходу, рушниця вистрелить. Щоб перезарядитися, відведіть підцівник повністю назад. Щоб продовжити стрільбу, подайте новий набій із магазина в набійник, перевівши підцівник
рушниця із широким спектром

24.4 )
МР-153 є зразком самозарядної рушниці, який розроблений під патрон 12/89 і надійно функціонує з усією гамою патронів 12-го калібру — від 12/70 до 12/89 у будь-яких комбінаціях
Рушниця
змінними
зубцями, закріпленими на
коробки. Затвор закривається у відкритому положенні після пострілу останнього патрона. Для звільнення затвора рушниці
ня затвора в передній частині ствольної коробки праворуч. Важіль зупинки каретки знаходиться на правій стороні ствольної коробки на передньому торці корпусу спускового механізму. Після зведення курка затвор не блокуватиметься в крайньому задньому положенні, якщо цей важіль не поданий назад.

1. Виконайте самоперевірку знань правил безпеки поводження з малокаліберною та пневматичною зброєю.
2. Укажіть, до якого виду зброї належить ТОЗ-8. Яке основне її призначення? Назвіть основні характеристики цього виду зброї.
3. До якого виду зброї належить ІЖ-38? Яке основне її призначення? Назвіть основні характеристики.
4. Укажіть, до якого виду зброї належить рушниця МР-153.
5. Назвіть принцип дії помпової рушниці.
6. Перелічіть основні переваги і
та напівавтоматичних гладкоствольних рушниць.

Яке, на вашу думку, основне призначення малокаліберних
матичних гвинтівок? Основи стрільби

або в тирі, заборонено: вести стрільбу з несправної зброї; брати на вогневому рубежі зброю, торкатися
зволу керівника стрільби; заряджати і передавати зброю без команди керівника; прицілюватися в мішені навіть незарядженою зброєю, якщо біля мішеней є люди; спрямовувати зброю
не докладати сили, не вдаряти частини зброї одна об одну.
Не можна зберігати гвинтівку з пластмасовими деталями в приміщеннях разом з фенолами, концентрованими кислотами, лугами, органічними розчинниками й іншими речовинами, що руйнують пластичні маси.
Під час перевезення (перенесення) навчальної зброї вона має бути розряджена. Переносити зброю в навчальних приміщеннях і
у
мінь» чи «на плече».
Умови стрільби з пневматичної гвинтівки або електронної зброї.
снюють 3 пробних, 5 залікових пострілів; час
готовку — 3 хв.
Стрільбу з пневматичної гвинтівки (ІЖ-38, ІЖ-60, МР-512, ІЖ-32, МР-532, MLG, DIANA) проводять з
рою ліктями




напруги, стійкість гвинтівки і рук найбільша, а заряджання гвинтівки найзручніше. Стрілець сідає за стіл або стає близько стійки, вибираючи найбільш зручну для себе позу. Усе тіло трошки повернуто праворуч від лінії прицілювання. Рекомендують під час стрільби злегка притулятися грудьми до ребра столу, але при цьому зберігати вільну позу з мінімальною напругою м’язів.
Гвинтівку треба взяти пальцями правої руки
палець
чотири пальці — справа. Долонею лівої руки взяти цівку ложа знизу так, щоб великий палець охоплював лівий бік цівки, а решта чотири
боку.
Потім нахилитися над столом і спертися ліктями на стіл або,
стрільба стоячи
стійки, спертися
на стійку. При цьому лівий лікоть і плече повинні бути
Гвинтівку треба вставити затильником у виїмку
і притиснути до нього. Голову опустити на гребінь приклада. Ноги стрілець ставить так, як йому зручно. Положення


Іл. 25.4. Уточнення наведення гвинтівки по вертикалі під час стрільби сидячи за столом: 1 — напрямок переміщення корпусу стрільця; 2 — лінія прицілювання після уточнення наведення гвинтівки; 3 — розташування прицілу після уточнення наведення гвинтівки; 4 — суміщені точки наведення і прицілювання; 5 — «яблучко» мішені — виявилося вище; 6 — точка наведення гвинтівки до уточнення: 7 — лінія прицілювання до уточнення наведення гвинтівки; 8 — лікті стрільця мають бути
то
вертикальної осі 2, що проходить
прицілювання 6. Якщо точка наведення гвинтівки 6 ( іл. 25.4. ) виявилася нижче (вище) точки прицілювання 4, то треба трохи відсунутися (присунутися) зі стільцем від столу або стати трохи далі (ближче) від стійки, але не зрушуючи з місця лікті 8. Влучна стрільба
прикладки гвинтівки для всіх пострілів вправи, що виконується. Розміщення приклада
би. Прицілювання ( іл. 25.5 ) складається
прицільного пристосування на
дистанцію; б) наведення гвинтівки на ціль за допомогою прицільного пристрою.

Іл. 25.5 Схема прицілювання в разі перевищення середньої точки прицілювання: 1 — середина прорізу прицілу: 2 — верхній край мушки; 3 — лінія прицілювання; 4 — середня траєкторія куль; 5 — середня точка влучення — центр мішені; 6 — мішень; 7 — точка прицілювання; 8 — ствол гвинтівки Установка прицілу на задану дистанцію відпрацьовується окремо в вертикальній і горизонтальній площинах. У пневматичній гвинтівці ІЖ-38 (ІЖ-22) це досягається
під час приведення
стрільби.
Рекомендують прицілювання розбити на два етапи — попередній і
новний.
Попередній етап займає понад половину всього часу прицілювання, повинен бути використаний для перевірки правильності прикладання.
Основний етап використовують для точнішого наведення гвинтівки і підготовки до натискання на спусковий гачок. Таке поетапне прицілювання зменшить втому зорової системи і підвищить точність стрільби. Кожен постріл потрібно здійснювати по можливості швидко, а паузи між пострілами робити досить тривалими, щоб очі встигали відпочити. Для стрілецької зброї застосовуються різні види прицілів: відкриті, діоптрійні з прямокутною або кільцевої мушкою, оптичні.
У гвинтівок ІЖ-38 (ІЖ-22) приціл відкритий.
Прицілювання здійснюється одним оком , яке називають провідним. Більшість стрільців прицілюється правим оком, тобто провідним оком є праве. Але є і винятки. Для визначення провідного ока застосовують різні методи.
Найпростіший метод: в аркуші паперу розміром 20 × 20 см треба вирізати круглий отвір діаметром 3 см. Потім,
стрільби. Тому рекомендують під час стрільби дивитися обома очима.
це важко, то непровідне око можна прикрити вузької вертикальною смужкою з білого паперу або з пластику таким чином, щоб мішень для непровідного ока була закрита.

Іл. 25.6. Відхилення гвинтівки через коливання
стрільця в різні сторони від точки прицілювання Прицілювання з відкритим прицілом. Для прицілювання необхідно провідним оком дивитися через середину прорізу прицільної планки на верхній край мушки так, щоб
то
литься від центру мішені на 23,4 мм.
Отже, найбільші відхилення бувають від нерівної мушки, тобто від кутових помилок відхилення
тимуть «корону».
Який же з елементів прицілювання важливіше бачити ясно? Практика свідчить: кращий результат буде за чіткого бачення мушки. Розміщення ясної мушки посередині прорізу прицільної планки досягається легко, так як розпливчастість країв прорізу однакова з обох сторін мушки. А ось
за висотою розмістити мушку важко, так як не видно чіткої межі верхніх виступів прицільної планки і «яблучка», вони мають «корони» (іл. 25.7).
Практика довела, що слід вирівнювати мушку тільки за суцільною лінією верхніх виступів прицільної планки і не зважати на нечіткуої частину («корону») прицільної планки.
Напружена і систематична

Іл. 25.7. Правильне бачення елементів прицілювання при стрільбі з відкритим прицілом: 1 — «корона» верхнього краю прицільної планки; 2 — «яблучко» мішені; 3 — «корона» «яблучка» мішені; 4 — чітка мушка

вання було праворуч, пробоїни виявляться не тільки вище, але і правіше.

Зберігайте використані мішені, щоб стежити за своїми успіхами. З’ясуйте, як глибоко вам потрібно натискати курок. Коли прицілюєтесь, злегка натисніть на курок, щоб у той момент, коли ви готові вистрілити, вам потрібно буде зробити невелике зусилля. Що менше руху знадобиться для пострілу, то менше зіб’єтеся з цілі. Відходите на дальшу відстань від мішені, коли ваші результати покращаться.
Будьте терплячими! Ви не станете стрільцем світового класу після кількох пострілів; на це потрібні роки практики. Можливо, ви досягнете етапу, коли вам буде здаватися, що ви вже не вдосконалюєтеся. Це означає, що ви відпрацювали свою техніку і досягли межі своїх можливостей. Із цього моменту, все, що ви можете робити, — це практикуватися, і в підсумку ви перейдете на новий рівень професіоналізму. Це вимагає
корисно, якщо ви стріляєте по рухомих

1. До якого виду зброї належить ІЖ-38?
2. У чому полягає порядок підготовки до стрільби ІЖ-38?
3. Перелічіть способи стрільби з пневматичної гвинтівки.
4. Охарактеризуйте етап прицілювання під час стрільби з ІЖ-38.
5. Охарактеризуйте помилки під час стрільби з ІЖ-38. Як усунути їх?

7. 6. Здійсніть взаємоперевірку


Доведіть прикладами, що зброя та
стрілецької зброї — фактори підвищеної небезпеки. Загальна будова боєприпасів до стрілецької
Елементи бойового патрона Набій (унітарний набій (патрон) ( іл. 26.1 ) — боєприпаси стрілецької зброї та малокаліберних гармат (до 76 мм), що заряджається в один (лат. unitas — єдність) прийом. Унітарним патроном може бути артилерійський постріл або набій, у якому є снаряд (куля, картеч або заряд дробу), заряд пороху, запальний елемент (капсуль-запальник).
Патрон ( іл. 26.2 ) (від нім. Hьlse — «оболонка») — тонкостінна закрита з одного кінця трубка (стакан), призначена для розміщення метального заряду і засобів займання (ініціації), що слугує оболонкою унітарного збройового патрона або артилерійського пострілу для вогнепальної зброї і що сполучає в одне ціле конструктивні частини патрона: снаряд (кулю, дробовий заряд, артилерійський Іл. 26.2. Гільза снаряд тощо), пороховий заряд і капсуль-запальник. Найважливіші якості збройової гільзи — герметичність, стійкість до корозії, міцність і легкість вилучення її з патронника після пострілу.

1 — куля; 2 — гільза; 3 — заряд пороху; 4 — денце із закраїною; 5 — запальний елемент (капсуль) й іноді додаткові елементи, з’єднані в одне ціле за допомогою гільзи
Іл. 26.1. Схема унітарногопатрона


Іл. 26.3. Бойовий патрон: 1 — куля; 2 — гільза; 3 — пороховий заряд; 4 — капсуль; 5 — дульце; 6 — проточка; 7 — ковадло; 8 — затравочний отвір; 9 — ударний склад
Бойовий патрон 5,45 мм складається з кулі, гільзи, порохового заряду і капсуля ( іл. 26.3 ). Маса — 10,2 г (7,62 мм — 16,2 г). Звичайна куля (маса — 3,4 г) призначена для ураження живої сили супротивника (іл. 26.4). Складається


сталевим
б) трасуюча; 1 — оболонка; 2 — свинцева сорочка; 3 — сталева серцевина; 4 — свинцева серцевина; 5 — стаканчик трасера; 6 — трасуюча суміш

Патрони 5,45 мм упаковані в дерев’яні ящики. У кожному з них
тяться дві цинкові герметично зачинені коробки. У кожній містяться картонні коробки ( іл. 26.5 ) по 30 патронів у
характеристики
розрізняють за калібром, будовою кулі, наявністю закраїни гільзи, призначенням та
використовується.
Єдине, що залишається загальним для всіх патронів, — це унітарність та центральне запалювання (розташування капсуля на донці
по повздовжній осі патрона). За типом патрони



5,45 мм патрон зразка 1974 р. (5,45 × 39 мм) ( іл. 26.8 ). Початкова швидкість кулі — 890 м/с; енергія кулі — 1347 Дж. Патрон
ли як автоматний з малим імпульсом для збільшення стійкості зброї під час стрільби та збільшення боєзапасу, що переносять, у 1,5 разу порівняно з патроном зразка 1943 р. Прийнятий на озброєння в 1974 р. одночасно з АК–74.
Патрон має сталеву лаковану гільзу та гострокінцеву кулю зі сталевим сердечником у свинцевій оболонці. Куля в подовженій головній частині має 4-міліметрову порожнину, потрібну для перерозподілу ваги, що впливає на стійкість польоту і зумовило чимало легенд про кулі «із зміщеним центром ваги». Кулю 7Н10 (маса 3,6 г) виготовляють з 1992 р., вона має збільшений за рахунок порожнини термостійкий сердечник та збільшене бронепробивання. Виготовляють патрони зі спеціальними кулями: трасуючою — Т (7Т3), бронебійною — Б (7Н22) та зі зменшеною швидкістю для безшумової стрільби — УС (7У1), а також холостий патрон з порожньою пластиковою кулею (7×3).
7,62 мм патрон зразка 1943 р. (7,62 × 39 мм) (іл. 26.9). Початкова швидкість кули — 715 м/с; енергія кулі — 2019 Дж.
Патрони виготовляють зі спеціальними кулями: трасуючі — Т-45, бронебійно-запалювальні — БЗ, запалювальні — З, бронебійні — Б (7Н23) і зі зменшеною швидкістю для безшумової стрільби — УС, а також холості патрони.
7,62 мм гвинтівковий патрон (7,62 × 54 мм) ( іл. 26.10 ). Початкова швидкість кулі ЛПС — 830 м/с; енергія кулі — 3306 Дж. Прийнятий на озброєння у 1891 р. під назвою «трьохлінійний гвинтівковий патрон». 9 мм патрон «Терен-3Ф» ( іл. 26.11 ) (споряджений еластичною кулею) застосовується для стрільби з пістолета калібру 9 мм, призначеного для патронів з еластичною кулею. Патрон «Терен-3Ф» для пістолетів нелетальної




26.12. 5,45

25.16. 5,45




кулею (5,45 БТ). Забезпечує підвищене





Іл.
Для заряджання
магазин (якщо він не був приєднаним) ( іл. 26.21 ).
Для безпомилкового приєднання магазина виконайте такі дії: піднесіть магазин подавачем угору до автомата так, щоб великий палець був на передній частині спускової скоби (тоді магазин розміститься під вікном ствольної коробки).

введіть верхню передню частину магазина у вікно ствольної коробки і поверніть його на себе до клацання; Іл. 26.21. Під’єднання магазина до автомата патронами
зніміть автомат із «запобіжника» (переведіть перевідник униз і встано-
віть на необхідний вид вогню);
відведіть за рукоятку затворну раму
проводжуючи; встановіть автомат на «запобіжник» (переведіть
верхнє положення), якщо
зин у ліву руку горловиною вгору



1.
2.
3.

4.
5.

Назвіть основні та проміжні сторони горизонту. Як визначити
на карті сторони горизонту?
У бойовій діяльності командирів підрозділів орієнтування на місцевості
необхідне під час доведення бойових завдань підрозділам, дотриманні напрямку руху, визначенні досягнутих рубежів і місця розташування цілей, а також з метою цілеспрямування та управління підрозділами та вогнем. У сучасному бою навіть тимчасова втрата орієнтування призводить до порушення взаємодії між підрозділами, ставить під загрозу своєчасне виконання бойового завдання. Помилки в орієнтуванні, а відповідно й у визначенні на місцевості досягнутих рубежів і положення цілей, можуть різко знизити ефективність застосування зброї
техніки. Тому вміння швидко і безпомилково орієнтуватися на місцевості в будь-яких
розташування стосовно навколишніх місцевих предметів і форм рельєфу, а також дотриманні запланованого або вказаного напрямку руху.
умовах орієнтування визначає, крім цього, положення на місцевості орієнтирів, своїх військ і військ супротивника, напрямок і глибину дій. Магнітний компас Під час орієнтування найчастіше використовують компас Адріанова ( іл.
— на Південний магнітний
шкала
стрілки, від 0° до 360
, через 15° (5 поділок шкали) і зовнішній

металевих предметів стрілка відхиляється від напрямку вздовж магнітного меридіана. Тому, визначаючи сторони горизонту, слід відходити від лінії електромережі, залізниці, бойової техніки, великих металевих предметів на відстань 40–50 м.
Орієнтування компаса, визначення сторін горизонту Поверненням кола встановлюють показник відліку, розташований навпроти мушки, на нульовий відлік за шкалою, а компас — приблизно в горизонтальне положення. Потім відпускають гальмо магнітної стрілки і повертають компас у горизонтальній площині так, щоб північний кінець стрілки збігався з нульовим відліком шкали. Потім, не змінюючи положення компаса, проводять візуалізацію через цілик і мушку, запам’ятовують на лінії візуалізації, який використовують як напрямок на північ із точки стояння.

Іл. 27.2. Взаємне розташування сторін горизонту Напрямки на сторони горизонту взаємопов’язані між собою ( іл. 27.2 ). Якщо відомий хоча б один із них, наприклад на північ, то в протилежному напрямку буде південь, праворуч — схід, а ліворуч
та кордонів використовують проміжні напрямки між сторонами горизонту. Наприклад, «
у південно-західному напрямку» або «Від висоти «Невідома» кордон проходить на відстані 1650 м у північно-східному напрямку ». Напрямки на сторони горизонту найчастіше визначають за компасом, місцем знаходження небесних світил і певними
або в районах
за положенням Сонця. У Північній півкулі Сонце сходить
час дня. Для визначення сторін горизонту за Сонцем і годинником
способів.
Перший спосіб. На аркуші паперу замальовують коло і ділять на 24 частини. Рисочку зверху позначають цифрою 14, знизу — 2, праворуч — 20, ліворуч — 8, а відносно цих цифр підписують інші цифри циферблату (від 1 до 24), в результаті чого ми отримаємо астрономічний циферблат для визначення сторін горизонту влітку (для визначення сторін горизонту взимку циферблат необхідно підписати — 13, 1, 19 і 7 відповідно).
У напрямку від центра кола вверх до цифри 14 (взимку — 13)
наносять стрілку і підписують «Південь». Другу стрілку накрес-
люють у напрямку на час спостереження і направляють на Сонце.
При такому положенні стрілки на Сонце попередньо нанесена стрілка на «Південь» вкаже відповідний напрямок. На іл. 27.3 показано визначення сторін горизонту

Іл. 27.3. Визначення сторін горизонту за сонячним
за сонячним компасом (влітку) о 10:00. Такий компас
і вночі, коли видно повний
ложення хвилинної стрілки
Кут між годинною стрілкою
та напрямком на цифру 2 (взим-
ку — на цифру 1) на циферблаті
годинника ділять навпіл — це і буде напрямок на південь влітку.
До півдня ділять навпіл ту дугу (кут), яку годинна стрілка має пройти до 14 (13) години (рис. 1.5а), а після півдня — ту дугу (кут), яку вона пройшла після 14 (13) години ( іл. 27.4 ). Іл. 27.4. Визначення сторін горизонту


ризонту після обіду, наприклад, о 17:00 (влітку Сонце з 14:00 до 17:00 пройшло по небосхилу кут у 45°), треба стати правим боком з витягнутою рукою у напрямку Сонця, лівою — встановити кут у 90°, який теж необхідно поділити навпіл, напрямок якого вкаже на південь.
Спосіб використовують за складних умов орієнтування і
цьому напрямок руху необхідно
відці, при здійсненні стрімкого маневру, виконанні спеціальних

за можливості, кілька ознак. Більшість із них зумовлені розташуванням місцевих предметів відносно Сонця, а саме:
вівтарі православних церков звернені на схід, а головні входи — на захід;
вівтарі костьолів звернені на захід;
припіднятий кінець нижньої поперечини хреста церкви звернений на північ;
відстань між кільцями на пеньках

дерев більша в напрямку з півночі на південь; Іл. 27.7. Визначення сторін горизонту за ознаками місцевих предметів навесні трава з південної
від цих предметів; сніг швидше тане на південних схилах; унаслідок цього на снігу утворюються зазубрини — шипи, які спрямовані на південь; ягоди та фрукти скоріше дозрівають (червоніють, жовтіють) з південної сторони; кора великих дерев грубша на північній стороні й тонша, еластичніша — на південній; дерева, каміння, черепичні та шиферні дахи раніше й густіше покриваються мохом, лишаями, грибками з північного боку; на деревах хвойних порід смола рясніше накопичується
боку;
мурашники розташовуються
сторони дерев, пеньків та кущів; окрім того, південний схил мурашників найчастіше пологий, а північний

го Арктичного архіпелагу. Через те розрізняють істинний (географічний) та магнітний азимути.

Істинний азимут (Аі) — кут між напрямком на Північний географічний полюс і на даний об’єкт.
Відповідно об’єкт з’єднує з географічним полюсом істинний меридіан . Саме такі меридіани наносять на карту.
Азимут, визначений за допомогою компаса, називають магнітним (Ам). Магнітний азимут — це

нітний
Визначення магнітного азимута компасом. Стати обличчям до орієнтира. Відпустити

Іл.27.8. Визначення напрямків (магнітних азимутів)
пристрій так, щоб крізь цілик і мушку бачити
магнітний азимут на орієнтир становить 300° . Щоб визначити зворотний азимут (азимут повернення), необхідно від визначеного магнітного азимута відняти 180°, а якщо його значення менше 180°, то додати 180° . Магнітний азимут напрямку визначають за допомогою компаса в такому порядку: відпустити гальмо; мушкою візирного пристрою встановити відлік заданого азимуту, наприклад, 300о і повернутися разом
вивченні
орієнтирами;
оформленні даних на карті
складанні схеми руху.
Вивчаючи місцевість, оцінюють її прохідність, маскувальні й захисні властивості, визначають важкопрохідні й непрохідні перешкоди і шляхи їх обходу.
План маршруту залежить від характеру місцевості, наявності на ній орієнтирів і умов руху. Головне — це вибрати маршрут, що дає змогу швидко й непомітно для супротивника вийти до вказаного пункту (об’єкта). Маршрут прокладають із таким розрахунком, щоб він мав мінімальну кількість поворотів. Точки повороту маршруту вказують біля орієнтирів, які можна легко розпізнати на місцевості (башти, перехрестя, мости, шляхопроводи, геодезичні знаки).
Відстані між орієнтирами під час пересування за маршрутом удень пішим порядком не мають перевищувати 1–2 км. Для переміщення вночі орієнтири намічають частіше.
Щоб забезпечити непомітний вихід до вказаного пункту, маршрут прокладають через балки, масиви рослинності та інші об’єкти, що забезпечують маскування руху. Необхідно уникати переміщень по гребенях висот і відкритих ділянках.
Значення магнітних азимутів і відстаней ретельно перевіряють, оскільки помилка при вимірюванні хоча б одного азимута чи відстані призводить до відхилення від запланованого маршруту і
орієнтування. Дані, необхідні для руху за азимутами, наносять на карту, а якщо її із собою


у

Іл. 27.11. Обхід перешкод пари кроків, беручи до уваги
за компасом напрямок, продовжити рух. На закритій місцевості
здійснювати
таким чином ( іл. 27.11 ): а) підійшовши до перешкоди (т.1),
рухатися за цим азимутом, вимірюючи
перешкоди (т.2); б) у т. 2 записати пройдену відстань (відрізок 1–2) і визначити напрямок за початковим азимутом, зробити поворот і рухатися до т. 3 (кінець перешкоди), рахуючи кроки; в) прийшовши в т. 3, рухатися ліворуч (праворуч) до т. 4 за зворотним азимутом до напрямку 1–2, поки не буде пройдено шлях, що дорівнює відстані між т. 1 і 2; г) у т. 4 визначити напрямок
відрізка 2–3 (ширину перешкоди в напрямку маршруту).
Пересуваючись на машині, обхід перешкоди здійснюють

1. У чому полягає суть і завдання орієнтування?
2. Які ознаки місцевих
3.
4.

5.
найчастіше використовують під час орієнтування?

умовні знаки вам відомі. Складання опису місцевості Географічний
ють із загальної характеристики території. Потім складають опис кожного географічного елемента. У загальній характеристиці місцевості вказують таку інформацію: дані про карту (номенклатура, масштаб, рік видання тощо);
відомості про межі ділянки (географічні та прямокутні координати її кутів), геодезичну основу (види опорних пунктів, їх кількість); характеристику місцевості (рельєф, населені пункти, шляхи сполучення, ліси тощо).
Після загальної характеристики описують географічні елементи місцевості :
рельєф ділянки (форми рельєфу, площа ділянки, протяжність, позначки абсолютних і відносних висот, головні вододіли, форма і крутизна схилів, наявність ярів, урвищ, вимоїн із зазначенням їх протяжності та глибини, штучні форми рельєфу тощо); гідрографію (назви окремих об’єктів; протяжність, ширина, глибина, напрямок і швидкість течії річок, похил, береги, заплави; транспорт, наявність гідротехнічних споруд тощо; площа, типи берегів, якість води озер; канали, джерела, колодязі тощо); рослинність (тип, склад порід, площа, розміщення); населені пункти (назва, тип, людність, адміністративне значення, структура і планування, об’єкти промисловості, комунального господарства, зв’язку тощо);
шляхи сполучення (тип; для автомобільних доріг — назва дороги або пунктів, які вона з’єднує, характер покриття, ширина тощо; для залізниць — кількість колій, вид тяги, назва станцій, вокзалів тощо; споруди на дорогах);
інші елементи місцевості (межі, ґрунти тощо).
Необхідно також зазначити, що сучасна топографічна карта надає найповнішу інформацію про місцевість. Проте, сучасні вимоги військ до отримання відомостей про місцевість настільки багатогранні, що задовольнити їх лише топографічними картами дуже важко, оскільки можливості карти можуть бути обмеженими. Наприклад, умовними знаками
на отримати додаткові відомості про топографічні елементи місцевості та інші дані, відсутні на топографічних картах. Наприклад, щодо населених пунктів у довідці можна отримати відомості про характер планування і густоту забудови кварталів, характеристику матеріалу будівель, наявність підвальних приміщень й інших сховищ, ширину головних проїздів та інших вулиць, матеріал їхнього покриття, а також наявність промислових і комунальних підприємств. Щодо дорожніх мереж, окрім загальної характеристики, у довідці надають додаткову інформацію про найбільшу величину підйомів і спусків, найменші радіуси поворотів, а також додаткові характеристики дорожніх споруд.
Щодо рельєфу і ґрунтів довідка надає відомості про основні форми рельєфу, які переважають, а також загальну характеристику ґрунтів та умови прохідності поза дорогами. Крім того, окремо до довідки подають схему ґрунтів даної місцевості. Гідрографія в довідці про місцевість представлена узагальненими та систематизованими відомостями про водні рубежі: режим річок
водоймищ протягом року, період
ків, можливість наведення переправ тощо. Надають додаткові відомості
час повеней і


По-перше,
По-друге, вони не схожі
По-третє, створюючи їх, враховують
що зображуються.
По-четверте, властивістю топографічних
Топографічні
фічні знаки .
розміри яких можливо передати в масштабі карти або плану ( іл. 28.2 ). Масштабними є
контурні зображення, наприклад озеро, ліс, фруктовий сад. Кожний масштабний знак


Розділ 5. Тактична підготовка
Викреслюються вони пунктиром, якщо вони не збігаються з іншими лініями на місцевості (канавами, дорогами, парканами), які відображаються своїми умовними знаками.
Позамасштабні умовні знаки застосовуються для зображення дрібних місцевих предметів, які не виражаються у масштабі карти, — окремі дерева, будинки, колодязі та ін. ( іл. 28.3 ). Під час зображення такого об’єкта в масштабі на карті отримаємо точку. Позамасштабний умовний знак включає цю якби головну точку, яка показує точне місцеположення даного об’єкта на карті, і своїм рисунком показує, що це за об’єкт.

Іл. 28.3. Місцеві предмети, які зображені позамасштабними умовними знаками (стрілками показані точки, що відповідають місцеположенню предмета на карті): 1 — завод (фабрика) з трубою; 2 — колодязь; 3 — тригонометричний пункт; 4 — пам’ятник; 5 — окремий камінь; 6 — кілометровий стовп; 7 — покажчик доріг; 8 — окремо розміщене дерево; 9 — окремий кущ; 10 — дерев’яний міст Пояснювальні умовні знаки застосовуються для додаткової характеристики місцевих предметів і показу їх різновидів. Наприклад, фігурка хвойного або листяного дерева всередині лісу показує породу, яка в ньому переважає, стрілка на річці – напрямок течії. Пояснювальні підписи на картах . Крім умовних знаків, на картах використовують повні і скорочені підписи, а також цифрові характеристики певних об’єктів. Повністю підписуються власні назви населених пунктів, рік, урочищ, гір і т.п.
Скорочені пояснювальні підписи , що супроводжують умовні знаки, стандартні, як і самі знаки, для всіх топографічних карт ( табл. 28.1 ). Таблиця 28.1.
А асфальт (матеріал покриття доріг) П піщаний (ґрунт дна річки)
арт. к. артезіанський колодязь пер. перевал (гірський), перевіз Б бруківка (матеріал покриття доріг)
бер. береза (порода лісу)
бл. п. блокпост (залізничний)
бр. брід
бр. мог. братська могила
б.тр. будка трансформаторна
пісок (продукт добування)
печера
платформа (залізнична)
ставок, протока
шляховий пост
роз’їзд В в’язкий (ґрунт
водонапірна башта
глина (продукт добування)
208
г.прох. гірський прохід
радгосп шп. шпиталь
силосна башта (г.-сол.) гірко-солона (вода)
склад
ГЕС гідроелектростанція (сол.) сол. солона вода, соляні розробки
Д дерев’яний (матеріал мосту) СС сільська рада
ЗБ
залізобетонний (матеріал мосту) ст. станція
запов. заповідник (сух.) сухий колодязь
зим. зимівля, зимовище Т твердий (ґрунт дна річки)
Джер. джерело тун. тунель
К кам’яний (матеріал мосту) ур. урочище К.
колодязь Ц цементобетон (матеріал покриття доріг)
кам. каменоломня, камінь шах. шахта
лісн. дім лісника
Шл шлак (матер. покриття доріг)
модр. Модрина (порода лісу) шл. шлюз
маш. машинобудівельний завод шк. школа
МТФ молочнотоварна ферма
(матеріал покриття доріг)
о., о-ва острів, острови елев. елеватор
оз. озеро
Скороченими
які не
значенням. Наприклад, біля
ставиться підпис — шк ., біля казарми — каз ., навколо сараю
сар
і т.п. Цифрові позначення застосовуються для визначення кількості будинків у населених пунктах селищного типу, висот найбільш характерних точок рельєфу (видимих вершин, перевалів і т.п.), межового рівня води у річках і т.п.

1. Що таке азимут, істинний азимут, магнітний азимут?
2. Як визначають магнітний азимут напрямку?
3. Як здійснюють рух у заданому напрямку за допомогою компаса?

4. Як поділяють топографічні знаки?
5. Використовуючи топографічну карту, опишіть ділянку місцевості, визначену вашим товаришем / товаришкою.

тощо.
орієнтирів, місцевих предметів, цілей, інших об’єктів. Існують різні способи і прилади для визначення відстаней на місцевості: по карті, аерофотозйомки, за допомогою далекоміра і т.д. Але існують і більш прості способи вимірювання. Окомірно Це спосіб є найбільш поширеним і доступний кожному, так як відстані визначаються без застосування будь-яких приладів, що дуже важливо в умовах бойової обстановки, але його точність залежить від величини відстані, що визначається, умов спостереження і досвіду спостерігача. У досвідченого спостерігача помилка у визначенні відстані 1 км складає 10–15%, у недосвідченого — 30–50%. При збільшені відстані збільшується і помилка. Тому уміння впевнено
ні до цілей противника

вгору здається, що предмети ближче, а вниз — далі. Якщо між спостерігачем і предметом немає інших
що
якщо є — далі; при спостереженні через водні простори, лощини та інші пониження рельєфу відстані здаються меншими; при спостереженні в ясний сонячний день предмети здаються ближчими, ніж при спостереженні при похмурій погоді та в сутінках. Предмети яскравих кольорів (червоного, жовтого, білого) здаються ближчими, ніж предмети темних кольорів (чорного, синього, сірого). Група людей здається завжди ближче, ніж одна людина на такій же відстані; людина, що лежить здається далі, ніж людина, що стоїть; на рівній та одноманітній місцевості (в лузі,
зброї солдат
Видно риси обличчя, руки, деталі стрілецької зброї
Видно очі у виді крапок
Видно білки очей
м
м
м
м Вимірювання відстані кроками Вимірювання відстані кроками в порівнянні з іншими способами застосовуються обмежено, тільки в тих випадках, коли дозволяє обстановка.
Рахунок ведуть парами кроків. Щоб вимірювану відстань перевести в метри, треба знати довжину кроку. Вона визначається з проміру кроками лінії, довжина якої відома або точно виміряна заздалегідь. Якщо пройдена відстань визначена досить наближено, то приймають, що відстань в метрах дорівнює числу пар кроків, збільшеному в півтора рази, так як пара кроків в середньому дорівнює 1,5 м.
Для точних результатів треба пройти відрізок у 100 м і розділити на отриманий середній результат. Наприклад, при вимірюванні відстані отримаємо 54 та 56 пар кроків. Середнє число пар кроків 55. Довжина пари кроків буде: 100 м : 55 = 1,8 м. По відрізках місцевості. Цей прийом полягає в здатності спостерігача подумки представляти на місцевості звичні відстані, наприклад 100, 200, 300, 400 м. Відкладаючи ці відрізки в своїй пам’яті, спостерігач подумки відкладає потрібний відрізок в глибину стільки раз, скільки він вкладеться до спостережуваного предмета. За ступенем видимості предмета. Визначаючи відстань цим прийомом, потрібно враховувати, на якому тлі місцевості знаходиться предмет (ціль) і поблизу яких інших предметів він розташований. Визначаючи відстань за ступенем видимості предметів, необхідно також враховувати що: дрібні предмети (кущі, горби, каміння), а також окремі фігури людей знаходяться дальше, ніж знаходяться на тій же відстані великі предмети (ліс, висота, населений пункт, колона); одноколірний, одноманітний фон місцевості (луг, сніг, рілля) якби наближає предмети, які знаходяться на ньому; різнокольоровий фон, навпаки, маскує і якби віддаляє їх; предмети світлих кольорів краще видно, ніж предмети темного кольору; при
рук і ніг людини, що йде
Ґудзики і пряжки
Риси обличчя людини, кисті рук
Визначення відстаней

а вишка висотою 20 м — 5 мм. Отже, відстань до будинку — 300 м, до вишки — 2 000 м ( іл. 29.1 ). Для впевненого використання у бойовій практиці цього способу необхідно знати розміри деяких місцевих предметів, бойової техніки противника та інші. Наприклад, легко запам’ятати, що середній зріст людини — 1,7 м. Відстань між стовпами лінії зв’язку —
кола ( іл. 29.2 а ).

ження ( іл. 29.3 б ) і прицілювання ( іл. 29.3 в ) тощо.

Іл. 29.3 а. Шкала бінокля, перископа

29.3 б. Шкала бокових поправок оптичного прицілу ПСО-1

29.3 в. Приціл автомата, кулемета Під час виміру кутів у тисячних називають і записують число сотень, потім число десятків і одиниць тисячних. Якщо сотень і десятків немає –називають і записують нулі. Наприклад, величини кутів у тисячних 343, 52 і 2 записуються як 3-43, 0-52 і 0-02, а вказуються «три, сорок три», «нуль, п’ятдесят дві» та «нуль, нуль дві».
Із залежності між кутовими та лінійними величинами, відстань (дистанцію) до предметів у метрах визначають за формулою:
D = B K 1000, де B — висота (ширина) предмета, K — кутова величина предмета.

Приклад . Спостерігач в
помітив висування
( іл. 29.4 ).
Рішення . Кутовий розмір сільського будинку, що спостерігається

кля (0-10), його висота 6 м. Відстань до противника — 600 м. Іл. 29.4. Визначення відстані за шкалою бінокля
Таким чином, знаючи величину приладів спостереження (прицілювання) у тисячних та розміри цілей противника, наприклад, танка (довжина, ширина або висота) і місцевих предметів (будинок, стовп тощо), поблизу яких знаходиться


Звідси можна визначити, що вона пройшла близько 7,5 км від вихідного пункту.
Визначення відстані за співвідношенням швидкості звуку і світла Звук розповсюджується у просторі зі швидкістю 330 м/с, або 1 км за 3 с, а світло — практично миттєво. Таким чином, відстань у кілометрах до місця, де пролунав постріл, дорівнює числу секунд, які пройшли від моменту спалаху до моменту, коли був почутий звук пострілу, поділеному на 3. Наприклад, спостерігач почув звук пострілу через 9 секунд після спалаху гармати. Відстань до місця спалаху: D = 9 : 3 = 3 км. Визначення
Визначення відстані побудовою трикутника на місцевості застосовується для визначення ширини непрохідних ділянок місцевості (боліт, мінних полів). На іл. 29.6 а показано визначення ширини річки побудовою рівнобедреного трикутника, у якого катети рівні, тобто ширина річки АВ дорівнює довжині катета АС .
Точку А вибирають так, щоб з неї було видно орієнтир (точка В) на протилежному березі і при цьому була
можливість вздовж берега виміряти відстань, що дорівнює ширині ріки. Точку С визначають методом наближення, вимірюючи кут


вимірювати відстань між точками.
Щоб виміряти відстань між двома точками:
1. На комп’ютері, Android, iPhone та iPad відкрийте Карти Google.
2. Натисніть початкову точку правою кнопкою миші.
3. Виберіть Виміряти відстань .
4. Натисніть будь-яке місце на карті, щоб створити шлях, відстань якого хочете виміряти. Щоб додати іншу точку, натисніть будь-яке місце на карті.
Унизу карти ви побачите загальну відстань у милях і кілометрах. Порада . Щоб перемістити точку або шлях, натисніть і перетягніть їх. Щоб вилучити точку, натисніть її.
5. Закінчивши, унизу картки натисніть значок .

1. Що необхідно пам’ятати при визначенні відстані окомірно?
2. Як виміряти відстані кроками та по відрізках місцевості?
3. Що необхідно також враховувати, визначаючи відстань за ступенем видимості предметів?
4. В чому сутність визначення відстаней за лінійними
5.
нами.
6. Як визначити відстані за часом руху, співвідношенням швидкості звуку і світла?
7. Чому відстань, визначена за допомогою слуху,
людини може бути різною?
8. В чому сутність визначення відстані побудовою трикутника на місцевості?

9. Розв’яжіть приклади:
9.1. Солдат противника під час атаки у повний зріст закривається по висоті великою вертикальною поділкою (рискою) сітки бінокля. Визначити відстань до цілі.
9.2. Піхота противника під прикриттям танків веде наступ. Визначити відстань до противника, якщо танк по ширині закривається мушкою автомату.


картах Рельєфом
( іл.
)
сукупність різних нерівностей на земній поверхні. Розрізняють основні форми рельєфу: гора (горб), хребет, улоговина, сідловина,
місцевості на планово-картографічних матеріалах зображають за допомогою відповідних умовних знаків, що повинні відповідати таким умовам: докладно й точно показувати розміщення всіх форм його нерівностей, що характеризують розчленованість та уступоподібність місцевості; забезпечувати
висот окремих точок місцевості

щоб найкраще уявляти справжній
місцевості.
На сучасних топографічних
зонталями, що доповнюються абсолютними позначками та бергштрихами ( іл. 30.2 ).

Спосіб горизонталей для зображення рельєфу земної поверхні
запропонував в 1791 р. Жан Дюпен-Тріель для побудови карти Франції. Цей спосіб найоб’єктивніший, простий, надає змогу геометрично найточніше передати форму рельєфу та відобразити його особливості.




суші) ставків, озер є горизонталями. Іл. 30.3. Принцип зображення рельєфу

(б)
Задану віддаль h між сусідніми січними площинами називають висотою перерізу рельєфу ( іл. 30.3 а ). Висоту перерізу можна також визначити як різницю висот двох сусідніх
винні горизонталі (напівгоризонталі) через половину основного перерізу рельєфу пунктирними лініями з довжиною рисочок 4 мм і відстанню між ними 1–2 мм. Якщо подробиці рельєфу не можна зображені половинними, застосовують допоміжні горизонталі , які проводять також пунктирними лініями, тільки з коротшими рисочками, ніж у половинних ( іл. 30.3 б ). Горизонталі та інші умовні знаки природних форм рельєфу зображають коричневим кольором, а штучні форми рельєфу — чорним. На картах горизонталі викреслюють суцільними лініями коричневого кольору завтовшки 0,1 мм. Для збільшення виразності рельєфу і полегшення читання карти, якщо висота перерізу рельєфу 1, 5, 10, 20 і 40 м, кожну п’яту основну горизонталь з позначками, кратними відповідно 5, 25, 50, 100 і 200 м, зображають товстішою (0,25 мм) коричневою лінією. Такі горизонталі називаються потовщеними . За висоти перерізу 2,5 м потовщують кожну четверту горизонталь з позначками, кратними 10 м. Висоту основних
кут нахилу місцевості більшим — за величиною закладання (за відстанню між горизонталями) можна визначити крутизну схилу в градусах; найкоротша відстань між двома горизонталями — перпендикуляр до них, що відповідає напряму найбільшої крутизни. Отже, напрям схилу в кожній його точці перпендикулярний до горизонталей; вододільні лінії та осі видолинків перетинаються горизонталями під прямим кутом; горизонталі на карті не перетинаються (за винятком зображення найбільшого уступу) і зберігають подібність відповідних їм ліній на місцевості, утворених у результаті уявного перерізу рельєфу площинами. Отже, горизонталі на карті точно передають форми рельєфу, їхнє розміщення та поєднання. Зазначмо, що горизонталі не дають наочного просторового уявлення про рельєф місцевості. Гора зображується замкненими горизонталями ( іл. 30.4.1 ) й котловина ( іл. 33.4.3 ) зображується та-
кими самими замкненими горизонталями, і відрізнити їх
можна тільки за напрямком схилів. Для цього на одній або
кількох горизонталях проводять скат-штрихи (бергштрихи) убік пониження схилу.

Хребет ( іл. 30.4.2 ) і лощина ( іл. 30.4.4 ) зображуються горизонталями, що мають витягнуту Іл. 30.4. Зображення типових форм рельєфу горизонталями: 1 — гора (висота); 2 — хребет; 3 — котловина; 4 — лощина; 5 — сідловина форму: у хребта — убік пониження, а в лощини — підвищення. У хребта скат-штрихи проводять від горизонталі з випуклої
Для сучасних карт
Масштаб 1 : 2000 – 0,5 м, 1,0 м, 2,0 м
1 : 5000 – 0,5 м. 1,0 м, 2,0 м
1 : 10000 – 1,0 м, 2,0 м
1 : 25000 – 5,0 м, 10,0 м
Висоту перерізу рельєфу підписують
табом (наприклад, «Суцільні горизонталі проведені через 10 м).
При даній висоті перерізу рельєфу чим
тим він вищий,
таль з відміткою 200 проходить
Це означає, що сарай розміщений на висоті 200 м.


Іл. 30.5. Абсолютні й відносні висоти точок
Іл. 30.6. Визначення висот і взаємного перевищення точок по карті У разі, коли горизонталь не має підписаної відмітки, її значення визначають за відмітками інших горизонталей або висот точок місцевості. Наприклад, потрібно визначити висоту точки місцевості, на якій перебуває окремий камінь ( іл. 30.6 ). Умовний знак окремого каменя розміщений на горизонталі без відмітки. Штрихи (покажчики схилів) на горизонталях показують, що схил знижується убік струмка. Ліворуч від горизонталі з окремим каменем знаходиться стовщена горизонталь з відміткою 200. Висота перерізу дорівнює 10 м. Отже, горизонталь, яка проходить через умовний знак окремого каменя, має позначку 190, яка і є висотою точки.
Якщо точка розташована між горизонталями , то її абсолютну висоту визначають за значенням відмітки висоти
Для цього до значення відмітки висоти горизонталі додають
мають (залежно від положення
Наприклад, потрібно визначити висоту розвилки польових доріг ( іл. 30.6 ). Точка розміщена приблизно на 3/4 величини закладання від нижньої горизонталі, що має відмітку 220, і на 1/4 — від верхньої горизонталі з відміткою 230. Висота перерізу рельєфу дорівнює 10 м. Унаслідок цього поправка до нижньої горизонталі становить 7,5 м, а до верхньої горизонталі
метів (лісу, кущів, будівель тощо) над рівнем землі. Такі дані беруть або з карти (надписів), або за даними розвідки місцевості.
Взаємну видимість точок визначають за картою одним із таких способів. Спосіб зіставлення висот точок. Визначення за картою взаємної видимості зводиться до того, щоб, не перебуваючи на місцевості, встановити наявність перешкод (топографічних елементів місцевості) у напрямку між точкою спостереження і об’єктом (ціллю). Користуючись горизонталями, розглядають за картою рельєф місцевості вздовж напрямку, за яким передбачається вести спостереження, і встановлюють, які нерівності або місцеві предмети можуть закривати видимість. Потім визначають по горизонталях абсолютні висоти спостережного


Іл. 30.7. Укриття нижче спостерігача (СП) і цілі (Ц) Іл. 30.8. Укриття


залежати від форми цього схилу (іл. 30.10), на рівному і вигнутому схилах всі точки звичайно спостерігаються, якщо не перешкоджає рослинність або місцеві предмети, а на випуклому і хвилястому схилах такої видимості може і не бути. Іл 30.11. Визначення взаємної

взаємній видимості. У таких випадках питання про наявність взаємної видимості необхідно вирішувати шляхом графічних креслень, застосовуючи спосіб побудови трикутника або побудови скороченого

Іл. 30.12. Побудова повного профілю Спосіб побудови профілів місцевості дає змогу найточніше позначити на карті поля невидимості. Профілем називають креслення, яке зображає переріз місцевості вертикальною площиною. Напрямок на карті, уздовж

в даній смузі місцевості, ділянки, які не проглядаються із жодного спостережного пункту, рекомендовано зафарбувати
цем: червоним
розташуванні супротивника, синім — у нашому розташуванні ( іл. 30.13 ). Правила користування навігатором Навігаційна апаратура призначена для
системи GPS NAVSTAR забезпечити в автономному режимі позиціювання
транспортних засобів.
12-канальні кодові приймачі з вбудованою антеною здатні приймати диференційні поправки від системи WAAS/EGNOS. Індивідуальна переносна навігаційна апаратура споживачів супутникових навігаційних систем ГЛОНАСС та GPS NAVSTAR СН-3003М «БАЗАЛЬТ-М» призначена для оснащення військових частин та підрозділів ракетних військ та артилерії Сухопутних військ ЗСУ та частин топографічної служби ЗСУ, безперервного визначення координат, часу, напряму і швидкості руху в будь-якій точці земної кулі за сигналами СНС ГЛОНАСС, GPS NAVSTAR та видачі їх на пристрій індикації, по стандартному інтерфейсу в зовнішні системи ( табл. 33.2 ). Таблиця 33.2. Основні ТТХ СН-3003М «БАЗАЛЬТ-М»

Точність визначення координат/ висоти в автономному режимі роботи:
GNSS ГЛОНАСС GPS
Точність визначення координат/ висоти в диференційному режимі роботи
Похибка визначення вектору швидкості GNSS
ГЛОНАСС GPS
10-20/15-35 м 10-30/15-50 м 25-40/70 м
5 м / до 7 м
0,1 м/с 0,1 м/с 0,5 м/с
Системи координат WGS-84, ПЗ-90, СК-42 Перетворення координат: з СК-42 в WGS-84; з WGS-84 в СК-42; з СК-42 та WGS-84 в системи UTM (Universal Transverse Mercator) та MGRS (Military Grid Reference System); Напруга живлення 10-30 В Потужність споживання 7 Вт Габаритні розміри 176×195×65 мм Маса 1,8 кг Портативний 12-канальний

динат місця, часу і
GPS-приймачі орієнтування на місцевості Garmin-GPS-12XL, Garmin-GPSеМАР та Garmin-МАР 276С , основні

шляхових точок точка 1000 Кількість маршрутів/точок у
з 500 точок, автоматизований трек на 2500 точок
Картографічна
OUT
PAGE — використовується для прокручування
сторінок і повернення із сторінки підменю. Натиснувши та утримуючи в даному положенні більше 1 с для виклику вікна вибору режиму (автомобільний або морський);
QUIT — служить для прокручування послідовності основних сторінок в зворотному порядку, а також для відновлення попереднього значення в полі введення даних або скасування непотрібної операції; ENTER/MARK — призначена для вибору виділеної опції меню. При введенні даних ця кнопка дозволяє почати введення і потім прийняти обрані значення. Якщо ця кнопка натиснута і утримується вданому положенні більше однієї секунди, ваше поточне місцеположення буде відзначено шляховою точкою; MENU — служить для перегляду опцій поточної сторінки. Для виклику головного меню потрібно двічі натиснути на кнопку MENU; NAV/MOB — використовується для виклику навігаційного меню.
FIND — дозволяє провести пошук шляхових точок користувача, міст, потрібних об’єктів, установ і т.д.;
POVER — натисніть та утримуйте у натиснутому положенні більше 1 с для включення і виключення приладу. При короткочасному натисканні використовується для регулювання підсвічування екрану і гучності зовнішнього динаміка; ARROW KEYPAD (кнопка із стрілками) — використовується для вибору опцій меню і введення даних. Здійснює
Для включення та виключення приладу необхідно:
1. Натиснути на червону кнопку POVER та утримувати її у натиснутому положенні. Після включення пристрою
звуковий сигнал і на екрані з’явиться сторінка з попередженням/інформацією.
2. Для переходу до наступної сторінки натиснути кнопку ENTER/MARK.
3. Після включення, приймач почне приймати сигнали супутника. На розрахунок місцеположення може піти декілька хвилин. Навігація за маршрутом здійснюється таким чином: Опція «Navigate Route» (навігація по маршруту) дозволить вибрати із списку маршрут для руху. Для руху за визначеним маршрутом:
1. Натиснути на кнопку NAV/MOB.
2. За допомогою кнопки із стрілками
3.
опцію «Navigate Route» (навігація
ENTER/MARK.

1. Що таке рельєф?
2. Чим на сучасних топографічних картах позначають рельєф?
3. Що таке висота рельєфу і чи є вона постійною величиною?
4. Що таке горизонталі? Які є види горизонталей?
5. Які властивості горизонталей?
6. Як визначають абсолютні та відносні висоти за топографічною картою?
7. Навіщо потрібно визначати зони видимості?
8. Які правил роботи з навігатором?


Визначення
координат Як відомо, паралелі та меридіани є елементами градусної сітки, за допомогою якої визначають географічні координати об’єкта. За топографічною картою (іл. 31.1) їх можна визначити
Пригадайте з предмета «Географія», що таке екватор, паралель, меридіан, широта, довгота. Іл. 31.1. Визначення географічних координат за топографічною картою Системою географічних
за вертикальною рамкою, що зміщення відбулося на 2 точки, тобто на 20» убік зростання широти. Кількість мінут не змінилася. Тому географічна широта точки г. Малиновська становить 54°40’20» пн. ш . Аналогічні дії проведемо для визначення довготи (λ). Підписаний меридіан — це права внутрішня рамка карти — 18°07’30» сх. д. Прикладемо лінійку вздовж правої рамки карти і плавно пересуватимемо її паралельно до цієї лінії до заданої точки. Так, за горизонтальною мінутною рамкою та
позначками секунд помітимо, що зміщення відбулося на 2’27» убік зменшення значення довготи. Тобто географічна довгота точки г. Малиновська — 18°05’03» сх. д.
Визначення прямокутних координат На топографічних картах нанесена прямокутна (кілометрова) сітка, яка дає змогу встановити прямокутні координати будь-якої точки на карті. Прямокутні координати — це система координат, у якій віссю X прийнято осьовий меридіан 6-градусної зони, а віссю Y — екватор. Саме ці дві лінії (осьовий меридіан і екватор) під час проектування зони на поверхню циліндра стають прямими взаємно перпендикулярними лініями, решта меридіанів і паралелей є кривими. Точка перетину осьового меридіана і екватора є початком прямокутних координат кожної зони.
Прямокутні координати пока-
зують відстань у кілометрах до да-
ної точки від екватора (координата X , яка може змінюватися від 0 до
понад як 10 000 км на полюсах)
і від осьового меридіана (коорди-
ната Y , яка може змінюватися від 0 до 333 км на екваторі в місцях
його перетину з крайніми західни-
ми і східними меридіанами зони) ( іл. 31.2 ).
На топографічні карти нанесе-
но лінії через кожний 1 км або 2

км і паралельні осям X та Y . Вони Іл 31.2. Зональна система прямокутних координат
утворюють кілометрову сітку, що покриває карту системою однакових за площею квадратів. Біля рамок карти підписані значення ліній кілометрової сітки. Двозначні
( іл. 31.3 ). Відшукаємо квадрат, у якому
Спершу визначимо координату Х . Найближча горизонтальна лінія кілометрової сітки до точки має підпис 6065. Це означає, що до цієї лінії від екватора 6065 км, або 6 065 000 м. За допомогою лінійки визначимо, що г. Дідова Гора розташована на карті на 1 см південніше за цю лінію. У масштабі 1:25 000 це відповідає відстані на місцевості 250 м. Оскільки на південь відстань до екватора скорочується, то 250 м треба відняти від значення 6 065 000 м, тобто: 6 065 000 м – 250 м = 6 064 750 м. Отже, X — 6 064 750.

Іл. 31.3. Визначення прямокутних координат за топографічною картою
Аналогічно за вертикальними лініями кілометрової сітки визначимо координату Y . Як бачимо, г. Дідова Гора розташована між вертикальними лініями з координатами Y (у метрах) 4 811 000 та 4 312 000, але ближче до другої, не
6 064 750 м на
від екватора.
ша цифра координати Y «4» означає, що точка лежить у 4-й геодезичній зоні. Осьовий меридіан цієї
має координату Y 4 500 000. Тому решта
осьовий
ан 4-ї зони на 188 100 м (4 500 000 м –– 4 811 900 м = 188 100 м). Використовуючи кілометрову
також

1. Пригадайте, де і в який спосіб у рамці топографічної карти показано поділ на мінути та секунди.
2. Якому значенню дорівнює відстань між двома сусідніми точками біля зовнішньої рамки карти?
3. Пригадайте, що означають числові
4.



Пригадайте з уроків історії та правознавства, що таке правова основа будь-якої діяльності.
Цивільний захист (ЦЗ) — це функція держави, спрямована на захист населення, територій, навколишнього природного середовища та майна від надзвичайних ситуацій ( іл. 35.1 ) шляхом
ям, ліквідації їх наслідків і надання


безпеки України, а також акти Президента та КМУ . Основними завданнями і заходами держави у сфері ЦЗ є запобігання виникненню НС, захист населення і територій від НС, ліквідація НС та їхніх наслідків, а також ті, що сприяють їх виконанню, як-от створення і підтримка в постійній готовності системи оповіщення, планування заходів ЦЗ на мирний час і особливий період, здійснення державного нагляду (контролю) та інші. Для виконання завдань, спрямованих
або проведення робіт із запобігання та ліквідації наслідків; медичну допомогу, соціально-психологічну підтримку та медико-психологічну реабілітацію в разі отримання фізичних і психологічних травм.
Громадяни України зобов’язані: дотримуватися правил поведінки, безпеки та дій у надзвичайних ситуаціях; дотримуватися заходів безпеки у побуті та повсякденній трудовій діяльності, не допускати порушень виробничої і технологічної дисципліни, вимог екологічної безпеки, охорони праці, що можуть призвести до надзвичайної ситуації; вивчати способи захисту від надзвичайних ситуацій та дій у разі їх виникнення, надання домедичної допомоги постраждалим, правила користування засобами захисту; повідомляти службі екстреної допомоги населенню про виникнення надзвичайних ситуацій; у разі виникнення надзвичайної ситуації до прибуття аварійно-рятувальних підрозділів вживати заходів для рятування населення і майна; дотримуватися протиепідемічного, протиепізоотичного та протиепіфітотичного режимів, режимів радіаційного захисту; виконувати правила пожежної безпеки, забезпечувати будівлі, які їм належать на праві приватної власності, первинними засобами пожежогасіння, навчати
поводженню з вогнем. Іноземці та особи без громадянства, які перебувають
права й повинні виконувати такі ж
винятками тих, які
ними договорами України.
Виконання завдань, які
цивільного захисту

такі
Єдина державна система цивільного захисту (ЕДСЦЗ) — сукупність органів
ганів виконавчої влади, місцевого самоврядування, підприємств, установ й організацій, які забезпечують державну політику в галузі цивільного захисту в мирний час і в особливий період. ЕДСЦЗ складають: органи управління; сили, призначені для виконання завдань цивільного

їни з надзвичайних
(ДСНС
( іл. 32.2 ). До сил цивільного захисту належать: 1) оперативно-рятувальна служба ЦЗ; 2) аварійно-рятувальні служби; 3) формування ЦЗ; 4) спеціалізовані служби ЦЗ; 5) пожежно-рятувальні підрозділи (частини); 6) добровільні формування ЦЗ.

Іл. 32.3. Робота оперативно-рятувальної служби цивільного захисту

Іл. 32.4 Емблема Державної служби медицини катастроф

Іл. 35.2 Автомобілі центру екстреної медичної допомоги та медицини катастроф Оперативно-рятувальна служба цивільного захисту функціонує в системі Державної служби України з надзвичайних ситуацій (ДСНС) (іл. 32.3). Особливим видом аварійно-рятувальних служб є Державна служба медицини катастроф ( іл. 32.4, 32.5 ), яка діє в складі центрів екстреної медичної допомоги та медицини катастроф.
Для ліквідації наслідків НС відповідно
можуть залучатися ЗСУ, інші військові формування та правоохоронні органи спецпризначення.
ЄДСЦЗ діє на державному, регіональному, місцевому і об’єктовому рівні. Вона, залежно від масштабів і особливостей НС, функціонує у режимах: 1) повсякденного функціонування; 2) підвищеної готовності; 3) надзвичайної ситуації; 4) надзвичайного стану або воєнного положення. Режим повсякденного функціонування ЕДСЦЗ встановлюється за умов нормальної виробничо-промислової, радіаційної, хімічної, сейсмічної, гідрометеорологічної, техногенної і пожежної обстановки, гідрогеології, за відсутності епідемій, епізоотій тощо.
Режим підвищеної готовності ЕДСЦЗ встановлюють у межах конкретної території у разі істотного погіршення виробничо-промислової, радіаційної, хімічної, епідемічної, сейсмічної, гідрометеорологічної обстановки, за наявності загрози виникнення НС. Режим надзвичайної ситуації ЕДСЦЗ встановлюється в разі виникнення НС, залежно від масштабу,
На об’єктах господарювання за типовою схемою, враховуючи особливості об’єкта, створюються служби ЦЗ: 1) оповіщення і зв’язку; 2) медична; 3) радіаційного та хімічного захисту; 4) охорони громадського порядку; 5) протипожежна; 6) енергопостачання та світломаскування; 7) аварійно-технічна; 8) сховищ та укриттів; 9) транспортна; 10) матеріально-технічного постачання та інші.
Організація навчання населення діям у НС. Відповідно до
Кодексу цивільного захисту навчання населення діям у НС здійснюють: 1) за місцем роботи — працюючого населення; 2) за місцем навчання — здобувачів освіти; 3) за місцем про-
живання — непрацюючого населення.
Навчання працюючого населення діям у надзвичайних ситуаціях є обов’язковим і здійснюється в робочий час за рахунок коштів роботодавця за програмами підготовки населення діям у надзвичайних ситуаціях, а також під час проведення спеціальних об’єктових навчань і тренувань з питань цивільного захисту. Навчання здобувачів освіти діям у надзвичайних ситуаціях
пожежної безпеки є обов’язковим і здійснюється під час освітнього процесу дітей старшого дошкільного віку за навчальними
навчальних дисциплін та планами
тренувань з
цивільного захисту за рахунок коштів, передбачених
освіти, що забезпечують здобуття
рівня. Для підвищення якості освітнього процесу з дітьми та учнями з питань захисту життя, формування культури безпеки і норм поведінки у надзвичайних ситуаціях у закладах дошкільної освіти щороку проводяться Тижні безпеки дитини, у закладах
— Дні цивільного захисту. Непрацююче населення самостійно вивчає пам’ятки та інший інформаційно-довідковий матеріал з питань цивільного захисту, правила
ситуації, у зоні яких або у зоні можливого
ситуаціями.

1. Що таке цивільний захист і яка
2.
4.
5.
6.

людей (через аварії, катастрофи, стихійні лиха, епідемії, терористичні акти, збройні конфлікти тощо). Вони призводять до загибелі людей і до значних матеріальних втрат. Такі події називають надзвичайними ситуаціями (НС) .

Надзвичайна ситуація — обстановка на окремій території, суб’єкті господарювання або водному об’єкті, яка характеризується порушенням нормальних умов життєдіяльності населення, спричинена катастрофою, аварією, пожежею, стихійним лихом, епідемією, епізоотією, епіфітотією, застосуванням засобів ураження або іншою небезпечною подією, що призвела (може призвести) до виникнення загрози життю або здоров’ю населення, великої кількості загиблих і постраждалих, завдання значних матеріальних збитків, а також до неможливості проживання населення на такій території чи об’єкті, провадження на ній господарської діяльності.
НС, які можуть виникати на території України в мирний і воєнний час негативно впливають на функціонування об’єктів економіки та життєдіяльність населення. Для організації ефективної роботи із запобігання надзвичайним ситуаціям, ліквідації
наслідків, зниження масштабів втрат та збитків дуже важливо знати причини їх виникнення. Надзвичайні ситуації, відповідно до кодексу цивільного захисту, класифікують: а) за характером походження або причиною виникнення; б) ступенем поширення; в) розміром людських утрат та матеріальних збитків.
Залежно від характеру походження подій , що можуть зумовити виникнення НС на території України, визначаються такі види надзвичайних ситуацій : 1) техногенного характеру; 2) природного характеру; 3) соціальні; 4) воєнні ( іл. 33.1 ).
НС техногенного характеру
пожежі, неспровоковані вибухи чи їх загроза, аварії з викидом небезпечних хімічних, радіоактивних, біологічних

виникають вторинні
документах. НС техногенного характеру
людьми, і які вона використовує. Великі аварії та катастрофи на об’єктах можуть виникнути внаслідок стихійного лиха, а також порушень технології виробництва, правил експлуатації різних машин, обладнання і встановлених норм безпеки.
Виробничі, транспортні та побутові аварії та катастрофи за наслідками не поступаються стихійним лихам. Унаслідок техногенних аварій і катастроф виникають ситуації, які призводять до значних

( іл. 33.2 ).
нього транспортного
якої постраждали люди чи заподіяна шкода майну. На дорогах щорічно виникають десятки тисяч аварій і катастроф. Статистика свідчить, що протягом кожних 10 хв відбувається одна ДТП, кожних 2 год в автокатастрофах гине 1 особа. Основними причинами аварій та катастроф на залізничному транспорті є несправність колії, рухомого складу, технічних засобів керування, прорахунки відповідальних за безпеку руху поїздів тощо. У процесі аварії, що виникла, крім зіткнень, можливе і сходження поїздів з колії, а також виникнення пожежі й вибуху ( іл. 33.3, 33.4 ).



Статистика свідчить, що майже половина авіаційних аварій і катастроф трапляється на льотному полі, решта
на різних висотах польоту літального апарата, нерідко над малонаселеною територією землі або над водяною поверхнею. Щодо кількості постраждалих під час авіакатастроф, то тут часто діє принцип «усе або нічого».
Під час катастрофи на річковому і морському транспорті ( іл. 33.5 ) план дій на судні такий: оголошення тривоги для екіпажу й пасажирів; оцінка обстановки та вживання заходів щодо захисту людей, які перебувають на судні; підготовка рятувальних засобів, засобів для гасіння пожежі, а також механізмів захисту судна від потрапляння води. На виробництві, у побуті часто виникають вибухи газу та інших
хонебезпечних речовин , що призводить до
будівель і пожеж ( іл. 33.6, 33.7 ).

Пожежа — неконтрольований


тобто внаслідок переливу води через греблю.
наслідками гідродинамічних аварій є катастрофічні затоплення. АЕС на території України є одним з основних джерел забезпечення електричною енергією господарства країни ( іл. 39.9 ). Виробництво, транспортування, збереження і використання радіоактивних матеріалів на АЕС строго регламентовано правилами технології, техніки безпеки і контролю за їх застосуванням. Проте це не спростовує ймовірності виникнення аварій, унаслідок чого ці об’єкти називають радіаційно небезпечними . У результаті радіаційних
( іл. 36.10 ), з пошкодженого
викидають радіоактивні речовини у вигляді розпечених

Іл. 33.8. Зруйнована вибухом


пов’язаних із
іонізуючого випромінювання, належать променеві ураження — гостра променеву хворобу, радіаційні ураження шкіри, слизових оболонок, певних
організму.
До хімічно небезпечних об’єктів належать підприємства, що виробляють різноманітну хімічну продукцію, нафтопродукти, фармацевтичні препарати, а також підприємства, що мають холодоагенти, очисні споруди, залізничні станції з об’єктами відстою, склади з отрутохімікатами, сховища, транспортні трубопроводи тощо.
Під час екстремальних ситуацій природного, виробничого, транспортного характеру

рушує нормальну життєдіяльність населення, завдає матеріальних збитків.
Щорічно в Україні виникає до трьохсот НС, спричинених метеорологічними, гідрологічними та геологічними явищами. Найбільша їх кількість зумовлена метеорологічними явищами.

Іл. 33.11. Повінь

Іл. 33.12. Наслідки зсуву Повені ( іл. 33.11 ) — тимчасове затоплення значної частини суші водою в результаті розливу річок через велику кількість опадів, інтенсивне танення снігу, утворення заторів льоду під час весняного паводка, вітровий нагон води в річки з моря. Причиною повені можуть бути і завали на річках через землетруси, гірські зсуви, цунамі або гравітаційних хвиль від підводних ядерних вибухів, руйнування дамб, гребель, гідровузлів. Повені характеризуються підйомом рівня води й затопленням територій. Селевий потік — потік суміші ґрунту й води, у якому багато каміння та уламків зруйнованих гірських порід і дерев. Селеві потоки утворюються в гірських
сті дощів, швидкого танення
гірського снігу, землетрусів. Маючи значну масу і швидкість, селі руйнують дороги, сільгоспоб’єкти, населені пункти і все інше на шляху просування. Зсуви — ковзне зміщення мас гірських порід схилом під дією сили тяжіння внаслідок повені, землетрусу, послаблення міцності порід через сільськогосподарську діяльність або будівництво, які здійснюють, не беручи до уваги геологічних умов місцевості ( іл. 33.12 ). Зони зсуву захоплюють райони забудови, створюючи таким чином
ситуацій з непередбаченими наслідками. З групи метеорологічних явищ
ними стихійними лихами є бурі, урагани та смерчі. Основна причина їх виникнення — циклонічна діяльність атмосфери. Циклони Атлантичного океану зазвичай називають ураганами, а тропічні циклони західної частини Тихого океану — тайфунами.
на більшість — у липні–вересні. Вони мають циклічність, і
сприяє
ньому прогнозуванню. Урагани супроводжують зливи, снігопади, гради, блискавки, курні й снігові бурі. Ураган ламає і вириває з коренями дерева, руйнує будинки, лінії електропередачі, будинки й споруди ( іл. 33.13 ). Люди можуть потрапити під уламки зруйнованих будинків. Уламки, що летять дуже швидко, та інші предмети завдають людям важких травм. Смерч (торнадо) — атмосферний вихор, що виникає в грозовій хмарі й поширюється аж до поверхні землі. Він має вигляд стовпа, іноді з вигнутою віссю
обертання, діаметром до сотень метрів з лійкоподібними розширеннями догори й донизу ( іл. 36.14 ). Повітря в смерчі обертається проти годинникової стрілки зі швидкістю до 100 м/с й одночасно підіймається спірально, утягуючи в себе різноманітні предмети.
Середня швидкість переміщення смерчу сягає 50–150 км/год. Тривають смерчі від кількох хвилин до кількох годин, долаючи за цей час шлях від сотень метрів до десятків кілометрів. Смерч, рухаючись над землею, завдає руйнувань того ж рівня, що й сильні ураганні вітри, але на менших площах. Це пов’язано з потужною дією обертової сили повітря та різким підйомом повітряних мас догори. При цьому певні об’єкти (автомобілі, легкі будівлі, дахи будинків, люди і тварини) можуть відриватися від землі й
метрів. Урагани, бурі й смерчі — одні з найпотужніших сил стихії,



хвилі), що
ками. При цьому
що спостерігають під час землетрусів,
руйнування будинків, пожежі, вибухи,
речовин, аварії, вихід із ладу систем життєзабезпечення. За
розмірами збитків та площею ушкоджених територій, за непередбачуваністю та малоймовірністю захисту від них ці катастрофи не мають аналогів. Найскладніша ситуація виникає через землетрус у великих містах, коли руйнація будинків, споруд, комунікацій, систем газо- та водопостачання, каналізації діяльність міста порушується, виникають пожежі, з’являється значна кількість постраждалих з травмами, опіками. Унаслідок землетрусів щорічно гине в середньому 100 тис. осіб. Інтенсивне випадання снігу може призводити до утворення снігових заметів , які супроводжуються різкими змінами температури й спричиняють зледеніння доріг, ліній електропередач; паралізують роботу авто та залізничного транспорту, порушують нормальне життя населених пунктів і навіть великих міст ( іл. 33.16 ).

Іл. 33.16. Снігові замети

Іл. 33.17. Лісова пожежа

Іл. 33.18. Розряд блискавки У горах особливо небезпечними є снігові лавини , які мають велику руйнівну силу, заподіюють великих матеріальних збитків і спричиняють людські жертви. Боротьба зі сніговими лавинами має тривалий характер, її здійснюють протилавинні служби. Специфічним стихійним лихом є засуха, коли довго не випадають опади. Це призводить до зневоложення ґрунту й масової загибелі рослинності, відтак — голоду. Засухи спричиняють підвищену пожежну небезпеку і природні пожежі , наприклад, лісові пожежі ( іл. 33.17 ) — неконтрольований процес знищення вогнем об’єктів довкілля, під час якого виникає небезпека для всього живого.
Виникають пожежі зазвичай через порушення правил пожежної безпеки, а також у результаті дії блискавки, самозаймання (торф’яні пожежі), особливо під час засухи тощо. Незважаючи на те що блискавки рідко призводять до масових уражень людей, доцільно звернути увагу і на це стихійне явище природи ( іл. 33.18 ). Сила струму під час грозового електричного розряду може змінюватися від 10 000 А до 40 000 А. Повітря, через яке проходить
типу, масштабів,
особливостей регіону і населених пунктів, що опинились в районі події, об’єктів господарської діяльності. На об’єктах господарського комплексу, у т. ч. в навчальних закладах, завчасно розробляються спеціальні заходи щодо запобігання або максимального зменшення руйнівних наслідків надзвичайних ситуацій природного і техногенного характеру, можливих утрат людей і матеріальних цінностей. До таких заходів належать суворе дотримання специфічних вимог безпеки; організація оповіщення керівного складу штабів цивільного захисту і населення; спеціальна підготовка й оснащення рятувальних формувань; надання медичної допомоги ураженим і матеріальної допомоги постраждалим. Отже, у процесі навчання населення діям у надзвичайних ситуаціях розглядають проблеми безпеки людини під час надзвичайних ситуацій, шляхи зниження небезпечних та шкідливих чинників до допустимих норм, розробляють методи й засоби захисту людини та ліквідації наслідків таких ситуацій.
Соціальні НС — порушення нормальних умов життя та діяльності людей
території, об’єкті (у т. ч. водному), спричинене

33.19. Терористичний акт протиправними діями терористичного і антиконституційного
зброї та небезпечних речовин, нещасними випадками тощо ( іл. 33.19 ).

1. Яка подія називається надзвичайною ситуацією?
2. Наведіть приклади надзвичайних ситуацій техногенного характеру. Чому їх
3.
4. Які причини транспортних аварій і чим небезпечні такі аварії,

5.

Пригадайте з уроків історії (як України, так і всесвітньої), якого лиха завдавали війни, соціальні й політичні конфлікти. Чому їх наслідки зазвичай бувають катастрофічними?
Практично для будь-якої НС властиві такі загальні ознаки: загроза загибелі людей чи значне порушення умов їх життєдіяльності; заподіяння економічних збитків; істотне
Класифікація НС за їх рівнями здійснюється для забезпечення організації взаємодії центральних і місцевих органів виконавчої влади, підприємств, установ та організацій у
та ліквідацією
Для визначення рівня надзвичайної
такі критерії: 1) територіальне поширення та обсяги технічних і матеріальних ресурсів, необхідних для ліквідації наслідків НС; 2) кількість людей, які загинули (постраждали), або чиї умови життя порушено; 3) розмір збитків, завданих НС. З урахуванням територіального поширення, обсягів заподіяних
куваних економічних збитків, кількості людей, які загинули; за масштабом можливих наслідків; характеру сил і засобів, що залучаються до їх ліквідації, розрізняють 4 рівні надзвичайних ситуацій: 1) загальнодержавний; 2) регіональний; 3) місцевий; 4) об’єктовий. НС державного рівня за територіальним поширенням вважають таку, що:
1) поширилась або може поширитися на територію інших держав; 2) поширилась на територію двох чи більше регіонів України, а для її ліквідації необхідні матеріальні й технічні ресурси в обсягах, що перевищують можливості цих регіонів (понад один відсоток відповідних бюджетів);
3) яка призвела до загибелі понад 10 осіб, або внаслідок якої постраждало понад 300 осіб, або було порушено нормальні умови життя понад 50 тис. осіб більш як на 3 доби;
4) спричинила збитки, що складають понад 150 тис. мінімальних


1)
відповідних бюджетів);
2) призвела до загибелі 3–5 осіб або внаслідок якої постраждало 50–100 осіб, чи було порушено нормальні умови життєдіяльності 1000–10 000 осіб довше ніж на 3 доби;
3) завдала збитків, що складають понад 15 000 мінімальних розмірів заробітної плати.

Так, повінь на Закарпатті— стихійне лихо, що сталося через інтенсивні опади, різке підняття рівня



1.
2.
3. Як поділяються НС за вагомістю впливу на людей?
4. На які категорії поділяють аварії, що можуть бути причиною НС?


Поміркуйте, чому для
чинники ураження населення.
ситуацій утворюються внаслідок руйнування атомних і гідроелектричних станцій, складів і сховищ радіоактивних і токсичних речовин та відходів, нафтопродуктів, вибухівки, сильнодіючих отруйних речовин, токсичних відходів, транспортних та інженерних комунікацій.
Війни знищували значні людські і матеріальні ресурси, сприяли поширенню інших лих, гальмували розвиток людства. Зброя ставала все потужнішою, а наслідки її використання
ядерну зброю, яка може
випробувань цієї зброї, моделювання обстановки,
планеті. Після
унаслідок застосування системи залпового
13 га будуть знищені всі споруди і майже 82 % живої сили супротивника. Засоби радіоелектронної боротьби , які застосовуються в сучасній війні для дезорганізації управління військами, не знищують матеріальні засоби (споруди і техніку), але надзвичайно шкідливі для людини.
Розглянемо наслідки використання різних видів зброї для життєдіяльності людини.
Звичайна зброя. Триває розробка й надходження на озброєння армій звичайних засобів ураження, таких як вогнепальна зброя , що має значну вбивчу силу, підвищену дальність і велику точність ураження. Часто використовують стрілецьку зброю ( іл. 35.1 ). Потрапляючи в тіло людини, куля спричиняє деструктивні зміни, розриває м’які тканини й порожнисті органи, великі судини, нерви, трощить кістки, змінює при цьому напрямок руху, тому рановий канал має зигзагоподібний хід із рваним вихідним отвором і масивними ушкодженнями. Під час війни України з Російською Федерацією та великої
терористичних
у
значне збільшення постраждалих із мінно-вибуховою травмою, яка
токсичні продукти ( іл. 35.2 ). Внаслідок використання



не завжди можна вчасно поховати. Погіршання умов життєдіяльності населення, недостатнє забезпеченням усім необхідним, зростання популяцій гризунів і комах, які є переносниками хвороботворних мікроорганізмів, призводять до появи осередків інфекційних захворювань .
Цьому сприяє недостатнє медичне обслуговування, нестача ліків, забезпечення якими ускладнено. Порушується робота лікувальних закладів, що призводить до зростання загальної захворюваності населення . Треба враховувати, що сучасна війна не обходиться без значних руйнувань, під час яких виникають загрози життю людини. Важливою є техногенна й екологічна небезпека. Хімічні підприємства, нафтопереробні заводи в разі їх часткового або повного руйнування призводять до техногенної катастрофи і є джерелом небезпеки для здоров’я і життя людей, подібної до тієї, що виникає в разі застосування хімічної зброї. Особливу увагу слід приділяти катастрофам, які можуть виникнути під час руйнування внаслідок бойових дій екологічно небезпечних об’єктів, таких як гідро- та атомні електростанції (ГЕС, АЕС). Наслідки катастрофічні — затоплені території, перервані комунікації, зруйновані підприємства, відсутня електрична енергія і, звісно, значні людські жертви. Аварія на АЕС, за небезпеками, які виникають, може бути подібною до застосування супротивником ядерної зброї малої
Важливо пам’ятати, що першочерговим
таких руйнувань, але війна є війна і такі небезпеки можуть виникати. Війна

НС воєнного часу — необхідна умова підготовки людей до можливих бойових дій. Тому потрібно розробляти комплексні заходи підготовки населення, діяльності місцевої
ких ситуацій.


тиск повітря. Вона майже миттєво охоплює і стискає тіло людини, відкидає його швидкісним натиском повітря, крім того, з великою швидкістю летять уламки стін будівель, дерева, каміння, скло та інші предмети. У людей виникатимуть різні травми: розриви, розчавлення, вивихи, переломи, значні кровотечі, ушкодження внутрішніх органів та інші травми від механічної дії уламків.
Унаслідок дії світлового випромінювання ядерної зброї у виживших осіб можуть виникати опіки відкритих ділянок тіла, тимчасова сліпота й опіки очей, а також опіки від полум’я пожеж. Тяжкість опіків у постраждалих залежить від температури вибуху, яка сягає мільйонів градусів. Дія проникної радіації зумовлюється потоком γ-променів і нейтронів із зони ядерного вибуху, що триває лише перші 10–15 с. Біологічна дія проникної радіації проявляється залежно від кількості поглинутої тканинами організму радіаційної енергії, її розподілу
одноразового опромінення дозою 1–2 грей (Гр) розвивається гостра
ступеня (середньої тяжкості), 5–6 Гр — ІІІ ступеня (тяжка
(вкрай тяжка форма). Радіоактивне зараження місцевості
трапляння радіоактивних речовин в організм у разі вживання заражених продуктів харчування та води, а також під
ні ураження шкірних
Електромагнітний імпульс призводить до виникнення наведених
теле- і радіоапаратура, порушиться на певний час зв’язок, можуть спостерігатися
розлади в організмі людини.
ураження, яке поширюється вітром, робить перебування на
води й продуктів харчування. Основу хімічної зброї складають
(ОР), які відповідають визначеним технічним вимогам, мають певні фізико-хімічні та надзвичайно токсичні властивості, що забезпечують найбільшу бойову ефективність під час використання.
Застосування ОР утворює осередки хімічного зараження — територію, де є люди, техніка, джерела водопостачання, продукти й інші об’єкти, що зазнали дії хімічної зброї.
Основними засобами доставки ОР до місця призначення є авіаційні хімічні бомби й касети, керовані й некеровані хімічні снаряди або ракети, артилерійські хімічні снаряди та міни, хімічні фугаси, термічні й механічні генератори аерозолів, а також шашки, гранати і патрони ( іл. 35.5 ), які зберігаються в спеціально обладнаних сховищах під особливим контролем ( іл. 35.6 ). Іл. 35.5. Хімічна




осередків застосовують крапельно-рідинні ОР. Розроблено
кацій отруйних речовин, в
яких лежать імовірність їх використання в сучасній війні, тактичне призначення, характер токсичної дії, стійкість. Широко застосовують табельні отруйні речовини (ті, що прийняті на озброєння), резервні й обмеженого призначення . За тактичним призначенням , ОР поділяють на такі групи: а) ОР смертельної дії; б) ОР, що призводять до тимчасового розладу діяльності організму (цей поділ доволі умовний, тому що ОР смертельної дії в малих дозах можуть діяти як такі, що тимчасово виводять організм із ладу, а у великих дозах вони мають смертельну дію); в) ОР, що на короткий час виводять ор-
стійкістю ОР поділяють на дві групи: а) стійкі ; б) нестійкі . Найпоширенішою є класифікація ОР за токсичною
(CS), Сі-Ар (CR), адамсит; психохімічної дії: Бі-зет (BZ). У ряді держав розроблені
єння
компонентів, із яких
і транспортування таких
рення високотоксичної ОР. Проводяться експерименти щодо змішування кількох типів ОР, синтезуються нові ОР, зокрема з використанням токсинів та отрут різних представників фауни та флори, а також відходів виробництва. Можливе широке використання хімічної зброї для зараження водних ресурсів. Бойові отруйні речовини (нервово-паралітичної та шкірно-наривної дії) проникають в організм людини не тільки через дихальні шляхи, слизову оболонку очей та шлунок, але й через відкриті непошкоджені ділянки шкіри. Якщо не застосувати заходів індивідуального захисту, можливий великий відсоток утрат людей. дей, тварин і рослин, зараження місцевості, споруд, техніки, води й продуктів харчування. Під час Першої

світ.
р. о 3 год 30 хв німецька армія вперше в історії застосувала хімічну

дей будь-якої пори року ( іл. 35.8 ). Застосовують
зброю за допомогою авіабомб, ракет, снарядів, мін; виливних пристроїв та генераторів аерозолів; контейнерів із комахами й тваринами.
Ураження відбувається під час вдиханні аерозолів, а також через збудників хвороб або токсинів під час дихання, споживання їжі, через руки і через комах.
Як біологічну зброю можна використати такі збудники інфекційних захворювань, як-от: чума, натуральна віспа, сибірка, пситакоз, туляремія, бруцельоз, лихоманка Ку, жовта лихоманка тощо, а також токсин ботулізму (сильна біологічна отрута).
Розробки в цьому напрямі тривають у спеціальних лабораторіях із застосуванням такого сучасного методу, як генна інженерія, коли непатогенним мікроорганізмам надають властивостей небезпечних збудників. На збудник, створений цим методом, не впливають наявні в медицині лікарські препарати, і це створює
людства в мирний час у разі випадкового потрапляння такого збудника
( іл. 35.9 ).

1. Які види зброї використовуються під час воєнних дій?
2. Які фактори ураження ядерної зброї?
3. Чим небезпечна хімічна зброя? За якими ознаками і на які групи поділяють бойові ОР? Наведіть приклади.
4. Чим небезпечна біологічна зброя? Як відбувається ураження нею?
5. Які особливості застосування й ураження людини звичайною зброєю?
6. Які небезпеки загрожують у воєнний час унаслідок антисанітарних умов?


Поміркуйте й скажіть, чи є у вашому
потенційно небезпечними об’єктами (ПНО) , тобто такими, на яких використовують, виготовляють, переробляють, зберігають чи транспортують небезпечні речовини та біологічні препарати. Небезпечними називають біологічні, хімічні, токсичні, вибухові, окислювальні, займисті речовини. До біологічних препаратів належать речовини біологічного походження, що небезпечні для життя і здоров’я людей та довкілля.
Є об’єкти, на яких наявна реальна загроза виникнення аварії
порушення умов експлуатації (наднормативний
вин, пожежа, вибух тощо). Вона може призвести до небезпечної
надзвичайної ситуації техногенного характеру. З метою захисту від таких аварій, населення має знати фактори ураження кожної з них. Потенційно небезпечними об’єктами вважають: хімічні підприємства та виробництва; військові об’єкти та підприємства з виробництва вибухових речовин і
боєприпасів;
підприємства та установи, що мають виробництво ядерних матеріалів (радіоактивні відходи), використовують та зберігають їх; підприємства з виробництва та постачання електричної та теплової
енергії;
металургійні, машинобудівні та металообробні підприємства й виробництва;
підприємства з видобування руд та нерудних копалин;
підприємства з виробництва будівельних матеріалів;
підприємства з обробки деревини;
підприємства легкої промисловості;
підприємства з виробництва та обробки тваринних продуктів;
підприємства з виробництва харчових продуктів та смакових речовин; санітарно-технічні споруди комунального призначення; гідроспоруди; об’єкти транспорту; трубопроводи та споруди на них; заправні станції; сховища газу, нафти і нафтопродуктів; склади небезпечних та шкідливих речовин; об’єкти водопостачання та водовідведення. За видом небезпечних речовин, що їх використовують у виробничому
на: а) пожежовибухонебезпечні (ПВНО); б)
§ 36. Надзвичайні
( іл. 36.1 ). Аварії на таких підприємствах
знищення

Іл. 36.1. Нафтобаза

Іл. 36.3. Жидачівський целюлозно-паперовий комбінат

Іл. 36.2. ПАТ «ДНІПРОАЗОТ»

Іл. 36.4 Лисичанський нафтопереробний завод Хімічно небезпечними є підприємства хімічної ( іл. 36.2 ), целюлозно-паперової ( іл. 36.3 ), нафтопереробної ( іл. 36.4 ), металургійної промисловості; пов’язані з виробництвом добрив, соди, кислот; з великими запасами сильнодіючих отруйних речовин (СДОР) і транспортні магістралі для їх перевезення. На таких підприємствах є також накопичувачі, у яких збираються забруднені води, які можуть заподіяти значної шкоди довкіллю. У разі аварії на хімічно небезпечному об’єкті з розливом СДОР утворюється зона хімічного зараження, яка охоплює місце розливу СДОР і територію, над якою поширилася хмара зараженого повітря з концентрацією, яка призводить до ураження. Найімовірнішими СДОР, спроможними викликати масові отруєння, необхідно вважати хлор, аміак, азотну кислоту, оксиди азоту, чадний газ, сірчистий ангідрид, сірковуглець, синильну кислоту, деякі інсектициди та ряд інших сполук.
СДОР спроможні призвести до уражень не тільки людей, але й тварин, рослин, території, спричинивши серйозні екологічні наслідки. СДОР можуть проникати в організм через дихальні шляхи, шкірні покриви, слизові оболонки очей і шлунково-кишкового тракту, надходячи з їжею або
водою.

Іл. 36.5 Рівненська АЕС Радіаційно небезпечними об’єктами є атомні електростанції (АЕС) ( іл. 36.5 ), виробництва ядерного палива, переробки та поховання радіоактивних відходів тощо. Аварії на таких об’єктах супроводжуються викидом радіоактивних речовин (РР) в атмосферу,
підприємства металургійної, вугільнодобувної промисловості, полігони для зберігання твердих побутових відходів, тваринницькі комплекси, транспортні комунікації тощо. Загалом Державний реєстр України містить дані про понад 24 тис. потенційно небезпечних об’єктів. Гідротехнічні споруди призначені для використання водних ресурсів і для боротьби зі шкідливим впливом водної стихії. Це греблі ( іл. 36.6 ), дамби, вали, канали, шлюзи ( іл. 36.7 ), трубопроводи, тунелі, моли, водосховища, хвостосховища ( іл. 36.8 ) та інші інженерні споруди, які призначені для отримання електроенергії, покращення судноплавства або
забору води для водопостачання



Підприємства металургійної
атмосферу викидами оксидів
вуглецю, сірчаного ангідриду, пилу, сажі та інших шкідливих речовин. А вода, яка використовується для охолодження, забруднюється механічними речовинами, нафтопродуктами, сульфатами, хлоридами та іншими хімічними речовинами. На цих підприємствах завжди є накопичувачі, у яких збираються великі об’єми відходів виробництва. У діяльності таких підприємств слід передбачити можливі аварійні ситуації, які можуть призвести
промислових підприємств, яке перегниває і розкладається, та внаслідок фільтрації може бути причиною забруднення підземних водоносних джерел токсичними відходами ( іл. 35.14 ).

Іл. 35.12. ВАТ «Запоріжсталь»

Іл. 35.13. Трипільська

Іл. 35.14. Зберігання твердих відходів

Іл. 35.15. Аварія з розливом бензину
Діяльність великих тваринницьких комплексів може призводити до забруднення сечею поверхневих водоносних
виникне проблема забезпечення населення та
тварин чистою водою. Тому, споруджуючи тваринницькі
сті для сечі і гною з такою міцністю, щоб унеможливити попадання відходів тваринництва у відкритий ґрунт. Транспортні аварії , як аварії на потенційно небезпечному об’єкті, здебільшого, пов’язані з перевезенням небезпечних речовин ( іл. 35.15 ). Іноді автомобільні аварії супроводжуються вибухами, пожежами, викидами отруйних речовин, потраплянням автомобілів у прірву, воду. Часто вони зумовлені технічними несправностями, поганим станом доріг, людським фактором.
Боротьба з наслідками ДТП буде ефективною лише за умови широкого впровадження комплексу науково обґрунтованих заходів, спрямованих на підвищення рівня безпеки дорожнього руху. Найбільша кількість аварій припадає на автотранспорт, однак і на залізничному, повітряному, водному і трубопровідному транспорті вони виникають часто. Значна частина постраждалих під час транспортних аварій гине від неякісного надання домедичної допомоги, хоча травми деколи і не бувають смертельними. Масштаби і наслідки транспортних аварії принципово не відрізняються від аварій на інших потенційно небезпечних об’єктах, де виробляють або застосовують такі ж небезпечні речовини, і визначаються видом транспорту і кількістю вантажу, який
ситуації.
Запобігання аварій на потенційно небезпечних
ні, розміщенні, будівництві,
підприємств, споруд та інших
дженні нових технологічних процесів та устаткування, а
сі експлуатації
подбати про екологічну безпеку людей, раціональне використання природних ресурсів, додержання нормативів шкідливих впливів на довкілля. При цьому мають бути передбачені вловлювання, утилізація, знешкодження шкідливих речовин і відходів або повна їх ліквідація, виконання інших
ров’я людей.

1. Поясніть терміни: техногенна навантаженість території, потенційно небезпечні об’єкти.
2. У яких галузях народного господарства є потенційно небезпечні об’єкти?
3. На які групи поділяють потенційно небезпечні об’єкти за видом небезпечних речовин? Наведіть приклади.
4. Які небезпеки можуть виникати у разі аварій на вибухо- пожежорадіаційно- хімічнонебезпечних об’єктах?
5. Поясніть, чим небезпечні гідродинамічні аварії, великі водосховища; нафто-, газо-, аміакопроводи; аварії на підприємствах металургійної промисловості, об’єктах енергетики; полігони



У Кодексі ЦЗ сформульовані принципи
ються захисту населення: гарантування та забезпечення державою конституційних прав громадян на захист життя, здоров’я та власності; пріоритетності завдань, спрямованих на рятування життя та збереження здоров’я громадян. Для їх реалізації необхідно виконати основні заходи забезпечення захисту населення в надзвичайних ситуаціях , до яких належать: повідомлення про загрозу і виникнення надзвичайної ситуації та постійне інформування про обстановку; навчання населення вмінню застосовувати засоби індивідуального захисту і діяти в надзвичайних ситуаціях; укриття людей у сховищах, медичний, радіаційний та хімічний захист, евакуація з небезпечних районів; спостереження та контроль за ураженістю навколишнього середовища, продуктів харчування та води радіоактивними, отруйними, сильнодіючими отруйними речовинами та біологічними препаратами;
організація і проведення рятувальних та інших робіт у районах лиха й
осередках ураження. Для виконання
сфері цивільного захисту створена
ситуацій, місцеві державні адміністрації
вання повинні здійснювати
населення щодо дій у надзвичайних ситуаціях. У колективах суб’єктів господарювання (підприємств, організацій, навчальних закладів), крім цього, працівники мають бути забезпечені засобами колективного та індивідуального захисту. Ураховуючи зазначене, кожен
1) отримання інформації
2)
організовують:
1) за місцем роботи — для працюючого населення; 2) за місцем навчання — для дітей дошкільного віку, учнів та студентів; 3) за місцем проживання — для непрацюючого населення.
Навчання учнів, студентів та дітей дошкільного віку діям у надзвичайних ситуаціях та правилам пожежної безпеки є обов’язковим і здійснюється під час освітнього процесу.
Дії за сигналами цивільного захисту
час аварії на хімічно небезпечному об’єкті. Одержавши повідомлення (по радіо або з інших
бів оповіщення) про викид (розлив) в атмосферу СДОР, виконайте вказані рекомендації. Повідомте сусідів про отриману інформацію. Надайте допомогу літнім і хворим особам. Надягніть засоби індивідуального захисту органів дихання та найпростіші засоби захисту шкіри (за відсутності табельних засобів використовуйте поліетиленову плівку, прогумовані плащі, гумові чоботи, рукавички). Швидко вийдіть з хімічного вогнища в напрямку, вказаному працівниками цивільного захисту, або самостійно у бік, перпендикулярний напрямку вітру. Оминайте тунелі, яри, улоговини: у низинах може бути висока концентрація СДОР. Вийшовши із зони зараження, зніміть засоби захисту, верхній одяг, ретельно вимийте очі, ніс та рот, за можливості якнайшвидше прийміть душ. Якщо засобів індивідуального захисту немає і вийти з району аварії неможливо, залишайтесь у приміщенні, але негайно та надійно герметизуйте його! Мінімізуйте можливість проникнення СДОР (парів, аерозолів) у приміщення: щільно зачиніть вікна та
заклейте димоходи, вентиляційні люки, щілини в рамах вікон та дверей, вимкніть джерела газо-, електропостачання та загасіть вогонь у пічках, чекайте повідомлень органів влади з питань надзвичайних ситуацій через
інформації. Можна уникнути уражень, перебуваючи на верхніх поверхах вашого будинку. Для
молоко, сік, вода); якщо є підозра на ураження СДОР, негайно зверніться до медичного закладу. У разі аварії на атомній електростанції. Почувши звуки сирен і гудків, потрібно ввімкнути радіо- і телевізійні приймачі, прочитати повідомлення в мобільному телефоні. Відповідно
укритися в сховищі, підвалі або в будівлі, де застав сигнал. У будівлі зачинити вікна, двері, вентиляційні отвори, загерметизувати
одяг, взуття, речі туалету, постільну білизну, документи, найцінніші речі й гроші в екстрену валізу. Упакуйте все в поліетиленові мішки, чекайте підходу автотранспорту. З підходом автотранспорту або в призначений час у квартирі потрібно вимкнути газ, воду, електроприлади тощо, надягти плащ з капюшоном, рукавички, зимове взуття, узяти речі, зачинити квартиру (будинок) і попрямувати до місця посадки.
Під час повені. Вимкніть нагрівальні пристрої, одягніть дітей, візьміть документи, найцінніші речі та гроші, запас продуктів і води (загальна маса речей на одну людину не повинна перевищувати 50 кг). З підходом автотранспорту для забезпечення евакуації або перед тим, як самостійно вирушити на збірний евакуаційний пункт, вимкніть у квартирі газ, воду, електро-прилади тощо, візьміть речі, зачиніть квартиру (будинок). Суворо дотримуйте вимог і вказівок представників цивільного захисту. Повітряна тривога (ПТ). Усе населення зобов’язане укритися в захисних спорудах! Якщо сигнал застав вас: удома — негайно вимкніть нагрівальні прилади, газ, воду, одягніть дітей, візьміть засоби індивідуального захисту, медичну аптечку, документи, необхідні речі, запас продуктів і води, вимкніть освітлення і швидко йдіть у сховище (укриття); за можливості, попередьте сусідів; на роботі — ужийте заходів для безаварійної зупинки виробництва (відповідно до інструкції) та йдіть в укриття; на вулиці — швидко прямуйте в найближче сховище чи укриття; у громадському
тролейбусі, трамваї
укриття. У разі відбою повітряної тривоги (Відбій ПТ).
штабу цивільного захисту через радіотрансляційні мережі, телефонні канали зв’язку, а також з пересувних гучномовних установок про те, що повітряна тривога минула, організовано за командою адміністрації залишіть захисну споруду. Приступайте
Ураховуючи
1)
що виникли
з вадами зору та слуху формі;
2) забезпечення засобами колективного
1) дотримувати
2)

1.
2.
3.

4.


гігієни, медикаменти, інструменти, предмети самооборони
харчування.
Усі речі в тривожній валізі
ними) і не використовуватися в повсякденному побуті.
Цивільна тривожна валіза призначена тільки для максимально швидкої евакуації знебезпечноїзони(території де відбуваються землетрус, потоп, пожежа, підвищена криміногенна обстановка, епіцентр воєнних дій тощо).
Правильно укомплектована тривожна валіза має забезпечувати автономне життя людини в більшості екстремальних ситуацій, коли поблизу немає води, їжі, тепла, даху над головою. Тривожна
ній родині.
Труднощі під час комплектації. Формування тривожної валізи може займати
вають на тривалість процесу комплектації, перераховані

комплекту в повсякденному житті.
Наплічник. Правильно вибраний наплічник забезпечить надійність, зручність і не-обхідну місткість. В ідеалі наплічник краще вибирати такий, до моделі якого ви звикли, але якщо такого немає, то в принципі для тривожної валізи цілком придатний будь-який туристичний наплічник. Обсяг наплічника вимірюється в літрах. За обсягом вибирають наплічник залежно від того, скільки речей у ньому планується нести. Краще придбати наплічник тільки після того, як основна частина предметів буде зібрана і можна буде адекватно оцінити той об’єм наплічника, який потрібен.
Наплічники бувають кількох типів ( іл. 38.2 ):
1. «Колобки» ( іл. 38.2 а ). Наплічник — це безформний речовий мішок з брезенту, тканини чи іншого матеріалу, що має дві лямки. Завантажений до межі «колобок» не дуже зручний для носіння, тому що центр ваги не розподіляється на спину і таз, а зосереджений в одній точці. За рахунок цього біг, подолання перешкод та інші активні дії з такими наплічниками утруднені — за наявності важкого вантажу може «перекинути» власника через зміщений в сторону центр ваги. Має мінімальний обсяг, що варіюється в межах від 20 до 60 л. З плюсів подібного роду



Наплічник: а) «колобок»; б) анатомічний; в) станковий
2. Анатомічні наплічники ( іл. 31.2 б ). Цей різновид наплічників — це мішок із синтетичної тканини, що має у своїй конструкції елементи з різних легких сплавів і пла-стику, що надають наплічнику форми. Наплічник має «спину» — частина наплічника, що прилягає
тривалих піших подорожей, коли є необхідність перенесення великогабаритних вантажів. Рама кріпиться до наплічника з боку спини і дає
прикріплювати до неї додатковий вантаж. Станкові наплічники травмонебезпечні, тому що під час падіння трапляються випадки ушкодження хребта об жорстку металеву раму.

Тому найкраще в якості «валізки» використовувати «колобок» або анатомічний наплічник, які відносно недорогі, травмобезпечні, доволі зручні та комфортні для носіння, гнучкі, мають регульований обсяг та легкі. Комплектація тривожної валізи. Численні рекомендації радять покласти в екстрену валізу якомога більше речей, найчастіше дійсно необхідних (наприклад сокиру, пилку). Але розширювати нескінченно екстрений комплект не можна, бо реальна маса такої «валізи» стає просто непідйомною для людини. І з цим необхідно рахуватися. Загалом, проблема маси головна проблема під час формування екстреного наплічника. Тривожна валіза комплектується на 40–50 % під конкретну людину. І цілком можливо, що для себе можна взяти якісь речі, не згадані нижче. Це
місцевості, в якій
проживаєте, інших факторів список
приклад, для людей похилого віку чи дітей.
Отже, для надзвичайних ситуацій, описаних вище, повинен бути напоготові якісний надійний наплічник з такими речами і продуктами. 1. Копії важливих документів у водонепроникній упаковці ( іл. 38.3 ). Заздалегідь необхідно зробити копії паспортів, автомобільних прав, документів, що доводять права на нерухомість, автомобіль тощо. Документи укласти потрібно так, щоб їх легко можна було дістати. Якщо є можливість відсканувати документи, то не завадить

УКХ/FM діапазону та запасними батарейками для нього. У продажу є недорогі приймачі з динамо-машинкою для живлення. Приймач дає змогу стежити за тим, що відбувається. Можна взяти недорогий мобільний телефон із зарядним пристроєм.
6. Ліхтарик , а краще кілька, із запасними батарейками і лампочками для нього.
7. Компас і годинник. Купувати водонепроникні.
8. Ніж і топірець .
9. С игнальні засоби (свисток, фальшфейєр).
10. Пакети для сміття ємністю 120 л. Штук 5. Може замінити тент, якщо розрізати.
11. Рулон широкого скотчу .

Іл. 38. 4. Мультитул
12. Мультитул ( іл. 38.4 ) — багатофункціональний інструмент. Зазвичай він виглядає як складні пасатижі, у ручках якого заховані додаткові інструменти (ніж, шило, пила, викрутка, ножиці і багато іншого).
13. Упаковка презервативів (12 штук без коробки, без мастила і ароматизаторів). Може знадобитися в багатьох ситуаціях.
14. Шнур синтетичний , діаметр 4–5 мм, довжина — 20 м.
15. Блокнот і олівець .
16. Нитки та голки .
17. Аптечка першої необхідності . Кількість ліків розрахована на надання допомоги не тільки собі, а й іншим: бинти, лейкопластир, йод, вата; активоване вугілля (інтоксикація); «Парацетамол» (жарознижувальний); «Супрастин» (алергія); «Іммодіум» (діарея); «Фталазол» (кишкова інфекція); «Альбуцид» (очні краплі); антибіотики в пігулках.
18. Постійні ліки , які ви вживаєте постійно, готують на тиждень із зазначенням дозування та способу застосування. Імена та телефони ваших лікарів. Стежити за терміном придатності ліків.

Іл. 38.5. Одяг
19. Одяг , а саме: накидка від атмосферних опадів з капюшоном, всесезонна куртка, нижня білизна (2 комплекти), шкарпетки бавовняні (2 пари), запасні штани, сорочка або кофта, в’язана шапочка, рукавиці, шарф, надійне і зручне взуття ( іл. 38.5
20. Міні-палатка
21. Гігієнічні
в супермаркетах), туалетний папір, кілька упаковок сухих хусток, кілька носових хусток, вологі серветки. Жінкам — засоби особистої гігієни. Можна взяти бритву і манікюрний набір.
22. Товари для дітей .
23. Посуд : казанок, фляга, ложка, кружка (краще металева 0,5 л), розкладний стаканчик.
24. Сірники (краще туристичні). Запальничка .
25. Запас їжі на кілька днів . Все, що можна їсти без приготування і що займає мало місця, довго зберігається. Питна вода на 1–2 дні, яку потрібно періодично оновлювати. Висококалорійні солодощі (дуже добрий для цього чорний шоколад, який досі використовується тактичними військовими групами). Пригорща льодяників.
26. Продукти : 2 банки з гарною тушонкою; галети; супові пакети; м’ясні чи рибні консерви; якщо є місце: будь-яка крупа, макарони, сухі
напівфабрикати.
27. Горілка або медичний спирт .
28. Сімейні цінності , реліквії, але тільки після упаковки
нішого.
Пакування речей у тривожній
та ефективності виживання.
дощу і мокрого снігу.
Є кілька варіантів, як приховати наплічник від негоди:
ник; використовувати спеціальну
ти наплічник,
людини. Тому
метів, можна


сучасних гіпермаркетах
великий: є харчові контейнери, медичні, контейнери для рибалок / туристів / мисливців тощо. Однак захоплюватися контейнерами не варто, тому що використання контейнерів зменшує вільний об’єм наплічника. Як укладати речі в наплічник , точної відповіді немає. Вважають, що важкі речі доцільно розташувати ближче до спини, у нижній частині наплічника. Основна маса має бути на рівні плечей. Однак найбільш використовувані речі, наскільки важкими вони б не були, усе-таки краще покласти у верхню частину наплічника
додаткові ки-шені, якщо вони є.
Групувати речі найкраще за категоріями в поліетиленових пакетах. Речі в наплічнику потрібно зберігати таким чином, щоб чітко знати, що де лежить і не змішувати різні за використанням предмети. Продукти харчування не можна класти разом із ліками, а елементи гігієни не слід зберігати з інструментами побутового призначення. Предмети і речі, які часто використовують (дощовик, засоби для розпалювання вогню, аптечка), необхідно зберігати так, щоб доступ до них було легко дістатися. Для цього часто використовувані предмети краще класти в окремі додаткові кишені наплічника (або одягу) або укладати їх поверх інших речей екстреного комплекту.

1. Що ви розумієте під поняттям «тривожна валіза»?
2. З якими труднощами можна зіткнутися під час комплектації тривожної валізи?
3. Який тип наплічника найкраще

4.
5.
6.

здійснюється в захисні споруди цивільного захисту (ЦЗ) — інженерні споруди, призначені для захисту населення. До захисних споруд належать: 1) сховище — герметична споруда для захисту людей, у якій протягом певного часу створюються умови, що виключають вплив на них небезпечних факторів, які виникають внаслідок НС, воєнних (бойових) дій та терористичних актів;
2) протирадіаційне укриття — негерметична споруда для захисту людей, у якій створюються умови, що виключають вплив на них іонізуючого опромінення в разі радіоактивного забруднення місцевості;
3) швидкоспоруджувана захисна споруда ЦЗ — захисна споруда, яку зводять із спеціальних конструкцій максимально швидко для захисту людей від дії засобів ураження в особливий період. Для захисту людей від деяких факторів небезпеки, що виникають внаслідок надзвичайних ситуацій у мирний час, та дії засобів ураження в особливий період також використовуються споруди подвійного призначення та найпростіші укриття.
Споруда подвійного призначення — це наземна або підземна споруда, що може бути використана за основним функціональним призначенням і для захисту населення, наприклад метрополітен ( іл. 39.1 ), гірничі (шахтні) виробки. Іл. 39.1 Станція метрополітену

Сховища забезпечують надійний захист людей від факторів ураження усіх НС, зокрема й від найбільш небезпечних: проникаючої радіації, бойових отруйних речовин і бактеріальних




міцності огороджувальних конструкцій ( іл. 39.2 ), а також завдяки санітарно-гігієнічних умовам, що забезпечують нормальну життєдіяльність людей ( іл. 39.3 ). Найпоширеніші вбудовані сховища, які, зазвичай, розміщені в підвальних приміщеннях і цокольних поверхах виробничих, громадських чи житлових будівель. Можливе також будівництво сховищ,як окремо розташованих споруд ( іл. 39.4 ).
Такі сховища повністю або частково заглиблені й обсипані зверху і з боків ґрунтом. До них можуть бути під’єднані підземні переходи і галереї. За місткістю сховища поділяються на малі (до 150 осіб), середні (150–450 осіб) і великі (понад 450 осіб).

Іл. 39.4. План-схема окремо розташованого сховища: 1 — входи; 2 — передні тамбури; 3 — тамбури; 4 — приміщення для укриття людей; 5 туалети;
6 — насосна фекальних вод;
7 — вентиляційна камера;
8 — камери забору повітря
Приміщення, призначене для розміщення населення, розраховане на певну кількість осіб: на одну людину передбачено не менш як 0,5 м2 площі підлоги і 1,5 м3 внутрішнього об’єму. Основне приміщення сховища складається з відсіків для 50–75 осіб. У відсіках обладнують двоярусні нари-лавки для сидіння та лежаки. Місця для сидіння влаштовують розміром 0,45×0,45 м, а для лежання — 0,55×1,8 м.
Для того щоб у приміщення не потрапляло повітря, заражене радіоактивними, отруйними і бактеріальними речовинами, їх герметизують. Слід подбати про максимальну щільність стін і перекриття, а також відповідне обладнання входів і технологічних отворів. Фільтровентиляційний агрегат забезпечує вентиляцію приміщень сховища й очищення зовнішнього

так званий підпор ).
Сховище має зазвичай не менше двох входів, розташованих протилежно. Кожен вхід обладнаний захисними герметичними
та внутрішніми дверима, між ними — тамбур. У вбудованому сховищі, крім того, має бути аварійний вихід.
Системи енерговодопостачання, опалювання та каналізації сховищ пов’язані з відповідними зовнішніми мережами. На випадок їх ушкодження в сховищі мають бути переносні електроліхтарі, резервуари для зберігання аварійного запасу води, а також місткості для збирання нечистот. Опалювання надходить від загальної опалювальної мережі. Крім того, у приміщеннях сховища повинні бути комплект засобів для ведення розвідки (прилади радіаційної та хімічної розвідки, дозиметричні прилади), захисний одяг, засоби для гасіння пожежі, аварійний запас інструментів, засоби аварійного освітлення, запас продовольства і води на дві й більше доби на кожну людину. Протирадіаційні укриття (ПРУ). Ступінь радіоактивного забруднення місцевості, який
доходить до безпечних
герметичних захисних спорудах, де рівень
Захисні властивості ПРУ оцінюють коефіцієнтом захисту, який показує, у скільки разів рівень радіації на відкритій місцевості на висоті 1 м вищий від рівня радіації в укритті. Іншими словами, коефіцієнт захисту

Необхідно пам’ятати, що найпростіші укриття здебільшого
Усе населення повинно мати можливість укриватися в надійніших спорудах
і протирадіаційних укриттях. Ефективність захисту людей від радіаційної та хімічної
жить не лише від технічної
людей у захисних спорудах, обладнаних складним устаткуванням, але й від підготовки населення до використання захисних споруд за різних умов, що склалася, коли кожен має вміти знайти правильне рішення для захисту свого життя та здоров’я. Час перебування населення в захисних спорудах визначають штаби ЦЗ об’єктів господарського комплексу. Вони встановлюють, крім того, порядок дій і правила поведінки населення під час виходу зі сховищ і укриттів.

Правила перебування в захисних спорудах. Укриття в захисних спорудах і перебування в них здійснюють за командою штабів ЦЗ. Як правило, люди розміщуються групами за місцем роботи
проживання. Кожному / кожній надають місце для розміщення його / її індивідуальних засобів захисту та інших необхідних речей. Для літніх і хворих осіб, а також
Заборонено заводити в сховище тварин, заносити легкозаймисті, вибухонебезпечні та громіздкі речі. У захисних спорудах треба діяти організовано, без потреби не ходити, виконувати вказівки чергового персоналу. За необхідності, допомагати хворим і постраждалим.
Виходити зі сховища дозволено тільки за командою уповноважених осіб.

1. Для чого призначені захисні споруди? Охарактеризуйте їх.
2. Від яких факторів ураження захищають сховища і як вони обладнуються?
3. Що таке протирадіаційні укриття? Наведіть приклади. Які в них захисні властивості?
4. Якими бувають найпростіші укриття? Від чого вони захищають?
5. Які правила перебування в захисних спорудах?

6. Поділіться своїм досвідом перебування в сховищі і протирадіаційному укритті (укритті) під час повітряних тривог.

Повідомлення (оповіщення)
та
ведення
управління
никнення НС, аварій, катастроф, епідемій,
місцевих органів виконавчої влади, підприємств, установ, організацій та населення.
Оповіщення та інформування населення про загрозу й виникнення надзвичайних ситуацій, у тому числі
та слуху формі, покладається на місцеві державні адміністрації та органи місцевого самоврядування. Воно полягає у своєчасному доведенні такої інформації до органів управління цивільного захисту, сил цивільного захисту, суб’єктів господарювання та населення. Оповіщення про загрозу або виникнення надзвичайних ситуацій забезпечується шляхом:
1) функціонування загальнодержавної, територіальних, місцевих автоматизованих систем централізованого
або виникнення надзвичайних ситуацій;
2) централізованого використання інтернет-мереж загального користування, мереж мобільного та стаціонарного зв’язку, загальнонаціонального, регіонального та місцевого радіомовлення і телебачення та інших технічних засобів передавання інформації; 3) функціонування в населених пунктах,
вання людей сигнально-гучномовних пристроїв та електронних інформаційних табло для передачі інформації з питань цивільного захисту. Інформацію з питань цивільного захисту становлять

Іл. 40.1. Комплексна система інформування населення Серед завдань цивільного захисту першочерговою є своєчасність, надійність оповіщення населення про лихо, що насувається. З уроків історії вам уже відомо, що з давніх-давен, коли десь траплялася біда або комусь загрожувала небезпека, люди, почувши дзвони або биття на сполох (набат), збиралися на віче, дізнавалися про те, що трапилося, і приймали рішення щодо боротьби з небезпекою. Так і тепер: приховувати інформацію про небезпеку не можна. Люди мають знати обстановку, і тільки тоді можна розраховувати на розумні й свідомі дії, усунення паніки й інших негативних явищ. Це збереже життя багатьом тисячам людей. Завивання сирен ( іл. 40.2 ), переривчасті гудки підприємств, транспортних засобів означають попереджувальний сигнал оповіщення цивільного захисту

небезпеку тих, у кого немає радіо, телевізора, мобільного Інтернету, а також тих, хто працює в полі, лісі, на будівництвах і в інших віддалених місцях, використовують мобільні телефони, пересувні гучномовні установки на автомобілях, посланців (кур’єрів). Отже, основний спосіб оповіщення населення — передача повідомлення по радіо, телебаченню, через мобільний та стаціонарний зв’язок.

сті, зміст звернення може змінюватися.
Отже, у місті прозвучали сирени, мешканці отримують повідомлення на мобільні телефони, увімкнули радіоприймачі, телевізори, Інтернет і можуть почути повідомлення штабу ЦЗ приблизно такого змісту. У випадку аварії на хімічно небезпечному об’єкті: «Увага! Говорить штаб цивільного захисту міста. Громадяни! Трапилася аварія на бавовняному комбінаті з викидом в атмосферу хлору — сильнодіючої отруйної речовини. Хмара зараженого повітря поширюється у ... (такому-то) напрямку. До зони хімічного зараження потрапляють … (такі-то вулиці, квартали, райони). Жителям вулиць ... (таких-то) із приміщень не виходити. Зачинити вікна, двері, здійснити герметизацію квартир (будинків). У підвалах, нижніх поверхах не ховатися, тому що хлор важчий за повітря і затікатиме в низинні місця й підвали будинків. Мешканцям вулиць ... (таких-то) негайно залишити квартири, установи, підприємства за планом евакуації і виходити в райони ... (такі-то). Повідомте про це сусідам. Слухайте і читайте наші повідомлення. Далі дійте відповідно до
очікується випадіння радіоактивних опадів. У зв’язку із цим населенню, що мешкає в зазначених пунктах, необхідно перебувати в приміщеннях. Забезпечте
цивільного захисту» . Після перших поштовхів землетрусу:
захисту.
У зв’язку з
поштовхами землетрусу вживайте необхідних заходів безпеки. Вимкніть газ, електрику, перекрийте воду. Візьміть необхідний одяг, документи, продукти харчування, воду і виходьте на вулицю. Надайте допомогу літнім людям, хворим. Займіть місце на
електропередач.
трику, газ, самим іти в
райони (перерахувати). Там пройти реєстрацію на збірному евакопункті (вказати адресу). Про отриману інформацію сповістити сусідів, надати допомогу літнім людям і хворим. За будь-яких обставин поводьтеся спокійно, не панікуйте. Будьте уважні до наших повідомлень!» .

Залежно від умов аварії, катастрофи або стихійного лиха, а також обстановки, що склалася, зміст текстів звернення може відрізнятися від наведених вище.
Якщо виникла повітряна , хімічна або радіаційна небезпека у
воєнний час , також спочатку звучать сирени, тобто сигнал «Увага всім!», а потім передають відповідну інформацію. У разі повітряної тривоги: « Увага! Говорить штаб цивільного захисту. Громадяни! Повітряна тривога! Повітряна тривога! Вимкніть газ, перекрийте воду. Візьміть засоби індивідуального захисту, документи, запас води і продуктів харчування, вимкніть світло. Попередьте сусідів, допоможіть хворим і літнім
право на:
1) отримання інформації про надзвичайні
що
вадами зору та слуху формі;
2) забезпечення засобами колективного та індивідуального
їх використання. А також кожен / кожна зобов’язаний / зобов’язана :
1) дотримувати правил поведінки, безпеки та дій у надзвичайних ситуаціях;
2) вивчати способи захисту від надзвичайних
никнення, надання

1.
2.
3.

пов’язка, які захищають органи дихання від радіоактивного
і деяких видів бактеріальних засобів, але не придатні
речовин. Протипилову тканинну маску ПТМ-1 ( іл. 41.1 ) виготовляють самостійно за викройками і лекалами відповідного розміру з 4–5 шарів тканини, ретельно підганяють під рельєф обличчя для щільного прилягання до поверхні шкіри. Ватно-марлеву пов’язку ( іл. 41.2 ) виготовляють самостійно. Важливо знати, що зав’язки перехрещують, нижні зав’язують на тімені, верхні — на потилиці, чим забезпечують щільне прилягання пов’язки до шкіри обличчя: зверху — на
одягають окуляри.

Іл. 41.1. Протипилова тканинна маска ПТМ-1
1 — корпус
маски;
2 — оглядові
отвори;
3 — кріплення;
4 — гумова тасьма;
5 — поперечна
гумова смужка;
6 — зав’язки

Іл. 41.2. Виготовлення ватно-марлевої пов’язки (розміри у см)
Респіратори та фільтрувальні протигази. Респіратори використовують для захисту органів дихання від радіоактивного, промислового і ґрунтового пилу. Найпоширеніші респіратори Р-2 і ШБ-1 («Пелюстка»).
Респіратор Р-2 ( іл.
матеріалом від тонкодисперсного пилу.
вдиху потрапляє в підмасковий
— в органи дихання. Під час видихання повітря з підмаскового простору виходить через клапан видиху.

Іл. 41.3. Респіратори: а) Р-2; б) робота в респіраторі Р-2; в) «Пелюстка»; г) використання респіратора «Пелюстка»
Респіратор ШБ-1 («Пелюстка») ( іл. 41.3. в, г ) виготовляють зі спеціального матеріалу, який має високі фільтрувальні властивості. Це респіратор одноразового користування, його розмір універсальний, він широко застосовувався для захисту дихальних шляхів від радіоактивного пилу під час ліквідації наслідків аварії на Чорнобильській АЕС. Респіратори надягають за

«Респіратор надягти!» або самостійно. Після зняття респіратора необхідно провести дезактивацію, тобто видалити пил із зовнішньої поверхні напівмаски щіткою або витрусити. Внутрішню поверхню протирають вологим тампоном і просушують. Респіратор не захищає очі. Для захисту очей потрібно надягати окуляри, конструкція яких унеможливлює потрапляння пилу до очей. Респіратор необхідно зберігати в поліетиленовому пакеті, закритому за допомогою спеціального кільця. Фільтрувальні протигази призначені для захисту органів дихання, очей, шкіри обличчя від впливу отруйних, радіоактивних речовин, бактеріальних засобів та від різних шкідливих домішок, що є в повітрі. Принцип їх захисної дії заснований на очищенні (фільтрації) повітря, що вдихається людиною, від шкідливих домішок. У системі цивільного захисту нашої країни використовують фільтрувальні протигази для






вирізи для вух.
Модель цивільного протигаза ГП-7 широко використовується як
захисту дорослого населення, так і особового складу невоєнізованих формувань. Зберігається в сумці. Його
Трикотажний чохол фільтрувально-поглинальної коробки захищає її від дощу, бруду, снігу, грубодисперсних часток аерозолю. Переговорний пристрій протигаза забезпечує спілкування на відстані, а також полегшує користування технічними засобами зв’язку.
Протигаз ГП-7 одягають у такій послідовності: взяти лицеву частину обома руками за щічні
пальці зсередини тримали лямки; зафіксувати підборіддя в нижньому заглибленні обтюратора; рухом рук
догори і назад натягнути наголовник і підтягнути до упору щічні лямки.
Перед надяганням протигаза необхідно
потрапивши
Лицева частина протигаза ГП-7В має пристосування, за допомогою якого можна пити воду. Це гумова трубка з мундштуком і ніпелем, розміщена під переговорним пристроєм. Пристосування приєднується спеціальною кришкою до фляги. Крім того, лицева частина протигаза ГП-7ВМ ( іл. 41.6 ) має трапецієподібні отвори для скелець окулярних вузлів, що покращують огляд під час роботи. Також маска ГП-7ВМ, на відміну від протигазів ГП-7 і ГП-7В, має
під’єднання фільтрувально-поглинальної коробки (праворуч і ліворуч) для зручності використання протигаза. Іл. 41.6. Протигаз ГП-7ВМ

Протигаз може стати надійним засобом захисту, якщо
його підібрана за розміром і
хлорвініловою, поліетиленовою плівкою, клейонкою; пальта зі шкіри, грубого сукна або відповідно підготовлений інший одяг. До цієї групи також належить виробничий одяг — куртки і штани, комбінезони; джинсовий одяг, спортивні костюми після відповідної обробки. Вони можуть не тільки захищати від радіоактивних речовин і бактеріальних засобів, але також не пропускати певний час краплини рідких отруйних речовин. Усі ці види одягу добре захищають від радіоактивного пилу та деяких видів біологічних засобів. Для захисту ніг застосовуються чоботи (що вищі, то краще) гумові, шкіряні або з шкірозамінників. Захистити руки від ОР допоможуть гумові рукавиці, а від радіоактивного пилу і бактеріальних засобів — шкіряні й тканинні. Для захисту голови та шиї найкраще використовувати капюшони, а також різні головні убори, які запобігають осіданню пилу на волосся. Спеціальні (табельні) засоби захисту шкіри виготовляються промисловістю і при-значені для оснащення воєнізованих і невоєнізованих формувань цивільного захисту. За принципом захисної дії розрізняють ізоляційні та фільтрувальні засоби захисту.

Іл. 41.7. Герметичні індивідуальні засоби захисту Ізоляційні засоби захисту шкіри виготовляють з повітронепроникних матеріалів — спеціальної еластичної і морозостійкої прогумованої тканини. Вони можуть бути герметичними і негерметичними. Герметичні засоби ( іл. 41.7 ) захищають тіло людини від усіх можливих факторів ураження — газоподібних і краплиннорідких отруйних речовин, радіоактивних речовин, бактеріальних засобів. Зрозуміло, що газоподібні ОР проникають у негерметичні засоби. Тому вони захищають людину тільки

користовувати як захист повторно,
ним комплектом ЗФК
захисний костюм Л-1 ( іл. 41.8 ) виготовляють із прогумованої тканини, у комплекті є такі речі: куртка з
штани, які пошиті разом з панчохами; підшоломник; двопальцеві рукавиці. Окрім того, є сумка для перенесення і
розміри аналогічні розмірам захисного комбінезона (костюма). Маса комплекту

(п’ятипальцевими
гумованої тканини). Підошва захисних
гумову основу. Панчохи одягають поверх звичайного взуття і прикріплюють до ніг спеціальними фіксаторами, а до поясного паска — тасьмою. ЗЗК можна використовувати як накидку (за необхідності раптового використання), як плащ «у рукави» та як комбінезон.

Іл. 41.9. Загальновійськовий захисний комплект (ЗЗК): а) одягнений у рукави; б) у
Загальновійськовий фільтрувальний комплект
коефективний і
дихання від отруйних речовин, світлових і термічних вражаючих факторів, основних видів хімічно небезпечних речовин. Цей комплект має високі фізіолого-гігієнічні властивості, поєднання засобів захисту
основними елементами екіпірування


1.
2.
3. Із чого складається фільтрувальний протигаз? Яке його призначення, принцип дії та порядок застосування?
4. Які захисні властивості звичайних засобів захисту шкіри вам відомі? Що до них належить?
5. Які ізолюючі засоби захисту шкіри вам відомі? У чому полягає їхнє призначення, склад, правила користування?
6. У
шкіри?

1)
реабілітації; медична допомога населенню забезпечується
2) планування і використання сил та засобів закладів охорони
незалежно від форми власності;
3) своєчасне застосування профілактичних медичних препаратів та своєчасне проведення санітарно-протиепідемічних заходів ( іл. 42.2 );
4) контроль за якістю та безпекою харчових продуктів і продовольчої сировини, питної води та джерелами водопостачання;
5) завчасне створення і підготовку спеціальних
6)
7)
11)
ща, санітарно-гігієнічної та епідемічної ситуації;
12) санітарну охорону територій та суб’єктів господарювання в зоні надзвичайної ситуації;
13) здійснення інших заходів, пов’язаних з медичним захистом населення, залежно від ситуації, що склалася.

Іл. 42.1. Автомобіль служби медицини катастроф

Іл. 42.2. Проведення профілактичних щеплень

Іл. 42.3. Навчання населення способам надання домедичної допомоги
Радіаційний і хімічний захист Радіаційний і хімічний захист насе-
лення і територій передбачає:
1) виявлення та оцінку радіаційної і хімічної обстановки;
2) організацію та здійснення дозиметричного й хімічного контролю;
3) розроблення та впровадження типових режимів радіаційного захисту;
4) використання засобів колективного захисту;
5) використання засобів індивідуального захисту, приладів радіаційної та хімічної розвідки, дозиметричного й хімічного контролю аварійно-рятувальними службами, формуваннями та спеціалізованими службами цивільного захисту, які беруть участь у проведенні аварійно-рятувальних та інших невідкладних робіт, гасінні пожеж в осередках ураження радіаційно й хімічно небезпечних об’єктів та населення, яке проживає в зонах небезпечного забруднення; 6) проведення йодної профілактики рятувальників, залучених до ліквідації радіаційної аварії, персоналу радіаційно небезпечних об’єктів та населення, яке проживає в зонах можливого забруднення, радіоактивними ізотопами йоду з метою запобігання опроміненню щитоподібної залози;
7) надання населенню можливості придбання в особисте користування
го контролю;
8) проведення санітарної обробки

об’єктовому рівні .
Залежно від особливостей
види евакуації: а) обов’язкова;
б) загальна або часткова;
в) тимчасова або безповоротна.
Рішення про проведення евакуації приймають:
на державному рівні — Кабінет Міністрів України;
на регіональному рівні — обласні та міські державні адміністрації;
на місцевому рівні — районні, відповідні органи місцевого самоврядування;
на об’єктовому рівні — керівники суб’єктів господарювання.
Обов’язкову
зи:
1) аварій з викидом радіоактивних та небезпечних хімічних речовин;
2) катастрофічного затоплення місцевості;
3) масових лісових і торф’яних пожеж, землетрусів, зсувів, інших
гічних та гідрогеологічних явищ
4) збройних конфліктів (з районів можливих бойових дій у безпечні райони, які визначаються Міністерством
період).
Загальну евакуацію проводять для всіх категорій
1) можливого радіоактивного та хімічного забруднення; 2) катастрофічного затоплення місцевості з чотиригодинним добіганням проривної хвилі під
за віком чи станом здоров’я у разі виникнення надзвичайної



1) утворення
2) планування евакуації;
3) визначення безпечних районів, придатних
евакуйованого населення та майна;
4) організації оповіщення керівників суб’єктів господарювання і населення про початок евакуації;
5) організації управління евакуацією;
6) життєзабезпечення евакуйованого населення в місцях їх безпечного розміщення;
7) навчання населення діям під час проведення евакуації.
У разі виникнення загрози життю або здоров’ю громадянам України на території іноземних держав відповідні центральні органи виконавчої влади проводять їхню евакуацію.
Евакуацію матеріальних і культурних цінностей організовують у разі загрози або виникнення надзвичайних ситуацій, які можуть заподіяти шкоду, за умови, що є достатньо часу на її проведення.

Підготовка та проведення евакуації населення з небезпечних районів. Евакуаційні органи здійснюють планування евакуації, підготовку населення до евакуаційних заходів, контроль за підготовкою та розподілом усіх видів
йних перевезень, визначення станцій,
для посадки (висадки) населення, визначення маршрутів руху
пішки, практичне проведення евакуації, приймання евакуйованого населення та ведення його обліку за об’єктами, а також контроль за розміщенням і життєзабезпеченням.
про проведення евакуації евакуаційні органи уточнюють завдання керівникам об’єктів щодо проведення евакуаційних заходів, контролюють стан оповіщення населення, його збору, формування колон (через начальників


Іл.
транспортних
вістю, на
квиток; документ про освіту; трудову
свідоцтво про народження; гроші та цінності; продукти харчування і воду на
загальною масою не більш як 50 кг на кожного члена сім’ї. Дітям дошкільного віку вкладають у
оселитися за

Іл. 42.7. Пост радіаційного та хімічного спостереження
звичайних ситуацій. Для спостереження за радіаційним і хімічним станом довкілля на об’єктах господарського комплексу створюють пост радіаційного й хімічного спостереження ( іл. 42.7 ). Він є основним джерелом інформації про радіаційну й хімічну обстановку для керівників (начальників цивільного захисту) та начальників штабів ЦЗ цих об’єктів. Пост радіаційного й хімічного спостереження створюють на об’єктах господарського комплексу для спостереження за радіаційним та хімічним станом довкілля. Він є основним джерелом інформації про радіаційну і хімічну обстановку для керівників (начальників цивільного захисту) та начальників штабів
цих об’єктів.
Основні завдання поста спостереження: своєчасне виявлення радіоактивного та
й повітря; своєчасне оповіщення
тривога»;
потрапили в довкілля;
встановлення спостереження за районами, зараженими радіоактивними й отруйними речовинами (РР і ОР);
доповідь про характер зараження керівнику підприємства, установи та організації (навчального закладу),
пункту управління. Пост розгортають так, щоби з нього
приємствах; для побутових потреб (екологічних досліджень, для контролю радіаційної чистоти житлових приміщень, будівель і споруд, прилеглих до них територій, предметів побуту, одягу, будматеріалів, поверхні ґрунту на присадибних ділянках, транспортних засобів, грошових знаків (банкнот) і монет, для оцінки радіаційного забруднення лісових ягід і грибів, риби та дичини), як наочний засіб до використання в освітньому
і служб ЦЗ.
2. Спеціальні прилади хімічної
ручні) — газосигналізатор «ДОЗОР-С-М-5Н». а) Періодичного вимірювання гранично допустимих концентрацій у повітрі п’яти компонентів горючих газів та шкідливих речовин в якості горючих газів можуть виступати: природний газ — метан, пропан, бутан, вуглеводневі гази, пари нафтопродуктів, пари спиртів; в якості шкідливих речовин
вуглекислий
(сірчистий газ), сірководень; б) Видачі світлової та звукової
них норм загазованості.
3. Прилад хімічної розвідки
ступеня зараження отруйними
отруйними речовинами повітря, місцевості, техніки тощо. Принцип виявлення
отруйних речовин даним приладом заснований на лінійно-кольорометричному методі. Залежно від
колір, визначають тип отруйних речовин
цію у повітрі.
4. Радіометр-рентгенометр ДП-5В або
ний МКС-У (модернізований рентгенометр ДП-5В) призначений для вимірювання альфа-, бета-, гамма- та рентгенівського випромінювань. Прилад може використовуватися для виявлення локалізації і виміру джерел радіоактивного випромінювання різними службами контролю (персоналом атомних станцій, радіологічних лабораторій, співробітниками аварійних служб, цивільного захисту, пожежної охорони, поліції, співробітниками митних і прикордонних служб), в медицині, в армії, радіаційного моніторингу довкілля, територій і
5. Індивідуальний
ДП-24, ІД-1 або дозиметр гамма-випромінювання індивідуальний ДКГ-21, «Кадмій» (ДКС-02П).
6. Легкий захисний костюм Л-1 — на кожного.
7. Фільтруючий протигаз ГП-7В
42. Медичний, радіаційний
кожного.
8. Метеокомплект № 3 (там, де це
9. Секундомір.
10. Захисні окуляри.
11. Засоби зв’язку та оповіщення (телефон, сирена, гонг).





Іл. 42.8. Прилади для оснащення поста


а) «Терра» (МКС-05); б) ДКГ-21; в) «Кадмій» (ДКС-02П); г) «Прип’ять»МКС-У (модернізований рентгенометр; ґ) ДП-5В); д) «Пошук» (МКС-07); е) «ДОЗОР-С-М-5Н»
Обов’язки чергового спостерігача : у разі виявлення радіоактивного зараження вдягнути засоби захисту та контролювати зміни рівнів радіації через кожні 30 хв, при цьому робити
інших місцях району розташування
зовнішні ознаки використання противником хімічної та
зовнішніх ознак використання противником хімічної зброї або терористичного акту із застосуванням цієї зброї: наявність крапель мастила, плям, бризок, калюж на місцевості; зів’ялість рослин або зміна їх кольору; подразнення органів

1.
2.
заходи здійснюють для радіаційного й хімічного захисту населення і територій?
3. Що таке евакуація, які її види вам відомі?
4. У разі виникнення яких загроз організовують обов’язкову евакуацію населення?
5. Коли проводять загальну й часткову евакуацію?
6. У чому полягає підготовка та проведення евакуації населення з небезпечних районів? Що потрібно мати при собі кожному евакуйованому громадянинові?
7. Що передбачає спостереження і контроль за ураженістю навколишнього середовища, продуктів харчування та
радіоактивними, отруйними, сильнодіючими отруйними речовинами та
логічними препаратами?
8. Де створюють пост радіаційного та хімічного
яке його завдання і оснащення?


Пригадайте, що таке «надзвичайна ситуація». Дії
(воєнний) період.

період — це період функціонування національної економіки, органів державної влади, інших державних органів, органів місцевого самоврядування, Збройних сил України, інших військових формувань, сил цивільного захисту, підприємств,
що визначаються згідно з вимогами Законів
« Про правовий режим воєнного стану», «Про мобілізаційну підготовку та мобілізацію», а також інших нормативно-правових актів . Метою введення особливого періоду є створення умов для здійснення органами державної влади, військовим командуванням, органами місцевого самоврядування, підприємствами, установами та організаціями наданих їм повноважень у разі збройної агресії чи загрози нападу, небезпеки державній незалежності України, її територіальній цілісності.
Військовим командуванням надається право разом з органами виконавчої влади та органами місцевого самоврядування запроваджувати та здійснювати певні заходи правового режиму воєнного стану щодо захисту населення від можливих загроз. Органи виконавчої влади та органи
ють:
навчання працюючого населення діям у надзвичайних ситуаціях, спричинених застосуванням зброї, за програмою прискореної підготовки працівників. Навчання населення здійснюють: за місцем роботи (особи, які працюють); за місцем навчання (діти дошкільного віку, учні та студенти); за місцем проживання (особи, які не працюють); проведення функціонального навчання керівного складу та фахівців, діяльність яких пов’язана з організацією і здійсненням заходів захисту населення в особливий період, за прискореною програмою;
проведення навчання фахівців спеціалізованих служб цивільного захисту (за спеціальностями);
проведення інформаційно-просвітницької роботи серед непрацюючого населення щодо правил поведінки в умовах бойових дій; виготовлення та розповсюдження інформаційних матеріалів (брошур, буклетів, плакатів, пам’яток тощо) з питань дій населення в надзвичайних ситуаціях, спричинених застосуванням зброї; запровадження постійних рубрик з питань дій населення в надзвичайних ситуаціях, спричинених застосуванням зброї, у друкованих та інших засобах масової інформації,
Із собою мати: паспорт, військовий квиток, документи про освіту і фах, посвідчення про шлюб і народження дітей, пенсійне посвідчення, трудову книжку та інші документи, валізу (наплічник) з теплим одягом, постільною білизною, особистими речами і предметами гігієни, гроші, цінності, продукти харчування і воду на 3 доби. Загальна маса не має перевищувати 50 кг. До валізи (наплічника) прикріпляють нашивку з позначенням адреси постійного місця проживання, прізвища евакуйованого і місця призначення. На одязі дітей мають бути нашивки з позначенням прізвища, імені та по батькові евакуйованого, року народження, адреси
проживання і місця призначення. Виконувати всі розпорядження посадових осіб евакуаційних і евакоприймальних органів. Дотримувати дисципліни та порядку на маршруті (на шляху руху
розселення за новим місцем розташування. Перед тим, як залишити житло, необхідно зачинити вікна; вимкнути газ, воду та електрику; забрати продукти з холодильника. Особи, які мають на руках військові квитки з мобілізаційними приписами, евакуації не підлягають!
Якщо покинути зону ведення бойових дій неможливо, то потрібно:
вивісити на будинку плакат «Тут живуть
зробити запас продуктів харчування і води; за можливості, обладнати укриття в підвалі, захистити
піском, передбачити наявність аварійного виходу;
за наявності земельної ділянки обладнати укриття
будинку, яка більша за його висоту;
уточнити місце, де може бути надана медична допомога;
якщо розпочалася перестрілка, лягти на підлогу під
кімнаті;
по квартирі пересуватися повзком.
Не можна: підходити до вікон, якщо лунають постріли; спостерігати за ходом бойових дій; стояти чи перебігати під обстрілом; конфліктувати з озброєними людьми; носити армійську форму
одяг;
вдома запаси питної та технічної води; зробити запас продуктів тривалого зберігання; додатково укомплектувати аптечку засобами надання домедичної допомоги;
підготувати (закупити) засоби первинного пожежогасіння;
підготувати ліхтарики (комплекти запасних елементів живлення), гасові лампи та свічки на випадок вимкнення енергопостачання;
підготувати (закупити) прилади (примус) для приготування їжі в разі
відсутності газу і електропостачання;
підготувати необхідні речі та документи на випадок термінової евакуації або переходу до захисних споруд цивільного захисту
інших сховищ (підвалів, погребів тощо);
особистий транспорт завжди мати в справному
район;
обігріву оселі у випадку вимкнення централізованого
спокій, не реагувати
не розповідати
а також знайомим із ненадійною репутацією; завжди мати при собі документ (паспорт), що засвідчує особу,
групу крові, можливі проблеми зі
(алергію на медичні препарати тощо);
знати місце розташування захисних споруд
зу місця проживання, роботи, об’єктів частого відвідування (магазини, базар, дорога до роботи, медичні заклади тощо). Без необхідності старатися якнайменше перебувати поза місцем проживання, роботи та в малознайомих місцях; виходячи з приміщень, пересуваючись сходинами багатоповерхівок або до споруди цивільного захисту (сховища), дотримувати правила правої руки (як під час руху автомобільного транспорту) з метою уникнення тисняви. Пропускати вперед слабших і надавати допомогу жінкам, дітям, людям похилого
виконують незрозумілі роботи, протиправні та провокативні дії тощо, негайно інформувати органи правопорядку, місцевої влади, військових; надавати домедичну допомогу іншим людям у разі їх поранення; викликати екстрену (швидку) медичну допомогу, представників ДСНС України, органів правопорядку, за необхідності, військових; у разі, якщо стали свідком поранення або смерті людей, протиправних дій (арешт, викрадення, побиття тощо), намагатися з’ясувати та зберегти якнайбільше інформації про них та обставини події для надання допомоги, пошуку, встановлення
тощо. У разі виникнення реальної загрози
рішення, бути дисциплінованими та організованими.
Терміновій інформації, що доводиться до населення, передує
звучання електричних сирен, а також звучання електричних сирен у запису, що транслюється

налаштувати радіоприймачі на хвилю обласного радіо, телеприймачі — на канал обласної державної телерадіокомпанії чи Перший національний телевізійний
та прослухати подальші повідомлення. Повідомлення передаються протягом 5-ти хв після подачі звукового сигналу «Увага всім!». Вислухавши повідомлення,
до отриманих вказівок та рекомендацій; переконати-
ки з приміщеннями для
Про свій виїзд та місце подальшого перебування слід повідомити рідних та житлово-експлуатаційні органи. У разі самостійного виїзду слід узяти речі, які рекомендують брати під час оголошення евакуації, а також вимкнути у квартирі електрику, газ, воду. У випадку оголошення евакуації потрібно діяти згідно з вказівками органів цивільного захисту.

Якщо обстріл застав у будівлі, негайно зійти у підвал. У випадку якщо підвал відсутній або зачинений, зайти до сусідів на першому поверсі. Є правило: що нижче спустишся, то безпечніше. Зазвичай снаряди влучають у верхні поверхи. Якщо артилерійський обстріл застав у будинку зненацька і не лишилося часу зреагувати, швидко зайняти приміщення, які розташовані подалі від вікон, балконів (коридор, ванна кімната тощо), і дочекатись закінчення вибухів. Найчастіше уламки потрапляють у приміщення через вікна. Якщо є можливість, завчасно заклеїти скло вікон скотчем або забарикадувати шафами — це врятує від осколків скла. Якщо обстріли
речами.
тися ліфтом.
Якщо артилерійський обстріл
землю (канаву, яму), щільно притулитися до якогось виступу: бордюру,
руками. Найчастіше причиною поранення є
лею.
має бути заглибленим і, разом із тим, розташовуватися подалі від споруд, які можуть обвалитися внаслідок прямого влучання або спалахнути. Ідеально захищає траншея чи канава (подібна до окопу) завглибшки 1–2 м, розташована на відкритому місці. Після закінчення обстрілу необхідно

Обережно піднятися,
під капітальними будинками старої забудови; в оглядовій ямі гаража, станції технічного обслуговування; у каналізаційних люках; у вирвах, що залишилися від попередніх обстрілів. Не можна використовувати для укриття: під’їзди будинків; місця під технікою (вантажівкою, автобусом); не підготовлені для укриття підвали; укриття, що розташовані ближче 30–50 м від багатоповерхових будівель; проходи поміж штабелями, контейнерами, будівельними матеріалами.

У випадку, коли обстріл застав у транспорті (таксі, тролейбусі, трамваї): 1. Попросити водія зупинити транспортний засіб. 2. Вийти з транспортного засобу
маса починає сліпо копіювати його дії. Тому люди найчастіше


шарф, краватку, викинути сумку, парасольку тощо. Якщо щось упало, у жодному разі не намагатися підняти, бо життя найдорожче. Головне завдання в натовпі — не впасти. Якщо збили з ніг і людина впала на землю, треба спробувати згорнутися клубком і захистити голову руками, прикриваючи потилицю. За будь-якої можливості потрібно спробувати встати на ноги.
З метою запобігання надзвичайним ситуаціям під час проведення масових заходів рекомендують об’єднати колег, друзів, знайомих, які беруть участь у масових заходах, у так звані «групи порятунку». Основне їхнє завдання — своєчасне і оперативне реагування на раптові запити присутніх і недопущення панічних настроїв. Виявлення підозрілого предмета Підозрілі предмети та речі — це сумки, пакети, згортки, портфелі, картонні коробки, упаковки цигарок, приймачі, мобільні телефони, іграшки тощо, у яких можуть бути замасковані вибухові пристрої або в які може бути закладена вибухівка ( іл. 43.1 ).
Ознаки підозрілих предметів, які можуть виявитися вибуховими пристроями, такі: наявність дротів, малої антени, скотчу, підозрілих звуків (цокання годинника, клацання), джерел електричного живлення (батарейок, акумуляторів), розтяжки з дроту (шпагату, мотузки), незвичне розміщення, а також невластивий, специфічний запах. З метою запобігання надзвичайним ситуаціям під час проведення масових заходів рекомендують об’єднати колег, друзів, знайомих, які беруть участь у масових заходах, у так звані «групи порятунку». Основне їхнє завдання — своєчасне


(машиніста) транспортного засобу. Якщо виявлено будь-де підозрілий предмет, то: не чіпайте, не відкривайте та не переміщуйте його; зафіксуйте час його виявлення; не використовуйте мобільні телефони та засоби радіозв’язку; обов’язково дочекайтеся прибуття оперативно-слідчої групи, фахівців МВС і ДСНС та вкажіть місце розташування підозрілого предмета; простежте, щоб люди відійшли на безпечну відстань від знахідки. Якщо знайдено підозрілий предмет, який може виявитися вибуховим пристроєм, або боєприпаси, безпечними відстанями слід вважати такі рекомендовані зони евакуації та оточення ( табл. 43.1 ).
Автомобіль типу «Волга»
Мікроавтобус
Вантажна автомашина (фургон)

1. Що таке особливий період?
м
м
м
2. Як ви будете діяти під час артилерійського обстрілу (бомбардування)?
3. Як ви будете діяти з початком бойових дій у вашій місцевості?
4. Як потрібно поводитися в натовпі? 5. Якими будуть ваші дії в разі виявлення підозрілого предмета?


Які терористичні акти та війни відбувались у світі протягом останніх років?
Види терористичних проявів

Тероризм (від лат. terror — жах) — суспільно небезпечна діяльність, яка полягає у свідомому, цілеспрямованому застосуванні насильства шляхом захоплення заручників, підпалів, убивств, тортур, залякування населення та органів влади або зазіхань чи інших посягань на життя чи здоров’я ні в чому невинних
погрози вчинення
досягнення злочинних цілей.
Терористичні акти — злочинне
нення вибуху, підпалу чи інших дій, відповідальність за які передбачена статтею 258-ою КК України. Важливе значення має вивчення мотивів терористичних актів, оскільки це дає змогу розробляти ефективні дії щодо їх нейтралізації. Основою тероризму можуть бути політичні мотиви (залякування населення, послаблення державної влади, змушування до певних дій або фізичне знищення політичних супротивників), а також дії, що мотивуються релігійними переконаннями, помстою, користолюбством, економічною конкуренцією або пов’язані
поведінкою психічно хворих людей.

11 вересня 2001 р. світ був шокований зухвалими терористичними актами, скоєними підручними бен Ладена в Нью-Йорку ( іл. 44.1 ) і Вашингтоні. Цього дня бойовики-смертники з організації «Аль-Каїда» спрямували пасажирські літаки на башти-близнюки Всесвітнього торговельного центру, які були символом прогресу і могутності Америки, а також на Пентагон. У результаті загинуло близько 7 тис. людей, багато будинків було зруйновано, значно постраждав престижний діловий район Нью-Йорка — Мангеттен. Це був один з найбільших терористичних актів у світі. А через кілька тижнів


Іл. 44.2. Терористичний


Такі дії здатні викликати широкий резонанс, залишити глибокий
у психології населення або значної
частини, підірвати атмосферу безпеки, спокою, стабільності в суспільстві.
Терористичні акти: спричиняють масові людські жертви, чинять значний психологічний тиск на великі маси людей, спричиняють руйнування матеріальних і духовних цінностей, які можуть не підлягати відновленню, сіють ворожнечу між державами, провокують війни, недовіру і ненависть між соціальними і національними групами, що тривають, іноді, протягом життя цілого покоління.
Відомо, що дії, вчинені під час війни, зокрема партизанський рух, не кваліфікують як терористичні.
Теракт — безпосереднє вчинення злочину терористичного характеру у формі:
вибуху, підпалу, застосування або загрози застосування ядерних вибухових пристроїв, радіоактивних, хімічних, сильнодіючих отруйних, біологічних і вибухових речовин; знищення, пошкодження або захоплення транспортних засобів (наземних, морських, повітряних) чи інших об’єктів; замаху

Іл. 44.4. Представники терористичної організації
Терористичні акти щороку стають все більш ретельно організованими і жорстокими, з використанням найсучаснішої техніки, зброї, засобів зв’язку ( іл. 44.4 ). У різних регіонах світу політичними і націоналістичними радикалами, що взяли на озброєння методи терору для досягнення своїх цілей, організована розгалужена мережа підпілля, складів зброї, вибухових речовин і фінансових установ. Для при-криття терористичних організацій функціонує система фірм, компаній, банків і фондів. Найвірогіднішими цілями терористичних атак є місця масового перебування людей та об’єкти підвищеної небезпеки, які внаслідок підриву призводять до значної кількості людських жертв і можуть створити додаткову загрозу населенню та територіям, унаслідок викиду в навколишнє природне середовище небезпечних речовин (хімічних, біологічних, радіоактивних).
В Україні до таких об’єктів належать: атомні електростанції, транспортні вузли (зокрема аеропорти, залізничні станції), магістральні трубопроводи, військові склади, арсенали, промислові підприємства, установи, організації, які виробляють, використовують, зберігають, продають біологічні препарати, високотоксичні й отруйні речовини.
Типовою зброєю терористів є використання замаскованих вибухових пристроїв . Залежно від мети терористичного акту, такі пристрої, укомплектовані годинниковим механізмом, терористи можуть залишати в житлових будинках, навчальних закладах, установах і організаціях, підприємствах, громадському транспорті тощо. Завдяки пильності громадян, можна запобігти численним жертвам від спрацювання вибухового пристрою. Терористи намагаються розмістити вибухові пристрої в найбільш уразливих місцях , де зможуть завдати найбільшої шкоди населенню. До таких місць, як правило, належать: автомобілі; входи, внутрішні двори, підсобні приміщення адміністративних і житлових будинків, складських приміщень; урни для сміття, інженерні комунікації в місцях масового перебування людей (на фестивалях, ярмарках, базарах, у супермаркетах, підземних переходах тощо); громадський транспорт (вагони тролейбусів, автобусів, трамваїв, поїздів тощо); об’єкти підвищеної небезпеки тощо.
В окремих випадках вибуховий
тощо. Також
пристроями,
Розділ
домого предмета, антени, лампочки на його поверхні, хід годинника, що прослуховується; залишені предмети побутового призначення (валізи, сумки, пакунки, гаманці, дитячі іграшки, ручні ліхтарики, парасольки тощо) ( іл. 44.6 ); наявність предметів у місцях, не призначених для них (наприклад дитяча іграшка біля вхідних дверей); отримання поштового відправлення, уміст якого чи відправник йому не відомі; наявність у виявлених предметах характерного вигляду штатних боєприпасів, навчально-імітаційних, сигнальних, освітлювальних, піротехнічних виробів; наявність у виявлених предметах запаху бензину, газу, розчинника, пально-мастильних матеріалів, хімічних речовин тощо; наявність диму, що виходить із предмета; наявність у виявленому предметі елементів (деталей), що не відповідають його прямому призначенню, наприклад прикріпленого до нього мобільного телефона ( іл. 44.7 ), радіостанції, акумулятора; надзвичайно велика маса виявленого предмета (наприклад невідповідність ваги коробки від цукерок, банки від кави, блокнота тощо); нестандартний вигляд тари для посилки; наявність у дверях, вікнах, воротах будь-яких сторонніх предметів (наприклад, закріпленого дроту, ниток, важелів, шнурів тощо); наявність стороннього сміття на прилеглій території, розкопаного ґрунту на газонах, обмеженого ремонту тротуару, стіни будинку за відсутності
щодо їх проведення відповідними службами.

Іл. 44.5. Предмети, під які найчастіше






Також потрібно:
не користуватися запальничками, іншими джерелами відкритого вогню, а також предметами, що можуть його утворювати;
не доторкатися руками або іншими предметами до підозрілої речі; у жодному разі не намагатися перемістити підозрілий предмет (вибуховий пристрій) або змінювати його положення;
не залишати місце, де виявлено підозрілий предмет, за можливості, організувати його охорону. На сьогодні значно зріс та розширив свої межі тероризм міжнародного характеру, тобто такий, що зачіпає інтереси двох або більше держав, порушує міжнародний правопорядок.
Міжнародний тероризм — здійснювані у світовому чи регіональному масштабі терористичними організаціями угрупованнями, у тому числі за підтримки державних органів окремих держав, з метою досягнення певних цілей суспільно небезпечні насильницькі діяння, пов’язані з викраденням, захопленням, вбивством невинних людей чи загрозою їхньому життю і здоров’ю, зруйнуванням чи загрозою зруйнування важливих господарських об’єктів, систем життєзабезпечення, комунікацій, застосуванням чи загрозою застосування ядерної, хімічної, біологічної та іншої зброї масового ураження ( іл. 44.9 ). Віднедавна поширився кібертероризм, або комп’ютерний тероризм ( іл. 44.10 ) — використання або загроза використання комп’ютерних технологій з метою порушення суспільної рівноваги, залякування населення, вплив на прийняття рішень органами
політичних, корисливих або будь-яких інших цілей, а також напад на комп’ютерні мережі, обчислювальні центри, центри керування військовими мережами і медичними установами, банківські та інші фінансові мережі, засоби передавання інформації за допомогою комп’ютерних мереж.
Інтернет — це необмежений ресурс, який може бути використаний у всіх галузях діяльності людини. Проте він може бути і небезпечним, особливо для молоді. Основні небезпеки — це агресія, сексуальні домагання, заклики заподіяти шкоду, переслідування, образи, психологічний тиск, шахрайство, крадіжки, екстремізм, неетична реклама, порнографія, комп’ютерні віруси. Щоб запобігти цьому, ніколи не давайте приватної інформації про себе (прізвище, адресу, номер телефону), пам’ятайте про правила безпеки в Інтернеті.



10–15-річні підлітки, які мають на меті зірвати таким чином заняття в навчальному закладі. Незважаючи на те, що повідомлення зазвичай не підтверджується, на перевірку кожного з них відволікається багато людей і техніки (поліція, співробітники спецпідрозділів, пожежники, рятувальники, медики), і люди зазнають матеріальних збитків. Телефонне хуліганство та телефонний тероризм ( іл. 44.11 ) є злочинами, за які передбачено кримінальну відповідальність. Зокрема, згідно з ККУ, за такі витівки можна отримати штраф у великому розмірі або ж обмеження волі на термін до п’яти років. За неповнолітніх платити доведеться батькам, про що варто пам’ятати і дорослим, і дітям. За останніми науковими дослідженнями голосу в так званих фоноскопічних лабораторіях, навіть за незначними записаними фразами можуть встановити стать, вік, вагу, стан здоров’я, регіон проживання, національність тощо. Цих
для того, щоб встановити особистість «жартівника», який


Іл. 44.12. Захоплення заручників терористами
Іл. 44.11. Телефонне хуліганство і телефонний тероризм У сучасному світі не зменшується кількість випадків захоплення заручників ( іл. 44.12 ).

Заручник — фізична особа, яка захоплена і / або утримується з метою спонукання державного органу, підприємства, установи чи організації або окремих осіб здійснити якусь дію або утриматися від здійснення якоїсь
як умови звільнення особи, що захоплена. Види терористичних проявів Такі злочини, як правило,

іноді трапляється
біля виходів, розгляньте варіанти втечі через аварійні виходи; постарайтеся визначити кількість терористів; якщо вдається симулювати симптоми хвороби, з’являється можливість звільнитися в результаті переговорів: часто терористи звільняють жінок, дітей, літніх і хворих людей; звільнені заручники мають повідомити якнайбільше деталей: кількість загарбників, у якій частині транспортного засобу вони перебувають, яку зброю мають, кількість пасажирів і їхнє розташування, моральний стан терористів; сховайте документи і матеріали, що можуть вас скомпрометувати; віддайте особисті речі, яких вимагають терористи; не впадайте в паніку, краще подумайте, як знайти вихід зі становища; постарайтеся зрозуміти наміри терористів, щоб оцінити можливості
для опору; спробуйте з’ясувати, чи налаштовані вони рішуче,
чи розмовляти із сусідами.
Отже, за будь-якої ситуації, якщо ви опинилися в заручниках: не допускайте дій, які можуть спровокувати нападників до застосування зброї; не звертайте увагу на образи і приниження, не поводьтеся зухвало; виконуйте вимоги злочинців, не заперечуйте їм, не допускайте істерики і паніки;
перш ніж що-небудь зробити, — запитуйте дозволу; якщо ви поранені, постарайтеся не рухатися, — цим уникнете додат-
кової втрати крові.
Під час вашого звільнення: ляжте на підлогу
ведливе



німізації її наслідків; виявлення та усунення причин, що сприяють здійсненню терористичної діяльності.
Боротьба з тероризмом є складним та багатоаспектним завданням. Вона передбачає розвідувальну, контррозвідувальну, оперативно-розшукову та аналітичну роботу, ефективне проведення якої дозволяє виявляти терористичні організації на стадії їх зародження, ефективно протидіяти терористичним актам ще в період їх підготовки. Україна, яка є суб’єктом міжнародного права, намагається здійснювати певні заходи щодо нерозповсюдження тероризму не тільки ззовні, але й усередині держави.

пам’ятники, бетонні стовпи або бордюри, канави. Пам’ятайте, що автомобіль – не найкращий захист, тому що його метал тонкий, а пальне — вибухонебезпечне. За першої нагоди сховайтеся у під’їзді будинку, підземному переході, дочекайтеся закінчення перестрілки; проводьте заходи для порятунку дітей, за необхідності прикрийте їх своїм тілом. За можливості повідомте про інцидент співробітників поліції; якщо в ході перестрілки ви перебуваєте у будинку, — укрийтеся у ванній кімнаті й ляжте на підлогу, тому
безпечно через можливість рикошету. Перебуваючи в укритті, стежте за можливим початком пожежі. Якщо
почалася, а стрілянина не припинилася, залиште квартиру й сховайтеся в під’їзді, далі від вікон. Дії у випадку захоплення літака (автобуса): якщо ви виявилися в захопленому літаку (автобусі), не привертайте до себе уваги терористів. Огляньте салон, визначте місця
укриття на випадок стрілянини; заспокойтеся, спробуйте відволіктися від того, що відбувається, читайте, розгадуйте кросворди; зніміть ювелірні прикраси; не дивіться в очі терористам, не пересувайтеся
вайте сумки без їхнього дозволу; не реагуйте на провокаційну
жінкам у міні-спідницях бажано прикрити ноги; якщо
логу між кріслами й залишайтеся там до закінчення штурму; після звільнення — негайно залиште літак (автобус), тому що не виключена можливість його замінування терористами й вибуху парів бензину.
Якщо ви стали жертвою телефонного терориста: подзвоніть з іншого телефону (мобільного, від сусідів) на вузол зв’язку і скажіть причину дзвінка, своє прізвище, адресу та номер свого телефону; намагайтесь затягнути розмову та записати її на диктофон чи дайте послухати свідкам (сусідам); одночасно, з

1.
2.
3.
них вибухових пристроїв? Під що найчастіше маскують вибухонебезпечні предмети?
4. Як треба діяти, якщо
5. У чому полягає суть міжнародного тероризму?
6. Що таке комп’ютерний тероризм? Які ще небезпеки
в Інтернеті і як їх уникнути?

7. Які наслідки можуть мати телефонне
тероризм?
8. Як діяти
9.


з різними екстремальними ситуаціями
стихійні лиха, аварії, пожежі, катастрофи, нещасні випадки, дорожньо-транспортні пригоди тощо. Постраждалими можуть виявитися окремі люди, сім’ї та цілі спільноти: люди втрачають будинки, близьких, виявляються відірваними від сім’ї та звичного оточення або стають свідками насильства, руйнувань

загрозою смерті, тілесного ушкодження,
у результаті побаченого, почутого, усвідомленого на основі попереднього досвіду, у людини відразу мобілізуються всі резервні можливості — виникає стресова реакція. Це — неспецифічна реакція організму, яка забезпечує
насамперед фізичних ресурсів організму. Коли людині загрожує серйозна небезпека, вона реагує інстинктивно, незалежно від волі і бажань. Таку реакцію часом називають «бийся або біжи». Ця реакція готує організм людини до значної фізичної активності, вивільняючи адреналін, і приводить до прискорення обміну речовин, прискорення пульсу і зростання кров’яного тиску, підвищення потовиділення. Вона є цілком нормальною захисною реакцією і свідчить, що людина перебуває в певному стані, спрямованому на протидію небезпечним для неї впливам.
Однак фізична реакція на стрес в екстремальних ситуаціях постійно супроводжується інтенсивними емоційними переживаннями та зміною поведінкових реакцій

хічних функцій (свідомість, сприйняття, пам’ять, увага і мислення) і дезорганізації поведінки, що розвивається в результаті загрози або реального впливу
ності своєчасної
му — переживання невідповідності між
відуальними можливостями їх подолання,
відчуттям безпорадності та втрати контролю, порушенням сприйняття і переробки інформації, здатності використовувати набуті знання і досвід на практиці, що спричиняє іноді фізичні, психічні та особистісні розлади. Важливим є той факт, що на тлі психотравми виникають фізіологічні порушення: змінюються біохімічні показники, знижується імунітет, змінюється робота мозку, насамперед ті його зони, які пов’язані з контролем над агресивністю та циклом сну. Пережитий стан фіксується в пам’яті, а

тимчасово втрачає почуття безпеки та довіри. Раптово світ стає небезпечним, повним хаосу та взагалі місцем, де небезпечно перебувати. Постраждалому / постраждалій необхідно
ки, залишаючись поруч, і не боятися тривожності постраждалих
емоційних реакцій.
2. Активно слухайте. Важливо уважно вислухати про переживання постраждалих у безпечних умовах, адже це часто допомагає
зуміти та, врешті-решт, прийняти подію і змінити
місці події може бути мало часу, але все
та залишитися поруч доти, доки, наприклад, постраждалим
медичні працівники.
3. Поважайте почуття іншого. Поставтеся без
вам говорять, і прийміть пояснення подій постраждалою людиною — визнайте та поважайте її почуття. Не
нішню поведінку, а й підтримувати контакт із постраждалим / постраждалою, якщо йому треба поговорити про те, що трапилося. Він / вона може відмовитися від вашої допомоги, проте вам необхідно триматися трохи осторонь, але стежити за появою ознак того, що людині потрібна допомога. 4. Виявіть турботу та надайте практичну допомогу. Якщо хтось перебуває в екстремальній ситуації, дуже корисною
додому
вання, то під час короткочасних, але досить інтенсивних стресових впливів виникають дві найбільш загальні форми змін поведінкової активності: активно-емоційна,
вація психічних функцій, посилення ефективності захисних дій), і пасивно-емоційна, яка проявляється в очікуванні закінчення дії екстремального фактора (гальмування активності, зниження ефективності захисних дій). Зовні
навіть на прояв почуттів. У стані апатії людина може перебувати від кількох днів до кількох тижнів.
Ознаки : байдуже ставлення до навколишнього, млявість, загальмованість, мова повільна, з великими паузами. Якщо людину залишити без підтримки й допомоги в такому стані, то апатія може перерости в депресію (важкі й болісні емоції, пасивність поведінки, почуття провини, відчуття безпорадності перед життєвими труднощами, безперспективність тощо).

Перша допомога: поговоріть з постраждалим. Задайте йому кілька простих запитань, виходячи з того, знайомий він вам чи ні: «Як тебе звуть?», «Як ти себе почуваєш?», «Хочеш їсти?» тощо. Проведіть постраждалого до місця відпочинку, допоможіть зручно влаштуватися, візьміть за руку або покладіть свою руку йому на чоло. Дайте поспати або просто полежати. Якщо немає можливості відпочити (подія на вулиці, у громадському транспорті тощо), то більше говоріть з
залучіть його до будь-якої спільної діяльності.
2. Ступор — одна з потужних захисних реакцій
досить
це
виснаження. Контакт з навколишнім світом відсутній, постраждалий / постраждала не помічає
небезпеки й не починає дій, щоб її уникнути. Ознаки : різке зниження або відсутність довільних рухів і мови, відсутність реакції на зовнішні подразники (шум, світло, дотики), «заціпеніння» в певній позі, стан повної нерухомості.

Перша допомога: кінчиками великого й вказівного пальців масажуйте постраждалому точки, розташовані на чолі, над очима рівно посередині між лінією росту волосся й бровами, чітко над зіницями. Долоню вільної руки покладіть на груди постраждалого. Налаштуйте свій подих під ритм його подиху. Людина, перебуваючи в ступорі, може чути, бачити. Тому говоріть йому на вухо, тихо, повільно й чітко те, що може викликати сильні

ненормально голосна мова або підвищена мовна активність (людина говорить без зупинки, іноді абсолютно безглуздо), часто відсутня реакція на навколишніх (на зауваження, прохання, накази). Якщо такій людині не надати допомогу, це призведе до небезпечних наслідків: людина буде робити необмірковані вчинки, може заподіяти шкоду собі й іншим. Перша допомога : використовуйте прийом «захоплення»: перебуваючи позаду, просуньте свої руки постраждалому під пахви, пригорніть його до себе й злегка перекиньте на себе. Ізолюйте постраждалого від інших людей. Говоріть спокійним голосом про почуття, які він відчуває: «Тобі хочеться щось зробити, щоб це припинилося. Ти хочеш сховатися від того, що відбувається». Не сперечайтеся з постраждалим, не запитуйте, у розмові уникайте фраз із часткою «не», що стосуються небажаних дій («не біжи», «не розмахуй руками», «не кричи»). Рухове порушення зазвичай триває недовго й може
лий час і заважати самому постраждалому / постраждала й навколишнім. Ознаки : роздратування, невдоволення, гнів (з будь-якого, навіть незначного приводу); удари руками
якими-небудь предметами, словесна образа, лайка; м’язова напруга; зростання кров’яного тиску.

Перша допомога: зведіть до мінімуму кількість свідків. Дайте постраждалому можливість «випустити пару» (наприклад виговоритися або «побити» подушку). Доручіть роботу, пов’язану з високим фізичним навантаженням. Демонструйте доброзичливість, навіть якщо ви не згодні, не обвинувачуйте його, не висловлюйтеся із приводу
інакше агресивна поведінка буде спрямована на вас. Не можна говорити: «Що ж ти за людина!» Необхідно говорити: «Ти жахливо злишся, тобі хочеться все рознести вщент. Спробуймо разом знайти вихід із цієї ситуації». Намагайтеся розрядити обстановку смішними коментарями. Агресія може бути погашена страхом покарання.
5. Страх. Ознаки: напруження м’язів (особливо м’язів обличчя); сильне серцебиття; прискорене поверхневе дихання; знижений контроль за власною поведінкою. Панічний страх може спонукати до втечі, викликати

6. Нервове тремтіння. Людина, яка щойно пережила напад, надзвичайну подію або стала свідком такої події, учасником конфлікту (бойового зіткнення), може сильно тремтіти. Тремтіння виникає раптово — відразу після інциденту або через якийсь час. Так організм «скидає напругу». Ознаки : неконтрольоване нервове тремтіння (людина не може за власним бажанням припинити цю реакцію). Виникає сильне тремтіння всього тіла або окремих частин (людина не може утримати в руках дрібні предмети, запалити сірник). Збоку здається, що вона змерзла. Реакція триває довго (до кількох годин). Потім людина почуває сильну втому й потребу у
відпочинку.

Перша допомога: потрібно підсилити тремтіння. Візьміть постраждалого за плечі й сильно,

Подібна реакція обумовлена фізіологічними процесами в організмі. Коли людина плаче, усередині виділяються речовини, що мають заспокійливу дію. Добре, якщо поруч є хтось, з ким можна розділити горе. Ознаки : людина вже плаче або готова розридатися. Тремтять губи. Спостерігається відчуття пригніченості. На відміну від істерики, немає порушення в поведінці. Емоційна розрядка, полегшення не відбувається, якщо людина стримує сльози. Коли ситуація триває дуже довго, внутрішнє напруження може завдати шкоди фізичному й психічному здоров’ю людини. Про такий стан говорять: «Збожеволів від горя». Перша допомога : не залишайте людину наодинці. Встановіть з нею фізичний контакт (візьміть

гуркотом
буття фахівця спостерігайте за її станом. Не потурайте її бажанням. Методики екстреної психологічної самодопомоги В екстремальній
новці. Коли ви в стресі, то реагуєте інстинктивно тілом, ваш розум
кається. Скільки треба часу для тренування методикам саморегуляції? Вправи не вимагають багато часу на виконання (1–3 хв),
являється вже в
виконання прийомів), непомітні для інших, не мають

злість виходять
що
Мобілізуюче дихання допомагає подолати млявість і


ність ставлень, які допомагають сфокусуватись на можливостях, ресурсах навіть тоді, коли є проблеми.

Кроки до реалістичного оптимізму: подивіться на те, що відбувається, у позитивному сенсі; фокусуйтеся на позитиві, який є завжди; уникайте стану «скаржитись та нити»; вирішіть для себе, що є можливим, доступним для вас, а що неможливим; не будьте «проти» того, що турбує, а налаштуйте себе на пошук нових ідей; смійтеся над собою, але не над іншими (гумор має велику силу).

Самодопомога на початку паніки і страху. У момент виникнення паніки чи страху уповільніть дихання до 8–10 вдихів за хвилину. Щоб сповільнювати дихання, для початку навчіться зосереджувати всю увагу на цьому процесі,

хочете досягти. Дозволяйте собі розслаблятися, прислухатися до своїх думок, займатися тим, що до душі, наодинці з самим собою. Ви зможете краще зрозуміти себе. Якщо щось не вдалося, не витрачайте час на жалі. Краще думайте, як досягти цілі інакше, і робіть це.

1. Що таке психологічний стрес і внаслідок чого він може виникнути?
2. Які стани в людини свідчать про те, що в неї психологічний стрес?
3. Що передбачає екстрена психологічна допомога?
4. У чому полягає психічна саморегуляція?


5. Що потрібно робити, щоб навчитися психологічній самодопомозі, коли є: а) надмірне збудження; б) нав’язливі думки; в) песимістичний настрій; г) паніка та страх; ґ) відчуття невпевненості?
6. Як потрібно поводитися з людиною коли внаслідок психологічного стресу в неї є прояви: а) апатії; б) ступору; в) рухового збудження; г) агресії; ґ) страху; д) нервового тремтіння; е) плачу;
7. Складіть


Поміркуйте
поділити на чотири групи:
1. Гуманітарні наслідки від мін та ВНП (смерті, травми та подальша інвалідність; блокування доступу до лікарень, водопостачання, їжі, гуманітарної допомоги; перешкоджання вільному переміщенню людей тощо).
2. Соціально-психологічні наслідки (відчуття страху, безнадії, депресія, суїциди, підвищення рівня агресії і напруження у суспільстві).
3. Соціально-економічні наслідки (зруйнована інфраструктура та дороги, втрата родючих сільськогосподарських земель; витрати на відновлення водопостачання, енергопостачання тощо; навантаження на систему охорони здоров’я
з обмеженими фізичними можливостями; додаткові
4. Екологічні наслідки (збитки флори і фауни,
та ВНП негативно впливає на загальний
кожного. Протимінна діяльність в Україні 6 грудня 2018 року Верховною Радою
територій
в Україні» (Закон), що був підписаний Президентом України та набрав чинності 25 січня 2019 року. Закон визначає правові та організаційні засади здійснення протимінної діяльності (ПМД) в Україні та особливості державного регулювання у цій сфері. Протимінна діяльність (ПМД) — заходи, що проводяться з метою забезпечення

2) Розмінування (гуманітарне
3) Надання
реабілітації;
4) Знищення
гають знищенню відповідно до міжнародних
5) Агітаційно-просвітницька робота щодо незастосування протипіхотних мін.

Навчання з попередження ризиків від вибухонебезпечних предметів (Explosive Ordnance Risk Education — EORE ) є невід’ємною частиною ПМД, яка спрямована на зниження ризиків травм та смертей від ВНП шляхом підвищення
жаль, розмінування та очищення територій
предметів — доволі тривалий та дороговартісний
розмінування
Міжнародні стандарти
Міжнародні стандарти для програм у сфері гуманітарного розмінування були вперше запропоновані робочими групами на міжнародній технічній конференції, яка проводилася у Данії, у липні 1996 року. Були встановлені критерії для
всіх аспектів процесу розмінування, рекомендовані стандарти й узгоджене нове універсальне визначення поняття «розмінування». Наприкінці 1996
року принципи, запропоновані у Данії, були розвинені робочою групою під керівництвом ООН і з’явилися «Міжнародні стандарти для проведення операцій з гуманітарного розмінування». Перше видання
опубліковане Службою
діяльності (ЮНМАС) у березні 1997 року. Ці стандарти були перероблені і
мінами. Для досягнення цієї мети Конвенція всебічно забороняє використання, накопичення запасів, виробництво та передачу протипіхотних мін та закликає знищити всі запаси, очистити всі заміновані території та надати допомогу жертвам наземних мін. Російська Федерація, США, Китай, Індія, Пакистан (найбільші в світі виробники протипіхотних мін) та деякі інші країни не приєдналися до Конвенції.
2. Конвенція про заборону або обмеження застосування конкретних видів звичайної зброї, які можуть вважатися такими, що завдають надмірних ушкоджень або мають невибіркову дію зі змінами від 21 грудня 2001 року (Женевська конвенція) є одним з найважливіших документів у галузі міжнародного
гуманітарного права, котрі регламентують методи і засоби ведення війни. Вона має п’ять частин (протоколів). Проте лише два
стосуються протимінної діяльності:
мін-пасток та інших пристроїв з поправками, внесеними 3 травня 1996 року (прийнято Законом
1999
2281-ІV).
Головною метою положень, закріплених у Конвенції, є захист цивільного населення від надмірних ушкоджень чи невиправданих страждань внаслідок застосування конкретних видів звичайної зброї.
За характером Конвенція
неможливо виявити в тілі людини за допомогою рентгенівських променів. 3. Конвенція про касетні боєприпаси
накопичення, виробництво та передачу касетних боєприпасів.
Правила позначення небезпек, пов’язаних з
та
ними предметами — наслідками війни (Правила), розроблені відповідно
положень міжнародних гуманітарних конвенцій із урахуванням рекомендацій міжнародних стандартів з протимінної діяльності (IMAS), а також спрямовані на застосування та забезпечення виконання норм міжнародного гуманітарного права на території України. Зазначені Правила надають роз’яснення щодо заходів, спрямованих на недопущення цивільного населення до небезпечних районів, системи позначення небезпечних районів та їх огородження, зразку та опису попереджувальних знаків, утримання, обслуговування та передачу офіційних систем позначення. Однак не всі заміновані території або території, на яких велись бойові дії, на сьогодні обстежені на наявність мін та ВНП і мають відповідне позначення. Оскільки бойові дії продовжуються по сьогодні, залишається ризик для цивільного населення натрапити на заміновану ділянку або ВНП. У разі виявлення міни чи ВНП необхідним є також інформування оточуючих та осіб, що можуть опинитись поряд із небезпекою, тож саме правильне позначення небезпечного району може стати для інших сигналом щодо наближення до небезпеки.
Слід пам’ятати, що встановлення офіційних систем позначення здійснюється лише фахівцями у сфері

та неофіційні (саморобні) .
Офіційні попереджувальні знаки — ті, що зроблені відповідно до діючого стандарту та стандартів операційних процедур ( іл. 46.1 ). Неофіційні попереджувальні знаки — будь-які зроблені кустарним шляхом таблички, позначки та інші візуальні попередження, зроблені за допомогою підручних засобів. Це може бути від руки зроблена табличка чи просто надпис, стрічка, прив’язана на дереві хустина, перехрещені палиці, зібране в купу каміння тощо. Навіть пляшка на дереві може бути попередженням щодо небезпеки ( іл. 46.2 ).


46.1.
1.
2.
з шести офіційних мов Організації Об’єднаних
та/або мовою, поширеною у відповідному районі.
3. Попереджувальний знак по краях лицьового боку повинен мати жовту світловідбивальну смугу.
4. Зворотний бік попереджувального знака білого кольору.
5. Розміри трикутного попереджувального знака становлять не
ніж 28×20×20 см.
6. Розміри квадратного попереджувального знака становлять
ніж 25×25 см.




часові

ють та використовують певний проміжок
переджувальних знаків у небезпечному районі. Вони повинні бути помітними, чіткими, довговічними, стійкими до впливу погодних умов, чітко вказувати на небезпечний район, а також зрозумілими для населення певної громади, територія

як стійки огорожі можуть використовуватися дерева, кущі, елементи будівельних конструкцій, опори електропередач, стовпи; стрічка може бути виготовлена з будь-якого міцного матеріалу, зокрема канату, троса, дроту, мотузки, шпагату, шнура; попереджувальні знаки повинні прикріплюватися до верхнього краю огорожі на відстані не більше ніж 30 м один від одного та в межах 5 м від кожної поворотної точки, а також до стійок (у разі потреби) ( іл. 46.3 ). Іл. 46.3. Правила розміщення офіційних попереджувальних знаків
Саморобні системи позначення небезпечного району встановлюють у ситуаціях, пов’язаних із виявленням небезпеки, а також у разі неможливості встановлення постійної або тимчасової системи позначення.
Так, для позначення небезпечного району та місць виявлення
і ВНП можуть використовуватися всі доступні підручні засоби та матеріали: каміння; палиці (встановлюють навхрест); фарба, нанесена на дерева або скелястий ґрунт; прокопані канави, насипані піском смуги; зафіксована (зав’язана) червона ганчірка; інші позначення або перешкоди ( іл. 46.2 ).
Після позначення району небезпеки, за можливості, залишайтесь у зоровому контакті із місцем, де розташована небезпека, до приїзду фахівців спеціальних служб та не допускайте туди сторонніх осіб. Фахівці спеціальних служб, що прибудуть на виклик щодо виявлення мін та ВНП, у разі неможливості ліквідувати небезпеку на місці, повинні негайно замінити встановлену саморобну систему позначення небезпечного району на постійну або тимчасову. Оскільки саморобна система позначення може містити підручні матеріали, у разі перебування на територіях, де відбувались бойові дії або поблизу них, необхідно бути пильним

). Якщо на певній ділянці розміщувався чи зараз перебуває
підрозділ, ця ділянка вважається небезпечною. На ній можуть бути боєприпаси та інші ВНП. Підходи до військової частини часто мінуються, і навіть після того, як військові покинули цей об’єкт, можуть лишатися складові елементи мін, розтяжок, боєприпасів тощо. Це потрібно чітко усвідомлювати і не заходити на ці території. Також вкрай небезпечними є будь-які військові фортифікаційні споруди: окопи, траншеї, ДОТ (довготривала оборонна/вогнева точка), блокпости тощо. Зазвичай підходи до них мінують. Також там можуть бути залишки боєприпасів та ВНП, інші види небезпек. Ознаки бойових дій / військової діяльності ( іл. 46.5 ). Після обстрілів та інших видів військової діяльності залишаються видимі ознаки у вигляді воронок, залишків боєприпасів та техніки (як цілої, так і пошкодженої вибухами), зруйновані будівлі, НВБ тощо. Слід пам’ятати, що приблизно 30% боєприпасів не розриваються і залишаються страшною загрозою для населення. Крім того, ці райони зазвичай мінують, тому можуть бути приховані невидимі небезпеки. Залишена




Іл. 46.7. Узбіччя доріг, ґрунтові дороги та лісосмуги

Іл. 46.8. Залишки мертвих тварин
Ділянки з видимими ознаками пошкодження ґрунту та травного покриття, залишками дротів, розтяжок, ниток, мотузок, ізоляції, скотчу тощо.
Водойми, переправи, мости та інші важливі елементи інфраструктури можуть бути замінованими. Тому потрібно бути уважними та не наражати себе на небезпеку.

1. Що таке ПМД?
2. Які міжнародні конвенції щодо захисту
3. Назвіть різновиди загроз під час воєнних дій.
4. Якими
5. Назвіть ознаки небезпечних територій.

(швидкої) медичної
ЕМД).
Важливість домедичної допомоги зумовлена тим, що допомогу постраждалому надають свідки на місці
будь-якому іншому місці

безпорадними й зможете надати
регти життя

%.
Ви розпочинаєте вивчення домедичної допомоги з найскладнішої

який не зникає під час відпочинку й
в нижню щелепу або ліву руку; якщо людина скаржиться на загальну слабкість, відчуття смерті, запаморочення, пітливість, порушення ритму серцевої діяльності, негайно викликайте бригаду ЕМД, зателефонувавши «103» або «112».

Своєчасний виклик бригади екстреної (швидкої) медичної допомоги у випадку гострого серцевого нападу може запобігти раптовій зупинці серця.
Друга ланка «ланцюжка
раптова зупинка серця й бригада ЕМД викликана, негайно
клітку. Ця маніпуляція не вимагає додаткового обладнання




3.
4.
5.
6. У чому полягає сутність «ланцюжка виживання»?

допомоги постраждалому, який полягає в послідовному
кроків, що найвірогідніше забезпечать урятування
Ви їх опануєте, якщо пройдете спеціальні сертифіковані курси з домедичної допомоги.

Головним правилом надання домедичної допомоги
серця в постраждалого й за потреби виконувати йому СЛР.
Отже, якщо ви стали свідком нещасного випадку, пов’язаного із раптовою зупинкою серця в дорослої людини, перед тим, як надавати домедичну допомогу, виконайте « Крок 1 »: переконайся, що вам, постраждалому й іншим особам не загрожує небезпека.
Крок 1 Чи місце події безпечне? На місці події загрозу життю та здоров’ю можуть становити: пожежа; аварійний витік газу; оголені електричні дроти; уламки, які можуть впасти; вибухонебезпечні предмети тощо.
За таких обставин необхідно відкласти
усунення небезпеки або прибуття рятувальних служб. Миттєво викликайте бригаду ЕМД (телефоном «103») і аварійно-рятувальну службу (телефоном «101»). Чітко виконуйте вказівки диспетчера.

Іл. 48.1.

Якщо загрози життю немає, і ви вирішили наблизитися до постраждалого, за можливості, подбайте про засоби особистої безпеки. Основними засобами безпеки, що використовують на етапі домедичної допомоги, є медичні рукавички та клапан-маска для штучної вентиляції легень
Розділ
домедичну допомогу.

Постраждалий може відмовитися від ваших послуг. Проте, якщо його стан серйозний, а причина відмови, на вашу думку, — порушення психіки, домедичну допомогу варто пробувати надавати.
Коли постраждалою є дитина, слід попросити дозволу в осіб, які її супроводжують (батьків, родичів тощо). Якщо дитина без супроводу — надавайте домедичну допомоги! Якщо постраждалий відмовився
контакт, зателефонуйте «103».

ведіть нижню щелепу (докладно з


обмежене, бо реально
нути на спину зі збереженням поздовжньої осі: голова–хребет ( іл. 48.4 ). Для цього обхопіть

« Чую! Бачу! Відчуваю!

розпочати виконання йому
виконайте « Крок 5 »: викличте
уже відомо, бригада прибуде із зовнішнім дефібрилятором, що значно підвищить шанси постраждалого на виживання. Крок 5 Зателефонуйте




1. Що
2. Які засоби індивідуального захисту необхідні при виконанні СЛР?
3. Як визначити, чи постраждалий притомний? Чи дихає?
4. Що слід насамперед виконати, коли постраждалий непритомний і не дихає?
5. З якою метою здійснюють натискання на грудну клітку?
6. Як правильно діяти після отримання автоматичного
дефібрилятора?

дання домедичної
дихання. Дихання
дихальних шляхів
дихання.
універсальний алгоритм домедичної допомоги
чити прохідність
2)
3)
Розділ 7. Домедична допомога
постраждалого. Часто після цього виникає запалення легень, яке може призвести до смерті;
4) у постраждалого, який потонув, у дихальні шляхи потрапляє вода, намул, водорості;
5) при запальних захворюваннях ротоглотки, особливо після сну, у дихальному горлі може накопичуватися надмірна кількість слизу, який виділяється епітелієм верхніх дихальних шляхів. У певних випадках він може перешкоджати диханню; 6) перешкоджати диханню можуть фрагменти травмованих м’яких тканин ротової порожнини й глотки, а також уламки нижньої та верхньої щелепи. Тому під час первинного обстеження після проведення контролю кровотечі та (за наявності) її усунення, ви маєте забезпечити постраждалому прохідність верхніх дихальних шляхів.

Іл. 49.1. Схема перекривання дихального горла в положенні

Іл. 49.2. Туалет ротової порожнини Якщо постраждалий лежить на спині,
чи бинтом, помітні сторонні предмети, кров’яні згустки, слиз, блювотні маси ( іл. 49.2 ). За наявності сторонньої рідини (кров, вода) одночасно голову і тулуб поверніть у правий чи лівий бік, відтягуючи вказівним пальцем кут рота вниз, що полегшує самостійне витікання рідини з ротової порожнини. У разі часткового закриття верхніх дихальних

силенням звуку під час
травму
підборіддя, як зображено на іл. 49.3 . За цих умов язик не закриває


330



Іл. 49.3. Забезпечення прохідності дихальних шляхів методом закидання голови та підняття підборіддя за умови відсутності підозри на травму голови та шиї Іл. 49.4. Забезпечення прохідності дихальних шляхів методом висунення нижньої
ними правилами. Ви

1. Чому важливо відновити прохідність
2. Назвіть
страждалих.
3. У чому полягає туалет ротової порожнини?
4.
5. Як забезпечити





Зауважте краєм ока, чи грудна клітка постраждалого піднялася, як при нормальному диханні — такі рятувальні видихи є ефективними. Утримуючи голову відведеною, а нижню щелепу — піднятою, відірвіть свій рот від рота постраждалого й спостерігайте, чи опускається його грудна клітка під час видиху.
Ще раз наберіть повітря й аналогічно виконайте другий видих у рот постраждалого. Метод
Цей метод ( іл. 50.4 ) застосовують у випадку неможливості розкрити рот або за його ушкодження. Утримуйте


ні тіла;
перевірте, чи голова правильно відігнута, а щелепа правильно піднята; виконайте 1–2 (не більше) спроби штучної вентиляції легень (ефективні чи неефективні) щоразу перед тим, як розпочнете знову натискати на грудну клітку.

Уникайте вдихання видихуваного повітря постраждалого. Це може перешкодити вам продовжувати штучну вентиляцію легень.

1. Чому важливо швидко виконувати
2.
3.
4.


Що вам відомо про непрямий масаж серця (зокрема, з уроків «Основи здоров’я» і «Біологія»)?
Вам уже відомо, що найважливішим методом, який сприяє виживанню постраждалого із раптовою зупинкою
є непрямий масаж серця . Його здійснюють шляхом натискання на грудну клітку







51.3). Нахиліться
Повторюйте натискання з частотою у межах 100–120 натисків за хвилину (трохи менше, ніж 2 натиски за секунду).
Час натискання і повернення грудної клітки до вихідної форми мають бути однаковими.

Зменшення глибин натиску чи частоти натискань негативно впливає на виживання постраждалих.

1.



Пригадайте, що таке фібриляція серця?
Вам уже відомо, що ефективними заходами рятування життя постраждалого з раптовою зупинкою серця є правильне натискання на грудну клітку і якнайшвидша електрична дефібриляція. Було доведено, що відтермінування дефібриляції на 1 хв зменшує виживання постраждалих
Її виконання протягом 1–2 хв після раптової
ленню роботи серця в більшості постраждалих. У зв’язку із цим у більшості розвинених країн світу в людних місцях на помітному місці розташовують шафки з автоматичним зовнішнім дефібрилятором (АЗД) ( іл. 52.1 ). Невдовзі така ситуація буде і в Україні. Тому вам важливо навчитися діяти в умовах наявності поблизу місця події, де сталася раптова зупинки серця, автоматичного зовнішнього дефібрилятора.
Коли ви стали свідком раптової зупинки серця, усе потрібно чинити за алгоритмом, який уже вам відомий:
оцініть, чи все навколо безпечно; якщо безпека очевидна, підійдіть до постраждалого, з’ясуйте рівень його свідомості; якщо постраждалий непритомний, покличте
когось із присутніх свідків події на допомогу; з’ясуйте, чи дихає постраждалий; за відсутності дихання попросіть свідка події викликати бригаду екстреної (швидкої) медичної
допомоги й принести АЗД, якщо він є поблизу;
робіть СЛР: 30 натискань і 2 видихи в тіло постраждалого; продовжуйте ці цикли, поки не
принесуть АЗД.
Далі дійте або самостійно, або попросіть помічника відкрити кришку АЗД. Здебільшого він вмикається автоматично, в окремих випадках для ввімкнення натисніть кнопку ( іл. 52.2 ).
серця сприяє

Іл. 52.1. Автоматичний



Іл. 52.5. Вмикання електричного розряду


аналіз серцевого ритму
За потреби пристрій скаже
необхідність вмикання розряду. Переконайтеся, що ви, інші
торкаються тіла постраждалого, і натисніть кнопку розряду ( іл. 52.5 ). Одразу


його команди.

Практика показала, що застосування автоматичного зовнішнього дефібрилятора до прибуття карети

1. У чому полягає складність
3.

4.

час. Наростаюча м’язова втома супроводжується
на
зменшується частота натискань, порушується ритм. Усе це зумовлює зниження тиску
різко погіршується.




( іл. 53.2
литися від такої роботи. Тому потрібно переконливо їм сказати, що їхня
має позитивний вплив і під час застосування автоматичного зовнішнього дефібрилятора. Виконуючи СЛР, треба якомога менше часу витрачати на паузи між натисканням на грудну клітку. Коли ви працюєте самі, то виникне тривала пауза для наклеювання електродів. Коли ви працюєте в парі, то один рятівник продовжує натискати на грудну клітку, інший у цей час наклеює електроди ( іл. 53.3 ). Паузи практично немає. А далі — виконуйте голосові накази автоматичного зовнішнього дефібрилятора.
Коли ви тренуватиметеся діяти в команді, то переконаєтеся, що це непросто. Усі люди за своїми рисами характеру різні. Хтось вроджений лідер, хтось виконавець, хтось інтелектуал, а хтось нетренований і після першого циклу 30 : 2 буде скаржитися, що втомився. Роль лідера найвідповідальніша, бо він ухвалює рішення. Тому лідерські якості в собі потрібно виробляти шляхом тренувань. Візьміть найрізноманітніші сценарії, коли в когось виникла раптова затримка кровообігу. Тренуйтеся як у ролі лідера, так
тися, ким насправді ви є.

серця
будь-де (у школі, на вулиці, у магазині тощо) і з будь-ким
рідними. І ви постійно маєте бути готовим надати допомогу. Це допоможе швидше оговтатися, коли хтось потрапив у біду, і прийняти правильні рішення.


1. У чому полягає складність СЛР за раптової зупинки серця?
2. Чому робота в команді сприяє підвищенню ефективності СЛР?
3. Як розподілити ролі, проводячи СЛР двома рятівниками?
4. Яка особливість роботи в команді під час використання автоматичного зовнішнього дефібрилятора?
5. Чому варто тренувати лідерські якості?

Пригадавши

надати допомогу. Це допоможе швидше оговтатися, коли хтось потрапив у біду, і прийняти правильні рішення. Деякі з них, можуть бути смертельно небезпечними, якщо їх
раненні великих кровоносних
трів. Відомо, що зниження систолічного (пульсового)
не тільки абсолютною величиною крововтрати. Стан
страху, втоми, голоду, виснаження від довготривалого захворювання погіршують наслідки кровотечі.

Об’єм крові в дорослої людини 4–6 л, в середньому 5 л. Прийнято розрізняти три ступені гострої крововтрати: легкий ступінь —

порожнини тіла. У постраждалого спостерігають частий слабкий пульс, часте дихання, бліду шкіру, прохолодну або вологу на дотик, нудоту, блювання, відчуття спраги, зниження рівня свідомості. Імовірне виділення крові з природних отворів організму (рот, ніс, вушний прохід, пряма кишка тощо). За підозри на ушкодження внутрішніх органів потрібно забезпечити постраждалому спокій (положення лежачи) і викликати лікаря. Перед цим бажано накласти на живіт чи груди міхур з льодом чи холодною водою. Холодний компрес полегшує біль і знімає припухлість. Використовуючи лід, загорніть його в марлю, рушник
тканину, перш

Іл. 54.1. Капілярна кровотечі

Іл. 54.3 Накладена асептична пов’язка Загальні симптоми характерні для
вотеч, в тому числі
порожнини. Вони проявляються блідістю, запамороченням, частим слабким пульсом, прогресуючим зниженням артеріального тиску. Залежно від того, яка судина ушкоджена, говорять про кровотечу капілярну , венозну і артеріальну . При капілярній кровотечі ( іл. 54.1 ) кров ніби сочиться з поверхні ушкодженої тканини. Інколи вона може зупинитися самостійно. У інших випадках підняття ушкодженої частини тіла та накладання пов’язки достатні для зупинки кровотечі ( іл. 54.2 ). Така пов’язка, крім того, захищає рану від забруднення та потрапляння в рану хвороботворних мікроорганізмів. Її називають асептичною ( іл. 54.3 ). Але

Розділ 7. Домедична допомога
При венозній кровотечі кров має темно-червоне забарвлення; витікає вона не краплинами, а безперервно й повільно ( іл. 54.4 ). Витікання струменем, що не пульсує, буває тільки у разі поранення великої вени. Для припинення її необхідно підняти Іл. 54.4. Венозна кровотеча ушкоджену кінцівку





дин серця (повітряна емболія) і смерть
Артеріальна кровотеча виникає при порушенні цілісності артерій, кров витікає з рани сильним пульсуючим струменем яскраво-червоного кольору ( іл. 54.9 ). Така кровотеча може досить швидко привести до гострого знекровлення. Самостійно така кровотеча зупиняється дуже рідко. АртеріІл. 54.9. Артеріальна кровотеча альна кровотеча може досить швидко призвести

342
наявність рани в критичній ділянці тіла (бокові поверхні шиї, внутрішня поверхня плеча, внутрішня поверхня стегна) ( іл. 54.10 ); інтенсивно просяклий кров’ю одягу і пов’язки в ділянці критичних зон тіла ( іл. 54.11, 54.12 );
наявність на поверхні, де розташований постраждалий, у проекції критичних зон, плями крові діаметром близько 0,5 м (ширини тіла постраждалого) або калюжі, яка збільшується ( іл. 54.13 );

Іл. 54.11. Інтенсивне


Іл. 54.10. Критичні ділянки тіла

54.14, 54.15 ); ампутація (відрив)

Іл. 54.14. Витікання крові з рани сильним пульсуючим струменем яскраво-червоного кольору
( іл. 54.16 ).

Іл. 54.15. Пульсація крові з рани, та калюжі крові, що швидко збільшується (схематичне зображення)

Швидке виявлення масивної кровотечі скорочує час зупинки кровотечі, зменшує

4.



Оцініть ситуацію і переконайтеся у власній безпеці. Телефонуйте за єдиним безкоштовним телефонним номером виклику екстрених служб «112» або «103». Під час надання домедичної допомоги подбай про особисту безпеку: обов’язково одягніть латексні(гумові) рукавички (при їх відсутності — використовуйте звичайні поліетиленові пакети) та, при можливості, захисні окуляри і марлеву пов’язку (маску). Це потрібно для попередження потрапляння крові на дрібні пошкодження шкіри рук та слизову оболонки ока, щоб захистити себе від патогенних мікроорганізмів, що передаються через
трапила кров, необхідно промити його теплою чистою
та звернутися за консультацією до лікаря.
Розпочніть надання допомоги тоді, коли вам нічого не загрожує.
Якщо в будь-який момент ваша безпека
лишіть небезпечне місце, знайдіть укриття і перемістіть пораненого, якщо це можливо; давайте поради на віддалі; з метою перевірки свідомості задайте питання пораненому, що потребує відповіді; при відповіді на запитання порадьте постраждалому самостійно зупинити кровотечу: накласти турнікет, джгут або закрутку чи здійснити прямий тиск на рану; при можливості, запропонуйте йому переміститись у безпечне місце та продовжити надавати самодопомогу; зателефонуйте «101» до служби порятунку або за єдиним безкоштовним телефонним номером
там залишатися, щоб уникнути збільшення кровотечі. Якщо в рані застрягло стороннє тіло, не виймайте його. Перев’яжіть місце поранення навколо нього і обв’яжіть його ватно-марлевою пов’язкою. Поверх, для стабілізації, можна накласти фіксуючу
іл. 55.2 ). C (Compress) — застосуйте прямий тиск на рану для зупинки кровотечі. Якщо у вас немає
стиснути пошкоджені кровоносні судини,
можливість
згорнутися, виграти час для підготовки інших кровозупинних засобів (засоби для тампонування, джгут, турнікет) і дасть час обміркувати ваші подальші дії. Чиніть тиск не менше 5 хвилин. Візьміть будь-яку чисту тканину (наприклад., сорочку) і накрийте рану, що є джерелом кровотечі ( іл. 55.3 ); якщо під руками є марлеві серветки або бинт — використовуйте їх; притисніть обома руками тканину до рани і натискайте з максимальною силою ( іл. 55.4 ). Якщо, внаслідок прямого тиску на рану, кровотеча зупинилася,
55.5 ). Якщо кровотеча продовжується, а рана велика і глибока,
затампонувати
рану тканиною, бинтом або марлею (іл. 55.6).
Якщо кровотеча внаслідок тампонування




у випадку критичних звернень (критична кровотеча) — 10 хв; у випадку екстрених звернень (наприклад, венозна кровотеча) — 20 хв. Можливий інший варіант здійснення прямого тиску на рану. Для цього необхідно, при можливості, надати травмованій кінцівці такого положення, при якому вам буде зручно максимально натиснути на рану пальцями або долонею, причому краще це зробити через стерильну марлю або шматок чистої тканини ( іл. 55.7, 55.8 ). Якщо поранений притомний, ви можете запропонувати йому самому здійснити прямий тиск на рану, якщо його стан дозволяє це зробити ( іл. 55.9 ).

Іл. 55.7. Прямий тиск на рану пальцями з підняттям кінцівки
тиск на рану


Іл. 55.9. Самостійне





5.
6.

одночасно дійте за алгоритмом АВС для визначення можливого виникнення зупинки дихання і кровообігу.
Види джгутів та турнікетів Отже, якщо кровотеча на кінцівці не зупинилась після прямого тиску на рану, компресійної пов’язки і тампонування рани, завершальним кроком має бути накладання джгута або джгута-турнікета. Найпоширеніші з них: джгут з еластичної гуми типу Есмарха ( іл. 56.4 ), спеціальний джгут (турнікет) типу САТ ( іл. 56.5 ) українського виробництва СІЧ
(турнікет) з підручного матеріалу.

Іл. 56.4. Джут з еластичної гуми типу


Накладання САТ можливе і як самодопомога, і як взаємодопомога, як на руці, так і на нозі, як двома, так і однією рукою. Турнікет СПАС, або СІЧ, що виробляється в Україні, є
турнікета типу САТ, його вважають
засобів. СПАС
ві, накладають турнікет якомога
і доволі ефективним методом зупинки артеріальної
на кінцівках ( іл. 56.7 ).
Проте людина, яка надає
пам’ятати, що накладений джгут
надходження крові до ділянок, які розташовані нижче місця накладання, і, при не виконанні
Розділ 7. Домедична допомога
венозний відтік крові, при одночасному збереженні артеріального кровотоку.
Турнікет не слід періодично послаблювати
для відновлення кровопостачання тканин. Є ризик різкого падіння артеріального тиску, а в деяких випадках і смерті внаслідок утрати
крові малими об’ємами.
При ампутації (відриві) кінцівки турнікет потрібно накласти вище місця ампутації на 5–6 см і, при необхідності, він може залишатись
бльше 2 годин.
Слід уникати накладання турнікета на коліно і лікоть, так як це не зупинить кровотечу (судини сховані між кістками), проте може травмувати шкіру навколо суглобу.
Не накладайте турнікет на місця розташування кишень, бо речі, які там є (наприклад, ключі, мобільний телефон тощо), зменшують тиск на кінцівку і будуть перешкоджати зупинці кровотечі.

Іл. 56.7. Схематичне зображення місце накладання кровозупинного турнікета або джгута

Послідовність зупинки кровотечі з ран кінцівок: прямий тиск на рану компресійна пов’язка тампонування рани . Джгут або турнікет потрібно
якщо всі попередні заходи виявилися безуспішними. Джгут або турнікет накладають при масивних
а також травматичних ампутаціях (відривах) частин кінцівок.

Спеціальний кровоспинний джгут (Combat Application Tourniquet, САТ), розроблений у США, має вигляд стрічки з липучкою зі спеціальними пристосуваннями. У 2005 р.

350
між паском і пораненою кінцівкою, та надійно приклейте його до решти турнікета. Не приклеюйте стрічку далі за фіксатор закрутки.
Розмістіть турнікет у верхній третині плеча або стегна.
Закрутіть стержень (в більшості випадків — переважно тричі), поки кровотеча не зупиниться. Перевірте відсутність пульсу нижче поранення.
Закріпіть закрутку в кліпсі (ріжках-фіксаторах).
Закріпіть стрічку для написання часу і вільним кінцем стрічки обгорніть її залишок навколо кінцівки через кліпсу та
поверх стержня.
Запишіть час, коли було накладено турнікет.
На рану кінцівки накладіть асептичну
пов’язку ( іл. 56.8 ).

1. Одягніть сформовану стрічкою-липучкою петлю турнікета на поранену кінцівку. Турнікет має бути на 6–8 см вище місця кровотечі

5. Зафіксуйте стержень у кліпсі. Перевірте, чи зупинилася кровотеча, чи є пульс

2. Міцно затягніть турнікет, потягнувши за край стрічки

Іл. 56.8. Накладені на руку: а) турнікет (якомога вище, просто поверх одягу); б) асептична пов’язка

3. Зафіксуйте стрічку навколо кінцівки до кліпси за допомогою двосторонньої липучки

6.

4. Закручуйте стержень до зупинки артеріальної кровотечі та зникнення периферичного пульсу

7. Зафіксуйте

1. Одягніть турнікет навколо пораненої кінцівки. Розташуйте турнікет на 6–8 см вище місця кровотечі, протягніть край стрічки через внутрішній отвір пряжки. Міцно затягніть джгут

2. Протягніть край стрічки через зовнішній

4.
та зникнення периферичного пульсу. Зафіксуйте стержень у

3. Зафіксуйте стрічку навколо кінцівки до кліпси за допомогою двосторонньої липучки


місце кровотечі.
Потрібно обов’язково вказати час накладання джгута, для цього на видному місці роблять відповідний запис, наприклад маркером або кульковою ручкою на пов’язці, шкірі або на папері, який вкладають між турами джгута.
Якщо джгут накладено правильно,
рану
накладання
Вище місця кровотечі кінцівку обгорніть м’яким матеріалом (одяг, рушник, бинт) для того, щоб унаслідок накладання джгута не створювати складки шкіри, защемлення яких посилює біль ( іл. 56.12 ). Джгут просовують під кінцівкою і максимально розтягують на рівні однієї і двох третин його довжини ( іл. 56.13 ). Накладають перший тур, не послаблюючи джгут, наступними турами покривають на 1/3 попередній, дещо зменшуючи тиск, але так, щоб не допустити послаблення першого. Вільні
джгута закріплюються спеціальними фіксаторами ( іл. 56.14 ).
Якщо джгут накладено правильно, то нижче місця накладання зникає пульс, кінцівка блідне, стає холодною на дотик, припиняється кровотеча ( іл. 56.15 ).
На видному місці роблять відповідний запис, наприклад маркером або кульковою ручкою на пов’язці, шкірі або на папері, який вкладають між турами джгута Постраждалого транспортують у лежачому положенні, здійснивши транспортну іммобілізацію. Накладають







том або зав’язують вільними кінцями ( іл. 56.18 ). Точний час записують на клаптику паперу або на шкірі. Треба враховувати можливість травмування м’яких тканин у разі використання тонких шнурків, дроту, кабелю, а також надто щільного закручування.


Іл. 56.16. Накладання

Іл. 56.17. Накладання джгута-закрутки (турнікета) з підручного матеріалу (варіант)


Іл. 56.18. Накладання джгута-закрутки з підручного матеріалу (варіант)

слова турнікет).
Алгоритм дій перед транспортуванням у разі
кінцівці наведено на іл. 56.19

1. Якими
2. Який стандартний
3.
4. Які особливості накладання

5. Які правила слід пам’ятати
6. Як виконати зупинку кровотечі
7. Яка послідовність
марха?
8. Складіть

і пахвинних ділянок ( іл. 57.2 ). Для тампонування рани з метою зупинки кровотечі слід використовувати спеціальний кровозупинний бинт - стерильний бинт, який був просочений кровозупинними засобами та для зручності користування складений Z-подібно або «гармошкою» типу Combat Gauze (бойова марля) ( іл. 57.3 ). Іл. 57.1. Місця можливих «вузлових кровотеч»



57.3. Кровозупинний бинт Іл. 57.2. Проведення тампонування рани
Отже, якщо після проведення прямого тиску на рану шиї, підпахвових і пахвинних ділянок протягом 3-5 хвилин кровотеча продовжується, та при наявності перев’язувальних кровозупинних стерильних засобів або стерильного/чистого перев’язувального матеріалу (бинт, марля тощо),
дальша




марлею) ( іл. 57.6 ). Якщо цього недостатньо, використайте другий кровозупинний
чайний стерильний бинт, доки буде можливість втиснути їх усередину рани, та продовжіть тиск на рану протягом щонайменше трьох хвилин. При здійсненні тампонування потрібно дотримувати таких правил: уважно огляньте рану після промокання крові серветкою і, при можливості, виявіть місце кровотечі; своєю правою рукою притисніть судину в цьому місці до кістки в глибині рани, щоб зменшити кровотечу; якщо кровотеча з пахвинної ділянки, притисніть стегнову артерію на відстані (це можна зробити, притискаючи судинний пучок власним коліном ( іл. 57.7 ) і одночасно підготуйте кровозупинний або стерильний бинт до використання; візьміть в ліву руку кілька петель бинта і підведіть його під пальці правої руки, якою продовжуйте тиск на судину з використанням підведених петель; повторіть цей прийом до заповнення рани, не послаблюючи тиску правою рукою; після повного тампонування рани, здійсніть прямий тиск на рану двома руками протягом щонайменше 10 хвилин за використання звичайного




пальцями (на 1–15 хв) ( іл. 57.11 ). Можна також щільно затампонувати




1. Що таке
2.
3.
4. Для

рани?
5. Чи варто застосовувати кровозупинний
6. Що робити, якщо тампонування
8.

компресійна пов’язка може
Для її накладання використовують бинт, бажано еластичний,
також такі спеціальні перев’язувальні засоби, як індивідуальний перев’язувальний пакет та ізраїльський бандаж.
Компресійна пов’язка
зупинки масивної зупинки кровотечі і застосовується для:
зупинки венозної кровотечі (іл. 58.1);
зупинки масивної кровотечі:
після прямого тиску на рану, якщо кровотеча зупинилась
чна ( іл. 58.2 );
після тампонування рани, якщо кровотеча
( іл. 58.3 );

Іл. 58.1 Накладання компресійної пов’язки для зупинки венозної кровотечі

Іл. 58.2
тиску

Іл. 58.3 Накладання компресійної пов’язки після тампонування
Послідовність накладання компресійної пов’язки
Накладіть на рану стерильну або чисту марлеву серветку ( іл. 58.4 );
Поверх серветки (над усією поверхнею рани) накладіть


Іл. 58.5. Поверх серветки накла-
діть валик з бинта (вати, мобільного телефону), за допомогою якого створюватиметься тиск

Іл. 58.6 Використання еластичного бинта для накладання компресійної пов’язки

Іл. 58.7. Прикладання до рани міхура з льодом
Особливості накладання і використання компресійної пов’язки.
Не затягуйте компресійну пов’язку настільки сильно, щоб вона перешкоджала кровообігу. Валик, що підкладається під бинт, стискає поранені кровоносні судини і зупиняє кровотечу. Якщо шкіра кінцівки
че компресійної пов’язки стає холодною на дотик, стає блідою, синіє або німіє, а пульс не промацується — вона затягнута занадто сильно. При таких порушеннях циркуляції
транспортуванні постраждалого
вального закладу, заміна
проводитись медичними працівниками якомога швидше,
ня. Отже, тривалість доставки такого постраждалого до лікувального закладу не повинна перевищувати вказаний термін.

При зупинці масивної кровотечі
кінцівках перевага надається прямому тиску на рану, тампонуванню рани, компресійній пов’язці та їх поєднанню. Нерідко доводиться використовувати комбінацію цих способів. Якщо ці методи не зупиняють кровотечу, накладають турнікет (джгут).



Накрийте
Еластичним бандажем обгорніть кінцівку 1 раз.
Проведіть його через отвір аплікатора для створення тиску на рану.
Поверніть в протилежний бік, притискаючи аплікатор до












1.
2.
3.
4.
5. Яка послідовність накладання індивідуального перев’язувального
6.
пресійної пов’язки?
7. Як накладається ізраїльський

зони) представниками штатних
розділів передбачає: відтягування пораненого із зони обстрілу, а) бойовим
(одним стрільцем-санітаром); б) двома стрільцями-санітарами; винесення пораненого із зони
а) одним стрільцем-санітаром; б) двома стрільцями-санітарами; в) на санітарних ношах ланкою санітарів-носіїв. Ці заходи здійснюють під вогневим прикриттям; із

ста безпека санітара. Під час відтягування пораненого
пораненою особі, яка надає допомогу. Зменшувати цю небезпеку можна різними шляхами. За можливості, поранені мають самі собі накласти турнікет (джгут) і самостійно відповзти чи навіть відбігти з небезпечного місця. Якщо цієї можливості немає, основним способом захисту бойового медика взводу (стрільця-санітара) від поранення під час зупинки масивної
кровотечі та відтягування пораненого з небезпечної зони є вогнева перева-
га воїнів свого підрозділу.
Підповзаючи до пораненого (якщо можливо — з боку голови), важливо не підніматися вище його тіла, таким чином захищаючи себе від ураження супротивником. Потрібно попередити постраждалого про своє наближення, щоб він не відкрив вогонь у ваш бік. Важливо пам’ятати, що поведінка пораненого може бути непрогнозованою, і для запобігання цьому необхідна дружня підтримка, використання подібних до цієї фрази: «Друже, я біля тебе, зараз допоможу». Відтягування пораненого бойовим медиком взводу (стрільцем-санітаром). Залежно від характеру поранення, він може відтягнути на собі пораненого в положенні на боці ( іл. 59.1 ), на спині ( іл. 59.2 ),


ревертається на живіт, ноги
мають опинитися між його ногами. Рухається бойовий медик, відштовхуючись від землі тільки однією ногою, поки не втомиться, після чого відштовхується іншою ногою. Це дає можливість уникнути розкачування і звалювання пораненого зі спини
час руху. Зброю свою і постраждалого бойовий медик утримує на передпліччі вільної руки.
Небезпечніше для бойового медика — самому відтягувати пораненого стоячи або навприсядки, утримуючи за спорядження (ззаду — за евакуаційну петлю ( іл. 59.3 ), або
збоку — за лямку бронежилета ( іл. 59.4 а, б, в, г ), за підпахвові ділянки ( іл. 59.5 ) або за передпліччя ( іл. 59.6 ). У цьому випадку він
помітною мішенню для супротивника, а рух потребує великих енерговитрат, і тому його можна здійснювати на дуже обмежені відстані. Якщо виникла загроза, бойовий

Іл. 59.3. Відтягування
може вести вогонь у відповідь, прикриваючись тілом
далого.
ного солдата. Застосування допоміжних
ка, м’які ноші, плащ-намет,


Іл. 59.6. Відтягування
створює можливість супротивнику обстрілювати


ноші ( іл. 59.10 ) або плащ-намет
в безпечну зону ( іл. 59.11 ). У
прикриваючи себе і постраждалого.

Іл. 59.9. Відтягування пораненого двома стрільцями-санітарами за спорядження (лямки бронежилета)

Іл. 59.10. Укладання пораненої
Винесення пораненого на руках

Іл. 59.11. Відтягування пораненої на м’яких ношах двома стрільцями-санітарами
зони обстрілу одним стрільцем-санітаром. Від своєчасності й правильності організації винесення поранених з поля бою залежить їхнє життя. Необхідно швидко винести пораненого із зони обстрілу (червоної зони) в укриття
і
сприяти пересуванню, використовують спосіб підтримування пораненого
або спосіб Гауса ( іл. 59.13 ), можна легко і швидко застосовувати,

Іл. 59.12. Підтримування пораненої одним стрільцем-санітаром

Іл. 59.13. Винесення на спині (спосіб Гауса)
На руках перед собою можна виносити як

Іл. 59.14. Винесення
пораненого, так і притомного. Якщо поранений притомний, то він, притримуючись, обнімає стрільця-санітара за плечі ( іл. 59.15 ).
Щоб винести пораненого на плечах ( іл. 59.16 ), стрілець-санітар надає йому напівсидячого положення, а сам стає на коліно і просовує голову під його праву руку, потім обхоплює тіло постраждалого
плече. Цим способом
повідь.


Іл. 59.16. Винесення пораненого одним стрільцем-санітаром
утворюють ланку. Вони мають уміти використовувати різні способи винесення
обстрілу. Особливо
(ходи сполучення, траншеї, підвали тощо).

Іл. 59.17. Винесення пораненої на стіні ланкою санітарів-носіїв (спосіб Гауса)
§ 59. Техніка винесення

Іл. 59.18. Винесення пораненої ланкою санітарів-носіїв за плечі та ноги («один за одним»)
Щоб винести пораненого на руках, санітари-носії створюють сидіння за допомогою трьох або чотирьох рук. Якщо поранений непритомний або не
може триматися за шиї санітарів-носіїв, вони
один до одного, кожний опускається на одне коліно (санітар-носій з лівого боку — на ліве, з правого — на праве), підкладають під сідниці постраждалого «замок» з трьох рук ( іл. 59.19 а ) як сидіння, (четверта рука
із санітарів-носіїв, яка покладена на плече другого, буде опорою для спини постраждалого) і піднімаються для руху в повний зріст. За відносно доброго стану пораненого,
може трохи підвестися, сісти на руки санітарів і триматися за шию, застосовують для сидіння «замок» із чотирьох рук ( іл. 59.19 б ), ( іл. 59.20
( іл. 59.21 ). Ланка санітарів-носіїв



Розділ

може переносити постраждалих на ношах на значно


368



1.
основі чого визначають спосіб винесення пораненого з поля бою в кожному конкретному випадку?
2. Назвіть способи відтягування пораненого з небезпечної зони.
3. Як здійснюють відтягування пораненого на боці? Опишіть дії
медика взводу або стрільця-санітара, який, спостерігаючи за полем бою, побачив, що один з військовослужбовців отримав поранення передньої поверхні грудної клітки.
4. Як підготувати і відтягнути пораненого
спині? Опишіть дії стрільця-санітара, який, спостерігаючи за полем бою, побачив, що один з військовослужбовців отримав поранення правого стегна.
5. Які способи відтягування пораненого однією людиною стоячи або навприсядки? Які особливості кожного з
те кожен із цих способів?
6. Як здійснити відтягування пораненого із зони обстрілу на плащ-наметі? Що необхідно мати для цього, які переваги і недоліки цього способу порівняно з іншими?
7. Назвіть способи винесення пораненого на руках із зони обстрілу одним стрільцем-санітаром. Охарактеризуйте їх. За яких ситуацій ви будете використовувати кожен з названих вами способів?

8. Продемонструйте відомі вам способи винесення пораненого на руках із зони обстрілу одним санітаром, використовуючи як пораненого вашого однокласника чи однокласницю.
9. Опишіть дії стрільця-санітара, який, спостерігаючи за полем бою, побачив, що один з військовослужбовців отримав поранення лівого плеча.
10. Розкажіть, як можна винести пораненого з поля бою ланкою санітарів-носіїв. Які особливості використання кожного із цих способів? Групою з трьох осіб продемонструйте
вами способів. 11. З якою умовою і як здійснюють винесення пораненого на
Азимут (від араб. ас-салет –
шлях, напрямок) — кут між на-
прямком на північ та напрямком
на даний предмет. Б
Бліндаж — (фр. blindage, від фр. blinder — покривати заслонами) —
укриття, влаштоване на бойових
позиціях для захисту групи воїнів
від артилерійського та іншого вог-
ню супротивника.
Боєприпаси, що не вибухнули (НВБ) — вибухонебезпечні предмети, підготовлені до використання
або використані шляхом встановлення капсуля, запала/детонатора, переведення в бойове положен-
ня або іншим чином. Вони могли
бути вистрілені, скинуті, запущені
або випущені, проте не вибухнули
або через несправність, або конструкцію, або з будь-якої іншої причини. В
Вибухонебезпечні залишки війни (ВЗВ) — це боєприпаси, що не
вибухнули (НВБ) та залишені вибухонебезпечні боєприпаси (ЗВП).
Вибухонебезпечні предмети (ВНП) — вибухові матеріали промислового призначення та саморобного виготовлення, боєприпаси, що містять вибухові речовини, а також біологічні та хімічні речовини: бомби і боєголовки; керовані і балістичні ракети; артилерійські, мінометні, ракетні боєприпаси і боєприпаси до стрілецької зброї; усі
міни, торпеди і глибинні бомби; піротехнічні
370 А
бів. Висота перерізу рельєфу (від. лат. relevo — піднімаю) — відстань між двома сусідніми основними горизонталями по висоті.
Військова дисципліна — це бездоганне й неухильне додержання військовослужбовцями порядку та правил, установлених військовими статутами й іншим законодавством України.
Військовий полон — це тимчасове обмеження
Внутрішній порядок — це суворе додержання визначених військовими статутами правил розміщення, повсякденної діяльності, побуту військовослужбовців у військовій частині й несення служби добовим нарядом.
Вогнепальна зброя — зброя, у якій для викидання снаряда (міни, кулі) із каналу ствола використовується сила тиску газів, що утворюються під час згоряння метальної вибухової речовини (пороху) або спеціальних горючих сумішей.
вана на вирішення завдань захисту інтересів держави від зовнішніх та внутрішніх загроз.
Глибина строю — відстань від першої шеренги (військовослужбовця, що стоїть попереду) до останньої шеренги (військовослужбовця, що стоїть позаду).
Горизонталі — це замкнуті лінії, що проходять через точки місцевості з однаковою абсолютною
висотою
Гостра променева хвороба —
розвивається через одноразове, повторне або тривале (від кількох
годин до чотирьох діб) зовнішнє
гамма- і нейтронне опромінення всього тіла або більшої частини
його в дозі, яка перевищує 1 грей (100 рад).
Гуманітарне розмінування — комплекс заходів, які проводяться
операторами протимінної діяльності з метою ліквідації небезпек, пов’язаних із вибухонебезпечними предметами, включаючи нетехнічне та технічне обстеження територій, складення карт, виявлення, знешкодження та (або) знищення вибухонебезпечних предметів, маркування, підготовку документації після розмінування, надання громадам інформації щодо протимінної діяльності та передачу очищеної території. Д Двошеренговий стрій — стрій, у якому військовослужбовці однієї шеренги розміщені за військовослужбовцями іншої шеренги на відстані одного кроку (витягнутої руки, покладеної долонею на плече військовослужбовця, що стоїть попереду).
Дезінфекція — знищення заразних мікробів і руйнування бактеріальних токсинів на об’єктах, які
були заражені.
Директриса (військового стрільбища) — напрямок стрільби.
Дистанція — відстань у глибину між військовослужбовцями (машинами), підрозділами та частинами.
Довгострокові вогневі споруди — різновид фортифікаційних споруд, призначених для підвищення ефективності застосування зброї та військової техніки, забезпечення стійкого управління військами, захисту військ і населення від засобів ураження супротивника.
Доза — кількість речовини, яка діє на організм, виражається як маса (об’єм) лікарської речовини (г, мг, мл) або маса (об’єм) речовини на одиницю маси (мг/кг; мл/ кг); разова доза може бути мінімальною (пороговою), середньою й вищою.
Е
Евакуація — комплекс заходів щодо організованого вивезення (виведення) населення з районів, зон можливого впливу наслідків надзвичайних ситуацій і розміщення його в безпечних районах у разі виникнення безпосередньої загрози життю та заподіяння шкоди здоров’ю людей.
Епідемія — масове поширення інфекційної хвороби серед населення відповідної території за короткий проміжок часу.
Епізоотія — широке поширення заразної хвороби тварин за короткий проміжок часу, що значно перевищує
Словник термінів
що значно перевищує звичайний рівень захворюваності на цю хворобу на відповідній території.
Загиблі (померлі) — особи, які
загинули з причин, пов’язаних із
веденням воєнних дій.
Залишені вибухонебезпечні
боєприпаси (ЗВБ) — вибухонебезпечні боєприпаси, що не були
використаний під час збройного
конфлікту і більше не знаходяться під контролем жодної зі сторін
конфлікту.
Інтервал — відстань по фронту
між військовослужбовцями (машинами), підрозділами та частинами.
Інфекція — біологічне явище, суть якого полягає в специфічній взаємодії сприйнятливого організму-хазяїна (тварини, людини, рослини) з патогенними мікроорганізмами-збудниками внаслідок проникнення останніх в макроорганізм і розмноження їх там; виявляється в різних формах — від носійства та інапарантної інфекції до інфекційної хвороби.
Інформаційна війн а — це ви-
кладення інформації у спосіб, який формує у суспільстві чи групі людей потрібну точку зору, гро-
мадську думку, хід взаємодопов-
нюючих логічних думок, вичерпну систему поглядів щодо окремих питань на користь організатора
важливих інтересів людини і громадянина, суспільства та держави під час використання кіберпростору, за якої забезпечуються сталий розвиток інформаційного суспільства та цифрового комунікативного середовища, своєчасне виявлення, запобігання і нейтралізація реальних і потенційних
ці
у
Кіберзахист
сукупність
ганізаційних, правових, інженерно-технічних заходів,
заходів криптографічного та технічного захисту інформації, спрямованих на запобігання кіберінцидентам, виявлення та захист від кібератак, ліквідацію
наслідків, відновлення сталості і надійності функціонування комунікаційних, технологічних систем.
Кокарда — знак установленого зразка на головному уборі.
Колективна безпека — система
спільних дій держав, установленою Статутом ООН для підтримки міжнародного миру й безпеки, запобігання (придушення) агресії.
Колона — стрій, у якому військовослужбовці або підрозділи (машини) розміщені один (одна) за одним (одною)
пового патологічного процесу в
організмі, що характеризується
високою температурою (>37,5°С),
але відрізняється від перегрівання (гіпертермії) принципово іншим механізмом розвитку; виникає в разі впливу на організм екзо- і ендогенних речовин, що підвищують температуру тіла і спричинюють гарячку (пірогени). М
Магнітний азимут — це кут між напрямками на Північний магнітний полюс і на даний об’єкт.
Міжнародне гуманітарне право (МГП), або право збройних конфліктів — це система міжнарод-
но визнаних юридичних правових норм і принципів, які діють під час
міжнародних та внутрішньодержавних збройних конфліктів. Н
Навчальна зброя — спеціаль-
но приведена в непридатний для стрільби стан шляхом просвердлювання отворів у казенній частині ствола та вилучення чи вкорочу-
вання бойка; призначена для навчання правилам поводження зі зброєю.
Навчання з попередження ри-
зиків від вибухонебезпечних предметів — заходи, спрямовані на зменшення ризику тілесного ушкодження, спричиненого вибухонебезпечними предметами, шляхом підвищення інформованості населення
Надзвичайна ситуація — обстановка на окремій території, суб’єкті господарювання або водному об’єкті, яка характеризується порушенням нормальних умов життєдіяльності населення, спричинена катастрофою, аварією, пожежею, стихійним лихом, епідемією, епізоотією, епіфітотією, застосуванням засобів ураження
або іншою небезпечною подією, що призвела (може призвести) до виникнення загрози життю або здоров’ю населення, великої кількості загиблих і постраждалих, завдання значних матеріальних збитків, а також до неможливості проживання населення на такій території чи об’єкті, провадження на ній господарської діяльності. Нарізна вогнепальна зброя — така зброя, що має ствол або стволи тільки з нарізними каналами. Національна безпека — це захищеність державного суверенітету, територіальної цілісності, демократичного конституційного ладу та інших національних інтересів України від реальних та потенційних загроз. Національні інтереси — життєво важливі інтереси людини, суспільства і держави, реалізація яких забезпечує державний суверенітет України, її прогресивний демократичний розвиток, а також безпечні умови життєдіяльності і добробут її громадян. Національний спротив — це комплекс заходів, які організовуються та здійснюються з метою сприяння обороні України шляхом максимально широкого залучення громадян України до дій, спрямованих на забезпечення воєнної безпеки, суверенітету і територіальної цілісності держави, стримування і відсіч агресії та завдання противнику неприйнятних втрат, з огляду на які він буде змушений припинити збройну агресію проти України.
Об’єкти цивільної оборони — це сховища, які призначено для захисту населення (бомбосховища, протирадіаційні укриття, пункти управління тощо).
Онлайн-спілкування — це осо-
Словник термінів
блива форма комунікації, в процесі якої відбувається взаємодія людей
один з одним в мережі Інтернет, та
здійснюється шляхом обміну знаковими, та/або мультимедійними повідомленнями.
Оптичний приціл — це оптичний прилад, призначений для точного наведення зброї в ціль.
Особа, безвісно відсутня , — людина, що зникла під час ведення
воєнних дій і місцезнаходження якої невідоме.
Перев’язка — процес накладання пов’язки на рану та лікувальні
маніпуляції, які проводяться для її підготовки, об’єднуються під терміном.
Підготовка громадян України до національного спротиву (загальновійськова підготовка громадян) — сукупність заходів із метою формування патріотичної свідомості та стійкої мотивації громадян, набуття ними знань і практичних умінь, необхідних для захисту України.
Погон — наплічний або нагруд-
ний елемент форменого одягу, на якому розміщені знаки розрізнен-
ня військового звання та інші еле-
менти військової символіки.
Позумент — плетений золотави-
ми або сріблястими нитками шнур.
Поранення — порушення ціліс-
ності шкірних покривів або слизо-
вих оболонок людини, що супрово-
джується болем, зовнішньою або внутрішньою кровотечею, ушко-
дженням внутрішніх органів, а
різних шкідливих домішок, що є в повітрі. Протимінна діяльність (mine action) — заходи, що проводяться з метою забезпечення національної безпеки та спрямовані на зменшення соціального, економічного та екологічного впливу
374
медичних заходів, спрямованих на відновлення життєдіяльності вмираючого організму; оживлення організму після клінічної смерті.
Респіратор — прилад для індивідуального захисту органів дихання від пилу, отруйних випаровувань, газів тощо; фільтрувальна напівмаска, яка має два вдихальних i один видихальний клапан із запобіжним екраном, наголовником, носовим затискачем. Рельєф місцевості — сукупність різних нерівностей
один за одним.
Систем г еографічних координат — система, у якій розміщення точки на земній поверхні визначається кутовими величинами (широтою та довготою) відносно площини екватора та початкового меридіана.
Система колективної безпеки — сукупність спільних заходів держав задля підтримання миру, запобігання війні, припинення актів агресії та надання колективної
допомоги.
Стереотруба — оптичний прилад, що складається з двох перископів, з’єднаних разом окулярів і розведених у сторони у об’єктивів, для спостереження віддалених
предметів двома очима.
Стихійне лихо — природне явище, що діє з великою руйнівною
силою, заподіює значну шкоду території, на якій відбувається, порушує нормальну життєдіяльність населення, завдає матеріальних
збитків.
Стрілецька зброя — ствольна
зброя для стрільби кулями та іншими видами патронів; наймасовіша з усіх видів сучасної зброї.
Стрільба — ведення вогню з різ-
них видів зброї. Терміном «стрільба» позначають також наукову дисципліну, яка розробляє теорію
стрільби і предмет бойової підготовки. Стрільбу поділяють на бойову, навчальну
тощо фортифікаційна споруда, що влаштовується (закладена) в оборонному бою.
Унітарний патрон — складові сучасного заряду об’єднані в одному пристрої.
Фланг — правий (лівий) край строю. Під час поворотів назви флангів не змінюються. Фронт — бік строю, до якого військовослужбовці повернені обличчям, а машини — лобовою частиною.
Цивільний захист (ЦЗ) — це функція держави, спрямована на захист населення, територій, навколишнього природного середовища та майна від надзвичайних ситуацій (іл. 35.1) шляхом запобігання таким ситуаціям, ліквідації їх наслідків і надання допомоги постраждалим у мирний час і в особливий період.
Цифрова грамотність — це набір знань, умінь та навичок, які необхідні для безпечного та ефективного використання цифрових технологій та ресурсів інтернету. Ш
Шеренга — стрій, у якому військовослужбовці розміщені один біля одного на одній лінії. Шок — стан сильної
1. Бойовий статут механізованих і танкових військ Сухопутних військ ЗСУ Ч. ІІІ. — Київ, — 2016. — 332 с.
2. Військова токсикологія, радіологія, медичний захист: підручник / за ред. проф. О.Є. Левченка. — К. : СПД Чалчинська Н. В., 2017. — 788 с.
3. Військова топографія: Навчальний посібник. /А.М. Кривошеєв, А.І. Приходько, В.М. Петренко, Р.В. Сергієнко. – Суми: Видавництво СумДУ, 2010. – 281 с.
4. Вогнева підготовка. Навчальний курс. СТІ 000Г.09Л. ЦОСМП ЗСУ та ГУП ЗСУ, 2019.
5. Вогнева підготовка : навч. посіб. (з метод. рек.) / В. В. Василенко, В.М. Дзюба, О.Ю. Окунський, Б.І. Пилипів; За ред. Б.І. Пилипіва К.: Вид. ПАЛИВОДА А. В., 2003. – 272 с.
6. Вогнева підготовка: навч. посіб. / М.М. Ляпа, В.М. Петренко, О.І. Судніков, та ін. — Суми: Сумський державний університет, 2011. – 283 с.
7. Воєнна безпека. Стратегічне планування. Терміни та визначення. Військовий стандарт ВСТ 01.004.002 – 2019 (02). Центр воєнно-стратегічних досліджень НУОУ, 2019. — Режим доступу: https://drive.google. com/file/d/12C4hTmnE1ygCwbjSDZRHy11XDSH2GIuv/view
8. Домедична допомога (алгоритми, маніпуляції): Методичний посібник / В. О. Крилюк, В. Д. Юрченко, А. А. Гудима [та ін.]. — К. : НВП «Інтерсервіс», 2014. — 84 с.
9. Домедична допомога. Серцево-легенева реанімація. (алгоритми та маніпуляції: методичний посібник / Крилюк В. О., Кузьмін В. Ю., Кузьмінський І. В. — К., 2017. — 73 с.
10. Домедична допомога. Травма. (алгоритми та маніпуляції: методичний посібник / нфліктів: Навчальний посібник / Бадюк М. І., Ковида Д. В., Микита О. О., Козачок В. Ю., Середа І. К., Швець А. В. // За редакцією професора Бадюка М. І. — К. : СПД. Чалчинська Н. В. — 2018. — 212 с.
11. Екстрена медична допомога на догоспітальному етапі: навчальний посібник / [В. О. Крилюк, С. О. Гур’єв, А. А. Гудима, Н. І. Іскра та ін.]. — Київ. — 2016. — 400 с.
12. Закон України «Про військовий обов’язок і військову службу». — Режим доступу: https://zakon.rada.gov.ua/laws/show/2232-12#Text
13. Закон України «Про екстрену медичну допомогу».
https://zakon.rada.gov.ua/laws/show/5081-17#Text
14. Закон України
15.
16.
17.
https://zakon.rada.gov.ua/laws/show/1934-12#Text
https://zakon.rada.gov.ua/laws/show/2469-19#Text
https://zakon.rada.gov.ua/laws/show/1702-20#Text
пу: https://zakon.rada.gov.ua/laws/show/389-19#Text
18. Закон України «Про правовий режим
доступу: https://zakon.rada.gov.ua/laws/show/1550-14#Text
19. Закон України «Про протимінну діяльність в Україні». — Режим доступу: https://zakon.rada.gov.ua/laws/show/2642-19#Text
20. Захист від хімічних і радіаційних факторів ураження: навчальний посібник / за ред. проф. О. Є. Левченка. — К. : Українська військово-медична академія, 2015. — 404 с.
21. Кодекс цивільного захисту України. — Режим доступу: https://zakon. rada.gov.ua/laws/show/5403-17#Text
22. Конституція України. — Режим доступу: https://zakon.rada.gov.ua/ laws/show/254%D0%BA/96-%D0%B2%D1%80#Text
23. Конвенція про заборону або обмеження застосування конкретних видів звичайної зброї, які можуть вважатися такими, що завдають надмірних ушкоджень або мають невибіркову дію. — Режим доступу: https://zakon.rada.gov.ua/laws/show/995_266#Text
24. Конвенція про заборону застосування, накопичення запасів, виробництва і передачі протипіхотних мін та про їхнє знищення. — Режим доступу: https://zakon.rada.gov.ua/laws/show/995_379#Text
25. Концепція розвитку цифрових компетентностей. — Режим доступу: https://zakon.rada.gov.ua/laws/show/167-2021-%D1%80#Text
26. Курс стрільб зі стрілецької
машин КРП 03.032.0562018 (01). Затверджено наказом
від 17.04.2018 №160. — Режим доступу: https://drive.google.com/file/d/1dTWTU82qfe8HKVN06 TBWjqRHl4cVwbp3/view
27. Лєжнєв О. Про нові знаки розрізнення військових звань. — Видавництво «Знак», 2017.
28. Методика підготовки та проведення занять з вогневої підготовки. ВКДП 7-00(01).01. ЦОСМП ЗСУ та НАСВ, 2021. — Режим доступу: https://drive.google.com/file/d/1p089DcIYIicpqCEI8hSJuWZN1YOOi7 -H/view
29. Методичний матеріал по вогневій підготовці для навчання військовослужбовців, призваних за мобілізацією (загальновійськова підготовка у навчальних центрах, військових частинах) ЗСУ, 2015. — Режим доступу: https://drive.google.com/file/d/1a7vL5hzi2WaFXKXbF1Q80ASgtIfagDK/view
30. Міжнародне гуманітарне право / Під ред. Базова В. П. — К., «Варта». — 2000. — 176 с.
31. Міжнародні стандарти протимінної діяльності (МСПМД / IMAS) 01.10, Посібник з використання міжнародних стандартів протимінної діяльності, Друге видання, Поправка 8, червень 2013 р.
32. Міжнародні стандарти протимінної діяльності (МСПМД / IMAS) 04.10, Глосарій термінів, визначень і скорочень з питань протимінної діяльності, Друге видання (Поправка 6, травень 2013 р.), Крилюк В. О., Кузьмін В. Ю., Кузьмінський І. В. — К., 2017. — 84 с.
33. ДСТУ-П IMAS 08.40:2016 (IMAS 08.40:2013, IDT) Маркування загроз, пов’язаних із мінами та вибухонебезпечними залишками війни.
34. ДСТУ-П IMAS 09.10:2016 (IMAS 09.10:2013, IDT) Вимоги до очищен-
Список використаних джерел
ня замінованих (забруднених) ділянок місцевості.
35. ДСТУ-П IMAS 09.11:2016 (IMAS 09.11:2013, IDT) Очищення району ведення бойових дій.
36. Екстрена медична допомога (догоспітальні протоколи): посібник // за редакцією професора О. В. Богомолець, професора Г. Г. Рощіна. –Київ. Юстон. – 2016. – 212 с.
37. Екстрена медична допомога військовослужбовцям на догоспітальному етапі в умовах збройних коконфліктів: Навчальний посібник / Бадюк М. І., Ковида Д. В., Микита О. О., Козачок В. Ю., Середа І. К., Швець А. В. // За редакцією професора Бадюка М. І. — К. : СПД. Чалчинська Н. В. — 2018. — 212 с.
38. Екстрена медична допомога на догоспітальному етапі: навчальний посібник / [В. О. Крилюк, С. О. Гур’єв, А. А. Гудима, Н. І. Іскра та ін.]. — Київ. — 2016. — 400 с.
39. Міжнародні стандарти протимінної діяльності (МСПМД / IMAS) 12.10, Інформування про мінну небезпеку та небезпеку ВЗВ, Друге видання, Поправка 2, червень 2013 р.
40. Наказ Міністра оборони України від 23.03.2017 № 164 «Про затвердження Інструкції про порядок виконання норм міжнародного гуманітарного права в ЗСУ». — http://zakon3.rada.gov.ua/laws/show/z070417.
41. Небезпечні хімічні речовини. Аварії на хімічно небезпечних об’єктах: навчальний посібник / О. Є. Левченко, В. І. Сагло. — К. : Українська військово-медична академія. — 2015. –196 с.
42. Основи цивільного захисту: Навч. посібник / В.О. Васійчук, В.Є Гончарук, С.І. Качан, С.М. Мохняк.- Львів:Видавництво Національного університету «Львівська політехніка», 2010.- 417с.
43. Оцінка радіаційної хімічної обстановки: навчальний посібник / за ред. проф. О. Є. Левченка. — К. : СПД Чалчинська Н. В. — 2015. — 256 с.
44. Перша медична (екстрена) допомога з елементами тактичної медицини на догоспітальному етапі в умовах надзвичайних ситуацій: навч. посіб. / В. С. Тарасюк, М. В. Матвійчук, І. В. Паламар та ін.; за ред. В. С. Тарасюка. — К. : ВСВ «Медицина». — 2015. – 368 с.
45. Порадник воїну Сил територіальної оборони. Командування Сил ТрО, 2022. — Режим доступу: https://drive.google.com/file/ d/1EQFizjBpGs4tjsC_tzDFqy4Ej4udnfB7/view
46. Посібник щодо застосування озброєння іноземного виробництва у ЗСУ (інструкції з використання). Частина 1 (стрілецьке озброєння) М16 (М4), P-64, Uzi, FN FAL, CZ P-10, CZ BREN 2MS. ВП 7-(01).03.01. КСВ ЗСУ та ДНДІ ВСОВТ, 2022. — Режим доступу: https://drive.google. com/file/d/1jGxjp1YNu7hfKaD3z_96LXSrH25OKR0a/view
47. Постанова Кабінету Міністрів
від 24.03.2004 р. №368 «Про затвердження
zakon.rada.gov.ua/laws/show/368-2004-%D0%BF#Text
48.
378
ступу: https://zakon.rada.gov.ua/laws/show/372-2019-%D0%BF#Text
49. Постанова Кабінету Міністрів України від 26 червня 2013 р. № 444 «Про затвердження Порядку здійснення навчання населення діям у надзвичайних ситуаціях». — Режим доступу: https://zakon.rada.gov. ua/laws/show/444-2013-%D0%BF#Text
50. Протокол про вибухонебезпечні предмети – наслідки війни. — Режим доступу: https://zakon.rada.gov.ua/laws/show/995_c78#Text
51. Словник військових термінів та скорочень (абревіатур). ВКП 1-00(01).01. Воєнно-наукове управління ГШ ЗСУ. — Режим доступу: https://drive.google.com/file/d/1J79DanuoM66wkgUKmiv6QbJ0Pow1 UvLb/view
52. Спеціальна обробка: навчальний посібник / за ред. проф. О. Є.Левченка. К.: Українська військово-медична академія. — 2015. — 184 с.
53. Стандарт підготовки: Фахова підготовка санітарного інструктора роти (батареї) (вид. 1). — К., 2015. — 416 с.
54. Статути Збройних сил України: збірник законів: чинне законодавство зі змінами та доповненнями (офіційний текст). — Київ, 2016. — 424 с.
55. Стратегія воєнної безпеки України. — Режим доступу: https://zakon. rada.gov.ua/laws/show/121/2021#Text
56. Стратегії кібербезпеки України. — Режим доступу: https://www. president.gov.ua/documents/4472021-40013
57. Стратегічна концепція НАТО-2022. — Режим доступу: https://www. nato.int/nato_static_fl2014/assets/pdf/2022/6/pdf/290622-strategicconcept-ukr.pdf
58. Стратегія національної безпеки України. — Режим доступу: https:// zakon.rada.gov.ua/laws/show/392/2020#Text
59. Стройова підготовка. Методичний посібник. ВП 7-00(01).03. Центр оперативних стандартів і методики, 2021. — Режим доступу: https:// drive.google.com/file/d/1Nrda03uHnWApg2oeEp2Tk9DWUoNAV-0y/ view
60. 5,45-мм автомати Калашнікова (АК-74, АКС-74, АК-74Н, АКС-74Н) та 5,45-мм ручні кулемети Калашнікова (РПК-74, РПКС-74, РПК-74Н, РПКС-74Н). Керівництво зі стрілецької справи. ВКДП 7-00(01).01. УБП КСВ ЗСУ, 2019. — Режим доступу: https://drive.google.com/file/ d/1bac99TUc7t-QxgIuyFqmeLCTIHGh-hIr/view 61. 5,56-мм сімейство бойової зброї (C7/C7А1, C8/C8а1, LSW, SFW). Керівництво оператора. ВП 7-(01).03.01. Командування підготовки КСВ ЗСУ, 2022. — Режим доступу: https://drive.google.com/file/d/1od5X KGv37OsYGt3seHSap0yAQV39JhbB/view
Навчальне видання
Авторський колектив: Фука Микола Михайлович
Пашко Костянтин Олександрович Гарасимів Ігор Михайлович
Гудима Арсен Арсенович Чуткий Сергій Іванович
Мельник Роман Михайлович Білах Богдан Іванович
військовою та фізичною підготовкою»
Головний редактор Іван Білах Комп’ютерна верстка Дарії Янік Обкладинка Òåòÿíè Âîëîøèí Літературний редактор Ігор Миколів Художнє оформлення
р. www.aston.te.ua, e-mail: tovaston@gmail.com
